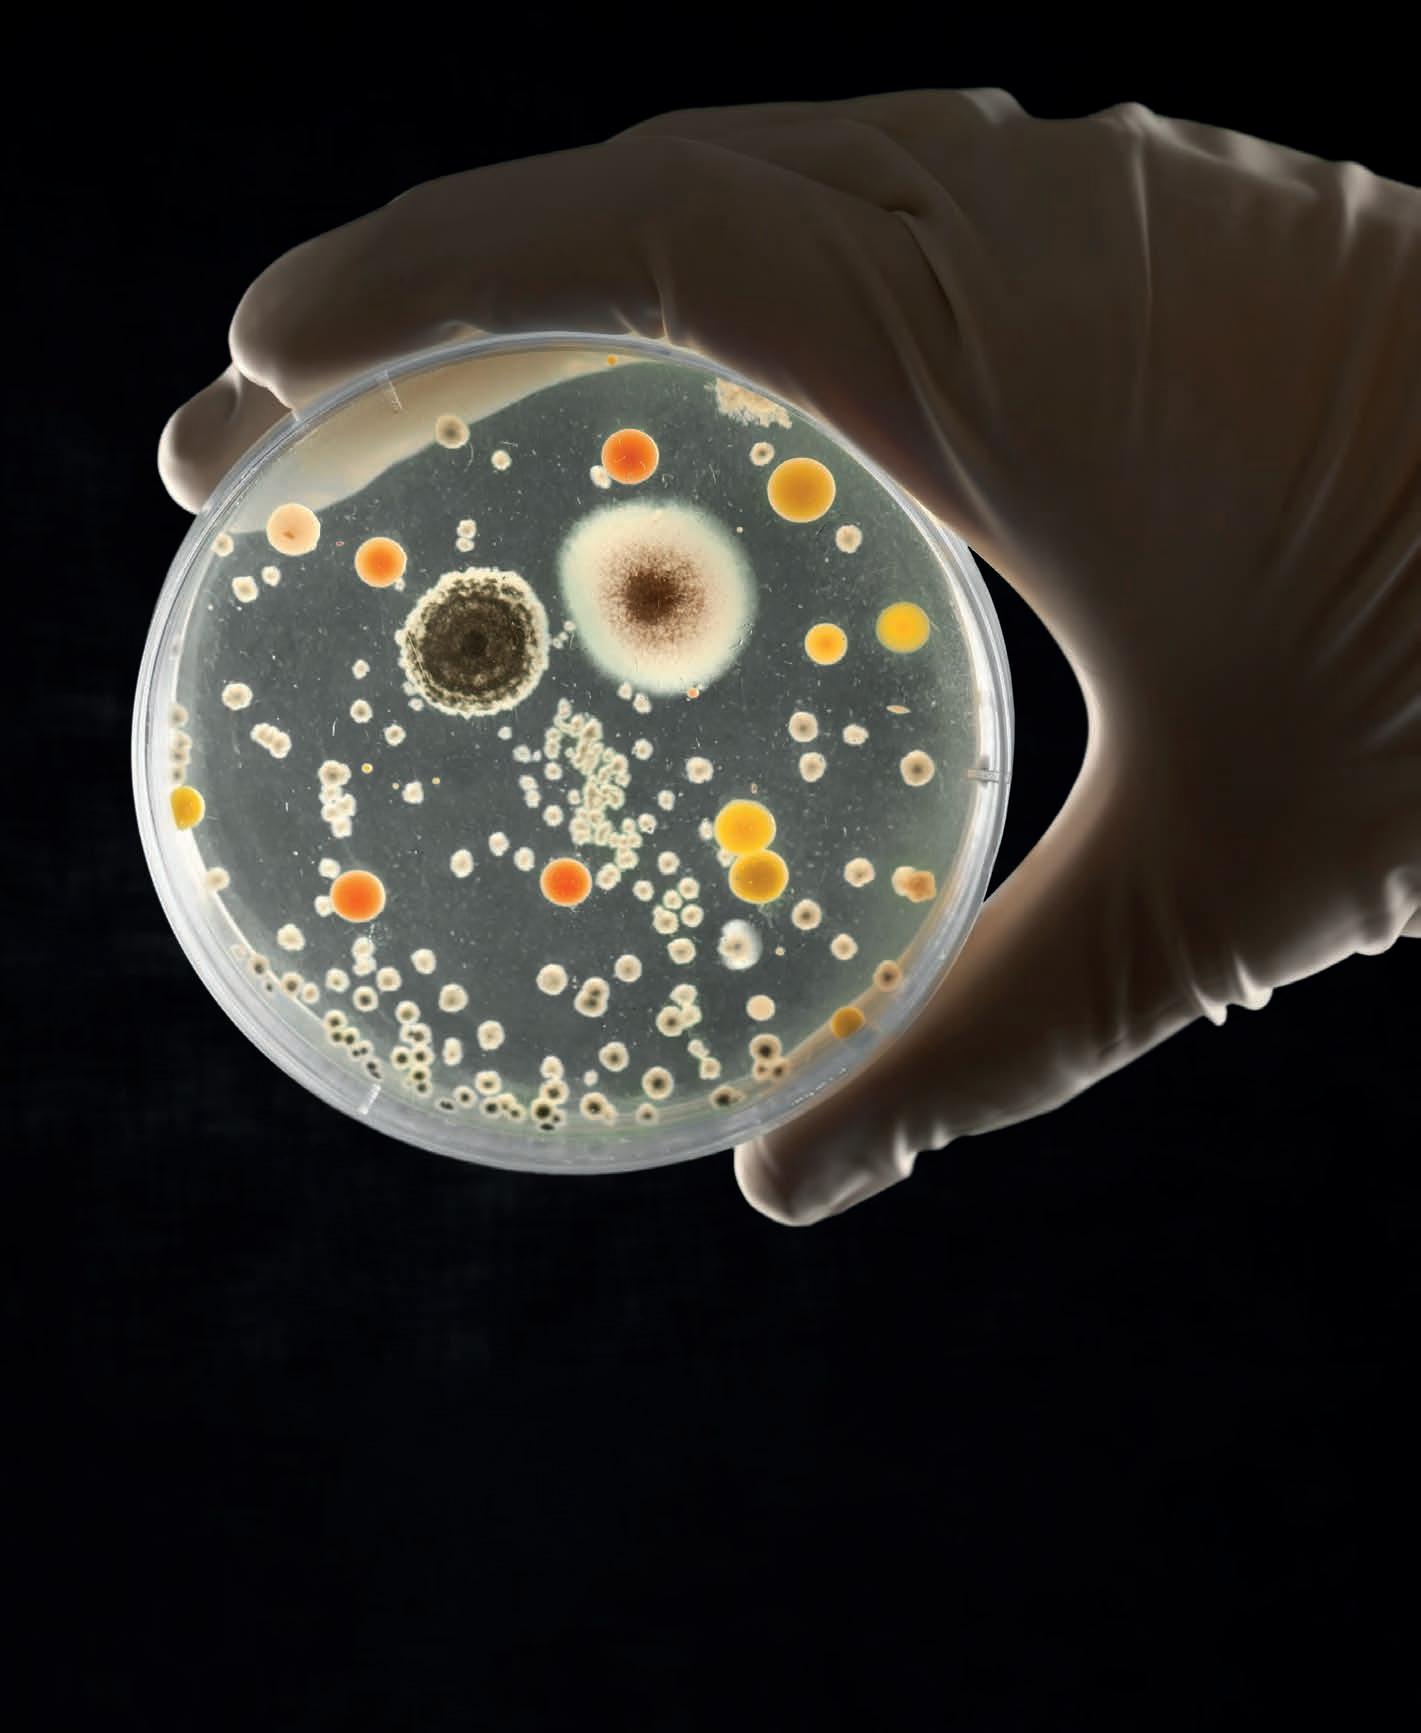

MENSILE DI PULIZIE INDUSTRIALI, SANIFICAZIONE E IGIENE AMBIENTALE












































































































































































































































































MAURIZIO PEDRINI direttore tecnico di Dimensione Pulito
Ancora una volta Milano si appresta a diventare la capitale internazionale del cleaning professionale: dal 27 al 29 maggio nei padiglioni della Fiera di Rho andrà in scena ISSA Pulire. La metropoli lombarda accoglierà la seconda Rassegna al mondo, per numero di visitatori, posizionata in Europa solo alle spalle di Interclean Amsterdam.
Saranno almeno 20.000 gli ospiti che varcheranno i tornelli d’ingresso, dei quali quasi 7.000 provenienti da oltre 100 Paesi. Sono cifre che, da sole, basterebbero a dimostrare l’assoluta rilevanza mondiale della manifestazione e la spasmodica attesa per l’evento espositivo, divenuto uno straordinario indicatore dello stato di salute dell’intero comparto economico.
Ma non basta: questa rassegna espositiva si conferma come una straordinaria piattaforma per l’innovazione, la formazione e il networking nel settore della pulizia e sani cazione professionale, perché - offrendo un punto d’incontro imperdibile - riunirà in un unico luogo la comunità globale dei professionisti del cleaning, creando un canale di contatto diretto tra domanda e offerta.
Le tre giornate si presentano, come sempre, intense, ricche di stimoli e diversi cate.
Oltre alla vasta area espositiva, che vedrà la partecipazione delle
aziende leader del settore e di interessanti start up innovative, i visitatori potranno assistere a seminari, workshop e presentazioni dedicate a temi chiave, come la sostenibilità, il green cleaning, la digitalizzazione e la sicurezza sul lavoro.
A ISSA Pulire Lab si discuteranno argomenti di grande attualità, tra cui il nuovo Codice degli appalti e l’applicazione dell’intelligenza arti ciale nel mondo del pulito professionale. In programma, inoltre, la seconda edizione dell’Hackathon, una stimolante competizione tra squadre di studenti universitari chiamati a sviluppare idee innovative che dimostrino come questo nuovo strumento possa generare valore nell’industria del cleaning.
Anche il parterre dei relatori si annuncia, come sempre, di grande prestigio, con la partecipazione di esperti come l’ex ministro del lavoro Cesare Damiano, Piero Martello, già presidente del Tribunale del Lavoro di Milano e Walter Ricciardi, professore di Igiene e Salute Pubblica presso l’Università Cattolica del Sacro cuore di Milano.
In de nitiva, ISSA Pulire si annuncia come un appuntamento davvero imperdibile, al quale anche Dimensione Pulito non mancherà, con il suo apporto di proposte e iniziative, dando appuntamento a tutti i lettori nel proprio stand, Pad.8-C18






















5UN APPUNTAMENTO IMPERDIBILE!
ATTUALITÀ 14L’ECCELLENZA DELL’IGIENE

26LA SFIDA EUROPEA DEL CLEANING IN PRIMO PIANO

32TRANSIZIONE 5.0 PER LA LOGISTICA

40VALORIZZARE IL LAVORO
36REGOLAMENTARE L’USO DELL’AI IN ITALIA



















46UNA GRANDE MANIFESTAZIONE

50LA STORIA DI PULIRE

58IL CLEANING TRA FUTURO E FORMAZIONE
TENDENZE

64CRONACA DI UN SUCCESSO
70IL VALORE DI UN MARCHIO
PROCEDURE

74LAVORARE IN SICUREZZA


























80CAPPE DELLA RISTORAZIONE SICURE E SALUBRI

86 LA PULIZIA DI SGROSSO

90SCOPATURA DEI PAVIMENTI

98IL CUORE DELLA RISTORAZIONE

102LAVANDERIE. EVOLUZIONE TECNOLOGICA

108LA FORMAZIONE MANAGERIALE NON È UN OPTIONAL

114MI SPIACE MA NON MI RICONOSCO PIÙ




Direttore Responsabile Giorgio Albonetti


IMPRENDITIVITÀ

RUBRICHE
NEWS


184AGGIORNAMENTI, NOVITÀ E TENDENZE
DAL MONDO DEL CLEANING
VETRINE
186SOLUZIONI INNOVATIVE PER IL CLEANING PROFESSIONALE
INDICE INSERZIONISTI
ALLEGRINI..................................12, 14
AMEDICS.....................................14, 69
ANNOVI REVERBERI.........................45
AREXONS/FULCRON.....................3, 14
ARIX............................................14, 79
CHRISTEYNS...............................14, 23
COMAC..........................................8, 14
COPYR ..................................14, 25, 55
DULEVO ...........................................14
EKOMMERCE...................................171
ESSECINQUE..............................14, 119
ESSITY TORK....................................59
FALPI............................................2, 14
FILMOP............................................95
FIMAP.........................................10, 14
HAGLEITNER..................................107
HYGENIA....................................14, 101
ICEFOR.............................................73
IGEAX...........................INSERTO II, 123
IMESA.......................................14, 105
INDUPHARMA ...........................14, 126
INDUSTRIE CELTEX ......... I-II COP, 1, 14
ITALCHIMICA..........................31, 56, 57
KAIROSAFE....................................135
LR FLAVOURS...........................14, 189
LUCART .......................... 14, III-IV COP.
LYRECO.....................................14, 183
MEDIAL INTERNATIONAL......14, 84, 85
MK.................................. INSERTO I, 14
MP-HT .........................................14, 55
NEWPHARM..............................14, 159
OMM.................................................67
ORMA......................................14, S 175
PAPERDÌ.......................................6, 14
PAREDES.....................................4, 14
POLYCHIM...................................14, 97
RCM.............................................14, 63
RG STRUMENTI..........................14, 131
RUBINOCHEM...........14, INSERTO II, 121 STI ..................................................113
SYNGENTA................................14, 165
TTS ............................................88, 89
VDM.............................................14, 83
VEBI...........................................14, 117
WE ITALIA...................................14, 35
Direttore editoriale Ornella Zanetti | ornella.zanetti@quine.it
Direttore Tecnico Maurizio Pedrini
Coordinamento editoriale iara celsi c scelsi ls r it el Redazione ristina ardinali c cardinali ls r it el imone iapparelli s ciapparelli ls r it el oredana itulano l vitulano ls r it el
Hanno collaborato
Marco Barbetti, Valentina Bernini, Paolo Bersighelli, Alberto Bubbio, Vincenzo Cama, Daniele Carli, Franco Cesaro, Graziano Dassi, Francesco Fiorente, Niccolò Luongo, Stefania Milanello, Marco Monti, Roberto Mozzone, Francesco Nicassio, Giuseppe Pastori, Maurizio Pedrini, Fabrizio Pirovano, Giacomo Torrenzi
Progetto grafico Elisabetta Delfini | e.delfini@lswr.it
Grafica e impaginazione LSWR
Immagini Shutterstock
Ufficio traffico e Servizio abbonamenti lena enitoni e genitonii ls r it el
Direttore Commerciale ostantino ial i c cial i ls r it el
Pubblicità e Sviluppo Filippo Viola f.viola@lswr.it Edoardo Rossi e.rossi@lswr.it Elena Brusadelli | e.brusadelli@lswr.it
Produzione ntonio ovene a iovene ls r it el Stampa New Press Edizioni srl - Lomazzo (CO)
Abbonamenti onamento annuale euro nnuale estero euro opia arretrata euro osto di una copia euro a onamenti uine ls r it el www.quine.it
www.dimensionepulito.it
Quine Srl ia padolini ilano uine it in o uine it el
Responsabilità
Dimensione Pulito periodico mensile registrato: autorizzazione del ri unale di ilano del uine iscritta al egistro peratori della omunica ione n del a pu lica ione o ristampa di articoli e immagini della rivista deve essere autorizzata per iscritto dall’editore. Gli articoli pubblicati su Dimensione Pulito sono sotto la responsabilità degli autori. I manoscritti e i disegni pubblicati non saranno restituiti.
i sensi dell art egolamento uropeo per la rote ione dei ati ersonali di seguito i dati di tutti i lettori saranno trattati sia manualmente sia con strumenti informatici e saranno utilizzati per l’invio di questa e di altre pubblicazioni e di materiale informativo e promozionale. Le modalità di trattamento saranno con ormi a uanto previsto dagli art del dati potranno essere comunicati a soggetti con i uali uine rl intrattiene rapporti contrattuali necessari per l invio delle copie della rivista titolare del trattamento dei dati uine rl ia padolini ilano al uale il lettore si potr rivolgere per chiedere l’aggiornamento, l’integrazione, la cancellazione e ogni altra operazione di cui agli articoli del uine srl ilano
Testata Associata
Distribuzione Rivenditori, Imprese di servizi, Aziende alimentari, Sanità e RSA, Enti pubblici, Pubblici esercizi, Hotellerie, Lavanderie professionali, isin esta ione e servi i am ientali rande distri u ione n ISSN 2612-4068
Una panoramica delle aziende protagoniste del cleaning professionale che si distinguono per qualità, innovazione e specializzazione.
La loro capacità di adattarsi alle nuove esigenze del mercato - sicurezza, innovazione, sostenibilitàle rende competitive a livello globale.
Scopriamo chi, ogni giorno, contribuisce ad alzare gli standard dell’igiene professionale con passione, affidabilità e visione per il futuro.


Da 80 anni Allegrini è sinonimo di eccellenza nella detergenza professionale. Offre soluzioni complete per la pulizia e l’igiene di ogni ambiente, con prodotti altamente performanti e sostenibili, tra cui detergenti certificati colabel, prodotti super concentrati e sistemi di dosaggio per ridurre sprechi e impatti ambientali. Innovazione, qualità e servizio a 360° – dalla consulenza alla formazione –fanno di Allegrini un partner a dabile per ogni esigenza di pulizia professionale.
BEST SELLER
Nome del prodotto: colabel lavatrice
Plus: Detergente completo enzimatico da utilizzare in lavanderia professionale e selfservice con sistemi di dosaggio automatici.

ALLEGRINI SPA
Vicolo Salvo d’Acquisto 2
24050 Grassobbio (BG) Tel. +39 035 424 2111
WWW.ALLEGRINI.COM
Amedics è un brand specializzato nella disinfezione in ambito professionale, facente capo all’azienda Lombarda H Srl. Con la sua esperienza in ambito disinfezione e sicurezza, è un partner ideale per supportare le varie realtà nella ricerca e identificazione di prodotti specifici e mirati propone un vasto listino di soluzioni disin ettanti certificati e registrati, con e cacia comprovata dal superamento di test con standard internazionali.
BEST SELLER
Nome del prodotto
Linea di prodotti detergenti e disinfettati.
Plus: Formulati ecocompatibili, assistenza post vendita, e cacia disinfettante comprovata, corsi di formazione.

AMEDICS PROFESSIONAL
Via Volterra 9
20146 Milano Tel. +39 0532978497
WWW.AMEDICS.EU

Fulcron PRO è un brand di Arexons, azienda italiana con oltre 100 anni di esperienza nella produzione di soluzioni per la pulizia in ambito professionale, industriale e fai-da-te. Nato nel 1985 con il celebre Super Sgrassatore Concentrato, oggi il brand offre una gamma dedicata ai professionisti dei settori Horeca, industria e facility management. Comprende detergenti per lavastoviglie, pulitori specifici, sgrassatori, disinfettanti, prodotti per pavimenti e lavamani. Qualità, e cacia e innovazione al servizio di tutti gli operatori.
BEST SELLER
Prodotto: D-Grex
Plus: Sgrassatore universale 750 ml, azione rapida su unto e grasso, sicuro su alluminio, fresco profumo di limone.

AREXONS SPA
Via Strada Antica di Cassano 23
20063 Cernusco S/N (MI)
Tel. +39 02 924361
WWW.FULCRONPRO.IT
Arix Pro è la divisione di Arix dedicata ai professionisti del settore Cleaning e Horeca. Con un team Ricerca & Sviluppo focalizzato sulla pulizia professionale, progetta tutti i prodotti in Italia, realizzandone la maggior parte negli stabilimenti italiani, secondo rigorosi standard qualitativi. L’innovazione è al centro dell’attività quotidiana, insieme a un impegno concreto verso la sostenibilità ambientale. Da questo principio nasce la linea We Like Green, sviluppata con materiali riciclati, riciclabili e naturali. Dal 2022, Arix Pro è partner di Alleanza dei Cuochi Slow Food. Con i prodotti Arix distribuiti in oltre 60 Paesi, l’azienda si distingue anche per le numerose certificazioni ottenute: ISO 9001, ISO 45001, S , , odello Organizzativo 231 e Bilancio di Sostenibilità.
BEST SELLER
Prodotto: ri ro icro ntibact
Plus: Panno multiuso anti-aloni con trattamento biocida attivo fino a 30 lavaggi, igiene e odori sotto controllo.

ARIX SPA
Viale Europa 23
Viadana (MN)
Tel. +39 0375 832111
WWW.ARIXPROFESSIONAL.COM


Non si costruisce un mondo più pulito in un solo giorno. Christeyns inizia l’attività nel 1946 a hent da un piccolo saponificio Da allora è diventatauna realtà di primo piano nel mercato mondiale della detergenza professionale. Christeyns significa prodotti chimici d alta qualità, attrezzature a dabili, servizio essibile e su misura l portfolio comprende soluzioni per la pulizia professionale di tessuti, industria alimentare e food retail, la pulizia professionale e i settori medico e Life Sciences. Da attività a conduzione familiare, si sviluppata fino a diventare un’azienda di primo piano sulla scena internazionale, ma sempre attenta alle esigenze locali. Così è in grado di soddisfare tutte le esigenze e aspettative dei clienti.
BEST SELLER
Prodotto: Bioxigen
Plus: Additivo ad azione sbiancante, igienizzante, combatte gli odori sgradevoli, raggiunge il massimo della sua attività già a 40°C.

CHRISTEYNS ITALIA SRL
Via Aldo Moro 30
20060 Pessano con Bornago (MI)
Tel. +39 0299 765200 WWW.CHRISTEYNS.COM
Con oltre 50 anni di esperienza, Comac si è distinta per saper a rontare le sfide del mercato e delle evoluzioni tecnologiche. Tra le soluzioni offerte da Comac troviamo lavasciuga pavimenti, spazzatrici, monospazzole, aspiratori, sanificatori e idropulitrici, capaci di soddisfare ogni esigenza di pulizia in diverse condizioni di uso e su ogni tipo di superficie el contesto attuale, sempre più competitivo, l’introduzione di soluzioni tecnologicamente avanzate consente a Comac di soddisfare le necessità specifiche di diversi settori rafforzando il legame con clienti e fornitori. L’azienda continua inoltre a investire in ricerca e sviluppo, per migliorare i propri prodotti, tenendo sempre al centro le persone.
BEST SELLER
Prodotto: S
Plus: S il cobot lavapavimenti progettato da Comac per la pulizia autonoma dei pavimenti. Sa adattarsi ad ogni situazione.

COMAC SPA
Via Maestri del Lavoro 13
37059 Santa Maria di Zevio (VR)
Tel. +39 045 8774222
WWW.COMAC.IT

Copyr, Compagnia del Piretro, è un’azienda italiana con oltre 60 anni di esperienza nella formulazione di insetticidi e prodotti per l’igiene ambientale. Specializzata in soluzioni di derivazione naturale, e caci e sicure, si distingue per l eccellenza scientifica e l’attenzione alla sostenibilità. Copyr, simbolo del Piretro in talia e in uropa, o re anche servizi ad alto valore aggiunto per professionisti e aziende. Insieme a Zelnova, forma uno dei principali player europei e internazionali nel settore dell’igiene ambientale, con una presenza consolidata in numerosi mercati.
BEST SELLER
Prodotto: en asa e tra
Plus: Insetticida aerosol automatizzato per sistema
Copyrmatic, contro insetti volanti contenente Piretro di derivazione vegetale.

COPYR SPA
Via Stephenson 73
20157 Milano (MI)
Tel. +39 02 390368.1
WWW.COPYR.EU
Fondata nel 1976, Dulevo International è specializzata nella produzione di attrezzature per la pulizia commerciale, industriale e stradale. Oggi, parte del Gruppo Fayat, è il principale produttore italiano del settore, con una gamma completa di soluzioni e un sistema di spazzamento meccanico aspirante filtrante tra i più e cienti sul mercato La rete di distribuzione copre oltre 70 Paesi, supportata da filiali dirette in ermania, ndia e Stati Uniti. Dulevo unisce tecnologia, sostenibilità e durata per rispondere alle esigenze di pulizia in contesti retail, industriali e urbani. assima attenzione riservata a performance, e cienza operativa, com ort per l’operatore e rispetto ambientale.
BEST SELLER
Prodotto: Dulevo 100
Plus: Spazzatrice robusta e a dabile, con grande capacità di carico e filtrazione polveri, anche in versione elettrica.

DULEVO INTERNATIONAL SPA
Via G. Guareschi 1
43012 Fontanellato (PR)
Tel. +39 0521 827711
WWW.DULEVO.COM

Con radici nel settore tessile e dell’abbigliamento, ssecinque nasce nel dall’esperienza quarantennale dei suoi fondatori. L’azienda applica questo know-how alla produzione di articoli per la pulizia professionale, realizzati in tutte le fibre tessili e con materie prime selezionate. Grazie a impianti altamente automatizzati e a una solida competenza produttiva, ssecinque garantisce qualità, versatilità e innovazione. Nel tempo ha sviluppato partnership strategiche con i principali produttori di attrezzature, offrendo un catalogo ampio e integrato. Flessibilità, internazionalizzazione e personalizzazione completano l’identità di un’azienda che unisce esperienza e visione.
BEST SELLER
Prodotto: icro ast
Plus: Il panno mop permette una pulizia perfetta grazie al particolare intreccio tra la microfibra e il cotone op con sistema a strappo

ESSECINQUE SRL
Via Biancon 10/12
35010 Villa del Conte (PD)
Tel. + 39 049 9390114
WWW.ESSECINQUE.NET
Fondata nel 1987, Falpi opera con tre stabilimenti produttivi a onzone, rivero e ottalciata (Biella). L’obiettivo è da sempre portare innovazione nel settore delle attrezzature per la pulizia professionale. Con oltre 35 anni di attività, una squadra giovane e dinamica, e una profonda conoscenza delle esigenze operative, Falpi propone soluzioni rapide, e caci e su misura per imprese di pulizia, ospedali, scuole e comunità. Tutti i prodotti sono progettati e realizzati in Italia, con materie prime selezionate per garantire qualità e lunga durata. L’intera gamma è completamente riciclabile, a conferma di un impegno concreto verso l’ambiente. azienda certificata S , ISO 14001, SA8000, e per la Parità di Genere secondo UNI/PdR 125:2022, oltre a essere riconosciuta con la medaglia S Silver op
BEST SELLER
Prodotto: ubi colabel
Plus: Il carrello Kubi ha ottenuto sia la certificazione colabel sia il remio colabel

FALPI SRL
Via Diagonale 120
Ponzone Trivero (BI)
Tel. + 39 015 7387777
WWW.FALPI.COM

Fimap progetta e produce in Italia macchine per la pulizia dei pavimenti che esporta in 80 paesi nel mondo. La gamma comprende diversi modelli di lavasciuga pavimenti, macchine spazzanti-lavanti, spazzatrici, aspirapolvere, aspiratori per solidi e liquidi, lavasuperfici tessili, monospazzole e sanificatori, adatti a esaudire ogni tipo di esigenza di pulito, dotati di innovative soluzioni tecnologiche che consentono di raggiungere alti standard di igiene in modo sostenibile. Passione e creatività alimentano un costante desiderio di esplorare nuove possibilità e di realizzare prodotti unici, che apportino un significativo miglioramento nel settore.
BEST SELLER
Prodotto: avasciuga pavimenti
Plus: Caratterizzata da una progettazione di qualità realizzata in un allestimento essenziale, per alti standard professionali.

FIMAP SPA
Via Invalidi del Lavoro 1
37059 S. Maria di Zevio VR
Tel. +39 045 6060411 WWW.FIMAP.COM
Hygenia è un’azienda specializzata in servizi di sanificazione, pulizia professionale e igiene ambientale. Con un approccio orientato alla sostenibilità e all’innovazione, offre soluzioni personalizzate per imprese, strutture sanitarie e pubbliche amministrazioni. razie a personale qualificato, tecnologie all’avanguardia e prodotti certificati, garantisce standard elevati di qualità e sicurezza. Hygenia si distingue per a dabilità, e cienza e attenzione al cliente, operando nel pieno rispetto delle normative vigenti. Un partner ideale per ambienti puliti, sicuri e salubri.


Con oltre mezzo secolo di esperienza, Imesa è un punto di riferimento nella produzione di soluzioni per il lavaggio, l’asciugatura e lo stiro di qualsiasi tipo di tessuto. La sua crescita si basa su creatività, collaborazione e investimenti costanti nelle persone e nelle loro competenze. L’azienda propone una gamma completa di lavatrici da 8 a 125 kg, essiccatoi rotativi da 11 a 75 kg, mangani a rullo con diametri di 25 e 33 cm e calandre asciuganti da e cm e soluzioni S integrano tecnologie digitali per ottimizzare l’operatività, monitorare i consumi e migliorare l’interazione tra utenti e staff tecnico, con particolare attenzione all’assistenza e alla manutenzione.
r Shield H non solo il brand di detergenti professionali e disinfestanti di Indupharma, ma è una vera e propria garanzia di innovazione, sicurezza ed e cacia razie all esperienza e alla capacità produttiva, r Shield H il punto di riferimento per i professionisti che cercano prodotti a dabili per l’igiene e la disinfestazione. La linea completa è progettata per ottimizzare i processi di pulizia e sanificazione, garantendo risultati eccellenti e protezione duratura. L’azienda investe costantemente nella ricerca e nello sviluppo per offrire soluzioni all’avanguardia che tutelino la salute delle persone e l ambiente on r Shield H, la sicurezza e la qualità diventano lo standard per ambienti puliti e protetti.
BEST SELLER
Prodotto: LX 100 Wi-Fi
Plus: Compatto ed elegante, copre 100 m² e neutralizza odori con atomizzazione costante e silenziosa.

HYGENIA SRL
Via G. Gioachino Belli 86
00193 Roma
Tel. +39 06 83512183 WWW.HYGENIA.IT
BEST SELLER
Prodotto: Lavatrice Supercentri ugante
Plus: Cesto e vasca in acciaio inox AISI 304, carico acqua calda e fredda servito, massima stabilità, bassa rumorosità. Programmi per lavaggio

IMESA SPA
Via degli Olmi 22
31040 Cessalto (TV)
Tel. +39 0421 468011 WWW.IMESA.IT
BEST SELLER
Prodotto: TC3 - Detergente per Climatizzatori
Plus: Detergente pronto uso, a bassa soglia di impatto ambientale, pulisce rapidamente e lascia un gradevole profumo di pulito.

INDUPHARMA SRL
Via Sorgaglia 40 35020 Arre (PD)
Tel. + 39 049 8076144
WWW.MRSHIELD-PROTECH.COM

ultinazionale, con stabilimenti in uropa, ndustrie elte specializzata nella produzione di referenze a uso igienicosanitario in carta tissue, tessuto non tessuto e sistemi di dispensazione. Il marchio Celtex, per il settore AFH, rappresenta la concretizzazione dei valori del gruppo: innovazione, qualità e a dabilità elevata attenzione alla performance dei prodotti, che da sempre contraddistingue il brand, si declina in soluzioni ideali per tutte le aree d’uso che necessitino di praticità, igiene e pulizia. La gamma spazia dai più tradizionali articoli monouso in tissue, come lenzuolini, bobine, asciugamani, carta igienica, ai sistemi di dispensazione ad erogazione controllata, pensati per garantire igiene e riduzione dei consumi nel mercato professionale.
BEST SELLER
Prodotto: Omnia Labor
Plus: Dispenser per bobina in fogli piegati, estraibili uno alla volta. gienico, compatto e versatile zero sprechi.

INDUSTRIE CELTEX SPA
Via Trav. del Marginone 23
55015 Montecarlo (LU)
Tel. +39 0583 2741
WWW.INDUSTRIECELTEX.COM

nfibra il marchio di Industrie Celtex specializzato nell’apparecchiatura della tavola. Sebbene si parli di monouso, con nfibra la ricerca di qualità e innovazione si esprime ai massimi livelli, mixandosi con estro e creatività. Un’ampia gamma di tovaglioli, tovaglie e sottopiatti, colorati e decorati, risponde alle più disparate esigenze del ristoratore, adattandosi a diversi contesti e locali, dalle apparecchiature più eleganti a quelle casual nfibra unisce design, creatività e attenzione all’ambiente: le carte, infatti, sono certificate S , a testimonianza dell’impegno ecologico del marchio.

L.R. Industries, leader nella creazione e produzione di fragranze e aromi, è il partner ideale per un prodotto ade in Italy di qualità, inedito e ra nato a proposta nasce dal lavoro di un team altamente qualificato che, lavorando in sinergia con i clienti, è alla costante ricerca di soluzioni innovative, al passo con l’evoluzione del mercato. Innovazione, originalità e ra natezza guidano ogni ase del processo, dalla formulazione alla realizzazione finale razie a queste caratteristiche, L.R. Industries si afferma come realtà solida e a dabile nel settore, capace di coniugare creatività, esperienza e spirito sartoriale nella profumazione.

Lucart Professional si distingue come marchio di riferimento nel mercato Away From Home, rappresentando l’eccellenza del gruppo industriale italiano Lucart. L’obiettivo di Lucart Professional è quello di offrire soluzioni concrete e tangibili per l’igiene. I prodotti, che spaziano dalla carta tissue ai sistemi di dispensazione fino ai saponi, sono progettati per ridurre l’impatto ambientale senza compromettere qualità e funzionalità. Con un impegno costante verso pratiche sostenibili, Lucart Professional si conferma come un partner responsabile e all’avanguardia, dedicato a garantire un futuro più rispettoso dell’ambiente. Scegliere Lucart Professional significa scegliere innovazione e impegno verso la sostenibilità.
BEST SELLER
Prodotto ispenser as ne
Plus: Dispenser per tovaglioli in carta, erogazione foglio a foglio, consumi ridotti, praticità d’uso, igiene superiore.

INDUSTRIE CELTEX SPA
Via Trav. del Marginone, 23
55015 Montecarlo (LU)
Tel. +39 0583 2741
WWW.INDUSTRIECELTEX.COM
BEST SELLER
Prodotto: Biodé
Plus: Linea di fragranze dinamica, innovativa e biodegradabile, che coinvolge tutte le famiglie olfattive.

L.R. INDUSTRIES SPA
Via Pantano 24
Cont. Valcorrente
95032 Belpasso (CT)
Tel. +39 095 7135944
WWW.LRINDUSTRIES.IT
BEST SELLER
Prodotto: Asciugamani piegati co atural
Plus co atural realizzato con Fiberpack®, materia prima ricavata da fibre di cellulosa ricavate da cartoni per bevande.

LUCART SPA
Zona Ind. Decimo
55023 Borgo a Mozzano-LU
Tel. +39 0583 83701
WWW.LUCARTPROFESSIONAL.COM

Lyreco è leader europeo e attore globale nella fornitura responsabile di prodotti e servizi per ogni ambiente di lavoro. Nata nel 1926, oggi il Gruppo opera in 40 Paesi con un network distributivo capillare. In Italia è presente da 30 anni come “partner unico per ogni esigenza azienda aiuta imprese e professionisti di ogni settore a creare spazi funzionali, sicuri e salubri, semplificando il processo d’acquisto con un’offerta ampia e consegne rapide e puntuali. Sono oltre 60mila le referenze gestite, dall u cio alla sicurezza, igiene e pulizia professionale, ergonomia e molto altro. L’approccio omnicanale favorisce ordini smart e assistenza continua attraverso account sul campo e da remoto, specialisti, Lyreco.it e customer care.
BEST SELLER
Prodotto: servizio e soluzioni multibrand
Plus: Consulenza di prodotto, approccio specialistico, prodotti e servizi multibrand, consegne essibili, puntualità e assistenza

LYRECO ITALIA SRL
Via Papa Giovanni Paolo II, snc
20040 Cambiago (MI)
Tel. +39 02 95 94 41
WWW.LYRECO.IT

Dal 1985, Specialisti nel Cleaning. edial una delle grandi protagoniste italiane operanti nel settore delle forniture professionali per la pulizia, la conservazione, il decoro e l’igiene degli spazi pubblici. Oltre mille prodotti a catalogo, garantiti da un’esperienza di 40 anni. Nel 2008 abbiamo acquisito etalnova, che ci ha reso Specialisti nella realizzazione di contenitori in metallo. Siamo Specialisti nella sfera generalista, con un’offerta accurata di prodotti in metallo di alta qualità a fianco di altre referenze in materie plastiche, per una proposta a 360° sempre dedicata alla funzionalità del prodotto. Per noi la sostenibilità è importante: abbiamo scelto impianti fotovoltaici per diminuire le emissioni di gas serra e siamo sempre alla ricerca di soluzioni green oriented.
BEST SELLER
Prodotto: BOB Color
Plus: Soluzione evergreen, la gamma di contenitori mono usso per la raccolta differenziata in aree interne a medio tra co

MEDIAL INTERNATIONAL SPA
Via A. Volta 7/9
26837 Mulazzano (LO)
Tel. +39 02 90660436
WWW.MEDIALINTERNATIONAL.COM

un azienda italiana focalizzata sulla ricerca di formule innovative in grado di rendere i luoghi in cui viviamo più puliti, piacevoli e sicuri. In una parola, più accoglienti. ar a, brand di , ha creato Sistema Detergenza, Sistema Igiene e Sistema Ambiente: tre gamme con prodotti studiati e formulati per soddisfare ogni esigenza del cliente, qualunque sia il suo settore, garantendo una Protezione Profonda Professionale in tutti gli ambienti e contesti.
BEST SELLER
Prodotto:
Plus: Detergente solventato, con capacità estrattive, sviluppato per sgrassare a ondo le superfici dure

MK SPA
Via Ciro Menotti, 77
20017 Rho (MI)
Tel. +39 02 93504187
WWW.MKSPA.COM

H , ondata negli anni a Padova dai fratelli Ragazzo, unisce innovazione e tradizione artigianale. Oggi, portata avanti dalla seconda generazione, prosegue con successo nella progettazione e produzione di spazzatrici industriali e urbane, che si distinguono per robustezza, a dabilità e innovazione Ogni macchina è progettata per rispondere alle esigenze del lavoratore, ottimizzare i tempi e migliorare l e cienza operativa e spazzatrici H non sono solo strumenti di lavoro, ma veri e propri alleati dell’operatore, rendendo il lavoro più facile, piacevole e soddisfacente. Non ci limitiamo a fornire macchinari, ma offriamo soluzioni su misura che rispondono alle sfide di pulizia, assicurando un ambiente di lavoro sicuro e pulito.
BEST SELLER
Prodotto Stout
Plus on motori elettrici a , questa spazzatrice uomo a bordo offre alte prestazioni e consumi energetici ridotti.

MP-HT SRL
Via Tamburin 19
35010 Limena (PD)
Tel. +39 049 7968360
WWW.MP-HT.IT

Fondata nel 1982, Newpharm® è un’azienda italiana di proprietà della famiglia Bagarollo, che da più di 40 anni, rappresenta una risposta a livello globale per chi è alla ricerca di soluzioni innovative per il benessere e la sicurezza delle persone. Produce e commercializza tecnologie avanzate per la disinfestazione professionale e l’igiene ambientale. Ogni innovazione è il risultato di sperimentazioni sul campo e in laboratorio, profonda conoscenza del mercato, confronto con eccellenze del settore e approccio lungimirante pronto a intercettare sia il cambiamento in atto sia le tendenze a venire. Con più di 4mila referenze e una presenza in continua espansione, l’azienda si impegna a soddisfare le esigenze dei clienti, mantenendo al centro l’innovazione, la qualità e la sostenibilità.
BEST SELLER
Prodotto: zamet
Plus: Insetticida potente e persistente contro insetti volanti e striscianti. Azione abbattente immediata.

NEWPHARM SRL
Via Tremarende 22
35010 S. Giustina in Colle (PD)
Tel. +39 049 9302876
WWW.NEWPHARM.IT

Da oltre 40 anni, Orma è il punto di riferimento nel Pest Control e nell’Igiene degli Ambienti e supporta i propri clienti con prodotti e servizi capaci di offrire soluzioni e caci per tutte le necessità Orientata all’innovazione ed alla massima eccellenza, Orma è garanzia di professionalità, qualità e benessere per tutti gli operatori del settore e per i loro clienti.
BEST SELLER
Prodotto: Air Control System
Plus: Dispenser aerosol e spray insetticida a base di piretro per una protezione immediata e continuativa sugli insetti volanti.

ORMA SRL
Via Chiribiri 2
10128 Trofarello (TO)
Tel. +39 011 6499064 WWW.ORMATORINO.COM
Dal 1989 Paperdi opera con successo nel comparto tissue dell’industria cartaria producendo, presso lo stabilimento di Caserta, articoli monouso per impieghi igienici e alimentari. La costante ricerca tecnologica e l’impegno per uno sviluppo sostenibile guidano la produzione di un’ampia gamma di articoli di alta qualità realizzati in pura cellulosa e carta ecologica come bobine industriali, lenzuolini, carta igienica jumbo e a rotolini, asciugamani interfogliati a , , , , e tovaglioli on l avvio, nel 2018, del funzionamento della propria Cartiera sita in Pietramelara, Paperdi vanta un sistema integrato di produzione che ha ulteriormente potenziato la qualità totale dei prodotti. Guidata da una visione responsabile nei confronti delle persone e dell’ambiente è riuscita ad affermarsi nel mercato italiano del tissue professionale, offrendo soluzioni essibili e competitive
BEST SELLER
Prodotto: Asciugamano inter ogliato a Plus: Pratici e igienici asciugamani a in cellulosa, ormato , veli in confezione da 200 fogli. ertificati colabel e S

PAPERDI SRL
Via Appia Antica, 53
81020 S. Nicola La Strada (CE)
Tel. +39 0823 490011
WWW.PAPERDI.IT

Paredes rivoluziona il mercato professionale dell’igiene dal 1942 con soluzioni pionieristiche come la prima bobina di ovatta per asciugatura industriale e il sistema auto-cut. Nata come specialista nell’igiene delle mani, l azienda si evoluta fino a diventare un fornitore completo di prodotti e servizi per l’igiene e la protezione. Oltre alla sua consolidata linea per ambienti sanitari, Paredes ha ampliato l’offerta acquisendo Orapi, leader globale nella produzione di prodotti chimici e per la manutenzione industriale. Continua a crescere, mantenendo come priorità l e cacia e la sicurezza per l’utente e per l’ambiente — principi fondamentali della missione aziendale.
BEST SELLER
Prodotto: Paredis Style Roll
Plus: Dispenser del già collaudato sistema a taglio automatico, è garanzia di a dabilità, com ort e igiene.

PAREDES ITALIA SPA
Via Scarsellini, 119 16149 Genova
Tel. +39 010 2362800 WWW.PAREDES.IT

Dal 1984 Polychim progetta, produce e commercializza: detersivi, detergenti, additivi e ausiliari per la detergenza, igienizzanti, cere e cosmetici a uso professionale. Offre ai distributori professionali del Cleaning una gamma di prodotti ampia e aggiornata per cucine, lavanderie, collettività, sanità, industrie, trasporti, igiene della persona, anche superconcentrati e con certificazione ed colabel Siamo specializzati nella creazione di linee di prodotto progettate ad hoc e personalizzate su specifiche esigenze del cliente distributore, oltre a fornire il necessario supporto pre e post vendita. I processi aziendali sono certificati secondo la orma
BEST SELLER
Prodotto: S
Plus: detergente igienizzante profumato anticalcare concentrato non acido per la pulizia e l’igiene di tutto il bagno.

POLYCHIM SRL
Via Fogazzaro 16
20092 Cinisello Balsamo (MI)
Tel. + 39 02.66016908
WWW.POLYCHIM.IT
al progetta, produce e distribuisce in tutto il mondo con una vasta rete commerciale, macchine per la pulizia industriale e urbana , acronimo di Raimondi Costruzioni eccaniche, stata una delle prime aziende italiane produttrici nel settore del cleaning, nata e cresciuta a odena, al centro di un territorio caratterizzato da un forte spirito imprenditoriale con vocazione alla eccanica di qualità e all’innovazione. È condotta con metodi manageriali ma la proprietà di amiglia aggiunge un valore di continuità e di relazioni dirette che ne aumentano l a dabilità nei confronti di partner commerciali, clienti e istituzioni. Oggi è la quarta generazione di Raimondi che garantisce tutto questo.
BEST SELLER
Prodotto: Icon
Plus: Lavapavimenti compatta, silenziosa e sicura, ideale per grandi superfici anche ingombre, ad alta autonomia.

RCM SPA
Via Tiraboschi 4
41043 Casinalbo (MO)
Tel. +39 059 515311
WWW.RCM.IT

RG strumenti è un’azienda che opera da oltre 10 anni nel settore della vendita della strumentazione scientifica per i laboratori d analisi nell’industria alimentare e farmaceutica. I suoi punti di forza sono l’approfondita conoscenza della strumentazione proposta, l’estrema attenzione alle esigenze del cliente, e quindi la capacità di fornire all’interlocutore la strumentazione più idonea alle specifiche necessità RG Strumenti ha da sempre un’attenzione particolare agli strumenti dedicati al monitoraggio dell’igiene ambientale e della salubrità degli alimenti. La stretta collaborazione con la multinazionale Hygiena LTD, di cui è il distributore u ciale in talia, ha atto in modo che RG strumenti sia diventata punto di riferimento nella fornitura di articoli per il controllo dell’igiene aziendale.
BEST SELLER
Prodotto ioluminometro nSure
TOUCH
Plus Strumento per la verifica immediata del livello igienico di una superficie deale per il monitoraggio giornaliero delle pulizie.

RG STRUMENTI SRL
Via Monte Aquila 24/a
43124 Parma (PR)
Tel. +39 0521 631188
WWW.RGSTRUMENTI.IT
Fondata nel 1960, Rubino Chem rappresenta un’eccellenza italiana nel settore chimico, distinguendosi per la ricerca, lo sviluppo e produzione di essenze, detergenti, igienizzanti e disinfettanti per uso domestico e professionale e di polimeri e schiumogeni per uso industriale. Con una rete commerciale ben sviluppata, l’azienda opera sia sul mercato nazionale che internazionale. La sua forza risiede nella capacità di coniugare una solida tradizione con un costante investimento in ricerca e innovazione, dando vita a soluzioni chimiche avanzate e performanti. Tutti i prodotti Rubino Chem sono formulati con materie prime di alta qualità e nel pieno rispetto degli standard ambientali, per rispondere in modo e cace e responsabile alle esigenze del mercato.
BEST SELLER
Prodotto Hi i egreaser Strong
Plus: Sgrassatore ad alta alcalinità che rimuove senza sforzo ogni traccia di grasso, unto, olio e residui carbonizzati.

RUBINO CHEM SRL
Via Vigili del Fuoco Cad. in Serv. 14/S
70026 Modugno (BA)
Tel. +39 080 5035348
WWW.RUBINOCHEM.IT

Syngenta è un’azienda leader a livello globale che impiega 30.000 persone in oltre 90 paesi. Attraverso un’organizzazione dedicata –Syngenta Professional Pest anagement si impegna ad aiutare le persone in tutto il mondo a vivere libere dal fastidio e dai problemi causati dai parassiti e dalle malattie trasmesse da vettori. pera a fianco dei pro essionisti del settore offrendo uno specifico port olio di rodenticidi e insetticidi ad ampio spettro e li mette nelle condizioni migliori per affrontare le sempre nuove ed emergenti sfide e per usufruire delle più avanzate tecnologie industriali.

a oltre anni, sinonimo di innovazione, qualità e a dabilità nel settore delle attrezzature professionali per la pulizia. Fondata con la passione per l’eccellenza, l azienda si distinta fin da subito per il suo impegno nel progettare e sviluppare soluzioni all’avanguardia, pensate per soddisfare le crescenti esigenze di un mercato in continua evoluzione gni prodotto il risultato di un attento processo di ricerca, progettazione e sviluppo, che garantisce tecnologie avanzate, performance elevate e una durata nel tempo. Con un approccio orientato al cliente, continua a rispondere alle sfide di un settore in rapida trasformazione, mantenendo sempre un focus sulla qualità e sull a dabilità nnovazione, passione e impegno la orza di
BEST SELLER
Prodotto: H
BEST SELLER
Nome del prodotto: Advion Gel
Plus: Controllo professionale di scara aggi e ormiche ertificati HACCP per uso nell’industria alimentare e Horeca.

SYNGENTA ITALIA SPA
Viale Fulvio Testi 280/6
20126 Milano
Tel. +39 02 334441
WWW.SYNGENTAPPM.COM/IT
Plus: Carrello multiuso in plastica riciclata, progettato per ospedali, con sistema brevettato Touch Free per sgancio frangia.

VDM SRL
Viale delle Industrie 16/8
20044 Arese (MI)
Tel. +39 02 93581011
WWW.VDM.IT

ebi , rutto dell esperienza consolidata di ebi stituto Biochimico e Bleu Line, due realtà storiche unite oggi sotto il gruppo Leonardo Lifescience Group, è il nuovo brand pensato per il settore Horeca e Cleaning professionale. L’obiettivo è chiaro: garantire ambienti impeccabili, dove ogni dettaglio conta. Con questo spirito, ebi si presenta al mercato con una gamma completa e innovativa di soluzioni che spaziano dalla cura e protezione professionale alla detergenza, dall’igiene della persona alla profumazione degli ambienti ebi si distingue per la qualità e l’innovazione, rafforzata da partnership strategiche che consentono la distribuzione esclusiva dei marchi Bacticyd, eo ue ro essional e ulp o , riconosciuti per le loro elevate prestazioni.
BEST SELLER
Prodotto: eo ue ro essional
Plus: Profumatori bifasici progettati per attivare e migliorare l’umore, eliminano odori e profumano a lungo ogni ambiente.

VEBI ISTITUTO BIOCHIMICO SRL
Via Desman 43
35010 Borgoricco (PD)
Tel. +39 049 9337111
VEBIPRO.IT

We Italia è una società di consulenza e distribuzione di prodotti, servizi e sistemi di Pulizia Professionale. Rappresenta una vasta rete distributiva presente su tutto il territorio nazionale, e a parte di H S, grande gruppo europeo di professionisti del pulito. Le attività di We Italia sono guidate dallo sviluppo sostenibile. Grazie alla capillarità sul territorio, si limitano le emissioni di CO2, garantendo al contempo la tempestività di consegne, consulenza e assistenza. La gamma di prodotti copre ogni tipo di necessità, grazie alla collaborazione con i più qualificati produttori nazionali e internazionali. Insieme ai prodotti colabel ornita assistenza nella certificazione delle imprese servizi a livello nazionale includono noleggio e assistenza per macchinari di tutti i tipi.
BEST SELLER
Nome del prodotto asic
Plus: sciugamano piegato a in fibre rigenerate, un velo, pezzi per cartone colabel, la soluzione per le imprese.

WE ITALIA SRL
Piazza Dei Martiri 1943-1945 1/2
40121 Bologna
Tel. +39 051268601
WWW.WE-ITALIA.IT








































AREE COMUNI E PUBBLICHE AREE CON SERVIZI ALIMENTARI AREE CON
Nel settore Horeca la gestione degli infestanti è una s da quotidiana che richiede prontezza, competenza e rispetto rigoroso delle normative. Ma cosa succede quando a dover scegliere il prodotto giusto sono operatori che non hanno una formazione tecnica specica? Copyr risponde con un’idea semplice e rivoluzionaria: Copyr Color Id, il primo sistema di codi ca cromatica studiato appositamente per sempli care la scelta delle soluzioni di pest management in ambienti professionali.
Grazie a un approccio innovativo e organizzato, Copyr Color Id guida l’operatore nella selezione del prodotto più idoneo per ogni tipo di ambiente, in modo rapido, responsabile e sicuro. Il sistema si basa su un codice colore identi cativo, facilmente riconoscibile, che associa a ciascuna area una categoria cromatica speci ca e intuitiva:
Aree con servizi alimentari. Cucine e zone di preparazione: qui servono prodotti di origine naturale, a bassa residualità, inodori e conformi ai protocolli HACCP.
Aree comuni e pubbliche. Camere, hall e spazi condivisi: soluzioni discrete, ef caci contro infestanti come cimici e acari, senza odori sgradevoli.
Aree con servizi igienici. Dove è necessaria un’azione forte anche in condizioni dif cili, come presenza di umidità o materiale organico.
Aree esterne. Dehor, terrazzi e giardini: prodotti autorizzati per l’esterno, ef caci e rispettosi del verde.
Copyr Color Id si distingue nettamente dai tradizionali codici colore usati nel cleaning professionale, perché introduce il criterio della speci cità ambientale: ogni soluzione è pensata per uno speci co contesto d’uso, facilitando decisioni immediate e corrette, anche per chi non ha una formazione tecnica approfondita.
Il vantaggio per le strutture ricettive e le imprese di Facility Management è doppio: riduzione degli errori e maggiore ef cienza operativa. Il sistema riduce al minimo il rischio di impiegare il prodotto sbagliato e ottimizza il tempo degli operatori, migliorando la qualità del servizio e la soddisfazione dei clienti.
Inoltre, per gli operatori e i governanti, rispettare le procedure in tema di HACCP e le disposizioni di sicurezza è fondamentale. Copyr Color Id garantisce che ogni prodotto utilizzato sia conforme, rendendo più semplice la gestione della sicurezza negli ambienti professionali. Offrire il massimo della protezione per utenti, ospiti e clienti nali. Facile da usare, rapido da implementare, Copyr Color Id è il nuovo alleato del settore Horeca nella lotta contro gli infestanti: un sistema unico, esclusivo, che coniuga innovazione, semplicità e responsabilità.





Espandersi in tutta Europa è l’obiettivo dichiarato dal neopresidente Roberto De Zorzi, alla guida per i prossimi tre anni della federazione che rappresenta le imprese di pulizia e multiservizi a livello internazionale
MAURIZIO PEDRINI
Durante la 67ª Conferenza di FIDEN (Fédération Internationale des Entreprises de Nettoyage), svoltasi a Cagliari dal 19 al 22 settembre, il Consiglio Direttivo ha eletto alla presidenza il veneziano Roberto De Zorzi. L’evento ha riunito rappresentanti di imprese di pulizia e multiservizi provenienti da tutta Europa, offrendo, come da tradizione, un perfetto equilibrio tra momenti di confronto culturale su temi di grande attualità, occasioni di networking informale, svago e scoperta del territorio. Sono state giornate intense e molto partecipate, durante le quali si è discusso di argomenti chiave per il futuro del settore, come l’intelligenza arti ciale e il coinvolgimento della generazione Z nelle aziende. Il neopresidente guarda ora al futuro, con l’obiettivo dichiarato di rafforzare la presenza della Federazione in Europa: «Guardo con grande interesse all’Olanda, alla Svezia, alla Danimarca, ma anche ai Paesi del Baltico e a quelli dei Balcani. Albania, Grecia, Croazia sono Stati che, grazie a un certo benessere, sentono il bisogno di accrescere la loro cultura d’igiene e di una pulizia sempre più mirata». Abbiamo quindi rivolto alcune domande a De Zorzi.
Fra i tanti temi al centro dell’attenzione sui quali si sono confrontati gli associati nell’incontro in Sardegna, due hanno riscosso senz’altro il maggiore interesse,
ovvero quello relativo all’applicazione dell’intelligenza arti ciale nel settore e le prospettive d’impiego nel mondo delle imprese dedite alla pulizia professionale da parte della cosiddetta generazione Z. Cosa può dirci su questi temi?
Il confronto e il dibattito al riguardo è stato ricco e intenso. Si tratta di argomenti che noi imprenditori dobbiamo affrontare con la massima attenzione e coraggio, in quanto rappresentano la situazione di grande cambiamento in atto, che investono il nostro come tanti altri settori. L’IA sta trasformando vari settori, dalle grandi aziende alle piccole imprese e start-up. Nonostante l’adozione sia ancora in fase iniziale nelle PMI, il potenziale dell’IA per innovare, ottimizzare e migliorare le operazioni è enorme. Studi e casi pratici mostrano come l’IA possa diventare un alleato strategico per la crescita e la redditività. Per quanto riguarda il secondo punto della sua domanda, è emerso come negli ultimi anni, il dibattito attorno ai giovani della generazione Z si sia notevolmente acceso, spesso concentrandosi sui loro presunti limiti in ambito lavorativo. In particolare, negli Stati Uniti si è assistito a un fenomeno crescente di licenziamenti tra i giovani dipendenti, attribuiti a fattori come la mancanza di motivazione, dif coltà nel problem solving e scarso allineamento culturale con le aziende. Credo che, anche se tali dinami-

Nato a Venezia il 12 marzo 1960, si è affermato quale brillante imprenditore nel settore dei servizi rivolti al professional cleaning. Nel 1986 ha fondato Procyon, società cooperativa di Facility Management, una delle prime sorte nel nostro Paese. Nel 2002 ha costituito Iniziative Venete Group, con sede a Venezia, società cooperativa operante in Italia e nei Paesi dei Balcani nell’ambito servizi B2B a imprese private europee impegnate nell’ospitalità alberghiera. Il Gruppo è partner di organizzazioni che promuovono grandi eventi culturali ed enti locali che erogano servizi alla collettività. De Zorzi è Presidente di FIDEN, Federazione europea che offre una piattaforma di formazione professionale e crescita culturale finalizzata alla cultura del pulito a tutte le piccole e medie imprese e imprenditori attivi in ambito continentale nel settore della pulizia industriale e del Facility Management.
che non siano ancora così marcate in Italia, sia importante ri ettere sulle implicazioni e su come le aziende, in particolare le PMI, possano trasformare una criticità in un’opportunità, grazie al welfare aziendale. In sostanza, il dibattito sui giovani della Gen Z non deve trasformarsi in una condanna, ma in un’opportunità per ri ettere su come costruire un mondo del lavoro più inclusivo e sostenibile.
Dunque, è richiesta una mentalità aperta all’innovazione e al cambiamento anche da parte delle imprese di pulizia italiane ed europee? Le novità ci sono sempre state e vanno recepite con intelligenza da parte delle aziende, adeguandosi passo dopo passo al cambiamento. L’IA, ben guidata dal pensiero umano, avrà straordinari campi d’applicazione a supporto degli operatori addetti al nostro settore. Penso anche al turismo, alle aziende, allo stesso internet. La nostra generazione è passata dall’uso dell’enciclopedia Treccani per accedere a un’informazione, alla ricerca su Internet tramite la parola chiave, alla chat GPT che, tramite l’algoritmo ci ha aperto nuovi, sterminati orizzonti. Insomma, siamo destinati alla costruzione di un nuovo sistema di domande, richieste e ricerche per disporre facilmente di risposte sempre più veloci, complete e mirate. È normale che tutto ciò accada nella vita delle nostre aziende.
Tornando al capitolo giovani, lei non è preoccupato che si trovino sempre meno giovani italiani disposti a lavorare nel settore delle imprese di pulizia e servizi?
Credo che, in realtà, il problema sia abbastanza relativo: conosco molti nostri giovani che si rimboccano le maniche e si dedicano con passione al lavoro delle pulizie e dei servizi, anche se - come ben sappiamo - non è abbastanza riconosciuto e valorizzato, anche sul piano economico.

NELL’AMBITO DELLA
PULIZIA SPECIALIZZATA
E DEL MULTISERVIZIO
Quanto all’insofferenza, o al disagio delle giovani generazioni nel portare avanti certi lavori, ricordo che io stesso mettevo in discussione i miei genitori come oggi i miei gli lo fanno con me e poi, avverrà la stessa cosa con i loro gli. È qualcosa di ciclico e siologico, a cui dobbiamo rassegnarci. Le aziende devono essere pronte e recepire i segnali di quando cominci a invecchiare. Io stesso sto prendendo coscienza delle mie dif coltà e vedo con grande favore l’ingresso dei miei gli ai posti di responsabilità. Alla conferenza ho seguito
con interesse l’intervento di quel relatore che spiegava di aver iniziato ad usare il PC a sei anni; noi abbiamo iniziato ad usarlo a trentacinque - quarant’anni, quando eravamo già vecchi. Il fatto che oggi i ragazzi siano smart tempestivi è naturale: noi non potremo mai raggiungerli. L’alternativa è tra l’adattarsi a questo mondo digitale o restare tagliati fuori.
Guardando al mondo delle imprese che si proiettano dalle pulizie al facility in una prospettiva europea, sappiamo che FIDEN offre un prezioso punto di riferimento culturale a supporto di questo processo, in vista di un’unione in ambito europeo che non sia solo di facciata: cosa insegna la vostra esperienza al mercato?
Anzitutto che non ci sono con ni. Ti sposti e viaggi con grande facilità in Europa perché i confini si sono molto allargati. Inoltre è importante valutare insieme i problemi, comprendere come i partner europei li affrontano, pur tenendo presente che le differenze a livello di Sistema Paese sono ancora profonde, specie a livello burocratico, legislativo ed economico. Attualmente nel Vecchio Continente esistono situazioni che meritano di essere prese come riferimento, mentre in passato guardavamo tutti con grande venerazione agli USA. Francia, Germania, Austria hanno sicuramente qualcosa da insegnarci e viceversa. Qualche tempo fa, ho letto sulla sua rivista l’interessante intervista da lei fatta a Oscar Farinetti, nella quale il noto imprenditore e manager affermava un concetto che condivido pienamente, perché ritengo che l’Italia sia davvero un Paese tra i più ricchi di risorse al mondo: basti pensare ai beni culturali, alla moda, all’enogastronomia, al design e in tanti altri campi. Anche nel nostro comparto, possiamo senz’altro comunicare alle imprese di pulizie e servizi di tutta Europa, qualche interessante inno-
vazione, condividendo il nostro know how. Insomma possiamo esportare conoscenze e valori importanti, di cui andare eri, ma dobbiamo esserne convinti. È giusto che in Europa esista un’associazione che dia voce ad un settore, purtroppo visto ancora come di serie B. Purtroppo, ancora molti quasi si vergognano a dire che ne fanno parte.
Parlando dell’Italia nel contesto continentale cosa può insegnarci un’esperienza come quella della FIDEN?
Ricordo che in una precedente intervista lei poneva al presidente europeo dell’associazione, che allora era tedesco, quali fossero le differenze maggiormente signi cative tra il contesto italiano e quello tedesco.
Certamente, i nostri amici d’Oltralpe operano in un quadro normativo nel quale le regole sono molto più ferree. Pensiamo, per esempio, alla sicurezza nei cantieri delle pulizie: da loro non si scherza, mentre qui in Italia troppo spesso le disposizioni legislative non vengono purtroppo rispettate, ma non succede nulla. Anche nell’ambito dei servizi di sani cazione e Facility Management siamo in presenza di aziende che, con il loro scorretto operare, hanno rovinato il mercato.
In altri Paesi europei, specie in Austria e Germania, le imprese di pulizia e FM dimostrano anche di saper fare meglio di noi, un gioco di squadra: è vero?
Certamente, direi che sanno fare lobbying tra di loro: l’esatto contrario di quanto avviene per noi italiani. In altre parole sono capaci di far leva su comuni interessi, riuscendo a esercitare una sorta di pressione verso i governi e le altre realtà economiche sulle quali intendono incidere. Per esempio, ciò avviene nella gare d’appalto con gli enti pubblici: quando si presentano agli interlocutori della PA, le imprese di pulizia e multiservizi hanno estremo rispetto dei
costi e, pur lavorando con budget molto più elevati, possono contare sul vantaggio di un costo della manodopera nettamente inferiore al nostro. In alcuni Paesi non esiste neppure la quattordicesima mensilità per i dipendenti e l’esborso di denaro da parte del datore di lavoro per un licenziamento è nettamente inferiore al nostro, come pure gli oneri accessori e previdenziali. Per tutte queste ragioni, i nostri amici di alcuni Stati europei riescono a vendere offerte prodotti ad un prezzo assai più elevato del nostro. Insomma, un motivo per chiedere con forza che da noi la lotta alle aziende spurie, attive quotidianamente nella concorrenza sleale, debba essere svolta da parte del Governo con grande determinazione, usando tutti i mezzi a disposizione, a partire da rigorosi controlli ispettivi.
Veniamo agli obiettivi che sta portando avanti con la sua presidenza: quali sono le priorità al centro del suo impegno? Il mio predecessore, Hans Ziegle che ringrazio, si è molto impegnato durante il suo mandato ad ampliare la rappresentanza delle imprese europee in seno alla Federazione. Durante il triennio nel quale sarò presidente il mio ruolo sarà quello di cercare di ampliare ulteriormente, non solo in Italia ma anche in Europa, questa rappresentanza. So che non sarà un compito facile nel nostro Paese, proprio per le difcoltà di cui accennavo in precedenza, ma farò certamente del mio meglio avvicinando quegli imprenditori che condividono la nostra mission, in modo da contare molto di più ed avere una degna rappresentanza a tutti i livelli istituzionali, in particolare al Parlamento Europeo, perché questa associazione rappresenta culturalmente e professionalmente imprese sane, produttive e desiderose di creare lavoro e ricchezza nell’ambito della pulizia specializzata e del multiservizio. È giusto che questa voce sia ascoltata e possa far valere le sue richieste.
Punterò anche a ricucire possibilmente lo strappo che si è creato qualche anno fa, a seguito di piccole rivalità, con i colleghi francesi, che pure sono stati tra i padri fondatori del nostro sodalizio e rappresentano una realtà assai significativa. Spero che guardando al futuro del cleaning si possano ritrovare serenità e spirito di collaborazione. Ma non solo: penso siano molto interessanti, per un’eventuale espansione della nostra presenza, anche l’Olanda, la Svezia e la Danimarca - anche i Paesi del Baltico e quelli dei Balcani. Quelli che ho elencato, insieme ad Albania, Grecia e Croazia, sono Stati europei che, grazie ad aver raggiunto un certo benessere, sentono il bisogno di accrescere la loro cultura d’igiene e di una pulizia sempre più mirata. Un ultimo elemento di ri essione che mi induce all’ottimismo è che in Europa e nel mondo intero assisteremo ad una progressiva carenza di manodopera per cui crescerà in modo esponenziale l’esternalizzazione dei servizi. Nel nostro settore si creerà tanta nuova occupazione, della quale potranno godere senz’altro le imprese più preparate e attente all’innovazione.
Insomma, la vostra Federazione è viva e punta a crescere nell’immediato futuro? Certamente, al nostro interno non sono associate solo imprese di pulizia, ma anche produttori di macchine, attrezzature e prodotti: fornitori con i quali il confronto è sempre utile e portatore di vantaggi reciproci. Credo che questa identità rappresenti un valore aggiunto per creare partnership e sinergie tra esponenti della stessa liera, pur avendo magari interessi diversi. Indubbiamente, uno dei primi bene ci è proprio quello di contenere e razionalizzare i costi da entrambe le parti. Per incrementare lo spirito associativo e farci conoscere in Europa, sto anche pensando di organizzare degli incontri nei vari Paesi potenzialmente interessati alla nostra presenza.


La Divisione Cosmetica Professionale di Italchimica lancia Beauty
Escape, nuova linea cortesia che eleva l’esperienza degli ospiti e supporta le strutture ricettive nel percorso verso una gestione sostenibile. Progettata per ridurre il monouso della plastica, Beauty Escape si distingue per un approccio green, che si concretizza in aconi ricaricabili eleganti e funzionali e ricariche in materiale a prevalenza cellulosica. Le ricariche da 1 litro sono realizzate con carta certi cata FSC e sono riciclabili secondo la normativa Aticelca, contribuendo a limitare sia lo spreco di materiali che quello di prodotto. Una scelta ideale per le strutture che desiderano coniugare sostenibilità e raf natezza, rispondendo alla crescente attenzione ambientale degli ospiti.
Beauty Escape nasce ad Abano Terme, luogo simbolico del benessere e della cura di sé, frequentato da un turismo internazionale alla ricerca di charme e autenticità. L’ispirazione prende forma in una villa veneta, l rouge del concept della linea: una collezione dedi-

cata all’hotellerie, che valorizza l’identità italiana con eleganza e attenzione alla sostenibilità.
La linea include bagnoschiuma, sapone mani, shampoo, balsamo e crema corpo, con formulazioni arricchite da ingredienti d’eccellenza: acido ialuronico, glicerina, pantenolo, vitamina E e oli naturali per nutrire e proteggere la pelle e i capelli. Comprende anche prodotti certi cati Ecolabel, garanzia di formulazioni eco-compatibili e delicate sulla pelle.
Le fragranze esclusive, sviluppate in collaborazione con importanti case profumiere, creano un’esperienza olfattiva memorabile. Dall’energia agrumata e oreale di Atlantis, alla sensualità speziata di Afrodite, no alla freschezza aromatica di Setai e alle note fruttate- oreali di Arbory, ogni profumo racconta un’identità unica, capace di rafforzare il posizionamento dell’hotel.
Il design dei aconi è stato curato per offrire massima funzionalità ed estetica: i dispenser di Atlantis e Afrodite possono essere utilizzati sia appoggiati sia ssati con staffe eleganti, garantendo praticità e inviolabilità. Le linee Arbory e Setai, invece, propongono cartucce squeezable sostituibili, ideali per ottimizzare i consumi e garantire sicurezza igienica.
Completano la gamma i profumatori per ambienti adatti anche alla profumazione di tessuti, moquette e tappeti: una soluzione perfetta per creare un lo conduttore olfattivo coerente in ogni spazio della struttura.
Beauty Escape rappresenta una nuova visione della cosmesi cortesia per l’hospitality, pensata per quelle strutture alberghiere che vogliono offrire ai propri ospiti un soggiorno indimenticabile, valorizzando ogni dettaglio, dalla fragranza alla texture, dal design alla sostenibilità.


















L’obiettivo
del Piano Transizione applicato all’industria 5.0 è quello di creare processi più personalizzati, efficienti e sostenibili, unendo il meglio delle capacità umane e tecnologiche
Il credito d’imposta 5.0 è uno strumento fiscale che permette alle imprese di recuperare parte delle spese sostenute per investimenti in beni strumentali, materiali e immateriali, che siano legati all innovazione tecnologica uesto incentivo stato creato per incoraggiare le aziende italiane a investire in soluzioni tecnologiche avanzate, in grado di migliorare i processi produttivi, aumentare la competitività e a rontare le sfide della sostenibilità ambientale e della transizione digitale
Il Piano Transizione 5.0 punta a rendere le imprese più competitive e a ridurne l’impatto ambientale grazie a investimenti in tecnologie all’avanguardia e alla formazione del personale. Rientrano nel piano tre tipologie di tecnologie: i beni strumentali materiali, costituiti da macchinari e attrezzature avanzate, sistemi di automazione industriale e dispositivi per il controllo e il monitoraggio dei processi basati su tecnologie IoT. I beni immateriali, rappresentati da software avanzati, piattaforme digitali, soluzioni di intelligenza arti ciale e sistemi di analisi dei dati (big data). In ne, le tecnologie legate alla sostenibilità, volte a migliorare l’ef cienza energetica, ridurre le emissioni di carbonio e promuovere l’economia circolare.
QUALI BENEFICI?
L’agevolazione consiste in un credito d’imposta la cui percentuale varia a seconda del risparmio energetico che gli investimenti
agevolabili permettono di ottenere in base a una serie di parametri riportati in Tabella 1. Il Piano Transizione 5.0 è cumulabile con tutte le agevolazioni, comprese quelle nanziate con fondi europei, e anche con il credito d’imposta ZES (zona economica speciale per il Mezzogiorno).
A differenza del credito d’imposta 4.0, l’agevolazione 5.0 dovrà essere obbligatoriamente prenotata sulla sezione dedicata del portale del GSE tramite una procedura che prevede una certi cazione ex ante (prima dell’investimento) che potrà essere redatta solo ed esclusivamente da certi catori abilitati (Art. 38 – Comma 11 Legge 56 del 29 Aprile 2024).
L’industria 5.0 è un’opportunità che introdurrà cambiamenti tangibili nel settore logistico, attraverso applicazioni mirate per l’ef cienza e la sicurezza. Nell’ambito
Se il focus di Industria 4.0 era centrato sull automazione e la digitalizzazione dei processi attraverso l utilizzo di tecnologie come, per esempio, l nternet o hings o , ndustria punta a integrare la tecnologia non solo per rendere le aziende più e cienti, ma per creare un ambiente di lavoro in cui l uomo e la macchina interagiscono in modo più armonioso e con una maggiore attenzione alla sostenibilità ambientale, con l’obiettivo di ridurre l impatto ecologico delle attività
dell’automazione del trasporto merci, l’adozione di carrelli automatici AGV (Veicoli a Guida Automatica) e di robot automatizzati AMR (Robot Mobili Autonomi) nei magazzini è in grado di trasformare il settore. Questi mezzi automatizzano il trasporto interno, migliorando l’ef cienza e riducendo il rischio di errori.
I software WMS di gestione della supply chain, potenziati dall’intelligenza arti ciale, permettono una gestione avanzata delle
Risparmio energetico di almeno il 3% dei consumi energetici dell’unità produttiva oppure di almeno il 5% dei consumi energetici dei processi produttivi
Risparmio energetico di almeno il 6% dei consumi energetici dell’unità produttiva oppure di almeno il 10% dei consumi energetici dei processi produttivi
Risparmio energetico di almeno il 10% dei consumi energetici dell’unità produttiva oppure di almeno il 15% dei consumi energetici dei processi produttivi
scorte attraverso un controllo più preciso e una piani cazione ottimizzata, riducendo gli sprechi e migliorando la risposta alle uttuazioni del mercato.
L’implementazione di sensori e software consente di fare passi avanti nel campo della manutenzione predittiva, monitorando lo stato dei macchinari in tempo reale, prevenendo guasti e riducendo i tempi di fermo.
L’introduzione di sistemi automatizzati per il picking e l’imballaggio ottimizza e accelera questi processi, aumentando la precisione e alleggerendo il carico di lavoro sico dei dipendenti. L’adozione di tecnologie come sistemi di lettura dei barcode, dei QR code o dei tag RFID sui carrelli elevatori migliora notevolmente la tracciabilità e la gestione dell’inventario, offrendo una visione chiara e aggiornata delle scorte.
L’automazione e l’ottimizzazione della preparazione degli ordini, supportate da software intelligenti, sono in grado di migliorare la velocità e l’accuratezza nel soddisfare le richieste dei clienti. In ne, non bisogna dimenticare le opportunità nel campo dell’analisi dei dati avanzata. L’uso di strumenti di analisi dei dati e di business intelligence fornisce dati indispensabili per ottimizzare le operazioni,
Fonte: mimit.gov.it/it
prevedere le tendenze di mercato e prendere decisioni.
Queste applicazioni speci che dell’industria 5.0 stanno portando il settore logistico verso un futuro più ef ciente, sicuro e sostenibile, sfruttando al meglio le potenzialità offerte dalla tecnologia avanzata con un focus importante verso la responsabilità e sostenibilità ambientale, attraverso, per esempio, l’utilizzo di forme di energia alternativa, quali carrelli elevatori con batterie al litio in sostituzione di quelli termici e la promozione di pratiche sostenibili. Per accedere alle agevolazioni scali, a tale impostazione va inoltre aggiunto un ulteriore elemento riconducibile ai concetti di etica e sicurezza, ponendo un’importante enfasi sul benessere dei lavoratori, attraverso la realizzazione di un ambiente di lavoro sicuro e soddisfacente, ove gli addetti sono valorizzati e sono parte integrante dei processi interni.
NUOVE FIGURE PROFESSIONALI
L’approccio e la gestione nella logistica 5.0 richiederà per le aziende più strutturate la creazione di alcune gure professionali speci che. Tra queste troviamo il manager della sostenibilità, che si occupa di svilup-
pare e implementare strategie aziendali volte a ridurre l’impatto ambientale e promuovere la sostenibilità. Oltre a monitorare il rispetto delle normative ambientali, ottimizza l’uso delle risorse e sensibilizza i dipendenti verso pratiche più sostenibili, garantendo un equilibrio tra responsabilità sociale, ambientale e obiettivi economici. Un’altra gura sarà il manager dell’energia che si occuperà di gestire l’ef cienza energetica di un’organizzazione. Il suo ruolo include l’analisi dei consumi energetici, la piani cazione di interventi per ridurre sprechi/costi e la transizione verso l’uso di fonti energetiche rinnovabili. È spesso coinvolto nella de nizione di politiche energetiche aziendali e nel rispetto delle normative in materia di energia.
L’attenzione generale sul Piano Transizione 5.0 ha una giusti cazione più che valida, rappresentata dal bene cio potenziale signi cativamente superiore a quello offerto dalla versione 4.0. L’impegno derivante da procedure e oneri burocratici, dalle certicazioni, comunicazioni e rendicontazioni è però decisamente più stringente. Inoltre, i tempi a disposizione sono decisamente minori; infatti tutte le pratiche, comprese quelle dell’interconnessione alle quali fa riferimento il 4.0, devono essere terminate entro il 31 dicembre 2025. Detto questo, il Piano Transizione 5.0 è una opportunità se si è de nito un progetto di investimento che produce risparmio energetico, con una cospicua introduzione di rinnovabili, e un sistema aziendale di misurazione consolidato. Diversamente, anche per evitare problematiche e sanzioni, Industria 4.0 è ancora una possibilità, seppur minore in termini di bene ci scali, che può essere di aiuto.
Articolo già pubblicato su Blu&Rosso, qui ripreso per gentile concessione.
GLOBALE,PROFESSIONALE
La più grande rete italiana nella distribuzione di prodotti, servizi e sistemi di Pulizia Professionale. Parte integrante di DHYS, gruppo europeo leader nel settore Cleaning.
229MLN fatturato
35 sedi in Italia

Consegne rapide grazie ai nostri 35 magazzini di prossimità, anche in provincia e in zone difficilmente raggiungibili
I nostri servizi a livello nazionale includono il noleggio di macchinari di varie tipologie
CONSULENZA E FORMAZIONE PER TUTTE LE SEDI
Assistenza tecnica tempestiva e consulenza dedicata su tutto il territorio, grazie ai nostri referenti in loco
ATTENZIONE ALL’AMBIENTE
Proponiamo all’interno del nostro listino numerosi prodotti Ecolabel e forniamo assistenza nella certificazione dell’Azienda
358 consulenti al tuo servizio

149 mezzi propri
86K mq di magazzini
Padiglione 12 Stand E09 E17 F10 F18
DANIELE CARLI
L’iter di Legge sulla normazione dell’utilizzo dell’Intelligenza Artificiale in Italia ha ottenuto, nel marzo scorso, il via libera dal Senato. Dopo l’approvazione anche da parte della Camera diventerà esecutiva.
L’Italia si avvia così a recepire le indicazioni dell’AI ACT dell’UE
Il 20 marzo scorso il Senato della Repubblica ha approvato il Disegno di Legge in materia di Intelligenza Arti ciale. È il primo tassello nel quadro di introduzione nel nostro Paese di una disposizione regolatoria sull’utilizzo dell’AI. Il provvedimento, collegato alla manovra, passa ora all’esame della Camera dei Deputati per la seconda e ultima tappa del processo di approvazione de nitiva. Dopo l’intervento normativo a livello europeo, con l’introduzione dell’AI ACT, tocca infatti ai singoli Paesi recepire nei loro sistemi legislativi la disposizione comunitaria. E in questo percorso, l’Italia si propone di essere il primo Paese nell’UE a disciplinare l’implementazione di questa tecnologia.
GLI OBIETTIVI DEL PIANO
L’iter della normazione nazionale è partito il 23 aprile dello scorso anno, quando il Consiglio dei Ministri ha approvato un Disegno di Legge con il quale il Governo italiano si proponeva di armonizzare la legislazione nazionale in ottemperanza
all’approvazione dell’AI ACT da parte della Commissione Europea. Il Disegno di Legge 1146 è composto da 26 articoli con l’obiettivo di promuovere il pieno sfruttamento delle potenzialità dell’AI mediante un utilizzo più responsabile, senza compromettere la sicurezza e i diritti individuali. Recependo le linee guide dell’AI ACT proposto dalla Commissione Europea, viene introdotto un approccio basato sul rischio, distinguendo i sistemi di Intelligenza Arti ciale in quattro categorie: rischio inaccettabile (tecnologie vietate, come sistemi di sorveglianza massiva), alto rischio (AI utilizzata in settori critici come sanità, giustizia e infrastrutture), rischio limitato (strumenti di AI che richiedono trasparenza, come chatbot) e rischio minimo (applicazioni a basso impatto, come i ltri di posta indesiderata). Diverse sono le s de che il percorso di normazione dell’AI in Italia si pone: bilanciare innovazione e protezione dei diritti per evitare discriminazioni e garantire trasparenza, formare professionisti specializzati investendo in istruzione e
ricerca per creare esperti in AI, sviluppare infrastrutture tecnologiche per migliorare le capacità di calcolo e la connessione digitale nel Paese.
Proprio in questo quadro sfidante, l’Italia sta muovendosi anche su altri binari con iniziative collaterali di investimenti, sia in formazione sia infrastrutturali, come il Piano Nazionale di Ripresa e Resilienza
04 / 2025

(Pnrr), che dedica dei capitoli di spesa alla ricerca e sviluppo nell’AI, e il Comitato Interministeriale per la Transizione Digitale, che definisce le strategie nazionali. Seppure nel nostro Paese la regolamentazione dell’utilizzo dell’AI sia ancora in fase di approvazione, esistono però già delle normative che disciplinano in parte il settore. Il Gdpr (regolamento generale sulla protezione dei dati) impone regole severe sull’uso dei dati personali nei sistemi di AI. Il codice dell’amministrazione digitale (CAD) promuove l’uso dell’AI nella pubblica amministrazione garantendo trasparenza e sicurezza. Il Decreto Legge sulla cybersicurezza stabilisce norme sulla protezione dei dati e sulla sicurezza informatica dei sistemi basati su AI.


La regolamentazione dell’AI in Cina è caratterizzata attualmente da un sistema normativo frammentato, basato su regolamenti settoriali piuttosto che su una legge unitaria, mirando a bilanciare lo sviluppo tecnologico con il controllo normativo e imponendo obblighi stringenti ai fornitori di servizi di AI. Anche se non esiste ancora una normativa equivalente all rtificial ntelligence europeo, però, nel Paese del Dragone è in fase di studio un regolamento generale sul tema. Il Ministero dell’Industria cinese ha emesso linee guida preliminari per standardizzare l’industria dell ntelligenza rtificiale la bozza propone di ormare più di standard nazionali e di settore entro il , oltre a partecipare alla ormazione di più di standard internazionali entro quel periodo Contemporaneamente, la Cass (Chinese Academy of Social Sciences), un’associazione di accademici indipendenti che ha un peso molto rilevante nell’attività legislativa in Cina, ha avanzato una proposta di legge in tema di AI cinese che si caratterizza, come l’AI europeo, per la centralità di una lista di sistemi di ad alto rischio che dovrebbero essere approvati dalle autorità prima di poter essere immessi nel mercato. el , intanto, in ina entrata in vigore una normativa riguardante l ntelligenza rtificiale enerativa, sancita dalla Cyberspace Administration of China. Denominata “Measures or enerative rtificial ntelligence Services , questa regolamentazione mira specificatamente all enerativa, delineando un ambito di applicazione preciso e differenziato rispetto all ntelligenza rtificiale in generale
Come in Cina, e a differenza dell’UE, in questi anni gli Stati Uniti hanno adottato normative che si concentrano su specifici settori o utilizzi dell’AI piuttosto che su un unica regolamentazione l ottobre il presidente oe Biden ha emanato l’Executive Order (EO) sul tema dello “Sviluppo e uso sicuro, protetto e a dabile dell ntelligenza rtificiale Sa e, Secure, and rust orth evelopment and se o rtificial Intelligence). L’obiettivo principale dell’EO era quello di stabilire un approccio coordinato a livello di overno ederale per lo sviluppo e l’implementazione di questa tecnologia, cercando di bilanciare la promozione dell’innovazione con la necessità di garantire la sicurezza, la protezione e la fiducia nelle applicazioni di ntelligenza rtificiale si estende su vari ambiti dalla sicurezza nazionale alla protezione dei diritti civili e dei lavoratori, dall’innovazione e competitività fino alla privac degli americani n sostanza, questo Executive Order segna un passo importante verso un approccio più strutturato e coordinato all’AI, riconoscendo sia le sue potenzialità sia i rischi associati. All’inizio del suo mandato, Donald rump ha abrogato l ecutive rder, considerandolo troppo rigido e limitativo dello sviluppo di tecnologie innovative, in linea con la sua filosofia di deregolamentazione e di riduzione delle interferenze governative nel settore privato.
UN MILIARDO DI INVESTIMENTI
Il piano normativo che sta seguendo l’iter parlamentare si fonda su tre macro-obiettivi: investire nella ricerca scienti ca sull’AI, promuovere la collaborazione tra diverse competenze e sostenere un piano per trattenere e attirare i talenti; valorizzare la ricerca applicata dell’AI, attraverso iniziative co-progettate da partenariati pubblico-privati; nanziare alcuni progetti pilota su scala nazionale.
È prevista l’introduzione della ‘Strategia nazionale per l’Intelligenza Artificiale’, dettando disposizioni in materia, che deve essere aggiornata e approvata con cadenza almeno biennale dal Comitato Interministeriale per la Transizione Digitale. La strategia nazionale deve mirare a favorire la collaborazione tra le amministrazioni pubbliche e i soggetti privati relativamente allo sviluppo e all’adozione di sistemi di Intelligenza Arti ciale, coordinare l’attività della pubblica amministrazione in materia, promuovere la ricerca e la diffusione della conoscenza in tema di AI, indirizzare le misure e gli incentivi nalizzati allo sviluppo imprenditoriale e industriale della tecnologia. Sono, inoltre, introdotte le Autorità Nazionali per l’Intelligenza Articiale, quali l’Agenzia per l’Italia Digitale (AgID) e l’Agenzia per la Cybersicurezza Nazionale (ACN). Queste assumeranno un ruolo fondamentale nel garantire il rispetto delle normative e nell’istituire spazi di sperimentazione per promuovere l’innovazione.
Il Governo ha stanziato un miliardo di euro, attraverso Sgr CdP Venture Capital, nel capitale di rischio di imprese che operano in Italia per incentivare progetti in ambito di AI, cybersicurezza, tecnologie quantistiche e telecomunicazioni, oltre a prevedere agevolazioni fiscali per i ricercatori che scelgono di lavorare o tornare in Italia in questo contesto. Sono previsti 600 milioni di euro per progetti rivolti ai servizi forniti dal ministero degli Affari Esteri a cittadini e imprese.
Il Disegno di Legge prevede anche lo svi-
luppo di tre ‘Large Multimodal Model’ italiani che si focalizzino su speci ci domini applicativi in cui l’Italia detiene una forte riconoscibilità internazionale. Ma anche implementare progetti interdisciplinari dispiegando iniziative competitive ispirate ai synergy grants ERC, nanziare la ricerca fondazionale e blue-sky per l’AI di prossima generazione, potenziare le collaborazioni internazionali nanziando programmi di ricerca centrati sull’AI e promossi in partenariato con università e centri di ricerca internazionali.
Sono previste anche misure a sostegno della formazione dei giovani, in particolare per l’acquisizione di nuove competenze in materia di utilizzo dell’AI. Viene richiamata l’attenzione sia su quella a livello universitario che su quella nelle scuole secondarie. Nel primo caso, per promuovere una formazione universitaria capillare sull’AI, consolidarne la formazione specialistica nei percorsi orientati verso pro li tecnici e di ricercatori, quali il Dottorato Nazionale sull’Intelligenza Arti ciale. Nel secondo caso, di realizzare percorsi educativi sull’AI nelle scuole, sviluppare iniziative di divulgazione mirate a sensibilizzare e coinvolgere la società italiana nella rivoluzione dell’Intelligenza Arti ciale; nanziare e sostenere iniziative di reskilling e upskilling in tutti i contesti produttivi. Per rendere ef cace l’attuazione della strategia di formazione, si propone la creazione di una Fondazione per l’AI, che avrà il compito di coordinare le diverse azioni, gestire i fondi dedicati e monitorare i progressi ottenuti.
Non solo l’Italia. A livello europeo, anche Francia e Germania stanno portando avanti strategie ambiziose per lo sviluppo dell’AI. In Germania, il Piano d’Azione del Bmbf (Bundesministerium für Bildung und Forschung – il Ministero Federale dell’Istruzione e della Ricerca Scienti ca) sull’In-
telligenza Arti ciale mira a dare un nuovo slancio all’ecosistema AI tedesco partendo dal presupposto che occorra caratterizzarlo con peculiarità Made in Germany. Dal 2018, la Germania ha ampliato signi cativamente gli investimenti in materia, con un budget annuale del Bmbf aumentato di oltre venti volte dal 2017. Il piano prevede almeno 20 nuove iniziative che si aggiungono alle 50 misure già in corso, con un forte focus sulla ricerca, lo sviluppo delle competenze, la costruzione di infrastrutture e il trasferimento tecnologico.
La Francia, attraverso il rapporto ‘IA: notre ambition pour la France’, presentato il 15 marzo 2024, propone 25 raccomandazioni per cogliere le opportunità offerte dall’’Intelligenza Artificiale. Il piano d’azione francese si concentra su sei settori principali: formazione, salute, sicurezza, sviluppo economico, trasparenza ambientale e governance. Le raccomandazioni mirano a promuovere la ricerca e l’innovazione, migliorare l’adozione dell’IA nelle PMI, e garantire un utilizzo etico e trasparente delle tecnologie AI.
Confrontando le strategie italiana, francese e tedesca emergono elementi comuni ma anche differenti peculiarità. Tutte e tre condividono l’obiettivo di posizionare i rispettivi Paesi come leader nell’innovazione AI, la formazione e il reskilling della forza lavoro sono elementi centrali in tutte, come pure il miglioramento dell’accesso a infrastrutture di calcolo avanzate e a facilitare la standardizzazione e l’accesso ai dati. In ne, la regolamentazione etica è una preoccupazione condivisa. Le principali differenze riguardano il contesto di riferimento e il focus tematico. La strategia italiana si sviluppa in un contesto normativo più in uenzato dall’AI ACT dell’UE, quindi con un focus sull’armonizzazione delle normative. La strategia francese pone più l’accento sulla sovranità tecnologica e l’autonomia strategica. Il piano tedesco, invece, si indirizza più sul trasferimento tecnologico e l’integrazione nei processi produttivi industriali.
A colloquio con Angelo Volpe, eletto alla guida nazionale di ANIP Confindustria. Tre le priorità fondamentali, al centro del mandato, il benessere delle persone, la competitività delle imprese e la valorizzazione del settore
MAURIZIO PEDRINI
ANIP-Con ndustria ha recentemente eletto al vertice del sodalizio Angelo Volpe, un manager assai apprezzato nel settore. Denita anche la squadra del Consiglio di Presidenza che, insieme al segretario generale, Barbara Fiorucci, af ancherà il presidente Volpe nei prossimi quattro anni, con la nomina dei vicepresidenti Paolo Cardino, Marzia Giuliani, Renato Spotti, Alberto Tavano Colussi e Floriana Tomassetti. Il neopresidente Angelo Volpe ha accolto
con grande disponibilità la nostra richiesta di poterlo intervistare sugli obiettivi del suo mandato e sui grandi temi che investono il futuro di un comparto il cui “peso” economico e sociale sta diventando sempre più rilevante nel nostro Paese.
Come è maturata la sua nomina alla Presidenza di ANIP Con ndustria? Se lo aspettava?
Fino a un anno e mezzo fa non avrei im-
maginato di poter essere chiamato a ricoprire questo incarico. Tuttavia, ho accolto con grande senso di responsabilità l’invito dei colleghi, nato dall’esigenza di portare all’interno dell’associazione una visione nuova, più attenta ai cambiamenti del mercato e in grado di rappresentare in modo equilibrato e incisivo le esigenze delle imprese operanti sia nel settore pubblico che in quello privato. Ritengo che la mia esperienza pluriennale nel comparto, unita


Nato a Bari nel 1969 è un imprenditore e manager specializzato nel settore del acilit management lla fine degli anni terminati gli studi entra ne a ucente pa dove muove i primi passi all interno dei principali dipartimenti a iendali fino a divenire irettore ommerciale ercato rivato e a seguire nel irigente con l incarico di irettore dei apporti stitu ionali e ndustriali a luglio ricopre il ruolo di onsigliere di mministra ione e nel gennaio viene nominato ruolo ricon ermatogli anc e per il triennio successivo tutto ci a valle di un articolato e complesso passaggio di testimone c e a visto l ingresso della ter a genera ione in a ienda e la parallela e non meno decisiva tras orma ione del sistema di governance da monocratico a collegiale lui si devono una peculiare atten ione ai temi della orporate ocial esponsi ilit nuove prospettive commerciali di sviluppo anc e in am ito europeo un forte impulso alla comunicazione e alla digitali a ione in un contesto di pro ondi cam iamenti della società. Ha saputo rispondere con determinazione e resilienza a sfide epocali come il post covid e la crisi energetica anc e gra ie all introdu ione di nuove modalit organi ative del lavoro uali un piano strutturato di lavoro agile e essi ile orientato al miglioramento del or li e alance ali politic e anno contri uito all importante crescita della societ sia a livello occupa ionale c e di atturato portando all ottenimento di numerosi riconoscimenti certifica ioni e rating s sen a tralasciare gli investimenti in ini iative di sviluppo sosteni ile e politic e am ientali on meno incisivo il suo apporto a livello associativo nell am ito confindustriale territoriale e na ionale sin dall adesione in giovane et al ruppo dei iovani di onfindustria ari e ttuale residente di onfindustria è Vicepresidente Uniferr (Unione Nazionale mprese di puli ia erroviaria e servi i integrati nonc mem ro di edera ione mprese di ervi i





ANIP, Associazione Nazionale delle Imprese di Pulizia e Servizi Integrati, è l’Associazione Nazionale di categoria, aderente a onfindustria, che rappresenta e tutela, a livello nazionale e comunitario, in sede politica, istituzionale e sindacale il comparto delle imprese che erogano servizi di pulizia e multiservizi, anche in orma integrata, avendo il compito di stipulare il CCNL di settore. Il comparto dei Servizi integrati e Multiservizi per la gestione e la

a un percorso consolidato all’interno del sistema con ndustriale e ad una profonda conoscenza delle dinamiche associative, abbia costituito un presupposto solido per questa nomina. Un riconoscimento che vivo non solo come un traguardo personale, ma soprattutto come una responsabilità collettiva da condividere e portare avanti insieme a tutta la squadra.
Con la sua azienda, ha alle spalle un’importante esperienza nel settore: come sta oggi il facility management in Italia?
Il facility management rappresenta un comparto sempre più strategico per l’economia nazionale, sia in termini occupazionali sia per il valore aggiunto che è in grado di generare lungo tutta la liera dei servizi. Parliamo di un’industria che in Italia vale oltre 45 miliardi di euro, con un tasso di crescita costante negli ultimi anni e una forza lavoro che supera le 600.000 persone
valorizzazione dei patrimoni immobiliari e urbani pubblici (manutenzione, pulizia, igiene ambientale, energia, security, logistica, ecc.) è un settore di mercato “labour intensive”, a cui appartengono migliaia di PMI e diversi grandi operatori, in continua e costante crescita, nonostante la crisi che ha portato alla contrazione di altri settori, con un impatto enorme in termini occupazionali onfindustria rappresenta numerose imprese che occupano migliaia di lavoratori, con un atturato globale annuo di circa miliardi di euro, operanti nelle diverse attività di pulizia, disin estazione, derattizzazione, sanificazione e servizi ausiliari, manutentivi e gestionali secondo le previsioni del CCNL Pulizie/Multiservizi.
delle imprese pubbliche e private. Tuttavia, siamo duciosi: le aziende più strutturate e visionarie stanno già investendo con decisione in sostenibilità ambientale, transizione digitale e valorizzazione delle risorse umane. Il futuro del facility management, in Italia, passa proprio da qui.
impiegate, distribuite in migliaia di imprese – dalle grandi realtà strutturate no alle piccole e medie aziende di servizio. Oggi, lo stato di salute del settore può essere denito dinamico ma non privo di criticità. Stiamo attraversando un periodo di trasformazione profonda, in cui alla tradizionale erogazione dei servizi si af ancano nuove competenze legate alla digitalizzazione, alla sostenibilità e alla gestione integrata degli spazi.
È un comparto che ha dimostrato grande resilienza, in particolare durante e dopo la pandemia, ma che oggi richiede maggiore riconoscimento normativo, stabilità contrattuale e investimenti per continuare ad innovare.
C’è ancora molto da fare in termini di quali cazione del mercato, di valorizzazione del lavoro e di diffusione di una cultura dei servizi come leva per la competitività
Veniamo alle linee guida del suo mandato, che l’Associazione intende sviluppare: quali saranno le priorità? Le priorità del mio mandato in ANIP si fondano su tre pilastri fondamentali: il benessere delle persone, la competitività delle imprese e la valorizzazione del settore. Metteremo al centro i lavoratori, perché la dignità e la qualità del lavoro passano dalla salute e dalla solidità delle aziende. Al tempo stesso, lavoreremo per un mercato meglio regolato, trasparente e stabile, attraverso un dialogo costruttivo con le istituzioni, la revisione del CCNL Multiservizi e l’allargamento della rappresentanza associativa. In ne, vogliamo promuovere una visione moderna del facility management, investendo in sostenibilità, innovazione e formazione, per far emergere il valore strategico del nostro comparto nell’economia del Paese.
Promuovere regole chiare e favorire l’innovazione, garantendo così occupazione di qualità e il benessere dei lavoratori. Cosa pensa al riguardo?
Credo fermamente che regole chiare e innovazione siano due leve indispensabili per costruire un futuro solido e sostenibile per il nostro settore. La chiarezza normativa è la base per un mercato sano, competitivo e trasparente, dove le imprese possono operare con equità e i lavoratori godere di tutele certe e condizioni di lavoro dignitose. Allo stesso tempo, l’innovazione è ciò che consente al nostro comparto di evolversi, migliorare i processi, ridurre gli impatti ambientali e offrire servizi sempre più ef cienti e di qualità. È anche un potente strumento per attrarre giovani talenti e valorizzare le professionalità esistenti. Solo combinando questi due aspetti potremo

davvero generare occupazione di qualità e garantire un reale benessere alle persone che ogni giorno fanno la differenza sul campo.
Il “nodo” della formazione, assieme a quello della sicurezza sul lavoro, è fondamentale per dare dignità e riconoscimento sociale non solo ai lavoratori, ma anche alle imprese. Quali sono le proposte di ANIP Con ndustria?
Sicuramente formazione e sicurezza rappresentano due temi fondamentali per rafforzare il valore sociale ed economico del nostro settore. Per ANIP Confindustria, investire in formazione signi ca, prima di tutto, riconoscere le competenze dei lavoratori, valorizzarne la professionalità e contribuire alla loro crescita. Non si tratta solo di un dovere, ma di una leva strategica per aumentare la qualità del servizio e la competitività delle imprese. ANIP intende promuovere percorsi formativi strutturati, anche in collaborazione con enti bilaterali e istituzioni, che puntino non solo all’aggiornamento tecnico, ma anche allo sviluppo di soft skills, fondamentali in un settore a forte contatto con le persone e le comunità. Inoltre, crediamo che la cultura della sicurezza debba essere sempre più integrata nei modelli organizzativi aziendali, come valore condiviso, non solo come obbligo normativo. Per questo lavoreremo af nché il tema
sia al centro del dialogo con le istituzioni, incentivando pratiche virtuose, strumenti innovativi e una maggiore professionalizzazione anche da parte delle committenze. Formazione e sicurezza, insieme, sono il presupposto per garantire dignità, stabilità e futuro al comparto.
Nonostante le più recenti normative green e Green Public Procurement puntino ad appalti sempre più trasparenti, verdi e premiali per le aziende “sane”, gli appalti al massimo ribasso rappresentano ancora una piaga, alla quale spesso la pubblica amministrazione non si sottrae. Purtroppo, è un tema ancora troppo attuale. La logica del massimo ribasso continua a rappresentare una distorsione del mercato, che penalizza le aziende virtuose e mette a rischio la qualità dei servizi e la dignità del lavoro. Le norme ci sono, penso ai CAM e al nuovo Codice degli Appalti, che introducono criteri ambientali, premialità e requisiti qualitativi. Ma da sole non bastano: serve un cambio di passo culturale e operativo anche da parte delle stazioni appaltanti. Il rispetto delle regole deve diventare la regola. È fondamentale che i procurement pubblici e privati, selezionino i fornitori non solo in base al prezzo, ma valorizzando l’esperienza, la sostenibilità e l’af dabilità economica e organizzativa delle imprese. E soprattutto servono controlli ef caci e
sanzioni per chi non rispetta le regole: solo così si potrà dare piena attuazione al principio della concorrenza leale. ANIP Conndustria continuerà a farsi portavoce di queste istanze, per tutelare le aziende sane e contribuire alla costruzione di un mercato trasparente, competitivo e responsabile.
Veniamo ai grandi temi dello sviluppo associativo, revisione del CCNL Multiservizi, tutela del mercato e rafforzamento dei rapporti con istituzioni e centrali di acquisto. In che modo ANIP punta a rafforzare il supporto alle imprese, valorizzando il ruolo strategico del facility management per l’economia nazionale?
ANIP-Confindustria intende rafforzare concretamente il supporto alle imprese attraverso un’azione strutturata su più livelli. Sul piano dello sviluppo associativo, stiamo lavorando per ampliare la rappresentanza e coinvolgere un numero crescente di imprese, offrendo servizi sempre più mirati e un dialogo costante con gli associati. Solo con una base ampia e coesa possiamo incidere realmente sul sistema. La revisione del CCNL Multiservizi è un passaggio cruciale: vogliamo che il nuovo contratto valorizzi il lavoro, promuova la qualità e tenga conto della trasformazione in atto nel settore, con un focus su competenze, formazione e sostenibilità. Per quanto riguarda la tutela del mercato, ANIP è impegnata a promuovere gare trasparenti e premianti per le aziende serie. Vogliamo un mercato in cui le imprese sane possano competere su qualità e non sul ribasso dei diritti o della sicurezza. In ne, il rapporto con istituzioni e centrali di acquisto sarà sempre più strategico. ANIP lavorerà per aprire tavoli di confronto strutturati, in modo da stimolare positivamente le scelte di policy e orientare le stazioni appaltanti verso criteri di qualità, sostenibilità e af dabilità. Tutto questo parte da una visione chiara: il facility management non è un costo, ma una leva per l’ef cienza e la competitività del Paese, in tutti i settori. Farlo capire con forza è la nostra missione.
AR PROFESSIONAL: la nuova gamma di idropulitrici dedicata ai professionisti in anteprima a ISSA
In occasione di ISSA PULIRE, Annovi Reverberi, azienda italiana leader nel settore delle pompe ad alta pressione, presenta AR PROFESSIONAL, la nuova gamma di idropulitrici dedicata ai professionisti.
Pensata per rispondere alle esigenze nelle condizioni di lavoro più impegnative, la gamma AR PROFESSIONAL trova applicazione in molteplici ambiti: dall’edilizia all’artigianato, dal settore automotive al car wash, dall’agricoltura e all’alimentare
AR PROFESSIONAL è progettata per offrire soluzioni su misura per ogni contesto operativo.
La gamma si articola in tre categorie di prodotto: idropulitrici con motore a induzione, ideali per un utilizzo intensivo e continuativo; idropulitrici con motore a scoppio, perfette per lavorare in ambienti privi di collegamento elettrico; idropulitrici ad acqua calda pensate per intervenire con e cacia su residui grassi e oleosi assicurando risultati eccellenti anc e nei contesti pi di cili
Tutte le soluzioni si distinguono per prestazioni di prim’ordine, frutto dell’esperienza di Annovi Reverberi e di una progetta ione orientata alla massima e cien a sicure a e durata ateriali di alta ualit e componenti studiati ad hoc come al ole i regola ione angiate pompe con testate nic elate con guarni ioni anc e per l ac ua calda e funzione autoadescante, rendono AR PROFESSIONAL una scelta strategica per ogni professionista c e cerca a da ilit poten a e continuit operativa
na gamma nata per a rontare le sfide di oggi con lo sguardo rivolto a uelle di domani
Perché l’innovazione non si ferma.
AR PROFESSIONAL, built to perform.













Se per alcuni anni - a seguito dell’avvento di Internet, delle vendite on line, e del lancio continuo anche tramite social, delle nuove produzioni, gli scettici avevano ipotizzato la fine delle fiere, ISSA Pulire è la riprova di come ciò, non sia affatto avvenuto
La Fiera milanese è divenuta un evento atteso da tutti i protagonisti della pulizia professionale, capace di delineare efficacemente non solo lo stato di salute, ma il futuro del settore. L’appuntamento in programma alla Fiera di Rho, dal 27 al 29 maggio 2025, si annuncia con tre giornate intense di relazioni commerciali, condivisione di know-how, networking, tendenze e soluzioni innovative. La Ventisettesima edizione si preannuncia ancora più ricca e innovativa, con già 108 nuovi espositori e l’introduzione di inediti comparti merceologici, tra cui componentistica, waste management e pest management. La presenza straniera segna ancora un notevole trend in crescita: un +29,8% di espositori esteri rispetto all’edizione del 2023. A confermare l’importanza della manifestazione è anche il dato sui visitatori che risulta in continuo aumento. L’evento, riconosciuto come piattaforma di networking e innovazione, offrirà ad essi l’opportunità di scoprire le ultime tendenze del cleaning, incontrare i principali player del settore e partecipare
a un ricco programma di convegni e workshop che si terranno nell’ISSA Pulire LAB su tematiche di grande attualità, tra cui codice appalti, sostenibilità e digitalizzazione. A ISSA Pulire 2025 si terrà anche la seconda edizione dell’HACKATHON, la competizione tra squadre di studenti universitari a cui verrà chiesto di sviluppare un’idea innovativa che dimostri in che modo l’intelligenza arti ciale contribuisce a generare valore misurabile nell’industria del cleaning. La competizione, a oggi, è supportata dagli sponsor Hagleitner, come Diamond Sponsor, Cummins, Idrobase e I-Team, come Team Sponsor. Insomma, tutto fa legittimamente ritenere che andremo a vivere un’altra Fiera carica di adrenalina, ricca di emozioni, destinata ad uno straordinario successo, proiettata a centrare tanti prestigiosi traguardi. Pulire guarderà però al futuro senza mai dimenticare il proprio passato. La nostra speranza è che le giovani aziende espositrici e quanti hanno a cuore la manifestazione conservino sempre viva la memoria, rendendo omaggio ai
“padri” che nel lontano 1980 fondarono A damp, con il sogno di creare una grande mostra di settore in grado di dare visibilità interna e internazionale al Made in Italy. Un comparto produttivo – il nostro - che, proprio grazie alla tenacia e alla lungimiranza di tanti piccoli imprenditori e self made man è diventato estremamente competitivo, raggiungendo persino il “tetto” d’Europa. La “spinta propulsiva” di Pulire, ne siamo convinti, grazie a nuove idee, sinergie e all’allargamento ad altre categorie merceologiche, non cesserà affatto. A questa e alle prossime edizioni della Rassegna, le nostre aziende e l’intero comparto produttivo saranno certamente vere e insostituibili protagoniste.
Ma vediamo come siamo arrivati ad oggi.
La ventiquattresima edizione, Pulire 2019, che precede di due anni quella in piena pandemia del 2021, (conclusasi comunque - pur in condizioni di enormi dif col-

tà - con la partecipazione di 300 espositori e oltre 10.000 visitatori) è la prima siglata anche dalla collaborazione con ISSA, la grande multinazionale del professional cleaning degli Usa che si occupa in tutto il mondo di formazione e organizzazione di eventi eristici.
Pulire cresce e si internazionalizza chiudendo i battenti, al termine delle tre giornate espositive, con oltre 17.000 visitatori. In Fiera si respira il clima di una manifestazione davvero importante, che riesce peròfortunatamente - a mantenere l’entusiasmo dei primi tempi e la voglia di rappresentare un appuntamento imperdibile per l’intera liera dell’igiene professionale e del pulito.
“NUOVO CORSO” INTERNAZIONALE
La ventiseiesima edizione della Fiera, che si svolge dal 9 all’11 maggio presso i padiglioni 8 e 12 di Fieramilano Rho, segna il trasferimento della manifestazione nella metropoli lombarda. I numeri nali, maturati dalla era internazionale della pulizia
e sani cazione, spazzano via le incertezze del “grande salto”, ricco di incognite, ormai compiuto. Dalla storica sede veronese, Pulire approda con successo alla capitale economica d’Italia; i dati non lasciano alcun dubbio: sono 373 gli espositori provenienti da 21 Paesi; ben 104 di essi sono nuovi e meritano un caloroso benvenuto. Segno più che positivo anche per la partecipazione degli operatori del settore: il conteggio nale, nei tre giorni di apertura della manifestazione, è oltre 20.000 presenze, in netto aumento sia rispetto all’edizione del 2021 che del 2019.
Un importante contributo a questo ottimo risultato lo hanno dato gli operatori esteri, che hanno rappresentato il 33,45% delle presenze, così come la concomitanza con ben tre ere che si sono svolte negli stessi giorni: Tuttofood, Made in Steel e Lamiera. In totale sono 107 i Paesi in visita a ISSA Pulire 2023, tra questi si contano anche quelli di provenienza dei 24 buyers selezionati da ICE Agenzia, che ha organizzato la partecipazione di delegazioni este-
re provenienti da USA, Egitto, Marocco, Sudafrica, Kenya e Ghana. Per favorire l’internazionalizzazione del Made in Italy, ICE AGENZIA ha anche presentato un’indagine di mercato nel comparto dei servizi di pulizia in Egitto, Marocco, Sudafrica, Thailandia, Malesia.
Insomma, la scelta strategica di portare la manifestazione a Milano si rivela vincente, con tre giornate intense e ricche di networking, formazione e business.
ISSA Pulire in versione milanese offre ancor più, a tutti i protagonisti del comparto l’opportunità di incontrarsi e di ragionare insieme sulle strade da percorrere. ISSA Pulire è portavoce di un settore produttivo forte e dinamico, traino per lo sviluppo del nostro Paese, in un momento in cui la Sani cazione - dopo la tragedia della pandemia - dovrebbe assolutamente essere posta al centro di tutte le attività pubbliche e private. L’entusiasmo e la soddisfazione espressa dagli espositori sono la prova che la coraggiosa scelta compiuta da A damp sta portando i frutti desiderati.



In un mercato dove l’innovazione corre veloce e la sostenibilità
è una necessità concreta, Marka brand di MK spa, lancia TAC&GO!: la nuova frontiera della pulizia professionale. TAC&GO! è la nuova gamma di detergenti superconcentrati progettata e sviluppata per chi opera quotidianamente nel settore del cleaning professionale e che desidera un sistema sicuro, ef cace e sostenibile.
Ogni prodotto TAC&GO! è il risultato di un processo di ricerca continua, con l’obiettivo di garantire elevati standard di sicurezza, prestazioni ef cienti e un ridotto impatto ambientale. Basta un semplice “TAC” per attivare una formula ad altissima performance, studiata per agire in profondità e rendere ogni ambiente impeccabile.
Il sistema è semplice, intuitivo e veloce:
• Riempire con acqua il acone da 500 ml o da 1 litro
• Avvitare il aconcino da 70 ml no al “TAC”
• Lasciar diluire e “GO”: il prodotto è pronto all’uso.
Per facilitare l’associazione tra aconcino e acone, ogni confezione TAC&GO! contiene etichette colorate coordinate con il colore del liquido da applicare sul acone: lo stesso codice colore rende immediato il riconoscimento del prodotto, sempli cando l’attività di cleaning e migliorando la gestione.



Le nuove soluzioni Marka TAC&GO! sono state studiate, progettate e sviluppate facendo leva su 4 pilastri fondamentali.
Sicurezza . Per Marka TAC&GO! la sicurezza della persona, dell’ambiente e delle super ci gioca un ruolo cruciale. Grazie allo speciale pack, l’utilizzatore non entra mai in contatto diretto con il prodotto, evitando schizzi e rischi per la salute. Il dosaggio è sempre preciso, riducendo sprechi di prodotto ed evitando sovradosaggi che comprometterebbero le super ci o l’ef cacia del prodotto. In aggiunta, i aconcini da 70 ml sono leggeri e facili da trasportare, riducendo il carico e migliorando la sicurezza dell’operatore.
Performance. Da oltre 60 anni, Marka si impegna a garantire performance e soluzioni all’avanguardia e continua a farlo anche con la nuova gamma TAC&GO!. Tutte le formule sono il risultato di studio, ricerca, passione e test comparativi con i migliori benchmark del mercato. Sviluppate nel laboratorio interno di MK, uniscono materie prime di alta qualità, prediligendo quelle di origine vegetale con performance pari o superiori a quelle delle versioni tradizionali.
Sostenibilità. TAC&GO! traduce in azioni concrete l’impegno di MK spa per rendere il mondo un luogo più accogliente, per noi e per le generazioni future.




















































SICUREZZA
Nessun conta o — Lo speciale pack evita il conta o dire o con il prodo o, prevenendo schizzi e rischi per la salute
Carico rido o — Pack e formato leggeri facilitano la movimentazione e aumentano la sicurezza dell’operatore
Dosaggio preciso — Il pack assicura sempre dosi pe e e, riducendo sprechi e prevenendo danni o ine cacia
Nessun errore — Etiche a con codice colore uguale al liquido per una diluizione immediata e corre a
STOCCAGGIO
82% di spazio recuperato — Ingombro rido o rispe o al formato classico, migliorando logistica e stoccaggio
Ca oni compa i — Ingombro minimo con 4 volte i prodo i del formato tradizionale
10 volte più prodo o — Ogni metro cubo contiene
10 volte più prodo o rispe o al formato standard
1 sta a 4 — Un ca one TAC&GO! equivale a 4 da 500 ml tradizionali
Riempire il acone con acqua ed a accare l’etiche a in dotazione.
1
Ricerca, Studio e Passione — I prodo i TAC&GO! nascono da un accurato lavoro del repa o Ricerca & Sviluppo
Formule testate — Testati e confrontati con i migliori benchmark per garantire prestazioni eccellenti
Materie prime selezionate — Formulati con materie all’avanguardia, preferendo quelle di origine vegetale
Alta concentrazione — Elevata concentrazione di materie prime per risultati garantiti ed e caci
-80% emissioni — Un bilico TAC&GO! sostituisce 5 bilici di aconi da 500 ml
-83% plastica — Ogni aconcino usa l’83% di plastica in meno rispe o a quello tradizionale
50% plastica riciclata — Ogni aconcino TAC&GO! è prodo o con il 50% di plastica riciclata
100% riciclabile — L’intero pack è monomateriale e totalmente riciclabile nella plastica
Avvitare il collo del aconcino del superconcentrato sul collo del acone e ruotare nché il prodo o inizia a fuoriuscire. 2
Chiudere il acone ed agitare energicamente per o enere una soluzione omogenea. Il prodo o diluito è pronto per essere utilizzato. 3

Vieni a vederlo dal vivo.

La nuova gamma ha un impatto molto positivo sull’ambiente:
• -80% di emissioni di CO2 grazie all’ottimizzazione logistica
• -83% di plastica rispetto al formato 500 ml
• Flaconcini prodotti con il 50% di plastica riciclata
• Flacone da 500 ml o 1 litro riutilizzabile per altre diluizioni
• Packaging monomateriale, facilmente riciclabile nella plastica
• Zero sprechi grazie al dosaggio perfetto.
Stoccaggio. Oltre ai vantaggi legati alla sicurezza, alla performance e alla sostenibilità, TAC&GO! ottimizza la logistica e lo stoccaggio. Un metro cubo può contenere no a 10 volte più prodotti TAC&GO! rispetto al formato standard da 500 ml. Tradotto in saving, si può recuperare no all’82% dello spazio di magazzino, con evidenti bene ci in termini di ef cienza, movimentazione e gestione delle scorte.
Ogni box TAC&GO! contiene 48 aconcini da 70 ml, suddivisi in 12 astucci da 4 pezzi: la soluzione perfetta per chi cerca praticità, ordine e compattezza.
La gamma TAC&GO! è versatile e trasversale, perfetta per ogni super cie e ambiente: ristoranti, hotel, uf ci, bar, palestre e imprese di pulizia. L’assortimento è composto da 7 referenze: quattro prodotti da diluire in aconi da 500 ml (pronto uso) e tre da diluire in aconi da 1 litro.
• Sgrassatore Limone. Sgrassatore liquido ad alto potere detergente ideale per contesti alimentari e non. La combinazione di tensioattivi, solventi e sequestranti garantisce un’elevata capacità emulsionante, facilitando la dissoluzione e l’eliminazione dello sporco grasso di origine animale, vegetale e proteica. È ideale per tutte le super ci lavabili, incluso acciaio inox.
• Vetri & Multiuso. Detergente igienizzante formulato con alcool isopropilico ideale per la pulizia quotidiana di vetri, porte, arredi e super ci metalliche. La presenza di solventi di origine vegetale intensi ca la fragranza per un profumo più duraturo e potenzia

l’azione sgrassante. Previene il deposito dello sporco, facilita lo scorrimento dell’acqua e garantisce super ci brillanti e senza aloni. Diffonde una piacevole fragranza di uva e mirtillo.
• Anticalcare Bagno. Detergente disincrostante acido con sbiancante ottico anti-ridepositante ideale per la pulizia quotidiana e periodica delle super ci bagno resistenti agli acidi. La perfetta sinergia tra acido citrico, acido sulfammico e tensioattivi assicura una pulizia profonda ed ef cace, rimuovendo rapidamente calcare, sporco grasso, residui organici e di sapone da sanitari, piastrelle e rubinetterie. Adatto anche contro le macchie di ruggine. Dona un gradevole profumo di pino ed è facile da risciacquare.
• Deodorante Bifasico. Deodorante ambiente con tecnologia formulistica bifasica, ideale per combattere i cattivi odori, neutralizzandoli e donando agli ambienti un fresco e piacevole profumo. La perfetta sinergia tra le due fasi, una altamente profumante e l’altra altamente ssativa, garantisce un profumo persistente negli ambienti.
• Pavimenti Floreale e Pavimenti Fruttato. Due detergenti igienizzanti con alcool isopropilico, ideali per la pulizia quotidiana di tutti i tipi di pavimenti, inclusi quelli protetti. La combinazione di tensioattivi e solventi garantisce un’elevata azione sgrassante, anche contro lo sporco più ostinato. Le soluzioni evaporano rapidamente e riducono i tempi di asciugatura, donando un gradevole profumo. Utilizzabili con sistemi mop e macchine lavasciuga.
• Sgrassatore Pavimenti. Detergente solventato ad alto potere sgrassante, ideale per pavimenti in gres, gres porcellanato, super ci microporose e cementi. La sua formula avanzata contiene uno speciale tensioattivo, che favorisce il contatto tra la soluzione detergente e la super cie, penetrando nei pori e migliorando la performance e l’azione estrattiva dello sporco. Non profumato. Utilizzabile con sistema mop e macchine lavasciuga.
Marka è Protezione Profonda Professionale

Un itinerario per cogliere alcuni passaggi che, dalla nascita all’edizione 2025, hanno portato la rassegna espositiva dedicata al pulito professionale ad affermarsi nel panorama internazionale. La storia di una fiera creata da diciassette lucidi “visionari”


La Fiera Pulire esordisce nel novembre del 1982, a Bologna, sulle ceneri della prima esperienza di Pulisan, una rassegna espositiva consumata a Roma E.U.R, che non aveva riscosso successo. La Mostra è curata da Mo.ed.co, “mostre, edizioni e convegni”. Il compianto Alfredo Pellizzari - a lungo editore, organizzatore di esposizioni - inaugura così, con questo inedito “format”, la lunga stagione delle ere del settore della pulizia industriale. A Pulisan e, successivamente, al debutto di Pulire, si mettono in vista le prime aziende importatrici di macchine, prodotti e attrezzature per il professional cleaning. L’iniziale tassello, tutto italiano, che si propone di creare una Fiera integrativa rispetto alla grande e affermata Interclean di Amsterdam, era stato posto.
L’idea di creare Pulire costituiva uno dei principali obiettivi delle 17 aziende fondatrici - nel gennaio 1981 - di A damp (Associazione fabbricanti italiani distributori attrezzature macchine per la pulizia), della quale Pellizzari era segretario. Egli stesso, insieme a Elio Zibra, Enrico Facchini e Luciano Tasin, aveva fondato il Centro italiano programmi pulizia manutenzione e sani cazione (Cippmes). Gli associati ad A damp, con entusiasmo, avevano deciso di dar vita a una Mostra destinata a esporre il meglio della loro produzione, auspicando l’elevazione professionale della pulizia tramite la nuova associazione. Intendevano dare maggiore visibilità alla loro offerta di mezzi meccanici e chimici, sostituendo, alla povera immagine delle donne delle
pulizie, figure qualificate, equipaggiate. Per pulire non interni, ma grandi ambienti: industrie, ospedali, scuole, uf ci. I primi associati volevano mostrare l’autonomia tecnico-economica di un settore che andava sottratto alla deprimente idea del “olio di gomito con stracci e scope”. L’intendimento era far crescere, produttivamente e culturalmente, un’attività arricchita di apporti formativi, capace di creare anche in Italia un universo e un mercato della pulizia industriale, come già all’estero con la “cleaning science” e la “sanitation”.
Allora il comparto era agli albori e le giovani aziende, poi affermatesi nel tempo, avevano da poco intrapreso la strada che le avrebbe portate a primeggiare in Europa e
A SERGIO ANTONIUZZI
A dispetto dell’età, Sergio Antoniuzzi non è solo l’instancabile fondatore e presidente di ICEFOR, Spa ma l’anima sempre attiva dell’azienda di Magenta che ha fatto scuola nel campo della detergenza professionale italiana. Dal 1978, pur con ruoli diversi, la guida con straordinaria passione a ancato dalla figlia aniela che da qualche anno ne ha assunto con abilità la dirigenza operativa. Lo abbiamo incontrato alla vigilia della sua ennesima partecipazione alla fiera dedicata alla pulizia pro essionale che l ha sempre visto protagonista per farci raccontare un’esperienza senz’altro all avanguardia, ma anche per ri ettere sul valore aggiunto della certificazioni e del marchio colabel, sul quale ha puntato fin con lungimiranza, fin da quando, in tempi ormai remoti, ancora il “green” non andava di moda.
La Fiera Pulire l’ha vista sempre presente con uno stand attraverso il uale fin a subito la sua a ien a si istinta per originalit e creati it come maturata l i ea i proporre un allestimento caratteri ato a una orte impronta ecologica a mia prima partecipazione avvenne alla fiera ulisan, a ilano,

ancora prima che nascesse fidamp oi, con ulire itinerante e successivamente a Verona, ho portato uno stand che non era solo espositivo, ma educativo arlavo di salute, biodegradabilità, sicurezza. Ricordo ancora i commenti sorpresi: ‘Cosa ci fa un’azienda chimica che non usa fosfati?’. Era un’idea ‘ante litteram’, perché io volevo trasmettere cultura, prima che vendere prodotti. Ed è questo che ci ha sempre distinti: uno stand come luogo di formazione e coscienza, non solo di marketing.
nel mondo. Le prime artigianali lavasciuga pavimenti erano state da poco faticosamente concepite e costruite, a volte mutuando modelli statunitensi o tedeschi, ma con creatività tutta italiana, nelle of cine meccaniche o in piccole fabbriche del Veneto, della Lombardia e dell’Emilia da alcuni coraggiosi e intraprendenti pionieri, destinati a lasciare un segno indelebile, con i loro nomi e i marchi, oggi noti e apprezzati un po’ ovunque nel mondo. Buona parte di questi modelli riprendevano - di fatto - l’impronta delle macchine già affermate negli Usa o in altri Paesi dove la pulizia meccanizzata delle super ci aveva già preso piede.
Pulire, dopo l’esordio nel capoluogo emiliano, è itinerante: prima del de nitivo approdo in terra scaligera nel 1991, fa tappa a Torino, Milano, Parma, Padova, Roma, Napoli e Bari, città dove la era semina curiosità e consenso. I primi anni di vita della Rassegna, vedono già protagonisti nomi di imprenditori e marchi aziendali che, con le loro vicen-
de, resteranno impressi a lungo nella storia e memoria indelebile della Fiera: Giancarlo Ruffo con Comac, Giulio Guizzi con Pulindustria-Cimex e Pulex, i fratelli Raimondi Renzo, Roberto e Romolo con Rcm, Sergio Antoniuzzi con Icefor, l’ingegner O. Fiorentini, fondatore dell’omonima industria, e tanti altri. Senza contare il fondamentale apporto di persone (sarebbero davvero tante da citare!) che da subito dimostrano il loro straordinario impegno a favore della nobile, duplice missione: far crescere la cultura del pulito e la Fiera che ne rappresentava l’elemento catalizzatore e divulgatore, in Italia e oltrecon ne.
Pulire mette piede una prima volta Verona nel novembre 1985, su una super cie di soli 2.500 mq lordi: l’organizzazione di Mo.ed. co è ancora solidamente guidata dalla gura autorevole e austera del dottor Pellizzari, che è anche direttore della rivista tecnica “Pulizia Industriale e Sani cazione” (la prima realizzata in questo ambito), il quale in
lcuni la consi erano un po come il pa re ella etergen a ecologica in talia come e uan o nata uesta oca ione per la puli ia pro essionale
Questa grande passione imprenditoriale affonda le radici in un’esperienza diretta, vissuta tra gli anni ’60 e ’70, quando iniziai a collaborare con l’Istituto di Clinica del Lavoro per testare l’impatto reale dei prodotti chimici sul campo. In quegli anni, la sicurezza nei luoghi di lavoro era spesso trascurata, e vidi con i miei occhi le conseguenze drammatiche di detergenti aggressivi e poco controllati: operaie con occhi arrossati, di coltà respiratorie, danni permanenti ai polmoni. Quelle immagini non mi hanno mai lasciato. Sono state la spinta profonda, umana prima ancora che imprenditoriale, che mi ha portato a cercare – e realizzare – un’alternativa concreta. Così, Già nel 1983, quando ancora non esistevano normative in materia, abbiamo scelto con determinazione di eliminare dalle nostre formulazioni sostanze come os ati, ormaldeide, , e solventi volatili È stata una scelta controcorrente, faticosa, che comportava costi e ricerca, ma che rispondeva a un preciso principio etico: la tutela della salute umana e dell’ambiente. Abbiamo introdotto tensioattivi vegetali altamente biodegradabili – oltre il 98% – in un’epoca in cui il mercato non era ancora pronto, né culturalmente né economicamente. Questa è l’origine della mia vocazione ecologica: non una moda, ma una
riva all’Adige ha le proprie radici familiari e qui ha fondato la testata. L’esposizione occupa un piccolo, modesto padiglione del quartiere eristico, al quale si accede varcando il grande cancello d’accesso, subito a destra rispetto all’ingresso, dato che a quei tempi non esisteva ancora il Palaexpo. Al suo anco la dolce, ef cientissima Ilva Gottardi, segretaria di Mo.ed.co. e A damp, factotum dell’evento, che ne cura il marketing, gli inviti, la promozione e la segreteria organizzativa. Al sottoscritto spetta - n da allora - il compito di curare l’uf cio stampa e PR , realizzando la conferenza stampa, i comunicati stampa e il giornalino quotidiano della manifestazione. Posso contare sul prezioso aiuto dei bravi fotogra Sgaravato, padre e glio, con i quali lavorerò anco a anco in più edizioni, che rmeranno per anni le istantanee uf ciali - prevalentemente in bianco e nero - degli stand distribuiti nei vari padiglioni e dei momenti salienti della manifestazione. Pulire, ha - quella prima volta - allestimenti quasi ‘spartani’, ma raccoglie un soddisfacente numero di visitatori,
missione nata dall’osservazione della realtà e dalla volontà di cambiare le cose quando farlo richiedeva coraggio e visione.
uali ifficolt a o uto a rontare per approcciare e tro are un posto al sole sul mercato
Oggi, in effetti, molti parlano di sostenibilità, mentre allora, eravamo in pochi a crederci davvero. All’epoca parlare di formulazioni ecologiche era quasi un’eresia. Infatti i costi delle materie prime naturali erano altissimi, le certificazioni non esistevano, e i miei colleghi spesso mi deridevano, dicendo che ‘gli ecologici non lavano’. Abbiamo dovuto fare tutto da soli: test di laboratorio, prove su campo, investimenti continui Ho perfino distrutto una mia prima linea già certificata
Ecolabel perché non era all’altezza delle mie aspettative qualitative e prestazionali, e l’ho rifatta daccapo. Ma non ho mai ceduto: ho voluto essere il primo, e questo ha richiesto coraggio, determinazione, visione e soprattutto coerenza. Il green, all’epoca era una sorta di scommessa solitaria.
arliamo el marc io colabel c e a ete ottenuto in anteprima e pi in generale elle certifica ioni ei ostri pro otti i cui siete entrati in possesso uale alore aggiunto i anno assicurato rispetto alla concorren a
raggiungendo ampiamente i risultati pre ssati. Anche grazie al mio contributo giornalistico, agli investimenti di redazionali e pagine pubblicitarie sulle pagine del Corriere della Sera e di altre testate nazionali e locali, come pure ai servizi televisivi – compresa l’immancabile RAI 3 - ha pure un buon riscontro mediatico.
INTERNAZIONALE
La manifestazione itinerante, come si accennava, viene quindi riproposta in altre città (memorabile l’edizione di Napoli!), salvo poi tornare a Verona nel 1991. A dispetto del calore nei padiglioni, provocato da un guasto all’impianto di condizionamento e di qualche altra avversità logistica e politica, la Mostra riscuote grande successo. Pellizzari crede in me e mi convoca a Milano, facendomi incontrare ed esaminare dal Comitato stampa del Consiglio direttivo dell’associazione: sono promosso a pieni voti e mi chiedono di curare sia l’uf cio stampa PR di A damp, sia quello della rassegna espositi-
va. Così ha uf cialmente inizio anche la mia collaborazione con l’associazione. Accolta nei padiglioni 8 e 9, la fiera del 1991 si snoda su una super cie di 16.000 mq lordi, con 120 espositori e 4.200 visitatori. Al termine, il bilancio è ancora una volta assai lusinghiero: in seno ad AFIDAMP si rafforza la convinzione che Verona rappresenti davvero, soprattutto per la sua posizione strategica, la città ideale per far crescere Pulire.
Così, due anni dopo, è ancora Verona ad ospitare la mostra-convegno, ben organizzata, che raccoglie quasi settemila visitatori, oltre un migliaio dei quali stranieri, specie in ambito europeo. L’edizione segna un punto di svolta per la rassegna, con la conquista uf ciale della patente internazionale da parte del Ministero del Commercio Estero e dell’ICE. Pulire è successivamente organizzata, su mandato di A damp, dall’Agenzia Dametti. Ancora una volta ne curo l’uf cio stampa e PR, organizzando e moderando anche qualche interessante convegno. Di quella fortunata edizione ricordo il sim-
e certificazioni che abbiamo ottenuto, a partire dall colabel, sono state e sono tuttora veramente qualcosa di straordinario, non solo in termini simbolici, ma soprattutto quale concreta garanzia di qualità, a dabilità e responsabilità on si tratta semplicemente di apporre un marchio su un etichetta dietro ogni certificazione c un lungo lavoro di costruzione d’un sistema aziendale rigoroso e coerente, sviluppato nel tempo con impegno e visione. Abbiamo adottato, già decenni fa, un approccio ispirato alla qualità totale del modello o ota, creando un’organizzazione che coinvolge attivamente fornitori, personale e clienti in un percorso condiviso di crescita e miglioramento continuo. Ogni lotto dei nostri prodotti è tracciato, ogni fase del processo produttivo è controllata e documentata, ogni formulazione nasce da un’attenta ricerca di equilibrio tra prestazioni elevate e sostenibilità ambientale e umana. Il nostro Ecolabel è reale, concreto: supera test prestazionali stringenti, non è frutto di una semplice strategia di marketing, ma il risultato di studi, prove di laboratorio, investimenti in ricerca e sviluppo e rigore tecnico. Il know-how che abbiamo costruito nel tempo non solo ci ha permesso di distinguere la nostra azienda sul mercato, ma ha anche suscitato l’attenzione e il riconoscimento delle istituzioni italiane ed europee, tanto da essere citati come modello in convegni, manuali, percorsi formativi e programmi di collaborazione con enti pubblici e accademici.
patico robottino parlante, con sembianze umanoidi, capace di catalizzare costantemente l’attenzione su di sé.
Sono decine di migliaia i visitatori provenienti non solo dall’Italia e dall’Europa (soprattutto tedeschi, olandesi e inglesi), ma anche i personaggi che, dall’82 in poi, hanno visitato Pulire, esprimendo meraviglia e apprezzamento per le tecnologie esposte, la capacità produttiva dei costruttori e il loro sforzo costante teso all’innovazione (confermato dall’omonimo e ambito Premio).
Senza dimenticare il richiamo degli innumerevoli appuntamenti collaterali – convegni, seminari, dimostrazioni tecniche e talk show – che hanno contraddistinto un evento non solo di grande interesse merceologico, ma anche culturale, con esclusive opportunità di aggiornamento professionale. Le edizioni biennali, nei primi tempi, hanno accolto regolarmente il Congresso nazionale di Anipio, Associazione degli infermieri specialisti del rischio infettivo, che ha richiamato centinaia di operatori specializzati per fare il punto sulla prevenzione e lotta alle ICA.
on sempre la clientela imostra i appre are pro otti i ualit c e magari anno un costo superiore rispetto a altri c e ne pensa
l tema del prezzo rappresenta una sfida quotidiana, spesso sottovalutata o mal compresa. Ancora oggi, in molti ambienti, persiste l’idea che un detergente sia semplicemente una miscela di “acqua, colore e profumo”. Ma questa visione riduttiva ignora completamente ciò che realmente offriamo: non un semplice prodotto, ma un concentrato di competenze, tecnologia, sicurezza, ricerca e rispetto per la salute e l ambiente oi non vendiamo solo detergenti, vendiamo conoscenza, consulenza sulle problematiche legate all’igiene e soluzioni integrate. Ogni nostra formulazione è rutto di studi scientifici, prove di laboratorio, attenzione normativa e volontà di anticipare le esigenze del mercato professionale. Abbiamo lavorato con impegno per far comprendere che dietro un prezzo apparentemente più alto si cela un valore aggiunto concreto: prodotti certificati, sicuri per l operatore, sostenibili per l ambiente, stabili nelle prestazioni nel tempo, rispetto dei collaboratori e la continuità di un rapporto commerciale sereno. Chi oggi ci sceglie, lo fa con consapevolezza. Sa che la qualità, sebbene richieda un investimento iniziale più alto, porta a una riduzione significativa dei costi indiretti: meno infortuni, minori consumi, minore usura delle
Senza dimenticare il Campionato mondiale dei pulitori di vetri, gli incontri con esperti e opinionisti internazionali – come il noto economista e sociologo Jeremy Rifkin –e per no il concerto all’aperto, sotto una pioggia battente, di Eugenio Finardi. Diversi anche i sindaci di Verona – da Enzo Erminero a Paolo Zanotto, da Flavio Tosi a Federico Sboarina – che, con i presidenti di Verona ere e vari sottosegretari, hanno presenziato all’inaugurazione del Salone. Col passare del tempo Pulire è diventata sempre più grande, in termini di padiglioni e super cie espositiva occupata, ed attraente per gli ospiti dai cinque continenti. La Fiera si è imposta sulla concorrenza europea e mondiale con numeri sempre più importanti, divenendo una manifestazione solida e matura, organizzata da A damp Servizi.
I nomi di Toni D’Andrea, AD di A damp Servizi e ora CEO di ISSA Pulire Network, e Stefania Verrienti, prima segretaria e ora direttrice di A damp, insieme a tutto lo staff organizzativo, sono ormai impressi nell’evoluzione di questa era, nata umilmente quarantadue anni orsono.
Quella del 2019 è un’edizione molto particolare, la prima siglata anche dalla collaborazione con ISSA, in cui la manifestazione veronese è chiamata a confermare il suo ruolo di leadership in uno scenario sempre più globale e internazionale. Il bilancio, in termini numerici è – come sempre - assai lusinghiero: Pulire cresce e si internazionalizza chiudendo i battenti, al termine delle tre giornate espositive, con oltre 17.000 visitatori. Il che signi ca - raffrontandola con la già ottima edizione 2017 - un +6%. Gli espositori propongono i propri prodotti, nella consueta elegante vetrina, su una super cie di quasi 16.300 mq, suddivisi tra i tre padiglioni in indoor e l’area dimostrativa in outdoor. Il dato più confortante è senz’altro relativo alla presenza di stranieri, che alla ne ammonta ad un terzo, cioè più del 30%. Un risultato considerevole, che premia e incentiva gli sforzi degli organizzatori. Ancora una volta, l’edizione del 2019 consolida il ruolo di riferimento della manifestazione in ambito nazionale ma specialmente internazionale. Sempre
superfici, meno tempo speso per ottenere risultati di pulizia e caci n un mercato in cui si parla sempre più di e cienza e sostenibilità, la qualità vera non è più un lusso: è una scelta strategica, intelligente e responsabile. La nostra esperienza dimostra che il valore reale non si misura solo sullo scontrino, ma su ciò che un prodotto è in grado di generare nel tempo fiducia, continuità, reputazione, e soprattutto benessere per chi lo utilizza ogni giorno”.
uesta inter ista uscir sulla ri ista c e err istribuita a ulire in c iusura in ualit i memoria storica ell e ento non posso are a meno i c ie erle un con ronto ra le prime e i ioni ella mani esta ione e uelle egli ultimi anni come cambiata la fiera el pulito ulire, agli esordi, era molto più di una semplice fiera era un’autentica avventura. Gli stand erano piccoli, spesso improvvisati, ma abitati da pionieri coraggiosi che portavano idee nuove, visioni fuori dagli schemi, soluzioni tecniche che allora sembravano utopie. C’era entusiasmo, passione, desiderio di confronto: si respirava l’aria della vera innovazione, quella fatta di esperienze condivise, ricerca sul campo, formazione che serviva davvero a cambiare le cose. Oggi
a proposito di internazionalità: sono 111 i Paesi di provenienza dei visitatori, 21 i Paesi degli espositori, 5 le delegazioni estere. L’organizzazione di A damp Servizi, in collaborazione con gli uf ci di ICE-Agenzia (che ha selezionato delegazioni provenienti da USA, Marocco, Egitto, Turchia e Sud Africa), predispone abilmente uno spazio dedicato per gli incontri b2b. Le cinque delegazioni di operatori esteri esprimono, infatti, mercati strategici e rappresentativi del mondo della distribuzione, degli utilizzatori nali, del comparto dei servizi integrati del cleaning professionale. Il tradizionale “Premio Innovazione”, dopo ben dieci onorate edizioni, passa il testimone al riconoscimento per il “Prodotto dell’anno”.
2023. MILANO
La ventiseiesima edizione della Fiera, segna il trasferimento della manifestazione nella metropoli lombarda e determina l’avvio di un nuovo corso che comincia proprio con questa edizione e che punta alla realizzazione di un progetto di integrazione, di internazionalizzazione e di crescita sempre maggiore.
ulire diventata una rassegna espositiva importante, strutturata, internazionale n grande evento che dà visibilità al settore uttavia, confesso che a volte sento la mancanza di quello spirito originario: il coraggio di osare, la centralità delle competenze tecniche, lo spazio dato a chi costruisce cultura e non solo business egli anni, però, il mercato è cresciuto. È maturato in termini di competenze, consapevolezza e formazione, e questo progresso ha coinvolto anche i distributori, non più semplici intermediari ma veri operatori professionali. Un’evoluzione possibile grazie a una collaborazione costante tra gli associati, che ha alimentato un dialogo costruttivo e continuo. Questa sinergia ha contribuito a far crescere la cultura del settore e la competenza degli operatori, promuovendo un approccio sempre più responsabile e orientato al rispetto del bene comune. Mi piacerebbe rivedere una fiera in cui tornino protagonisti coloro che sanno guardare avanti, che vogliono ancora ‘cambiare il mondo’ e non solo ‘vendere qualcosa’. Dove si premia la visione di lungo periodo, non l’inseguimento di una tendenza passeggera. Il nostro settore ha bisogno di numeri, certo, ma anche - e soprattutto - di cuore, idee, e di quel senso di responsabilità collettiva che ha animato i nostri primi passi.
MP-HT partecipa a ISSA Pulire presentando i frutti di un percorso che unisce ascolto, ricerca e innovazione. Al centro dell’impegno, la volontà di sempli care il lavoro quotidiano degli operatori, migliorandone sicurezza, ef cienza e comfort.
Dopo l’anteprima a Interclean, due delle novità più attese sono entrate in produzione: Wind Ant è una spazzatrice uomo a bordo che si distingue per la sua compattezza e agilità. È progettata per raccogliere detriti con grande ef cacia, grazie a un sistema integrato di aspirazione e nastro convogliatore. Il design ergonomico e la tecnologia a bordo la rendono intuitiva, silenziosa e altamente produttiva, ideale per contesti urbani e industriali.
Stout E+ è pensata per affrontare ambienti industriali complessi.



Resistente alle condizioni più gravose, garantisce basse emissioni e consumi ridotti, grazie ai motori elettrici a 24 Volt. Questi motori permettono di ottenere alte performance, ridurre i consumi energetici e garantire una durata continua di lavoro senza precedenti.
Oltre a queste novità, in era sarà possibile scoprire anche un modello storico, rivisitato per rispondere alle nuove s de del cleaning urbano. Ogni macchina MP-HT è progettata af nché il lavoro di pulizia diventi sempre più ef ciente e piacevole. La continua evoluzione delle spazzatrici MP-HT, che unisce l’esperienza artigianale con la tecnologia all’avanguardia, è la risposta ideale alle richieste di un mercato in rapida evoluzione.


Non solo spazzatrici, ma il tuo alleato.








































a cure della redazione
ISSA PULIRE, la era internazionale di riferimento per il settore della pulizia professionale e della sani cazione, organizzata da ISSA e A damp, è una piattaforma globale per l’innovazione, il networking e l’aggiornamento professionale e come tale offre un’ampia selezione di eventi dedicati agli attori del settore e alla presentazione delle ultime tecnologie per il pulito.
l’ISSA PULIRE LAB è il cuore pulsante dell’evento, un’area dedicata a convegni, seminari e workshop su tematiche cruciali come la sostenibilità, la digitalizzazione, il nuovo Codice degli appalti e la sicurezza sul lavoro. Un’opportunità per i professionisti di aggiornarsi e confrontarsi con esperti del settore.
La era ospita anche la cerimonia di premiazione del “Product of the Year”, riconoscimento assegnato al prodotto più innovativo nel campo della pulizia professionale che rappresenta un’occasione per valorizzare le eccellenze del settore e promuovere l’innovazione tecnologica.
GLI EVENTI AFIDAMP
Presso lo stand dell’associazione (PAV 8P - G03 G07 H04) sono in programma diverse iniziative. Gli esperti di ISPRA - sezione del Ministero dell’Ambiente che si occupa delle certi cazioni ECOLABEL - saranno disponibili durante tutto il corso della manifestazione per incontrare le aziende in era e fornire chiarimenti su procedure e rispondere a domande di aspetto generale.
Il 28 maggio alle ore 14:30 è in programma un appuntamento importante per tutto il comparto, “I Distributori al Centro: la forza della coesione per lo sviluppo del mercato”. AFIDAMP invita tutti
i distributori del settore del cleaning professionale a un momento dedicato esclusivamente a loro, per valorizzare il ruolo strategico della distribuzione e promuovere l’importanza di un’associazione coesa e rappresentativa.
il 28 Maggio, alle ore 16:00, verrà presentata la nuova “Guida sulle macchine autonome per la pulizia professionale”. Il documento fornisce indicazioni per l’utilizzo dei robot nel settore del cleaning professionale, affrontando temi come la privacy, la sicurezza e la sostenibilità ambientale nell’adozione di queste nuove tecnologie. Per l’occasione, la guida sarà distribuita gratuitamente in formato cartaceo. Una grande novità di quest’anno è l’Afterclean AFIDAMP Party, un evento speciale organizzato all’interno dello stand per creare network in un ambiente informale. Il party si terrà al termine del primo giorno di manifestazione, alle 18:30. L’elenco completo delle iniziative organizzate in era da AFIDAMP può essere consultato sul sito dell’associazione, www.adamp.it.
A.I.D.P.I. (Associazione Imprese Disinfestazione Professionali Italiane) è presente con il “Disinfestando Pavilion”, un’area dedicata al pest management professionale. Oltre all’esposizione di soluzioni innovative, sono in programma diversi momenti formativi e di aggiornamento, tra cui la presentazione della Norma UNI 11956, approfondimenti sul Registro elettronico nazionale per la tracciabilità dei ri uti (RENTRI), un focus sulla sicurezza e sulla “patente a punti” per il settore.






Tork si impegna a sviluppare soluzioni igieniche innovative e sostenibili, intelligenti per le aziende, migliori per le persone e per il pianeta.
Il dispenser Tork Xpress® eroga un asciugamano alla volta, aiutando a controllare i consumi e a ridurre gli sprechi1
Gli asciugamani compressi Tork Xpress® consentono di risparmiare spazio a magazzino, grazie alle risme compresse del 50%2. La riduzione dei materiali di imballaggio raggiunge il 27%3 e la riduzione delle emissioni di CO2 legate al trasporto è signi cativa, grazie ad un carico di asciugamano quasi doppio per ogni camion4.


Una migliore igiene per una migliore performance tork.it/igiene-negli-uffici


Tork, marchio del gruppo Essity, presenta a ISSA Pulire le sue ultime soluzioni, tecnologiche ed eco-responsabili, pensate per aiutare le aziende a conciliare le esigenze di igiene con l’impegno per l’ambiente.
Oggi l’ambiente e lo sviluppo sostenibile sono criteri fondamentali non solo per le aziende, ma anche per i loro dipendenti, partner e clienti. Le questioni ambientali sono ormai parte integrante delle strategie aziendali in quanto costituiscono un prerequisito per garantire un futuro sostenibile. I dipendenti sono sempre più consapevoli dell’impatto ambientale ed esprimono un desiderio crescente di lavorare per organizzazioni che condividono tali valori: si aspettano impegni concreti e azioni tangibili da parte dei loro datori di lavoro.
A dimostrazione del costante impegno per lo sviluppo sostenibile, Tork ha recentemente presentato Tork OptiServe, un’innovativa soluzione di carta igienica senza anima. Questa innovazione sempli ca la gestione dei bagni e riduce i ri uti di imballaggio del 92%, migliorando l’ef cienza degli addetti alle pulizie e riducendo l’impatto ambientale. Inoltre, con l’iniziativa Tork Focus4 Sustainability, Tork offre alle aziende un programma completo che fornisce dati chiari e comprensibili per ottimizzare le prestazioni e ridurre al minimo l’impatto ambientale. Il programma evidenzia i principali vantaggi dei prodotti e dei servizi Tork in materia di sostenibilità, aumentando la trasparenza e l’impatto positivo sull’ambiente.
«In Essity, crediamo fermamente che innovazione e sostenibilità


vadano di pari passo per costruire un futuro più sano e responsabile. Con soluzioni come Tork OptiServe e il programma Tork Focus4 Sustainability, offriamo alle aziende gli strumenti per soddisfare non solo i più elevati standard di igiene, ma anche per ridurre il loro impatto ambientale. ISSA Pulire è l’occasione perfetta per mostrare come Essity e Tork siano attivamente impegnate nella creazione di soluzioni che supportino le aziende nella transizione verso pratiche più sostenibili e responsabili», afferma Riccardo Trionfera, direttore commerciale Professional Hygiene Italia.
UN IMPEGNO RAFFORZATO
DA NUOVE SOLUZIONI INNOVATIVE
Tork propone tecnologie e servizi all’avanguardia per supportare le aziende nel percorso verso una gestione della pulizia più responsabile e orientata alla sostenibilità. Tra queste soluzioni, il sistema Tork Xpress® per asciugamani intercalati introduce un concetto di ef cienza compatta: grazie a una compressione del 50%, i dispenser possono contenere il doppio dei fogli, riducendo la frequenza di rifornimento e ottimizzando lo spazio di stoccaggio. La tecnologia compatta l’aria nelle confezioni, abbattendo del 27% l’uso di imballaggi e permettendo di trasportare quasi il doppio del volume per viaggio, con un impatto diretto sulla riduzione delle emissioni di CO2.
Attraverso l’iniziativa Tork Focus4Sustainability , l’azienda promuove un’igiene più ecologica grazie a soluzioni mirate. Il servizio Tork PaperCircle® consente di riciclare gli asciugamani di carta usati, riducendo la quantità di ri uti generati. Il di-

spenser SmartOne® ottimizza il consumo di carta, riducendolo no al 40%. Tutti i prodotti sono sviluppati per minimizzare gli imballaggi, sempli care la logistica e contribuire alla riduzione delle emissioni. Le certi cazioni EU Ecolabel e FSC garantiscono un impatto ambientale ridotto e una gestione responsabile delle risorse.
Tork Vision Pulizia sfrutta la raccolta e l’analisi dei dati in tempo reale per ottimizzare la gestione degli interventi. Questo sistema consente a Facility Manager e operatori del settore di monitorare con precisione quando e dove è necessario intervenire. Il risultato è una riduzione no al 20% delle ore dedicate alla pulizia e un incremento no al 30% nella soddisfazione degli utenti nali. L’adozione di questa soluzione migliora l’ef cienza operativa e garantisce il rispetto degli standard igienici più recenti.
Con il sistema Tork OptiServe®, l’azienda propone una carta igienica priva di anima e confezionata senza materiali super ui, riducendo i ri uti no al 92%. Il design compatto dei rotoli consente una maggiore autonomia, riducendo le scorte e semplicando la logistica interna. Le ricariche uni cate sempli cano la gestione dei servizi igienici e migliorano l’ef cienza operativa.
Anche in questo caso, le certi cazioni EU Ecolabel e FSC, unite all’utilizzo di energia rinnovabile nei processi produttivi, confermano l’impegno concreto nella riduzione dell’impatto ambientale.




Le macchine RCM con batterie al litio di ultima generazione rappresentano una soluzione ideale per migliorare le operazioni di pulizia professionale. Nel settore della pulizia professionale, l’ef cienza operativa è fondamentale e grazie a questa innovativa tecnologia la pulizia è ancor più ef ciente, economica e rispettosa dell’ambiente.
L’autonomia essibile consente di affrontare ogni tipo di intervento, dai lunghi turni di lavoro senza necessità di batterie di riserva, alle situazioni impreviste grazie alla possibilità di ricariche rapide, che raggiungono il 50% della carica in soli 60 minuti. Queste caratteristiche riducono i tempi di inattività e migliorano la produttività complessiva. Le batterie al litio sono no al 30% più ef cienti dal punto di vista energetico rispetto a quelle al piombo, AGM o gel, riducendo così i costi dell’elettricità e l’impatto ambientale. RCM offre un’ampia scelta di batterie e caricabatterie, anche on-board, garantendo la massima autonomia per operare su più turni e in qualsiasi ambiente sensibile.
Le batterie al litio di ultima generazione RCM offrono elevati standard di sicurezza grazie alla struttura sigillata che elimina la neces-
sità di manutenzione ordinaria e al sistema di gestione integrato che monitora costantemente le prestazioni. L’assenza di emissioni nocive le rende ideali anche per ambienti sensibili come ospedali, scuole e l’industria alimentare. Sono inoltre testate secondo rigidi standard internazionali e adottano chimiche molto più stabili e resistenti al fuoco.
Utilizzare le batterie al litio di ultima generazione permette alla macchina RCM di adattarsi a diverse esigenze operative, offrendo essibilità e af dabilità in vari contesti. Per questo motivo le batterie al litio sono disponibili per tutta la gamma di lavapavimenti e spazzatrici RCM.
Scegliere le batterie al litio per le macchine RCM signi ca investire in una tecnologia che migliora l’ef cienza operativa, riduce i costi di gestione e promuove la sostenibilità ambientale.
Per ulteriori informazioni e per scoprire la soluzione più adatta alle esigenze di pulizia, contatta RCM all’indirizzo comita@rcm.it.

















































































































































































ISSA PULIRE | Milano | 27-29 Maggio 2025








































Pad. 8 Stand K01-L02
























































Il bello di scegliere RCM è che non ti puoi sbagliare. Con due linee complete di lavapavimenti e motoscope per la pulizia professionale e un’ampia gamma di modelli in costante evoluzione, RCM ha esattamente la soluzione che cerchi. Macchine robuste, effi cienti, pensate per rendere ogni lavoro di pulizia più semplice e più rapido. In più RCM ti offre soluzioni per il noleggio e ti garantisce il miglior servizio di assistenza post vendita. Ecco perché con una macchina RCM non sbagli mai. Riconoscerla è facile, abbandonarla è impossibile!

La pulizia professionale delle superfici tra passato, presente e futuro. Un settore sempre più targato Made in Italy in continua espansione
MAURIZIO PEDRINI
Le macchine per la pulizia industriale rappresentano uno strumento indispensabile per numerosi settori dell’industria moderna, offrendo un’ef cace soluzione al ne di mantenere puliti e sicuri non solo gli ambienti di lavoro, ma anche i più importanti luoghi comunitari, nei quali si svolge la nostra quotidiana vita sociale: ospedali, scuole, centri commerciali, stazioni, aeroporti ecc.
La storia delle macchine - in primis lavasciuga pavimenti, moto spazzatrici, aspirapolvere e aspiratori industriali - ha visto un percorso di continua innovazione e trasformazione, a partire dai primi modelli manuali, no ad arrivare alle soluzioni automatizzate e intelligenti dei nostri giorni. Gli sviluppi tecnologici, insieme a un crescente interesse per l’ef cienza e la sostenibilità, hanno spinto il settore a ricercare costantemente, con crescente impegno rivolto alla ricerca, soluzioni sempre più ef cienti e performanti.
All’inizio del XX secolo, la pulizia degli ambienti era af data principalmente alla
forza lavoro umana e a strumenti rudimentali. Con l’avvento dell’industrializzazione, si è compresa la necessità di macchinari in grado di ridurre i tempi e i costi operativi, garantendo al contempo risultati di pulizia superiori. Al loro esordio sul grande palcoscenico del professional cleaning, le spazzatrici meccaniche vennero progettate e realizzate per pulire rapidamente vaste aree dei capannoni industriali, superando i metodi tradizionali basati sulla forza lavoro degli umili “pulitori”.
Nello stesso periodo, sono state introdotte le prime lucidatrici per la pulizia a umido del pavimento. I primi modelli erano probabilmente prototipi di macchine monospazzola che, mediante una spazzola smerigliatrice montata su una comune lucidatrice, rappresentavano la base per l’evoluzione delle moderne lavasciuga di varie forme e dimensioni.
Un grande passo avanti si è veri cato con l’introduzione delle macchine aspirapolvere industriali. Nonostante la limitata tecnologia dell’epoca, queste si dimostrarono signi cativamente più ef caci rispetto ai metodi precedenti, rappresentando un’in -
dubbia e cruciale innovazione nel campo della pulizia industriale. L’invenzione della prima aspirapolvere è attribuita a James Murray Spangler, un custode di grandi magazzini a Canton, Ohio, che soffriva d’asma. Nel 1907, Spangler creò una macchina utilizzando un palco di latta, una federa di raso e un manico di scopa. Questa macchina conteneva un motore elettrico alimentato da un ventilatore e una spazzola rotante. Il ventilatore espelleva l’aria da un’estremità della macchina attraverso la federa, mentre l’aria sporca sollevata dalla spazzola prendeva il suo posto.
Un’altra innovazione fondamentale è stata l’introduzione delle lavapavimenti progettate e costruite tra gli anni ’50 e ’60. Oltre ad essere più ef cienti e veloci, rispetto alla generazione precedente, esse bene ciavano anche dell’alimentazione elettrica. La loro ef cacia era notevolmente aumentata, poiché consentivano di pulire e asciugare i pavimenti in un solo passaggio. Un’altra pietra miliare nella storia del pulito pro-
MACCHINE PER LA PULIZIA INDUSTRIALE LE TAPPE DI UN’EVOLUZIONE
PRIME SPAZZATRICI
MECCANICHE
E LUCIDATRICI:
NASCE LA PULIZIA
INDUSTRIALE
MECCANIZZATA.
ARRIVANO LE
PRIME LAVASCIUGA
PAVIMENTI
ELETTRICHE:
PULIZIA E
ASCIUGATURA IN UN SOLO PASSAGGIO.
L’ITALIA SI AFFERMA
CON MODELLI
ARTIGIANALI
INNOVATIVI.
NASCONO LE
“UOMO A TERRA”.
Anni 2000
AUTOMAZIONE E
DESIGN SPINGONO
IL SETTORE
VERSO MACCHINE
CONNESSE E
SOSTENIBILI.

Oggi
INTELLIGENZA
ARTIFICIALE E IOT
PER MACCHINE
INTELLIGENTI, PERSONALIZZATE, GREEN.
fessionale è stata posta negli anni ’80 con la creazione delle lavasciuga pavimenti uomo a terra, dotate di spazzole a rullo che lavano, aspirano e spazzano in un unico passaggio. Tale miglioramento ha notevolmente incrementato le prestazioni di pulizia su pavimenti strutturati, come piastrelle stuccate o pietra naturale con superfici più ruvide, che erano diffuse nel Nord e Centro Europa.
04 / 2025
La produzione italiana ha saputo farsi strada anche in questo settore, grazie alla lungimiranza, alla tenacia e alla creatività dei primi fabbricanti “pionieri”, che - verso la metà degli anni ’70 - sperimentando nuovi prototipi con artigianale maestria - hanno costruito inediti modelli di lavasciuga pavimenti e motospazzatrici in semplici, umili
officine. Il loro successo è frutto di un felice connubio di precisione ingegneristica, innovazione tecnologica e raffinato design. In seguito, i produttori italiani, nelle piccole e medie imprese industriali concentrate soprattutto nel Nord Est e nel Centro-Nord Italia, hanno puntato su vari fattori. Anzitutto l’innovazione tecnologica, con investimenti in ricerca e sviluppo che hanno portato all’introduzione di sistemi di fil-
traggio e componenti di elevata af dabilità. E non da ultimo sul design ricercato, con un’estetica particolarmente curata e funzionale che, non solo rispondeva ai requisiti tecnici, ma anche alle esigenze ergonomiche degli operatori e agli standard di design richiesti dai mercati internazionali. A partire dagli anni ’80, le aziende italiane non hanno mai smesso - senza alcuna soluzione di continuità - di investire in innovazione: oltre al miglioramento delle funzionalità di base, esse sono state in grado di integrare progressivamente sistemi di automazione e digitalizzazione, anticipando così le tendenze globali nel settore della pulizia professionale.
L’AVVENTO TRAVOLGENTE DELL’ERA DIGITALE
La ne del XX secolo - come ben sappiamo - ha segnato l’inizio dell’era digitale. L’impiego di sensori e concetti della robotica ha portato all’introduzione delle macchine per la pulizia industriale totalmente automatiche. Meno di due secoli fa, i capannoni venivano puliti da squadre di persone con secchi e spazzoloni, mentre oggi disponiamo di macchinari autonomi, capaci di navigare all’interno del capannone, evitare ostacoli e pulire completamente il pavimento. Sono stati compiuti, insomma, enormi progressi anche dal punto di vista ecologico, con l’utilizzo di alimentazioni a batteria più ef cienti e processi di lavaggio che inquinano meno grazie a un consumo ridotto di acqua e detergenti. Negli ultimi anni, la convergenza tra industrializzazione e tecnologia dell’informazione ha aperto nuove, stimolanti prospettive. Oggi le macchine per la pulizia non sono più semplici dispositivi meccanici, ma veri e propri “sistemi intelligenti”, capaci innanzitutto di controllo remoto. Grazie alla connettività IoT (Internet of Things) gli operatori possono monitorare e gestire le macchine a distanza, ottimizzando i processi di manutenzione preventiva e
intervenendo rapidamente in caso di anomalie. Una seconda caratteristica è legata a sostenibilità e green technology: l’attenzione verso l’ambiente spinge lo sviluppo di motori a basso consumo, sistemi di riciclo dell’acqua e impiego di materiali ecocompatibili, rispondendo così alle crescenti richieste di conformità alle normative ambientali. Su questo scenario si è prepotentemente affacciata l’intelligenza arti ciale (IA): le macchine sempre più dotate di IA sono in grado di apprendere dall’uso quotidiano, adattandosi alle speci cità degli ambienti da pulire e migliorando continuamente le proprie prestazioni grazie ad algoritmi di machine learning. Questo permette, per esempio, di ottimizzare i percorsi di pulizia, riducendo consumi energetici e garantendo una copertura più accurata degli spazi.
DI MERCATO
Nonostante le incognite contingenti, i produttori italiani guardano con fiducia a nuovi mercati e s de internazionali. Le strategie spaziano a trecentosessanta gradi. Proviamo a sintetizzarle. Espansione nei settori high-tech: l’integrazione di funzionalità remote e sistemi intelligenti apre la porta a collaborazioni con aziende tecnologiche e start-up, contribuendo a creare ecosistemi di innovazione in cui i macchinari per la pulizia diventano componenti integrati di “smart building” e città intelligenti. Un fondamentale focus, ovviamente, riguarda la sostenibilità: l’adozione di tecnologie green non solo risponde a una crescente domanda di riduzione dell’impatto ambientale, ma rappresenta anche un elemento di differenziazione competitiva sui mercati esteri, dove la certi cazione ambientale è sempre più apprezzata. Un ultimo, fondamentale aspetto investe la cosiddetta “personalizzazione” dei modelli e dei servizi. Specialmente nel campo della fabbricazione di macchine impegnative
(lavasciuga pavimenti e motospazzatrici di medie e grandi dimensioni) si cerca di andare incontro alle speci che esigenze del cliente, adattando il prodotto con soluzioni sempre più personalizzate e intelligenti. Il futuro vedrà senz’altro un’accresciuta attenzione ai servizi post-vendita e all’assistenza a distanza. Con l’analisi dei dati raccolti in tempo reale, le macchine possono già ora suggerire interventi personalizzati, garantendo un accurato controllo dei processi lavorativi nei cantieri di lavoro e un’elevata ef cienza operativa.
In de nitiva, l’evoluzione delle macchine per la pulizia professionale delle super ci (lavasciuga pavimenti, moto spazzatrici, aspirapolvere e aspiratori industriali, ecc.) rappresenta un percorso davvero esemplare, del quale l’Italia intera deve andare era e orgogliosa. È la migliore testimonianza di come tradizione e innovazione possano integrarsi per creare soluzioni che rispondano pienamente alle esigenze di un mercato in continua evoluzione. I produttori italiani del settore sono i migliori interpreti della forza vincente delle PMI che costituiscono l’asse portante e vitale dell’economia italiana. Con la loro storica attenzione alla qualità, al design e al progresso tecnologico - ma anche con lo spirito di sacricio e l’intraprendenza che anima il loro operato - essi si confermano da tanti anni protagonisti indiscussi dell’export, capaci di proiettarsi al futuro, all’apertura di nuovi scenari attraverso il controllo da remoto, la sostenibilità e l’intelligenza arti ciale. Questo delicato equilibrio fra tradizione e innovazione, non solo rafforza la posizione italiana nel settore, ma suggerisce anche una promettente rotta per il futuro. Un futuro al quale guardare con ducia, in cui la pulizia professionale - ne siamo certidiventerà un esempio di ef cienza, rispetto ambientale e integrazione tecnologica.



















Amedics è riconosciuta come specialista nella disinfezione professionale. L’azienda offre una gamma di prodotti ad alto contenuto tecnico-scienti co, progettati per rispondere a esigenze speci che nei diversi ambiti applicativi.
La complessità di questi prodotti richiede un utilizzo consapevole, possibile solo attraverso informazioni chiare, complete e aggiornate. Comprendere a fondo le necessità degli utilizzatori è essenziale. Ogni prodotto presenta caratteristiche proprie, concentrazioni denite e tempi di contatto precisi che vanno rigorosamente rispettati per garantirne l’ef cacia.
Per questo motivo, Amedics investe costantemente nella formazione di venditori, agenti e distributori, rendendoli autonomi e preparati nel supportare i clienti con competenza e puntualità.
La formazione non è un’attività accessoria, ma una leva strategica: corsi chiari, ef caci e articolati permettono di costruire un bagaglio culturale coerente, capace di migliorare la qualità della vendita e di guidare il cliente verso scelte consapevoli.
A supporto delle funzioni commerciali, sono sempre disponibili il laboratorio di Ricerca e Sviluppo e l’uf cio Affari Regolatori, fondamentali per interpretare correttamente la normativa vigente su PMC e DM.
Amedics promuove un approccio integrato alla disinfezione, che inizia dalla scelta mirata del prodotto no alla sua applicazione corretta. Per facilitare questo percorso, l’azienda mette a disposizione materiali tecnici, schede informative dettagliate, corsi in presenza e online, webinar e aggiornamenti periodici. L’obiettivo è formare una rete solida di professionisti, in grado di prevenire errori, rafforzare la ducia del cliente nale e garantire sempre un alto standard di sicurezza.
Un altro punto distintivo è la consulenza personalizzata: ogni contesto applicativo viene analizzato in dettaglio per identi care le soluzioni più adatte al tipo di rischio e alle condizioni operative speci che. Questo approccio permette di ottimizzare le procedure e aumentare signi cativamente l’ef cacia degli interventi.
La combinazione tra competenza tecnica, supporto normativo e formazione costante rende Amedics un partner af dabile e reattivo, capace di rispondere alle s de di un mercato in continua trasformazione. In un settore in cui l’errore può avere conseguenze rilevanti, Amedics sceglie la via della competenza.
Un impegno quotidiano che mette al centro chi produce, chi vende e chi utilizza i prodotti. Perché solo un sistema formato e consapevole può davvero fare la differenza nella disinfezione professionale.



Ecolabel UE, nato nel 1992 e riconosciuto in tutti i Paesi dell’Unione Europea, ha segnato la svolta green della detergenza professionale. Non si tratta di un semplice “bollino verde”, ma di una certificazione che richiede un reale impegno da parte dei produttori
MAURIZIO PEDRINI
Negli ultimi anni, il settore della pulizia professionale ha vissuto una signi cativa trasformazione. Non si è trattato solo del frutto di tecnologie più performanti o di formulazioni sempre più ef caci, ma di un cambio di paradigma verso la sostenibilità ambientale. In questo scenario, il marchio Ecolabel UE rappresenta una garanzia sempre più riconosciuta e richiesta, sia in Italia che nel resto d’Europa, una sorta di spartiacque a garanzia di assoluta qualità nalizzata al rispetto dell’ambiente. Ma cerchiamo anzitutto di capire bene di cosa stiamo parlando. L’Ecolabel europeo è un marchio di qualità ecologica nato nel 1992,
tendenze green
84.000 prodotti certificati Ecolabel UE
1.000 aziende con almeno una linea certificata 28 categorie merceologiche coperte
(Fonte Commissione Europea 2024)

riconosciuto in tutti i Paesi dell’Unione Europea, che certi ca prodotti e servizi con un ridotto impatto ambientale durante l’intero ciclo di vita. Quando si parla di detergenti professionali – che siano per super ci, pavimenti, lavanderie o lavastoviglie industriali – avere l’Ecolabel signi ca garantire un equilibrio tra ef cacia del prodotto e tutela dell’ambiente. I criteri Ecolabel vengono periodicamente aggiornati in base agli avanzamenti tecnologici e scienti ci, e coprono aspetti quali: la biodegradabilità, la tossicità acquatica, le emissioni, il packaging e persino l’ef cienza d’uso. Non si tratta perciò – è bene sottolinearlo – di un semplice bollino “verde”, ma di una certi cazione che richiede un reale impegno da parte dei produttori.
Dietro al marchio Ecolabel c’è un sistema di controllo assai rigoroso, basato su autorità competenti, valutatori tecnici e norme europee. È utile, pertanto, sapere chi rilascia la certificazione in talia e quali siano gli enti preposti a garantire la trasparenza del processo
I CARDINI DEL SISTEMA NAZIONALE l punto di ri erimento istituzionale il inistero dell mbiente e della Sicurezza nergetica S , che svolge il coordinamento nazionale in materia di politiche ambientali e, in particolare, attua le direttive europee in tema di etichettature ecologiche ccanto al S , l S stituto Superiore per la rotezione e la icerca Ambientale agisce come Organismo competente per l colabel in talia, in base a quanto stabilito dal egolamento n S svolge molteplici compiti riceve le domande da parte delle aziende richiedenti e ettua i controlli tecnici e documentali valuta la con ormità ai criteri stabiliti dalla ommissione uropea rilascia u cialmente il marchio colabel
UN PROCESSO TRASPARENTE E TRACCIABILE a procedura di richiesta colabel, volontaria, ma estremamente strutturata, prevede il seguente percorso:
1. Fase istruttoria l azienda compila il ascicolo tecnico dimostrando la con ormità del prodotto
2. Valutazione S analizza il dossier, richiede prove, campioni e può e ettuare audit
3. Approvazione: se il prodotto risponde a tutti i criteri, viene pubblicato nel registro europeo Ecolabel.
4. Controlli periodici sono previste verifiche anche successive al rilascio, per con ermare il mantenimento dei requisiti
IL VALORE PUBBLICO DELLA CERTIFICAZIONE di erenza di altri marchi privati o volontari, l colabel UE ha un valore legale, poiché rilasciato da un ente pubblico in attuazione di una normativa comunitaria Questo lo rende particolarmente riconosciuto e credibile nei bandi pubblici, dove spesso viene esplicitamente indicato nei come marchio pre erenziale
PERCHÉ È IMPORTANTE
Nel contesto della detergenza professionale, l’Ecolabel è diventato uno strumento a dir poco strategico. Infatti, sempre più gare d’appalto - soprattutto nella Pubblica Amministrazione - richiedono prodotti certicati o dimostrano di preferirli nei Criteri Ambientali Minimi (CAM). Inoltre, molte aziende clienti pongono attenzione alla sostenibilità come elemento distintivo, e ciò spinge anche i fornitori di servizi di pulizia a rivedere le proprie scelte. Dal punto di vista operativo, utilizzare detergenti Ecolabel comporta bene ci anche per gli operatori: minore impatto sulla salute, minor utilizzo di sostanze irritanti, e spesso una maggiore sicurezza nella manipolazione quotidiana.
LA CORNICE REGOLATORIA
Il marchio Ecolabel, regolamentato dal Regolamento CE n. 66/2010, certi ca che un prodotto ha un impatto ambientale ridotto durante l’intero ciclo di vita. Per i detergenti professionali (per super ci dure, sanitari, stoviglie, lavanderia, ecc.) i criteri tecnici sono de niti e aggiornati dalla Commissione Europea e prevedono: limiti stringenti su sostanze pericolose e allergeni; elevata biodegradabilità; ef cacia testata con prove comparabili; requisiti sull’imballaggio (materiali riciclati, design riciclabile); indicazioni precise sull’etichettatura e le modalità d’uso.
LA LEGGE SUGLI APPALTI PUBBLICI
In Italia, la legge sugli Appalti Pubblici (D.Lgs. 36/2023, ex Codice Appalti) impone l’applicazione dei CAM – Criteri Ambientali Minimi. Questi richiedono esplicitamente, per molti bandi relativi ai servizi di pulizia, l’uso di prodotti con Ecolabel o con caratteristiche ambientali equivalenti. In pratica, possedere questa certi cazione può (o dovrebbe, come speriamo) fare la differenza tra partecipare a una gara o essere esclusi.
Indubbiamente, possedere prodotti certicati Ecolabel costituisce un chiaro vantag-
gio competitivo, soprattutto in Italia, dove la spinta verso gli acquisti verdi (Green Public Procurement - GPP) è cresciuta costantemente.
In sostanza, imprese che offrono detergenti con questo marchio godono di tutta una serie di vantaggi competitivi: guadagnano punteggio negli appalti pubblici; si posizionano come fornitori af dabili e responsabili; attraggono clienti privati sensibili alla sostenibilità; migliorano la reputazione e il posizionamento del brand; rispondono in anticipo a possibili future regolamentazioni obbligatorie.
Inoltre, sempre più multinazionali e grandi gruppi privati inseriscono nei capitolati richieste ambientali stringenti.
Essere già in linea con gli standard Ecolabel signi ca anticipare il mercato, riducendo il rischio di esclusione e migliorando la competitività.
Il contesto attuale - tra con itti internazionali, minacce di nuovi dazi doganali, aumento dei prezzi energetici e dif coltà di approvvigionamento delle materie prime - sta accelerando una ri essione profonda nel mondo della detergenza.
Produrre in modo sostenibile non è più solo una scelta etica, ma anche una strategia di resilienza industriale.
I prodotti Ecolabel, che richiedono formule più semplici, biodegradabili e meno dipendenti da sostanze critiche o derivati petrolchimici, possono contribuire a contenere i costi di produzione nel lungo periodo e a diversi care la supply chain. Inoltre, i fondi europei del PNRR e i programmi di transizione ecologica premiano le imprese con approccio green, con accesso agevolato a nanziamenti, agevolazioni e incentivi per l’innovazione.
La vera s da per il futuro della detergenza professionale sarà passare da una visione “di prodotto” a una trasformazione del processo produttivo e distributivo.
Avere l’Ecolabel non deve essere solo un traguardo, ma un punto di partenza per tutta una serie di ulteriori salti di qualità. Ne elenchiamo soltanto alcuni: investire in formazione degli operatori; digitalizzare le schede tecniche e i sistemi di monitoraggio; progettare imballaggi a impatto zero; ridurre l’uso di acqua e plastica; costruire liere locali e circolari.
Solo in questo modo, a nostro avviso, la certi cazione potrà diventare un reale valore aggiunto per tutti gli attori: produttori e clienti, ma - soprattutto - ambiente.
Accanto all’Ecolabel stanno emergendo altri marchi e certi cazioni che puntano a una detergenza sempre più green. Tra i più noti a livello europeo troviamo Nordic Swan (Paesi Nordici), molto rigido nei criteri ambientali, Blauer Engel (Germania), uno dei primi marchi ecologici al mondo, A.I.S.E. Charter for Sustainable Cleaning, più orientato all’impegno aziendale che al singolo prodotto.
In Italia, si sta sviluppando notevolmente anche l’interesse per etichette volontarie come CAM compliant, che segnalano la conformità ai criteri ambientali minimi de niti dal Ministero dell’Ambiente.
La s da, oggi, è far sì che questi marchi non siano solo strumenti di marketing, ma reali indicatori di un cambiamento di processo.
Servono trasparenza, formazione degli operatori e un impegno comune lungo tutta la liera: dal produttore al distributore, no a chi il prodotto lo utilizza ogni giorno.
In conclusione, ci sentiamo di poter convintamente affermare che l’Ecolabel non è solo un’etichetta: è una promessa, un patto con l’ambiente e con la salute delle persone. In un settore di grande importanza strategica come quello della pulizia professionale, scegliere prodotti certicati è un passo concreto verso un futuro più sostenibile e anche più competitivo, perché pulire bene oggi signi ca pensare davvero al domani.












procedureprevenzione

Gli operatori del cleaning professionale si trovano quotidianamente a gestire situazioni che possono comportare rischi significativi per la loro salute e sicurezza. È quindi essenziale comprendere il valore di un approccio sistematico alla prevenzione degli incidenti e alla protezione delle lavoratrici e dei lavoratori
Tutte le attività lavorative comportano dei rischi. Per rischio si intende la probabilità che si veri chi un evento pericoloso indesiderato in grado di causare un danno. Un infortunio è un evento indesiderato e non piani cato, che causa una lesione o una malattia.
La sicurezza sul lavoro continua a essere un tema centrale, con dati allarmanti che evidenziano la necessità di interventi concreti. In Italia, nei primi mesi del 2025, il numero di incidenti sul lavoro ha registrato un aumento signi cativo, con un incremento degli infortuni e delle cosiddette “morti bianche”. Questo scenario ha spinto istituzioni e parti sociali a intensi care gli sforzi per migliorare le condizioni lavorative e garantire maggiore tutela ai lavoratori. Secondo gli ultimi dati disponibili, il numero di vittime sul lavoro ha superato le 200 unità nel primo trimestre dell’anno, con un incremento rispetto al 2024. Gli incidenti più gravi si sono veri cati in settori ad alto rischio come l’edilizia, la logistica e l’industria manifatturiera. Le cause principali restano la scarsa formazione, la mancanza di dispositivi di sicurezza adeguati e il mancato rispetto delle normative vigenti.
LE NUOVE MISURE DEL GOVERNO
Di fronte a questa emergenza, il governo ha annunciato un pacchetto di interventi mirati a rafforzare la sicurezza nei luoghi di lavoro. Tra le misure più signi cative, spicca lo stanziamento di un miliardo di euro per incentivare le aziende a investire in prevenzione e formazione. Inoltre, è stato introdotto un sistema di incentivi per le imprese che dimostrino un impegno concreto nella tutela dei lavoratori, premiando chi adotta protocolli di sicurezza avanzati.
IL RUOLO DELLE AZIENDE E DEI SINDACATI
Le aziende sono chiamate a un ruolo attivo nella promozione della sicurezza, investen-

La pulizia professionale è sinonimo di salute pubblica e benessere collettivo. Se chi pulisce lavora con i giusti dispositivi di protezione individuale (DPI), utilizza metodi sicuri e attrezzature e cienti, il risultato finale sarà un ambiente più sicuro per chi lo abita.
Chiunque usufruisca di un ambiente pulito dovrebbe comprendere l’importanza delle misure adottate e sostenerle
do in tecnologie innovative e programmi di formazione per i dipendenti. I sindacati, dal canto loro, continuano a chiedere controlli più severi e sanzioni più dure per chi non rispetta le norme. La collaborazione tra istituzioni, imprese e lavoratori è fondamentale per ridurre il numero di incidenti e garantire un ambiente di lavoro più sicuro.
DEL CLEANING PROFESSIONALE
Il mantenere gli spazi puliti e ordinati implica l’uso di attrezzature speci che, prodotti chimici e tecniche che, se non gestiti correttamente, possono diventare pericolosi. Gran parte degli infortuni nel settore delle pulizie sono di lieve entità, tuttavia capitano anche incidenti gravi e mortali. L’entità del rischio dipende da vari fattori: il tipo di lavoro svolto (con macchinari, con strumenti, con prodotti pericolosi, ecc.); le competenze professionali acquisite (formazione e addestramento); il grado di conoscenza e consapevolezza dei lavoratori relativamente ai rischi.
Rischio chimico: l’uso di detergenti e prodotti chimici può causare irritazioni cutanee, problemi respiratori e altre reazioni avverse.
isc io fisico: movimenti ripetitivi, posture scorrette e l’uso di attrezzature pesanti possono portare a disturbi muscoloscheletrici.
Rischio biologico: gli operatori possono essere esposti a batteri, virus e altri agenti patogeni durante la pulizia di ambienti contaminati.
Rischio ergonomico: l’uso di attrezzature non adeguate o mal progettate può aumentare il rischio di infortuni.
Nel valutare le misure di prevenzione per mitigare i rischi occorre tenere presente che la sicurezza non è solo una questione di protezione individuale, ma anche di efcienza operativa. Un ambiente di lavoro sicuro favorisce la produttività, riduce i tempi di inattività causati da incidenti e migliora la qualità del servizio offerto. In questo la formazione gioca un ruolo decisivo. Gli operatori devono essere adeguatamente istruiti non solo sull’uso corretto delle attrezzature e dei prodotti, ma anche sulle procedure di emergenza e sulle tecniche di prevenzione dei rischi. La formazione continua non solo migliora la consapevolezza dei lavoratori, ma contribuisce anche a creare una cultura della sicurezza all’interno dell’azienda.
IL RISCHIO CHIMICO
I prodotti chimici sono essenziali per la pulizia e la sani cazione, ma possono rappresentare un pericolo significativo per la salute degli operatori se non utilizzati correttamente. La natura stessa di questi prodotti, spesso altamente concentrati e formulati per essere ef caci contro sporco e batteri, li rende potenzialmente dannosi per chi li maneggia.
L’esposizione diretta è uno degli aspetti più critici del rischio chimico. I detergenti, i di-
Solo attraverso un impegno condiviso tra aziende e lavoratori è possibile creare un ambiente di lavoro più sicuro e sostenibile, promuovendo standard elevati di qualità e sicurezza.
sinfettanti e gli sgrassanti possono causare irritazioni cutanee, problemi respiratori e, in alcuni casi, danni agli occhi. L’inalazione di vapori chimici o il contatto prolungato con la pelle sono tra le principali cause di questi effetti negativi. Inoltre, la miscelazione impropria di prodotti chimici può generare reazioni pericolose, come la formazione di gas tossici.
La gestione del rischio chimico richiede un approccio sistematico. È essenziale che i lavoratori comprendano l’importanza di leggere le etichette e le schede di sicurezza dei prodotti, che forniscono informazioni dettagliate sulle modalità d’uso e sulle precauzioni da adottare. Inoltre, l’uso di dispositivi di protezione individuale, come guanti, maschere e occhiali, è indispensabile per ridurre l’esposizione diretta. Altro elemento essenziale è la ventilazione degli ambienti di lavoro. Lavorare in spazi chiusi senza un adeguato ricambio d’aria può aumentare la concentrazione di vapori chimici.
Tra i sici, il più comune è rappresentato dall’esposizione a super ci scivolose. Durante le operazioni di pulizia, l’uso di acqua e detergenti può rendere i pavimenti particolarmente insidiosi, aumentando il
rischio di cadute. Questo problema è particolarmente rilevante in ambienti come cucine industriali, ospedali e grandi strutture commerciali, dove il traf co di persone e l’urgenza delle operazioni possono amplicare il pericolo. Macchinari pesanti o ingombranti come aspirapolvere industriali, lucidatrici e idropulitrici richiedono forza sica e attenzione per essere maneggiati in sicurezza. Un utilizzo improprio o una manutenzione inadeguata di queste attrezzature può causare infortuni, come schiacciamenti, urti o lesioni muscolari. Le vibrazioni generate da alcune attrezzature, come le lucidatrici, possono avere effetti negativi sulla salute degli operatori, causando disturbi al sistema mano-braccio se utilizzate per periodi prolungati. Allo stesso modo, l’esposizione a rumori elevati, tipica di alcuni macchinari, può portare a problemi di udito se non vengono utilizzati adeguati dispositivi di protezione. Inoltre, il trasporto e il sollevamento di carichi pesanti, come secchi d’acqua o contenitori di prodotti chimici, rappresentano un ulteriore fattore di rischio, soprattutto se non vengono adottate tecniche corrette di movimentazione. Per affrontare il rischio sico le aziende devono investire in attrezzature ergonomiche e sicure, progettate per ridurre lo sforzo sico e minimizzare i pericoli e prevedere l’uso di dispositivi di protezione individuale, come scarpe antiscivolo, guanti e cuf e antirumore, può fare la differenza nel prevenire incidenti.
Gli operatori spesso si trovano a lavorare in ambienti che possono esporli a una vasta gamma di agenti biologici, come batteri, virus, funghi e muffe. Questi agenti, se non gestiti correttamente, possono rappresentare una minaccia signi cativa per la salute, causando infezioni, allergie o intossicazioni. La natura stessa del lavoro di pulizia implica un contatto diretto con super ci e materiali potenzialmente contaminati. Ad esempio, negli ospedali o nelle strutture sanitarie, gli operatori possono entrare in
contatto con uidi corporei o ri uti biologici, aumentando il rischio di esposizione a patogeni pericolosi. Anche in ambienti meno critici, come uf ci o spazi commerciali, la presenza di muffe o polveri può rappresentare un rischio per la salute. Per ridurre il rischio biologico gli operatori devono essere adeguatamente istruiti sulle procedure di sicurezza e sull’uso corretto dei dispositivi di protezione individuale, come guanti, maschere e occhiali protettivi. Pratiche di lavoro sicure includono poi l’uso di prodotti disinfettanti ef caci, la corretta gestione dei ri uti biologici e la sani cazione regolare delle attrezzature.
Questo tipo di rischio si manifesta principalmente attraverso posture scorrette, movimenti ripetitivi e l’uso di attrezzature non adeguate, che possono causare problemi muscolo-scheletrici e compromettere la salute a lungo termine.

Formazione del personale: gli operatori devono essere formati sui rischi specifici del settore e sulle procedure di sicurezza.
Utilizzo di dispositivi di protezione individuale (DPI): guanti, maschere, occhiali protettivi e calzature antiscivolo sono essenziali per proteggere i lavoratori.
Manutenzione delle attrezzature: Le macchine e gli strumenti utilizzati devono essere regolarmente controllati e mantenuti in buone condizioni.
Gestione sicura dei prodotti chimici: è importante seguire le istruzioni del produttore e conservare i prodotti in modo sicuro.
Gli operatori del cleaning professionale si trovano spesso a lavorare in condizioni che richiedono sforzi sici signi cativi. Ad esempio, il sollevamento di carichi pesanti, come secchi d’acqua o macchinari, può mettere a dura prova la schiena e le articolazioni. Inoltre, l’uso prolungato di attrezzature vibranti può provocare disturbi al sistema mano-braccio. Un altro aspetto critico è rappresentato dai movimenti ripetitivi, come lo stro namento di super ci o il lavaggio manuale di pavimenti. Questi gesti, se eseguiti senza pause adeguate o senza l’uso di strumenti ergonomici, possono portare a in ammazioni e dolori cronici. Anche le posture scorrette, spesso adottate per raggiungere aree dif cili, contribuiscono a incrementare il rischio di lesioni. Per affrontare il rischio ergonomico, è essenziale adottare un approccio preventivo. Questi problemi non solo in uiscono sulla salute degli operatori, ma possono anche ridurre la loro produttività e aumentare i costi per le aziende a causa di assenze per malattia o infortuni. Le aziende sono dunque chiamate ad investire in attrezza-


ianifica ione elle atti it : organizzare il lavoro in modo da ridurre lo stress fisico e mentale degli operatori.
re i lavoratori, migliorare l’ef cienza operativa e costruire una reputazione positiva delle aziende che operano nel mercato. Il datore di lavoro ha la responsabilità di valutare tutti i rischi e adottare le misure di prevenzione e protezione più utili al ne di prevenire gli infortuni e le malattie professionali.
L’attuale approccio alla prevenzione del rischio sul posto di lavoro si inscrive nella de nizione dell’organizzazione Mondiale della sanità (OMS), che considera la salute non solo come assenza di malattia, ma anche come benessere sico, mentale e sociale delle persone.
La sicurezza deve essere vista come un investimento nel futuro, capace di generare bene ci tangibili sia per i lavoratori che per l’organizzazione. Solo attraverso un impegno costante e una gestione responsabile è possibile trasformare il cleaning professionale in un settore realmente sicuro e sostenibile.
ture ergonomiche, progettate per ridurre lo sforzo sico e migliorare la postura degli operatori. La formazione del personale deve mirare a insegnare tecniche corrette di sollevamento e movimentazione, nonché per promuovere l’importanza di fare pause regolari durante il lavoro.
Investire nella sicurezza non è solo un obbligo morale e legale, ma anche una strategia vincente. Garantire la sicurezza sul lavoro, rispettando le normative vigenti in materia di sicurezza consente di evitare sanzioni legali, ma è anche un elemento essenziale per protegge-
La sicurezza sul lavoro non è solo una questione normativa, ma un valore fondamentale che deve essere difeso con determinazione. Solo attraverso un impegno collettivo sarà possibile garantire condizioni di lavoro dignitose e ridurre il numero di tragedie che, ancora oggi, segnano profondamente il mondo del lavoro.



Nell’ambito della pulizia professionale, l’ef cacia e l’igiene rappresentano requisiti imprescindibili. In questo contesto, il panno multiuso Micro-Antibact sviluppato dal reparto Ricerca & Sviluppo di Arix Pro si distingue per prestazioni tecniche avanzate e una progettazione mirata a soddisfare le esigenze degli operatori professionali.
Il valore aggiunto del Micro-Antibact risiede nella sua capacità di combinare potere pulente e controllo microbiologico. Il panno è sottoposto a un trattamento biocida a base di cloruro d’argento, testato secondo la norma ISO 20743:2021. Tale trattamento contrasta ef cacemente la proliferazione di microrganismi come Staphylococcus aureus ed Escherichia coli tra le bre. Questo accorgimento consente al panno di rimanere igienizzato anche dopo numerosi cicli di lavaggio, per un minimo di 30, contribuendo a contenere la formazione di cattivi odori e garantendo un utilizzo più sicuro in ambienti critici.
Sul piano della struttura, il Micro-Antibact si avvale di micro bre ultrasottili, composte per l’88% da poliestere e per il 12% da poliammide. Questa combinazione di materiali favorisce un’elevata capacità assorbente e una rimozione dello sporco estremamente ef cace, anche in presenza di residui grassi o secchi. La nitura super ciale in poliuretano svolge una duplice funzione: da un lato permette una pulizia omogenea e senza aloni su super ci delicate e ri ettenti; dall’altro agevola il rilascio dello sporco durante le ope-
razioni di risciacquo, prolungando la durata del panno e riducendo i tempi operativi. Un altro aspetto rilevante è la speciale tessitura, che impedisce il rilascio di pelucchi e previene lo s lacciamento del panno, anche dopo un uso intensivo. Questo lo rende particolarmente adatto per l’impiego su super ci come vetro, acciaio e inox, che richiedono niture impeccabili senza segni o striature. In molti casi, un’unica passata è suf ciente per ottenere un risultato visibilmente brillante, ottimizzando le risorse e i tempi nei servizi di pulizia professionale.
Il formato di 35x38 cm e la grammatura di 240 g/mq assicurano una maneggevolezza ideale per l’uso quotidiano, sia in contesti Cleaning sia nel settore Horeca, dove le normative igieniche impongono standard elevati. Il panno è disponibile in quattro colorazioni differenti, un dettaglio tutt’altro che secondario: la codi ca cromatica consente di adottare sistemi di pulizia a zone, prevenendo la contaminazione crociata e migliorando l’organizzazione operativa. Micro-Antibact è parte integrante della gamma di strumenti Arix Pro con trattamento antibatterico, che include anche spugne abrasive, panni pavimento e mop. L’intera linea è concepita per offrire una risposta concreta alle esigenze di pulizia professionale, con un approccio orientato alla sicurezza, all’ef cienza e alla sostenibilità operativa.











È tutta italiana la recente iniziativa associativa nel settore
della bonifica dei sistemi di aspirazione, che riunisce aziende leader e professionisti specializzati
MAURIZIO PEDRINI
Una nuova importante realtà si affaccia nella filiera della pulizia professionale: l’Associazione Boni catori Sistemi Aspirazione (ANBSA). I servizi svolti dalle imprese appartenenti al comparto sono mirati particolarmente alla manutenzione delle cappe d’aspirazione sia della ristorazione in strutture di grandi dimensioni, come mense, alberghi e altre realtà ricettive, sia di ristoranti privati. L’intenzione dei fondatori è quella di dar vita a una rete di aziende, caratterizzate da un’elevata professionalità, capaci di affrontare le problematiche di pulizia degli impianti di aspirazione all’insegna di un’elevata competenza, attraverso percorsi comuni e condivisi.
Abbiamo incontrato il presidente, Edoardo Brazzarola, per conoscere meglio questo nuovo sodalizio, che si inserisce a pieno
titolo nella grande liera del cleaning professionale e della cultura del pulito.
Innanzitutto, le chiederei di presentarci la sua Associazione: con quale scopo è sorta e chi ne fa parte?
ANBSA è nata nel 2024, con l’intento di unire e rappresentare le aziende e i professionisti specializzati nella boni ca dei sistemi di aspirazione. L’esigenza di costituire un’associazione è maturata dalla consapevolezza di quanto oggi rivesta un’importanza fondamentale garantire l’ef cienza, la sicurezza e la qualità dell’aria negli impianti d’aspirazione all’interno degli ambienti in cui viviamo e lavoriamo. Dell’ANBSA fanno parte imprese altamente quali cate, che hanno al loro interno tecnici certi cati, consulenti e formatori del
settore. I soci fondatori sono le aziende Entasys, Kappagras, Aia Servizi e ATS. Prima di far nascere ANSBA ci conoscevamo da tempo ed avevamo intrapreso un percorso di condivisione a livello professionale supportato da ottimi rapporti personali.
Come pensate di operare, a breve e lungo termine, per divulgare una maggior sensibilizzazione sulla pulizia e sani cazione di sistemi di aspirazione?
Tra gli obiettivi a breve termine, il primo è sicuramente quello di far crescere e consolidare la nostra rete associativa, promuovendo una maggiore consapevolezza tra gli operatori del settore, aumentando ovviamente il numero di aziende altamente specializzate, associate ad ANBSA sul territorio nazionale. Le stesse dovranno

Edoardo Brazzarola è un imprenditore specializzato nella bonifica e sanificazione di cappe aspiranti e sistemi fumari, attivo da anni nel settore della pulizia professionale. È alla guida di SPZ Italia Group Srl, evoluzione dell’originaria Spazzacamino Italia, fondata da suo padre Claudio Brazzarola nel 2015, avendo una visione e acquistando i macchinari quando ancora il mercato italiano non era a conoscenza di questo servizio. Sotto la sua direzione, l’azienda ha ampliato i propri servizi, affermandosi a livello nazionale come punto di riferimento per la sanificazione nel settore Horeca SPZ Italia Group opera oggi con sedi a Lucca amministrativa, Vicenza, Milano e Bologna operative, offrendo interventi pro essionali e certificati per la sicurezza e l e cienza degli impianti di aspirazione. Edoardo è anche attivamente impegnato nella promozione della formazione tecnica e della cultura della prevenzione nel settore.
operare secondo gli standard previsti da un protocollo operativo ben de nito, con l’aiuto di professionisti, nella persona di
Giacomo Saliniti, che ci garantiscano un elevato sostegno a livello normativo e formativo. Stiamo lavorando per rafforzare la nostra visibilità istituzionale, non solo facendoci portavoce in tutte le sedi delle speci che esigenze dei nostri iscritti, ma anche promuovendo incontri con soggetti e associazioni interessati alle nostre proposte operative. A lungo termine, vorremmo che ANBSA divenisse un punto di riferimento per l’intero comparto, contribuendo a denire sempre meglio le linee guida tecniche e professionali per la boni ca delle cappe in ambito nazionale, in modo tale da garantire agli operatori di sviluppare davvero una cultura dell’igiene sempre più diffusa e mirata a questa tipologia di manutenzione. Il tutto grazie ad appositi percorsi formativi e campagne di sensibilizzazione, a benecio della sicurezza, della salute e del benessere dei clienti nali.
Potrebbe brevemente descrivere la vostra attività, specialmente quella di
boni ca periodica delle cappi aspiranti nell’ambito della ristorazione?
La boni ca periodica delle cappe aspiranti è essenziale sia per motivi igienico-sanitari che di sicurezza: infatti la cucina e i condotti di aspirazione accumulano nel tempo grassi e residui di combustibili che, se non rimossi regolarmente, vanno incontro ad un grave rischio d’incendio, diventando comunque un vero e proprio ricettacolo di batteri contaminanti. Una manutenzione trascurata, evidentemente, compromette l’ef cienza dell’impianto in termini di consumi energetici e riduce progressivamente la qualità dell’aria respirata dagli addetti all’interno della cucina. A nostro avviso, la boni ca non va vista affatto come una spesa accessoria, ma quale investimento necessario per tutelare la salute degli operatori, la qualità del cibo e l’ottimale mantenimento dell’impianto.
Veniamo alla situazione in Italia, Paese dove i ristoranti e le mense vengono
regolarmente frequentati da milioni di persone: l’attenzione e la sensibilità a questo problema, da parte dei cuochi e dei gestori delle attività di ristorazione, è adeguata?
Negli ultimi anni abbiamo osservato una crescente considerazione a questa delicata problematica da parte di molti gestori, chef, addetti al reparto manutenzioni e della grande distribuzione organizzata. Ciò si è reso maggiormente evidente specialmente nelle realtà meglio strutturate e attente alla qualità complessiva del servizio. Tuttavia, dobbiamo riconoscere che nel panorama italiano la sensibilità verso la boni ca periodica delle cappe è ancora un po’ disomogenea. Molti ristoratori, per mancanza d’informazione o errata percezione del rischio, tendono ad intervenire solo in caso di malfunzionamento evidente, oppure solamente dopo aver subito dei controlli ispettivi da parte degli enti preposti. Il nostro compito, come ANSBA, è proprio quello di colmare, possibilmente, questo gap culturale. Lavoriamo per sensibilizzare gli operatori del settore sul fatto che la manutenzione si può attuare semplicemente seguendo una buona prassi come previsto dal nostro protocollo, perché è anzitutto un atto di concreta responsabilità verso il cliente. Fortunatamente stiamo assistendo ad un crescente interesse per la formazione e gli interventi certi cati: soprattutto fra le nuove generazioni di imprenditori impegnati nella ristorazione; il cambio generazionale in atto sta aiutando molto a sensibilizzare e aumentare sempre di più l’aspetto manutentivo degli impianti di aspirazione.
A quali rischi vanno incontro i gestori degli impianti di ristorazione trascurando questa problematica igienica? Ha qualche esperienza signi cativa da ricordare al riguardo? Trascurare la manutenzione periodica delle cappe di aspirazione comporta molti rischi, sia dal punto di vista della sicurezza che della salute. Il rischio principale è quello relativo al pericolo d’incendio, dovuto alla
presenza di residui in ammabili all’interno delle cappe e delle condotte; in secondo luogo va evidenziata la proliferazione batterica che compromette la salubrità dei luoghi di lavoro. In passato, nel corso della mia attività professionale, ho dovuto affrontare anche situazioni piuttosto preoccupanti. Va detto, inoltre, che sta aumentando costantemente l’esercizio del controllo da parte delle Asl all’interno dei locali; a volte - in presenza di gravi carenze - si procede addirittura al fermo delle attività, se non viene rigorosamente effettuata una pulizia e sanicazione certi cata dell’impianto. Il nostro compito è quello di comprovare, se è tutto in regola, che è avvenuta una vera e propria boni ca. Ma non bisogna perdere tempo e procedere. Al riguardo, racconto un episodio emblematico: sono stato contattato un venerdì pomeriggio da un cliente che doveva effettuare una vera e propria boni ca della cappa aspirante, a seguito di un controllo dell’Asl: purtroppo, quando mi sono recato ad effettuare il sopralluogo, il lunedì successivo, il locale era andato a fuoco.
Come si svolge operativamente l’intervento di una vostra azienda associata?
Il primo passo è l’accurata valutazione preliminare del sistema di aspirazione, per cui si procede all’ispezione della cappe dei condotti e di tutti i componenti dell’impianto, allo scopo di veri care lo stato di salute complessivo dell’apparato e capire qual è l’intervento più adatto da eseguire. Una volta compiuta questa analisi, si procede alla pulizia vera e propria, impiegando speci ci strumenti professionali: spazzole rotanti, detergenti, prodotti chimici, aspiratori ad alta capacità aspirante. Questo processo serve a rimuovere grassi, residui di cibo e impurità di vario genere che si accumulano sulle varie superfici della cappa. È importante sottolineare che i nostri addetti operano su tutto l’impianto, quindi a partire dalle cappe, anche su tubazioni interne e motori. Infatti, l’intero impianto deve essere tenuto scrupolosamente sotto controllo.
Quanto è importante, per ANBSA la formazione, la quali cazione e l’aggiornamento professionale degli addetti?
La formazione, la qualificazione e l’aggiornamento professionale degli operatori rappresentano per le nostre aziende altrettanti pilastri fondamentali. Costituiscono, insomma, uno dei presupposti essenziali per fornire servizi caratterizzati da standard qualitativamente elevati, con la precisa volontà di restare sempre al passo con le innovazioni tecnologiche, le normative per la sicurezza e le migliori pratiche di un settore in continua evoluzione. Attualmente all’interno di ANBSA abbiamo inserito due speci ci livelli di formazione: il primo è l’OSBC, operatore specializzato boniche del grasso e l’altro - dopo circa diciotto mesi - l’IIA, ispettore impianti aspirazione. In questo modo puntiamo a fornire sempre al cliente nale la massima competenza professionale in materia.
Come vede il futuro delle vostre aziende, anche in relazione alle eventuali possibilità di espansione all’estero?
L’associazione guarda al futuro con grande fiducia e ottimismo perché le nostre aziende stanno crescendo costantemente sul mercato grazie a una notevole capacità di adattamento alle nuove esigenze e alle normative.
La domanda, nei nostri confronti, è in ascesa sia a livello nazionale che internazionale. All’estero esistono l’International Kitchen Exhaust Cleaning Association (IKECA), un’associazione di riferimento che opera negli USA, e un’analoga realtà in Gran Bretagna: con entrambe intendiamo instaurare fattivi rapporti di collaborazione. I mercati esteri sono molto interessanti e stiamo valutando di cogliere al meglio le opportunità che ci verranno offerte, ma in ogni caso siamo fermamente convinti che in Italia ci sia parecchio lavoro da fare, non solo per le cucine dei ristoranti privati, ma anche per quelle industriali.
Mop Pre Risparmio impregnazione
Consumo litri di acqua per il lavaggio di 1 punto vendita di 250 mq, 2 cambi d’acqua (10 lt pulita + 5 lt risciacquo)
Consumo giornaliero di litri di acqua per 1 punto vendita, 5 lavaggi al giorno
Consumo giornaliero di litri di acqua per 600 punti vendita
Consumo annuo di litri di acqua per 600 punti vendita 32.400.0001.296.00031.104.000
Consumo annuo di cisterne da 25.000 lt di acqua 1.296 521.244

L’Italia è il primo Paese europeo per consumo di acqua e il terzo nel mondo, con un uso giornaliero che varia tra i 150 e i 215 litri pro capite. Le risorse idriche del Paese ammontano a 52 miliardi di metri cubi, di cui il 50% è destinato all’agricoltura, il 10% all’energia e il 40% al settore civile, compreso il Cleaning, che contribuisce agli sprechi. Garantire la gestione sostenibile dell’acqua è una delle priorità dell’Agenda 2030 per lo Sviluppo Sostenibile delle Nazioni Unite.
In un settore ad alto consumo di risorse naturali, VDM si distingue come pioniera nella creazione di soluzioni ef cienti che tutelano l’ambiente e migliorano le condizioni di lavoro degli operatori. Dal 1976, l’azienda ha sviluppato prodotti diventati standard del settore, noti per il minor impiego di risorse naturali e per il loro impegno verso la salute degli utilizzatori.
Grazie alla sua lunga esperienza e competenza, VDM è stata scelta da una grande catena mondiale per creare una Case History italiana che ha coinvolto 600 punti vendita. L’obiettivo è stato ottimizzare le operazioni di pulizia, migliorare la salubrità degli ambienti e proteggere la salute degli operatori, bilanciando tempo, risultati, risparmio e impatto ambientale.
Le soluzioni, le metodologie e gli strumenti adottati saranno disponibili a ISSA Pulire, dove gli esperti di VDM offriranno formazione su come ridurre il consumo di acqua, risparmiare tempo e migliorare la salute degli operatori nel Cleaning.
La soluzione vincente contro le infezioni ospedaliere,in 3 semplici mosse!





























UN NUOVO LOOK, LA STESSA ATTENZIONE.
Abbiamo rinnovato la nostra identità e il nostro catalogo per riflettere ciò che siamo, vicini alle persone, attenti all’ambiente e capaci di offrire tutto ciò che serve, attraverso tre categorie definite: gestione dei rifiuti, igiene e complementi d’arredo.




Ambiti di intervento, fasi operative, attrezzature e prodotti per un’attività
complessa che richiede competenza tecnica e attenzione alla sicurezza
La pulizia di sgrosso è un intervento preliminare fondamentale per eliminare lo sporco più evidente e consistente da super ci di vario tipo, come pavimenti, pareti o arredi. Si tratta di un’operazione necessaria prima di procedere alla pulizia di fino, poiché rimuove residui grossolani come polvere, detriti, macchie grasse, calcinacci o residui di lavorazioni edili.
Questa tipologia di pulizia si esegue per vari motivi: in seguito a lavori di ristrutturazione, traslochi, cantieri, oppure in ambienti che sono rimasti chiusi a lungo e
necessitano di un’igienizzazione iniziale. È utile anche in contesti industriali, dove si accumulano sporco pesante e materiali contaminanti.
L’intervento si articola in diverse fasi operative, ciascuna con specifici obiettivi e metodi. Un corretto svolgimento di ogni passaggio è essenziale per ottenere un risultato ef cace e duraturo.
Ogni intervento inizia con un sopralluogo tecnico per valutare le condizioni ambien-
tali, la tipologia di sporco, i materiali presenti e la metratura da trattare. Questa fase permette di stabilire le tecniche, i prodotti e le attrezzature da impiegare. La piani cazione comprende anche la valutazione dei rischi e l’organizzazione dei DPI (Dispositivi di Protezione Individuale).
Si procede quindi con l’esecuzione dell’intervento di pulizia, che inizia con la rimozione manuale dei residui grossolani. In ambienti post-cantiere o industriali si trovano spesso frammenti solidi, come pezzi di legno, plastica, carta, detriti edili, im-
ballaggi e materiali ingombranti. La prima fase operativa è dunque la raccolta, spesso effettuata manualmente, e lo smaltimento di questi residui con l’ausilio di pale, sacchi, contenitori e carrelli.
Segue la rimozione della polvere e delle particelle fini con l’uso di aspirapolveri industriali ad alta potenza, spesso dotati di ltri HEPA per garantire il trattenimento delle microparticelle. Questo passaggio coinvolge pavimenti, super ci orizzontali, battiscopa, in ssi e arredi eventualmente presenti. In ambienti con detriti ni o polveri sottili, può essere necessario ripetere l’aspirazione più volte.
In seguito si effettua la pulizia localizzata dello sporco ostinato, intervenendo su macchie tenaci (vernice, cemento, silicone, grasso) con prodotti chimici speci ci, spatole, raschietti o spugne abrasive. A seconda della natura del residuo si usano solventi, deceranti, disincrostanti. L’operatore deve conoscere i materiali da trattare per evitare danni permanenti.
Dopo la rimozione dello sporco visibile, si procede con il lavaggio profondo, spesso mediante monospazzole o lavasciuga pavimenti. In caso di ampie super ci, l’uso di macchinari consente un’azione meccanica potente e uniforme, abbinata all’erogazione controllata di detergenti e all’aspirazione dell’acqua di risciacquo. Per pareti lavabili, piastrelle o vetri, si impiegano idropulitrici o spugne professionali.
L’ultima fase prevede la rimozione dell’umidità residua, fondamentale per evitare aloni, muffe o la formazione di nuovi depositi di sporco. Si utilizzano aspiraliquidi, panni in micro bra e bisogna garantire un’adeguata ventilazione degli ambienti. In alcuni casi, si ricorre a ventilatori industriali per velocizzare l’asciugatura.
Durante la pulizia di sgrosso, è fondamentale il rispetto delle norme di sicurezza sul lavoro e sull’uso dei prodotti chimici. Gli operatori devono essere dotati di DPI
1 Sopralluogo tecnico per valutare la tipologia di ambiente e di sporco da trattare
2 Rimozione dei residui grossolani raccolta, solitamente manuale, e smaltimento di detriti e materiali ingombranti
3 Spolveratura e aspirazione professionale per eliminare detriti fini e polveri sottili
4 Rimozione localizzata sporco interventi su macchie tenaci con prodotti chimici specifici
5 Lavaggio meccanico delle superfici pulizia profonda mediante monospazzole, lavasciuga pavimenti, idropulitrici
6 Asciugatura e areazione rimozione dell’umidità residua, tramite aspiraliquidi e panni in microfibra, per evitare la formazione di aloni e muffe
(guanti, occhiali, mascherine, scarpe antinfortunistiche) e formati sull’uso corretto delle attrezzature. Inoltre, tutti i detergenti devono essere accompagnati da schede di sicurezza (SDS).
Gli strumenti da utilizzare per le pulizie di sgrosso variano in base al tipo di ambiente e alla natura dello sporco, ma alcuni sono comuni nella maggior parte degli interventi: gli aspiratori industriali, dotati di grande capacità e potenza, ideali per raccogliere polveri, frammenti solidi e liquidi. I modelli più avanzati hanno ltri HEPA, funzione sof ante e fusto in acciaio inox. Le monospazzole, macchine versatili per il lavaggio, la deceratura e la lucidatura dei pavimenti, agiscono utilizzando dischi abrasivi o spazzole, a seconda della super cie da trattare. Le lavasciuga pavimenti permettono di lavare e asciugare contemporaneamente grandi super ci, facendo risparmiare tempo e garantendo una pulizia uniforme. L’idropulitrice, grazie all’acqua ad alta pressione, è utile per rimuovere lo sporco ostinato su super ci esterne, piastrelle, pavimenti industriali o pareti.
Per lo sgrosso si usano anche attrezzi manuali come spatole, raschietti, spugne abrasive, panni in micro bra, secchi, mop professionali e scope a setole dure, indispensabili per dettagli e ri niture.
Quanto ai prodotti chimici, ogni super cie richiede un trattamento mirato: disincrostanti per bagni e sanitari, deceranti per pavimenti cerati, solventi per vernici, sgrassatori per cucine.
La pulizia professionale di sgrosso è quindi un intervento complesso e strategico, che richiede competenza tecnica, attrezzature adeguate e prodotti speci ci. Quando eseguita correttamente, riporta gli ambienti a condizioni igieniche ottimali e li prepara alla successiva manutenzione o all’uso quotidiano.






Attrezzature superate e procedure laboriose niscono con il compromettere l’ef cienza complessiva del servizio di pulizia. Allo stesso modo, lacune in termini di sicurezza e igiene possono dare vita rispettivamente a pericolosi incidenti e contaminazioni. Lampo nasce dunque dall’esigenza di portare la pulizia a un livello superiore, rendendola altamente ef ciente, sicura e igienica.
ARRIVA OVUNQUE, CON QUALSIASI MEZZO
Progettato e realizzato da TTS, Lampo è il primo sistema di aggancio e sgancio imme diato e senza contatto delle mani con super ci contaminate. Composto da adattatore terminale Jack per manici e aste e dispositivo Plug per carrelli Nickita e Magic, per mette di usare un solo manico per tutte le operazioni ordinarie e straordinarie: dalla pulizia delle super ci a quella dei pavimenti, passando per vetri e specchi. Con Lampo, l’operatore dispone di una gamma completa di attrezzi per la pulizia professionale: può usare lo stesso manico per rimuovere le ragnatele con gli scovoli, spolverare le super ci elevate con i piumini, far brillare quelle lucide con le micro bre e pulire i pavimenti con i telai spolvero e lavaggio, personalizzando il processo in base alle esigenze. Inoltre, l’adattatore terminale Jack permette di utilizzare qualsiasi attrezzo provvisto di letto italiano, ampliando ulteriormente le possibilità offerte dal sistema e assicurando dunque la massima essibilità nell’utilizzo dell’attrezzatura.
immecarrelli e per-

AGGANCIA E SGANCIA
GLI ATTREZZI CON IL JACK
Agganciare manici e aste all’attrezzatura per raggiungere le super ci elevate è generalmente una perdita di tempo ed energie, l’operazione richiede infatti procedure laboriose e non sempre intuitive che tendono ad allungare i tempi delle operazioni aumentando di conseguenza i loro costi. Inoltre, talvolta pur di risparmiare tempo gli operatori recuperano scale o sgabelli nel tentativo di raggiungere le super ci più alte oppure utilizzano attrezzi non adeguati per affrontare pulizie impreviste, con il rischio in entrambi i casi di incorrere in pericolosi incidenti. Jack Lampo permette di passare velocemente alla pulizia in altezza e subito dopo a quella dei pavimenti, consente infatti di agganciare in un attimo attrezzi e telai sganciandoli poi altrettanto rapidamente, rendendo quindi più semplici e rapide le operazioni. Non solo: a differenza dei sistemi tradizionali che non assicurano l’ancoraggio dell’attrezzatura che tende così a sganciarsi, l’adattatore terminale di TTS mantiene gli attrezzi fermamente ancorati durante le operazioni di pulizia prevenendo dunque sganci accidentali e conseguenti danni e lesioni.


AGGANCIA E SGANCIA
I TELAI CON IL PLUG
Accedere alle diverse aree del carrello è molto spesso una vera e propria impresa, l’operatore deve farsi continuamente spazio tra gli attrezzi appesi per svuotare i contenitori nel portasacco, prendere l’attrezzatura dalle vaschette, aprire porte e cassetti ed estrarre il vassoio, allungando inevitabilmente i tempi delle operazioni e rischiando al tempo stesso di sbattere sui manici o colpire i telai. Plug Lampo permette di riporre i telai spolvero













e lavaggio direttamente sul carrello, al di fuori delle aree operative, azzerando dunque gli ostacoli che rallentano le varie attività. Lo sgancio avviene senza alcun contatto diretto delle mani con superfici potenzialmente contaminate, contribuendo quindi al mantenimento di elevati standard di igiene. Utilizzare lo stesso manico dotato di Jack Lampo con l’intera gamma di attrezzi TTS permette di ottimizzare i processi e liberare ulteriormente il carrello dando così la possibilità di attrezzare al massimo anche quello più compatto per creare una stazione di pulizia completa. Un notevole vantaggio per l’operatore che non deve più tornare nello sgabuzzino a prendere di volta in volta l’attrezzo richiesto per le operazioni straordinarie in quanto ha sempre a disposizione tutto il necessario per qualsiasi intervento di pulizia, pianicato o meno.




Le tecniche utilizzate per eliminare la polvere dai pavimenti sono numerose e con diversi pro e contro a seconda dell’ambiente e delle necessità del contesto nel quale si opera

Come a tutti quelli come me che si possono de nire “differentemente giovani”, viene spesso la voglia di parlare di argomenti, fatti, abitudini e anche di riferimenti tecnici, riguardanti il proprio lavoro dei tempi passati. A volte il giovane che ascolta, considera questi argomenti “vecchi” e spesso per lui, ovvio obsoleti. Addirittura banali o troppo laboriosi e per questo non più tenuti in considerazione. Tuttavia, anche se dimenticati, certi argomenti e metodologie hanno una valenza sempre attuale. Frequentemente queste metodologie sono state sostituite introducendo nuove tecniche di lavoro, senza veri care però se le nuove siano effettivamente migliori di quelle “antiche” eventualmente implementate. Secondo me questo è il caso della scopatura dei pavimenti che preferisco chiamare “depolverizzazione” dei pavimenti. Mi riferisco alla “scopatura a umido” dei pavimenti in confronto ad altri sistemi.
I PRIMI CORSI DI FORMAZIONE
Concedetemi di ritornare indietro a più di mezzo secolo, nel 1971, al primo corso di formazione da me tenuto sulle pulizie professionali. Era circa un anno che avevo iniziato a lavorare in Sutter, che aveva deciso di proporsi anche sul mercato delle pulizie professionali, già leader sul mercato domestico, per le cere per pavimenti e famosa per i lucidi da scarpe.
Era stata fatta una “joint venture” con la Sutter SA svizzera, produttrice delle macchine
SECONDO TAPPETO INTERNO PER ASCIUGATURA FINALE E POLVERI FINI
PRIMO TAPPETO INTERNO PER ELIMINAZIONE RESIDUI PICCOLI
TAPPETO ESTERNO PER ELIMINAZIONE RESIDUI GROSSOLANI
QUAL È IL MOMENTO MIGLIORE PER EFFETTURA L’OPERAZIONE?
6 12 18 24 6
Il grafico mostra una situazione in reparti ospedalieri ma si può estendere anche a strutture lavorative come gli uffici. Durante la notte la polvere che è nell’aria scende e si deposita sulle superfici, dalle quali si può rimuovere al mattino, utilizzando una delle tecniche che vengono in seguito presentate. Durante la mattina il movimento delle persone (medici o infermieri negli ospedali) e la loro presenza la produce e la alza. Nel momento della pausa pranzo, o di stasi del movimento dei sanitari nelle ore centrali, si ha una parziale discesa della polvere, per poi avere un nuovo innalzamento nell’aria nel pomeriggio.
Verso fine giornata e durante la notte, lentamente la polvere ridiscende fino al mattino, quando la ritroviamo di nuovo sulle superfici.
Taski e di prodotti chimici sempre a marchio Taski, grazie anche alla relazione famigliare con la sua proprietà, sempre Sutter, esistente a quel tempo. Da molti anni il marchio Taski è passato ad altra proprietà.
Le imprese di servizi, allora solo imprese di pulizia, ancora generalmente di piccole dimensioni, si approvvigionavano per la maggioranza nei supermercati per i detergenti e per le cere per i pavimenti. Ma stava cominciando il mondo delle pulizie professionali. Il mop, le lavasciuga, le monospazzole, le cere metallizzate, i deceranti, ecc. cominciavano ad essere strumenti di lavoro normali in sostituzione dello straccio e bastone e delle cere che richiedevano la lucidatrice. Vi era anche una forte richiesta di formazione da parte degli addetti ai lavori, molto più di oggi, dove i dirigenti delle imprese di servizi sembrano i primi ad essere meno interessati alla formazione per sé stessi e per i propri addetti.
I colleghi della Sutter svizzera erano molto bravi ad effettuare la presentazione dei sistemi di pulizia, e devo ammettere che, pur avendo già avuto nozioni nella mia precedente esperienza Nordamericana, i corsi che
effettuavano i colleghi svizzeri erano più completi e originali.
La prima cosa che mi aveva impressionato era stata l’importanza che veniva data proprio al problema della polvere, oggetto di questo documento. Ricordo che la prima immagine che veniva proiettata riguardava quella della città di Zurigo che mostrava e metteva in evidenza le tonnellate di polvere che giornalmente ricadevano su questa città. Si voleva “terrorizzare” i presenti per mostrare poi come la si poteva combattere, e con essa limitare i problemi associati alla respirazione della polvere nei luoghi con nati. Polvere che poteva provenire dall’esterno, e polvere prodotta in loco dalle stesse persone che utilizzano i locali. Problema di notevole importanza negli ambienti sanitari.
Per prima cosa si insegnava che la polvere esterna dovesse essere fermata, e non portata in giro nei locali interni. Questo utilizzando tre diversi tipi di tappeti, come dall’immagine in apertura ( gura 1). Altra cosa che si poneva (e si pone) in evidenza è il momento più adatto per effettuare le depolverizzazioni.
Il gra co di gura 2 mostra una cosa ba-
SISTEMI DI DEPOLVERIZZAZIONE DEI PAVIMENTI
Nelle foto seguenti sono illustrati i diversi sistemi di depolverizzazione dei pavimenti con alcuni commenti ad essi associati. Lascio al lettore le considerazioni su quale possa essere il sistema più adatto

1. SCOPA A FRANGE IN COTONE A RICCIO
PRO: è il sistema più usato. La frangia in cotone è disponibile perché è usata anche per il lavaggio.
CONTRO: fa un certo attrito. Si satura rapidamente con la polvere. Non si vede quando è satura se non quando è visibilmente molto sporca di cile da lavare. Si tende a usarla troppo. Uso negato negli ospedali per il trasporto e/o rilascio della polvere in altri locali con il rischio d’infezioni crociate.


500MILA PER MINUTO 5 MILIONI PER MINUTO
figura 3. Emissione di particelle (peli, pelle, microorganismi ecc.)
per le varie situazioni eventualmente di sua competenza. In breve sintesi, le tecniche di depolverizzazione dei pavimenti si possono così riassumere con i “pro” e i “contro” di ciascun sistema.

2.SCOPA A FRANGE IN MICROFIBRA A RICCIO
PRO: blocca meglio la polvere della scopa a frange in cotone. Scivola meglio di quella in cotone.
CONTRO: quando si satura la polvere vola. Si tende ad usarla troppo. Non si vede quando è satura se non quando è visibilmente molto sporca. Stessa critica per l’uso in ospedali per il trasporto della polvere con il rischio d’infezioni crociate.

3. MICROFIBRA A PELO RASO CON TELAIO A VELCRO
PRO: il pelo raso trattiene meglio la polvere del pelo riccio. Scivola molto bene. Può trattenere con l’incastro a V anche residui grossolani. Si lava bene.
CONTRO: si satura molto sulla parte rontale, non coprendo tutta la superficie del pelo e successivamente la polvere vola. Uguale a stessi metri quadri di quella a riccio. Stesso problema per uso in ospedali per le infezioni crociate.
nale ma essenziale di quale sia il momento o i momenti migliori per operare la depolverizzazione sulle super ci e sui pavimenti durante la giornata.
Tutto questo ci dice che gli interventi di depolverizzazione devono essere effettuati al mattino, il più presto possibile, e nel primo pomeriggio con un ripasso.
Le persone stesse emettono particelle e con esse microrganismi. la gura 3, a sinistra veniva proiettata in quei corsi, ed è diventata molto attuale in tempo di Covid nel recente passato.
Ma ritorniamo al primo corso che ho tenuto nel 1971 e nei successivi anni ’70. Dopo la proiezione della polvere su Zurigo si prendeva un tavolo lungo circa 2 metri per 7080 cm, con sopra incollata una striscia di Linoleum (quello vero con fondo in Juta). Come sapete il Linoleum ha una super cie leggermente rugosa.
Su questa tavola si stendeva della polvere ricavata da un’aspirapolvere mescolata a polvere uorescente. L’uso del Linoleum non era casuale perché la super cie del Linoleum, leggermente rugosa, trattiene me-

4. SCOPA A FRANGIA IN MICROFIBRA A PELO RICCIO CON TELAIO A VELCRO A UMIDO
Utilizzo con pulitore tipo VIOLA (sistema a semi secco)
PRO E CONTRO: gli stessi del sistema 3, con il vantaggio di poter smacchiare il pavimento, evitando un eventuale lavaggio. Presenta il vantaggio che non vi è dispersione della polvere che rimane trattenuta meglio. Il pulitore va spruzzato in piccole quantità per evitare che la rangia si bagni troppo e la polvere si attacchi meno.

5. PANNETTI (GARZINE) PREIMPREGNATI MONOUSO SU SCOPA A TRAPEZIO (LAMELLO)
PRO: molto e caci a trattenere la polvere Il monouso li rende molto adatti all’uso ospedaliero.
CONTRO: limitata metratura di utilizzo, massimo 15-20 mq (una stanza ospedaliera). Tendenza ad un uso superiore, poi la polvere vola. Richiede il cambio frequente dei pannetti con la conseguenza di un alto costo per mq. Rischio di infezioni crociate se il cambio del pannetto non è frequente.

6. FRANGIA DI LAVAGGIO N MICROFIBRA CON PRODOTTO ANTISTATICO
PRO: e cacia migliorata rispetto all’equivalente senza il prodotto antistatico. Si raddoppia l e cacia per una maggiore penetrazione della polvere all’interno della microfibra eno rischi che la polvere voli
CONTRO: costo per l’uso del prodotto. Un po di di coltà nel lavaggio della rangia
glio la polvere. La tavola era leggermente inclinata verso gli “allievi”.
A questo punto si scopava circa metà della super cie con una normale scopa tradizionale di setole, raccogliendo la polvere con una paletta.
L’altra metà della tavola si “depolverizzava” con una scopa a frangia rivestita con una garza inumidita (scopatura a umido).
Apparentemente nessuna differenza si notava tra le due parti.
A questo punto si chiudevano le nestre oscurando la stanza, si spegneva la luce e
si accendevano delle lampade a luce ultravioletta. La parte scopata con la scopa di setole appariva con residui uorescenti come delle “strisciate”, mentre la parte trattata con il sistema della scopatura a umido appariva pulita e si mostrava che la uorescenza della polvere era rimasta sulla garza appoggiata sulla scopa a frange.
A questo punto mi domando quale sia stata l’evoluzione della tecnologia, quando ancora oggi nei locali civili vedo spesso che
la depolverizzazione dei pavimenti avviene con scopa di setole o al meglio con scopa a frange di cotone a secco, satura di polvere. Negli ospedali si è diffuso l’uso delle “garzine” pretrattate posate sulla scopa a trapezio o “lamello”. Queste sono certamente ef caci se però si usano per una stanza al massimo per 15-20 mq.
A volte, o più volte, le garzine vengono usate per molti metri quadri nei corridoi e ben oltre i 15 metri quadri, pertanto saturate dalla polvere. Raramente si usano in strutture civili.

6. SCOPATURA AD UMIDO SEMPLICE CON GARZA PRE-INUMIDITA
PRO: nessun costo, e cacia nel trattenere la polvere che rimane raccolta anche su più strati. Non si sporca la frangia. ossibilità di ricambiare la garza quando la si vede satura. La frangia rimane sempre pulita volte più superficie di recupero rispetto ai pannetti. Un certo numero di garze umide per i metri quadri da fare, sono preparate in un secchiello chiuso. Si possono depolverizzare da 100 a 200 mq prima di cambiare la garza.
CONTRO: è necessaria un po’ di cura nel sistemare la garza sulla frangia. Critica per l’uso in campo sanitario: la polvere se contaminata, anche se non viene rilasciata, potrebbe contaminare le nuove pavimentazioni con le quali va in contatto.

7. SCOPATURA AD UMIDO CON GARZA PRE-INUMIDITA CON SOLUZIONI DI DISINFETTANTI A BASE DI QUATERNARI D’AMMONIO
PRO: tutti i vantaggi della scopatura ad umido, nonché migliorata dal fatto che i Quaternari di Ammonio hanno la carica positiva nella molecola che facilita l attrazione ed il fissaggio della polvere Si possono depolverizzare da 150 a 250 mq prima di cambiare la garza. Questo evita il rilascio della polvere e l’eventuale contaminazione successive grazie anche al fatto che la polvere stessa risulta disinfettata. Questo sistema può essere utilizzato anche nelle strutture civili solo per il fatto che la carica positiva dei Quaternari d mmonio acilita il fissaggio della polvere Si preparano un certo numero di garze pre-impregnate umide (strizzate) con la soluzione disinfettante con un secchiello chiuso, ed utilizzarle già pronte nel numero utile necessario per i mq da depolverizzare.
CONTRO: è necessaria un po’ di cura per sistemare la garza sulla frangia.



La frangia in cotone viene impregnata con un’emulsione di olii e poi fatta asciugare. Gli olii si fissano nel cotone
PRO: la frangia blocca una grande quantità di polvere l sistema utilizzato e consigliato solo per locali polverosi come magazzini o per grandi superfici a polvere non vola durante il passaggio della frangia.
CONTRO: la frangia si sporca molto ed è brutta a vedersi. Utilizzabile solo per locali dove l’estetica della frangia sporca non è un problema.
Attenzione alla fase di impregnazione e asciugatura. L’acqua dell’emulsione degli olii deve evaporare completamente. L’asciugatura deve essere fatta in locale aerato. Se la frangia rimane umida può rilasciare tracce degli olii sul pavimento.
Una volta ho visto in un ospedale che la persona (dipendente di una impresa) passava il “lamello”, di quelli con la gomma spugna, addirittura senza garzina. Per ovvie ragioni non si può fare il nome dell’impresa.
Raramente vedo utilizzata la “scopatura a umido” e tantomeno quella consigliata per le strutture sanitarie, pre-inumidite con soluzione disinfettante. Non ho più fatto corsi spegnendo le luci con la polvere uorescente (né altre prove tecniche di questo tipo) ma sono sicuro che il sistema di depolverizzazione delle garze con soluzioni di Sali quaternari d’Ammonio risulterebbe ancora quella vincente.

La linea Shine racchiude le eccellenze Filmop per la pulizia dei vetri, progettate per renderla al tempo stesso altamente efficace ed efficiente. Qualità dei materiali, tratti innovativi, elevato comfort e compatibilità con il sistema Uni-Connect sono i punti di forza che contraddistinguono l’intera linea rendendola unica nel suo genere.
I top di gamma sono le versioni snodate del supporto per vello Clarus-W Master e del tergivetro Gloss-W Prime, studiate nei minimi dettagli per permettere all’operatore di scegliere in base alle esigenze se utilizzare gli attrezzi liberamente snodati, quindi con movimento a “S”, o se bloccarli in pochi istanti nell’angolazione desiderata.
Tra i prodotti in gamma si distingue anche
Gloss-W Ambo, simbiosi perfetta tra il supporto vello Clarus-W Master e il tergivetro Gloss-W Prime che consente di usare un solo attrezzo per il lavaggio e l’asciugatura velocizzando le operazioni.
I tergivetro in plastica di Filmop si distinguono inoltre per il sistema altamente innovativo che consente di girare o sostituire la lamina in maniera estremamente veloce e comoda, comportando un notevole risparmio di tempo ed energie. Supporti vello e tergivetro sono in ne abbinabili alle aste Spectra-W Pro, progettate per rendere le operazioni in altezza rapide e sicure
ISSA Pulire sarà per Filmop l’occasione perfetta per presentare l’intera gamma dedicata ai vetri, destinata a fare la storia della pulizia professionale.









Gli essenziali per la pulizia dei vetri Efficaci. Efficienti. Ergonomici.






























Dal 1984, Polychim è sinonimo di competenza, af dabilità e innovazione nel settore dei detergenti professionali. Con sede a Cinisello Balsamo, in provincia di Milano, l’azienda si è affermata negli anni come punto di riferimento per la produzione di detergenti, igienizzanti, additivi, cere, cosmetici e ausiliari destinati alla pulizia e all’igiene di ambienti e super ci nei settori più diversi: dall’industria alle collettività, dai trasporti alla ristorazione, dal settore sanitario alle RSA, no alle lavanderie professionali. Ciò che contraddistingue Polychim è un approccio orientato alla personalizzazione. L’attività principale dell’azienda è infatti quel-

la di sviluppare e realizzare prodotti a marchio cliente, offrendo un servizio essibile e modulabile. A seconda delle esigenze del committente, la personalizzazione può riguardare esclusivamente l’immagine e il brand del prodotto, oppure estendersi alla creazione di formulazioni ad hoc, con packaging su misura, pensati per rispondere in modo mirato alle richieste del mercato.
Ogni soluzione proposta da Polychim nasce da un dialogo costante con il cliente e da un’attenta attività di ricerca e sviluppo. I nostri laboratori sono in grado di studiare formulazioni innovative ed ef caci, ponendo la massima attenzione alla salute degli operatori e alla sostenibilità ambientale. In un settore sempre più orientato alla responsabilità e alla qualità, Polychim si distingue per la capacità di coniugare prestazioni elevate e rispetto per l’ambiente. Il know-how maturato in oltre quarant’anni di attività ci consente di rispondere prontamente alle s de del mercato, proponendo prodotti che uniscono ef cacia, sicurezza e valore aggiunto. Grazie a un processo produttivo essibile e strutturato, siamo in grado di supportare sia piccoli lotti sia produzioni su larga scala, mantenendo sempre elevati standard qualitativi.
Polychim non è solo un produttore, ma un vero e proprio partner di ducia per tutte le realtà che cercano soluzioni personalizzate per la detergenza professionale. La forza di Polychim è nella capacità di ascoltare, progettare e realizzare prodotti che rispecchiano l’identità del cliente e ne rafforzano la presenza sul mercato.























































procedurelavaggio stoviglie
Le lavastoviglie professionali sono strumenti indispensabili in ambienti ad alta intensità come ristoranti, bar, hotel e ospedali. Grazie alla loro capacità di gestire grandi volumi di stoviglie in tempi ridotti, garantiscono igiene ed efficienza, contribuendo a mantenere standard elevati di pulizia
Chi lavora in un ristorante sa bene che una lavastoviglie professionale non è semplicemente un elettrodomestico: è il fulcro di un sistema che deve garantire piatti perfettamente puliti, bicchieri senza aloni e posate brillanti, tutto nel minor tempo possibile. Senza un dispositivo af dabile, la gestione del servizio si complica, con ritardi, sprechi e un inevitabile calo della qualità percepita dal cliente.
Ma cosa distingue una lavastoviglie professionale da quella domestica? Innanzitutto, la capacità di lavaggio: questi apparecchi sono progettati per gestire enormi quantità di stoviglie ogni ora, con cicli più rapidi e potenti. Poi c’è la temperatura dell’acqua, più elevata rispetto ai modelli casalinghi, garantendo un’igienizzazione impeccabile. In ne, la durata e la resistenza: costruite con materiali robusti come l’acciaio inox, le lavastoviglie professionali sono progettate per durare anni, sopportando usura intensiva.
Per ottenere risultati ottimali, è essenziale utilizzare detergenti speci ci per lavastoviglie professionali. Nella scelta dei prodotti occorre tenere presente le diverse possibili esigenze che si devono considerare: detergenti per acque dure, con un alto potere sgrassante, per acque trattate con osmosi, per proteggere le guarnizioni, detergenti per cristalli e argenteria, formulati per materiali delicati, che garantiscono brillantezza senza danneggiare le super ci.
L’acqua è un elemento fondamentale: non solo è il mezzo principale per la pulizia, ma la sua qualità e gestione in uenzano direttamente l’ef cienza, la durata e i risultati del lavaggio. Comprendere il ruolo dell’acqua e adottare misure per ottimizzarne l’uso è essenziale per garantire elevate prestazioni.
L’acqua di buona qualità, pura e ben gestita, non solo garantisce stoviglie pulite e brillanti, ma contribuisce anche a ridurre il consumo energetico della macchina, a prevenire l’accumulo di calcare e impurità, prolungando così la vita della lavastoviglie e ad assicurare standard igienici elevati, essenziali in ambienti professionali. Tra gli aspetti legati alla qualità dell’acqua sono da considerare:
• durezza: l’acqua dura, ricca di minerali come calcio e magnesio, può causare accumuli di calcare che compromettono il funzionamento della macchina e la qualità del lavaggio.
• purezza: l’acqua contaminata da impurità può lasciare residui sulle stoviglie e danneggiare i componenti interni della lavastoviglie.
• temperatura: l’acqua calda migliora l’efcacia del detersivo e aiuta a rimuovere grasso e sporco ostinato.
Il mercato offre una vasta gamma di lavastoviglie professionali, ciascuna con caratteristiche specifiche
Lavastoviglie a capote ideali per grandi volumi, con un design che consente un facile carico e scarico.
Lavastoviglie a nastro progettate per mense e catering, con un sistema di trasporto automatico.
Lavastoviglie sottobanco compatte e adatte a bar e piccoli ristoranti.
Lavastoviglie a ciclo breve pensate per lavaggi rapidi e frequenti.

nuta non solo garantisce stoviglie perfettamente pulite, ma riduce anche il rischio di guasti e prolunga la vita utile dell’apparecchio. Investire tempo nella pulizia e nella manutenzione signi ca risparmiare sui costi di riparazione e migliorare l’ef cienza energetica della macchina.
FUTURO GREEN
Negli ultimi anni, il settore delle lavastoviglie professionali ha visto un’evoluzione significativa. Grazie all’innovazione tecnologica, oggi esistono modelli che ottimizzano i consumi di acqua ed energia, riducendo l’impatto ambientale senza compromettere l’ef cacia del lavaggio. Alcune aziende stanno investendo in sistemi di ltraggio avanzato, che consentono di riutilizzare l’acqua nei diversi cicli, abbattendo gli sprechi. Altre puntano su soluzioni intelligenti con sensori e automazioni, che regolano il consumo energetico in base al carico effettivo. Questi progressi non solo aiutano a ridurre i costi operativi, ma rispondono anche alla crescente domanda di soluzioni sostenibili nel settore della ristorazione.
MANUTENZIONE
Per mantenere alte prestazioni e assicurare un’igiene impeccabile, è fondamentale una pulizia regolare e accurata. Trascurare la manutenzione può portare a malfunzionamenti, cattivi odori e persino contaminazioni batteriche.
Una lavastoviglie professionale ben mante-
Una manutenzione regolare delle lavastoviglie prevede: una pulizia quotidiana, la decalci cazione, una pulizia profonda settimanale e mensile e ispezioni tecniche. Operazioni di pulizia quotidiana
Ogni giorno, al termine del servizio, è buona norma eseguire alcune operazioni di pulizia per evitare accumuli di sporco e residui di cibo. Ecco i passaggi fondamentali:
• Rimozione e pulizia dei ltri: i ltri catturano residui di cibo e grasso, quindi vanno estratti e lavati sotto acqua corrente per evitare ostruzioni.
• Pulizia delle braccia di lavaggio: gli ugelli possono intasarsi con residui di cibo e calcare, compromettendo l’ef cacia del lavaggio. È consigliabile controllarli e pulirli regolarmente.
• Lavaggio della vasca interna: un rapido risciacquo con acqua calda e un detergente speci co aiuta a mantenere la macchina pulita e priva di odori.
Oltre alla pulizia quotidiana, è importante dedicare del tempo a una manutenzione più approfondita:
• Pulizia delle guarnizioni: le guarnizioni della porta possono accumulare sporco e umidità, favorendo la proliferazione di muffe. Passarle con un panno imbevuto di aceto o detergente antibatterico è una buona pratica.
• Controllo del sistema di scarico: vericare che lo scarico sia libero da residui e che l’acqua de uisca correttamente evita problemi di drenaggio.
Una lavastoviglie professionale ben mantenuta non solo garantisce stoviglie perfettamente pulite, ma riduce anche il rischio di guasti e prolunga la vita utile dell’apparecchio. Investire tempo nella pulizia e nella manutenzione signi ca risparmiare sui costi di riparazione e migliorare l’ef cienza energetica della macchina.
Seguire queste semplici pratiche permette di mantenere la lavastoviglie in condizioni ottimali, assicurando un servizio impeccabile e rispettando gli standard igienici richiesti nel settore della ristorazione.
In de nitiva, la lavastoviglie professionale è un investimento strategico, che garantisce ordine, pulizia e velocità, contribuendo al successo dell’attività. Dopo tutto, un ristorante può avere la cucina più creativa del mondo, ma senza piatti perfettamente puliti, l’esperienza del cliente non sarà mai davvero perfetta.
• Decalcificazione: il calcare è uno dei principali nemici delle lavastoviglie professionali. L’uso di prodotti anticalcare o di un ciclo di lavaggio con aceto bianco aiuta a prevenire incrostazioni.
•Sistema integrato: manico, serbatoio e mop in un unico strumento compatto.
•Dosaggio controllato: spruzza solo la quantità necessaria, senza sprechi.
•Facile e igienico: mop lavabile e sostituibile, montaggio rapido.
•Design ergonomico: leggero, maneggevole e confortevole anche per usi prolungati
Nel mondo della pulizia professionale, l’innovazione è la chiave per offrire soluzioni ef caci, sostenibili e pratiche. Il Mop Hy-Genio di Hygenia rappresenta una di queste soluzioni d’avanguardia, tanto da essere stato candidato come Product of the Year alla era ISSA Pulire di Milano, uno degli eventi più prestigiosi del settore.
Hy-Genio è molto più di un semplice mop: è un sistema completo progettato per ottimizzare le operazioni di pulizia in ambienti professionali, riducendo sprechi, tempi morti e rischi per l’operatore. La sua struttura ergonomica e il design studiato nei minimi dettagli lo rendono un alleato perfetto per imprese di pulizia, strutture sanitarie, ristorazione, hotellerie e ambienti ad alta frequentazione. Hy-Genio è un sistema integrato che combina manico, serbatoio e testata mop in un unico strumento compatto e funzionale. L’operatore può caricare direttamente il liquido detergente nel serbatoio


controllata consente di dosare con precisione la soluzione detergente, evitando sprechi e aumentando l’ef cacia della pulizia.
Hy-Genio è progettato per essere facile da usare e garantire un elevato livello di igiene: il mop si monta e si smonta rapidamente, mentre la testata in micro bra, lavabile e sostituibile, favorisce una gestione più sostenibile delle risorse. Il design ergonomico, leggero e maneggevole, riduce lo sforzo sico dell’operatore e migliora il comfort anche durante le attività di pulizia più prolungate.
La vera forza di Hy-Genio sta nella sua capacità di sempli care la pulizia rendendola più ef ciente, igienica e sostenibile. Con una sola attrezzatura è possibile ottenere un risultato professionale anche in spazi ristretti o in situazioni che richiedono interventi rapidi. È particolarmente apprezzato in contesti dove l’igiene è prioritaria, come ambulatori, cucine, spogliatoi e scuole. L’assenza di secchi evita ristagni d’acqua e contatti con super ci contaminate, contribuendo a elevare gli standard igienici.
La candidatura di Hy-Genio come “Product of the Year” a ISSA Pulire Milano conferma l’impegno di Hygenia nell’innovazione continua. Il prodotto ha attirato l’attenzione per la sua capacità di unire design funzionale, performance elevate e attenzione all’ambiente.















Trent’anni di costante impegno verso l’nnovazione, qualità e professionalità.

MIGLIORARE L’IGIENE DEGLI AMBIENTI E IL BENESSERE DELLE PERSONE, DIFFONDERE LA CULTURA DELLA PREVENZIONE
FORNIRE AI CLIENTI SOLUZIONI E OPPORTUNITÀ DI BUSINESS, CON AFFIDABILITÀ, TRASPARENZA E PROFESSIONALITÀ IN OGNI FASE DELLA PARTNERSHIP
SVILUPPARE IN AZIENDA NUOVE IDEE, RICERCARE ALTERNATIVE E SOLUZIONI CHE CREINO VALORE PER I PARTNER, I CLIENTI E I COLLABORATORI
AGIRE CON LA MASSIMA TRASPARENZA, EFFICIENZA E COLLABORAZIONE PER CREARE SOLUZIONI DI ALTO LIVELLO, NEL MASSIMO RISPETTO SOCIALE E AMBIENTALE
Le ultime innovazioni nel settore delle lavanderie industriali puntano su digitalizzazione, analisi dati e gestione intelligente dei detergenti, favorendo anche sostenibilità e risparmio energetico
SIMONE CIAPPARELLI
Il settore delle lavanderie industriali sta vivendo una trasformazione profonda, spinto dall’urgenza di migliorare l’ef cienza operativa, rispondere alle esigenze di sostenibilità ambientale e ottimizzare l’esperienza del cliente. In questo scenario, la digitalizzazione, l’analisi dei dati e l’adozione di sistemi di dosaggio intelligente dei detergenti si pongono al centro dell’innovazione. Allo stesso tempo, il risparmio energetico e idrico rappresenta un obiettivo chiave, supportato da nuove tecnologie che riducono l’impatto ambientale senza compromettere la qualità del servizio.
La digitalizzazione ha introdotto un cambiamento radicale nelle lavanderie industriali. Sistemi avanzati di gestione e monitoraggio consentono oggi di controllare in tempo re-
ale tutte le fasi del processo, dall’accettazione dei capi alla loro restituzione. I software gestionali evoluti integrano funzioni di tracciabilità tramite RFID (Radio Frequency Identification) o codici QR, permettendo di seguire ogni singolo pezzo attraverso il ciclo di lavaggio. Questo non solo migliora l’ef cienza, ma riduce drasticamente il rischio di smarrimenti o errori. La raccolta e l’analisi dei dati stanno diventando strumenti imprescindibili per ottimizzare i processi. I dati raccolti - come consumi di acqua, energia, tempi di lavaggio, utilizzo dei macchinari - vengono analizzati per individuare inef cienze, prevedere manutenzioni e ridurre i tempi di fermo. In particolare, l’uso dell’intelligenza arti ciale permette di elaborare previsioni accurate sui volumi di lavoro futuri, facilitando una piani cazione più ef cace delle risorse. Alcune piattaforme software permettono anche di creare
dashboard personalizzate che mostrano KPI (Key Performance Indicators) in tempo reale, consentendo ai manager di prendere decisioni più rapide e basate su dati oggettivi.
DOSAGGIO INTELLIGENTE
La gestione corretta dei detergenti è essenziale non solo per garantire risultati di lavaggio ottimali, ma anche per ridurre sprechi e minimizzare l’impatto ambientale. Negli ultimi anni, i sistemi di dosaggio automatico si sono notevolmente evoluti. I moderni sistemi di dosaggio intelligente sono capaci di calcolare in modo preciso la quantità di detergente necessaria in base al tipo di tessuto, al livello di sporco e al peso del carico. Alcuni dispositivi si integrano direttamente con il software di gestione della lavanderia, ricevendo dati in tempo reale e adattando il dosaggio in maniera dinamica. Questi sistemi permettono anche di utilizzare detergenti
/ 2025

OBIETTIVI DELLO SVILUPPO
TECNOLOGICO
NELLE LAVANDERIE
• MONITORAGGIO IN TEMPO
REALE DEI CAPI
• DOSAGGIO INTELLIGENTE
DEI DETERGENTI
• RISPARMIO IDRICO TRAMITE
RECUPERO DELL’ACQUA
GIÀ UTILIZZATA
• RISPARMIO ENERGETICO TRAMITE
CICLI DI LAVAGGIO INTELLIGENTI
La tecnologia RFID rappresenta una delle innovazioni più significative nel settore delle lavanderie professionali. Grazie all identificazione automatica tramite radio requenza, possibile monitorare con precisione il ciclo di vita di ogni capo tessile, migliorando l e cienza operativa e garantendo maggiore trasparenza e a dabilità nei servizi l sistema si basa su tag elettronici transponder applicati agli indumenti o alla biancheria gni tag contiene un microchip con un codice univoco rilevato da appositi lettori anche a distanza, senza contatto visivo diretto. Questi tag, cuciti nei tessuti o integrati in etichette resistenti ai lavaggi, permettono una gestione in ormatizzata e in tempo reale di ogni ase dal ritiro, al lavaggio, alla riconsegna. vantaggi sono molti automatizzazione del processo riduce gli errori umani e consente un controllo preciso dell’inventario, con risparmio di tempo e risorse e lavanderie monitorano lo stato e la durata di ogni capo, ottimizzando i ricambi e prevenendo urti o smarrimenti er i clienti, significa maggiore a dabilità e trasparenza noltre, l analisi dei dati raccolti consente di migliorare pianificazione e logistica, aumentando produttività e riducendo sprechi n esempio concreto quello delle lavanderie ospedaliere, dove la tracciabilità ondamentale per igiene, sicurezza e rispetto dei protocolli amici, lenzuola e divise sono dotati di tag RFID che registrano lavaggi, cicli d’uso e destinazione. Questo sistema evita contaminazioni incrociate, gestisce i ricambi e garantisce un servizio documentabile e con orme egli ultimi anni, la tecnologia evoluta rapidamente tag sono ora più piccoli, economici e resistenti anche ai lavaggi ad alta temperatura e agli agenti chimici Sempre più lavanderie industriali, soprattutto nei settori sanitario e alberghiero, adottano questa tecnologia per gestire grandi volumi di tessuti con precisione ed e cienza
multicomponente, che vengono miscelati automaticamente nella proporzione ideale a seconda del ciclo selezionato. Il risultato è un miglioramento della qualità del lavaggio, una maggiore durata dei tessuti e un considerevole risparmio economico. Inoltre, molte aziende stanno sviluppando soluzioni IoT (Internet of Things) per monitorare costantemente lo stato dei prodotti chimici e inviare noti che automatiche in caso di livelli critici, evitando interruzioni operative.
La crescente sensibilità verso le tematiche ambientali ha spinto il settore delle lavanderie industriali a investire in tecnologie per ridurre l’impatto delle proprie attività. Uno degli ambiti principali è il risparmio idrico. I nuovi impianti di lavaggio sono progettati per riutilizzare l’acqua grazie a sistemi di ltrazione e trattamento che consentono di recuperare e riutilizzare no all’80% dell’acqua di risciacquo. Tecnologie come l’osmosi inversa o la ltrazione a membrana sono sempre più diffuse, abbattendo drasticamente il consumo di acqua potabile. Anche l’ef cienza energetica ha fatto passi da gigante. Le macchine di ultima generazione sono equipaggiate con motori a basso consumo, sistemi di recupero del calore e cicli di lavaggio ottimizzati che riducono i tempi e le temperature necessarie. Alcuni impianti utilizzano pompe di calore per il riscaldamento dell’acqua, migliorando ulteriormente l’ef cienza.
Nell’ambito delle energie rinnovabili, molte lavanderie stanno installando impianti fotovoltaici sui propri stabilimenti, riducendo la dipendenza dalle fonti energetiche tradizionali e abbattendo le emissioni di CO2. Inoltre, l’adozione di detergenti a basso impatto ambientale - spesso certi cati da enti terzi - completa il quadro di una liera sempre più green.
Un elemento chiave della trasformazione delle lavanderie industriali è l’integrazione tra le varie tecnologie. I sistemi di gestione digitali dialogano ormai in maniera uida con macchinari automatizzati, dosatori in-
telligenti e impianti per il recupero di acqua ed energia.
Questo approccio integrato permette non solo di ottimizzare i singoli processi, ma di migliorare l’ef cienza complessiva della lavanderia, generando bene ci tangibili in termini economici e ambientali. Ad esempio, i dati raccolti da sensori intelligenti possono essere utilizzati per tarare dinamicamente il dosaggio di detergenti e i parametri di lavaggio in funzione della disponibilità idrica o delle condizioni energetiche del momento. Alcuni sistemi più avanzati sono già in grado di suggerire modi che operative per ridurre ulteriormente l’impatto ambientale, come la proposta di cicli di lavaggio alternativi o la programmazione automatica dei carichi in base al costo orario dell’energia. Guardando al futuro, il ruolo dell’intelligenza artificiale e del machine learning sarà sempre più centrale. Oltre a ottimizzare i processi esistenti, queste tecnologie promettono di aprire la strada a nuovi modelli di business. Un esempio è il concetto di lavanderia “as a service”, in cui i clienti pagano solo per l’effettivo utilizzo del servizio, senza doversi preoccupare di gestione, manutenzione o sostituzione degli impianti. Questo modello, già in fase sperimentale in alcune realtà, potrebbe ridurre notevolmente l’impronta ecologica complessiva, favorendo l’uso di macchinari sempre aggiornati ed ef cienti. Inoltre, l’analisi predittiva basata su big data consentirà di sviluppare strategie ancora più mirate per la riduzione dei consumi, personalizzando l’approccio non solo su base aziendale, ma anche sul singolo cliente nale.
Il settore delle lavanderie industriali sta attraversando una fase di profonda innovazione tecnologica. Digitalizzazione, analisi dati, gestione intelligente dei detergenti e tecnologie green non sono più semplici tendenze, ma elementi fondamentali per competere in un mercato sempre più attento all’ef cienza e alla sostenibilità. Le aziende che sapranno integrare in modo intelligente queste tecnologie saranno in grado di offrire servizi di qualità superiore, ridurre i costi operativi e contribuire in modo concreto alla tutela dell’ambiente.



Lei ci mette lʼesperienza, noi tutto il resto.
Con IMESA hai un mondo di soluzioni: lavatrici, essiccatoi, detergenti, competenza e assistenza.
Perché ogni gesto di pulizia merita il meglio


Hagleitner crea l’igiene. L’azienda, a conduzione familiare, offre soluzioni d’igiene personalizzate per ogni settore di applicazione: dispenser e sistemi di dosaggio intelligenti, prodotti di pulizia di alta qualità e sani cazione garantita per area bagno, cucina, lavanderia, pulizia degli edi ci e cosmetica. Lo spirito inventivo dell’azienda crea soluzioni sostenibili per il futuro, in modo che clienti e partner siano sempre un passo avanti quando si tratta di igiene. L’eccellenza del servizio è parte integrante della filosofia aziendale. In collaborazione con il cliente, i consulenti per l’igiene sviluppano soluzioni su misura che sempli cano i processi operativi ottimizzando risorse.
LA DIGITALIZZAZIONE
GENERA EFFICIENZA
Hagleitner senseMANAGEMENT (HsM) è lo strumento digitale per la gestione dati dei dispositivi. Tutti i dispenser e sistemi di dosaggio digitali Hagleitner trasmettono i dati allo smartphone o al gateway, tramite Bluetooth, del consumo, del livello di riempimento o l’eventuale necessità di assistenza.
Tramite l’app Hagleitner360 i dati possono essere visualizzati in qualsiasi momento su
smartphone e tramite il portale web HsM anche su notebook e pc. Collocazione, livello di riempimento, consumo e stato energetico di tutti i dispositivi collegati in rete possono essere visualizzati a colpo d’occhio, rivelando immediatamente dove è necessario intervenire. Il personale può lavorare in modo mirato, risparmiando tempo per inutili spostamenti. L’igiene diventa visibile, piani cabile e documentabile.
Con integral 1FLAIR, Hagleitner ha sviluppato un sistema di dosaggio digitale per lavanderie, che conquista per la sua tecnologia innovativa. Precisione del dosaggio, ef cienza dei costi e sicurezza sono le priorità assolute. Grazie al sensore integrato, il sistema di dosaggio è in grado di calibrarsi da solo. I componenti altamente concentrati del detersivo, vengono erogati con precisione. La tecnologia RFID integrata rende impossibile confondere i prodotti durante la sostituzione delle taniche. Le spie LED sulle taniche indicano il livello di riempimento, in modo da poter sostituire tempestivamente le taniche vuote. L’analisi dei consumi e dei

L’azienda ha la sua sede centrale a Zell am See, in Austria, dove si svolge la ricerca, lo sviluppo e tutta la produzione dei prodotti. L’azienda dispone di 27 sedi in 12 Paesi, ogni sede è provvista della propria logistica, assistenza tecnica nonché del reparto vendite-consulenze.
cicli di lavaggio forniscono dati trasparenti e contribuiscono all’ottimizzazione delle risorse. La manutenzione digitale da remoto consente di regolare le impostazioni e di riconoscere ed eliminare rapidamente in qualsiasi momento errori di funzionamento. Ciò garantisce la massima af dabilità operativa e un’igiene su cui poter contare in ogni momento.




Trasparente: dati in tempo reale informano su riempimento, consumo e necessità di assistenza
Efficiente: app con funzione di analisi
Intelligente: sicuro da usare, preciso nel dosaggio e manutenibile da remoto

ISSA Pulire 2025
Hagleitner Stand: Padiglione 8 – B01/C08
Scoprite altri nuovi prodotti

























Gestire un’impresa richiede un’adeguata preparazione teorica e pratica. La formazione in questo campo ha quindi un forte impatto sulla qualità delle attività svolte e sui risultati aziendali
ALBERTO BUBBIO
Università Cattaneo | LIUC di Castellanza (VA)
Vi dereste di un medico che vi visita senza aver studiato anatomia? Che cosa direste di chi guida un’auto o un bus senza la patente? Come mai ci si scandalizza quando si scoprono persone che posseggono armi, ma non hanno il porto d’armi? E l’elenco potrebbe continuare; è necessaria un’adeguata preparazione, teorica e pratica, per svolgere determinate attività. Tra queste attività è opportuno che ci si
abitui ad annoverare la gestione d’impresa, il fatto di fare management. In proposito, come ci sono diverse attività, ci sono diversi livelli di formazione. Per imparare qualcosa di management, in molte Business School, società di formazione e in alcune associazioni, ci sono i corsi di base sulle tecniche, sulle attività che dovrebbero caratterizzare il funzionamento efficace di un’impresa, sui metodi per svolgerle e
sulle soft skill che è opportuno curare, per passare poi ai corsi avanzati.
ANGAISA da tempo si è mossa sui temi di base, partendo dalla distinzione tra strategia e gestione operativa. Di fondo, l’idea che la formazione manageriale sia opportuna o addirittura necessaria. È da tempo che ci si è accorti che il contenuto della formazione manageriale sia fra le cause del mancato sviluppo economico del Pae-
se. Per fortuna gli imprenditori italiani con le loro idee hanno compensato il gap e hanno consentito all’economia di galleggiare. Ma molti si sono fermati lì, dove hanno iniziato. Incapaci di dare, insieme ai loro collaboratori, la spinta verso la crescita. Di fare quello che in passato avevo de nito il “grande salto”. Restiamo un Paese di PMI.
INVESTIRE PER CRESCERE
I tre principali motivi per cui si ritiene che la formazione manageriale non sia solo un optional, ma un’attività da estendere a più persone in azienda, sono:
• alzare il livello tecnico della squadra (sarebbe opportuno avere almeno persone nelle varie aree gestionali in possesso dei fondamentali): partendo da quello che è opportuno tutti conoscano, possedendo i fondamentali si risparmia tempo e i risultati della gestione tendono a migliorare;
• attivare momenti di apprendimento su temi mirati, spesso propedeutici a cambiamenti interni o indotti da situazioni di ambiente esterno; per esempio, fornendo le conoscenze/competenze speci che che possono servire in momenti particolari della vita aziendale: come lo sono una fase di crescita sostenuta, la gestione in in azione o la gestione nel post-Covid; d’altra parte, il bravo skipper è quello che sa “portare la barca” quando il mare è tempestoso;
• spingere le persone ad aumentare il proprio impegno lavorativo, far crescere la loro motivazione.
Dopo aver fatto formazione ci risulta che le persone siano desiderose di applicare i suggerimenti ricevuti. Di certo percepiscono che si stia investendo in una loro cresci-
ta professionale e questo di solito genera soddisfazione. Talvolta la partecipazione a un’iniziativa di formazione sortisce effetti addirittura più positivi di un incentivo monetario. Con riferimento ai fondamentali e al livello tecnico di base, sono da ricordare come centrali nella formazione almeno tre temi: il primo, basato sulla conoscenza delle cinque attività che caratterizzano il processo di management (vedi gura a pag. 110) dove le prime tre attività (piani cazione, organizzazione delle risorse e guida-leadership) dovrebbero essere quelle preponderanti come tempo dedicato da parte delle persone ai vertici dell’azienda. Comunque, le tre a cui dedicare più attenzione e dove essere in possesso delle competenze migliori.
Il secondo tema si riferisce al possedere la capacità di leggere la dimensione economico- nanziaria dell’azienda (bilancio di esercizio) con i suoi ussi di reddito e di cassa e i suoi indici di redditività.
In ne, il terzo tema è rappresentato dalla consapevolezza di quali approcci si sono dimostrati, nel tempo, più ef caci a supporto dell’attività di direzione e delle sue cinque fasi caratterizzanti, come la direzione per obiettivi, l’attività in team, il budget per il controllo di gestione, e la balanced scorecard per l’attuazione della strategia. Poi ci sono anche i temi di grande attualità. Anche questi andrebbero conosciuti e capiti nei loro eventuali impatti gestionali. Inutile sottolineare quanto oggi la politica economica di Trump (dazi inclusi) e l’Intelligenza Arti ciale siano alcuni di questi temi: cambieranno le potenzialità di azione del management, rendendo disponibili informazioni in passato non condizionanti.
Ricordiamoci che è dalla qualità del management che dipendono i risultati aziendali.
Alla base di risultati aziendali soddisfacenti o più che soddisfacenti, oltre a un momento magico dei mercati, che può aiutare, ci sono idee imprenditoriali innovative e un management che le sa realizzare.
La qualità del management è un mix di variabili: età, contesto culturale di provenienza, grado di scolarizzazione, conoscenze del settore in cui l’impresa opera e conoscenza di tecniche e di soluzioni manageriali. È dal diffondersi di queste ultime che ci si prepara al “grande salto”. E il grande salto lo richiede il mercato con le sue economie di scala e di scopo.
L’imperativo sta diventando “mangiare, per non essere mangiati”.
Pertanto, non è azzardato sottolineare che la formazione manageriale non è mai stata né mai sarà un optional. Serve invece a fornire alle persone almeno una dotazione di base su cosa signi chi e come si possa gestire un’azienda. Questa dotazione nel tempo deve poi cercare di essere alimentata, per ri ettersi in risultati sempre migliori. Come sottolinea una recente ricerca della London Business School, anche gli imprenditori e gli Amministratori delegati (Ceo) è opportuno che non trascurino la formazione. La loro crescita professionale è infatti al 70% legata all’esperienza, per un 20% all’interazione con i collaboratori, ma un 10% rimane legato a programmi di formazione strutturati.
Dalla loro crescita conseguono i risultati che le imprese da loro guidate ottengono. Pertanto, nel mondo anglosassone (Stati Uniti Harvard Business School, Sloan Management School e London Business School) cui si uniscono le realtà di Svizzera (IMD di Losanna), Germania (Berlino, European School of Management and Technology) e Francia (Insead) la rilevanza di questa formazione è ampiamente riconosciuta. Escono libri come quello
LA FORMAZIONE MANAGERIALE HA UN
FORTE IMPATTO SULLA QUALITÀ DELLE ATTIVITÀ
DI MANAGEMENT SVOLTE
E SUI RISULTATI AZIENDALI. NELLE AZIENDE PER CRESCERE CI VOGLIONO LE PERSONE. MA LE PERSONE, PER AIUTARE IN QUESTA CRESCITA, DEVONO ESSERE MESSE IN GRADO DI CRESCERE
di Birkinshaw Julian, importante docente della London Business School, che ci ricordano come proprio sui temi di management ci sia ormai una letteratura ampia e particolarmente costruttiva: 100 ways to be a better boss. Mind Tools for managers (100 soluzioni per essere un Boss migliore. Strumenti mentali per manager - J. Wiley 2018).
Anche io ci credo e molte esperienze vissute in questi anni con numerose imprese e in alcune Business School italiane (Sda Bocconi e Istud), me lo confermano. Finché il medico non ha studiato anatomia capirà molto poco del corpo umano. Lo stesso vale in azienda per la “dimensione eco- n” della gestione che studia e spiega i ussi economici e quelli nanziari, con una serie di indicatori (dal Roe al Ros). Conoscerli aiuta a impostare gli investimenti senza intaccare la solidità finanziaria di un’impresa; si sarà quindi in grado di impostare politiche di sostenibilità nanziaria degli investimenti. Altresì ci sono degli studi che evidenziano come formulare una strategia, o anche come far funzionare un
team. Ci sono alcuni accorgimenti che possono aiutare il team a svolgere al meglio le sue funzioni. Qualcuno potrebbe obiettare dicendo di essersi documentato su questi temi e di aver studiato in modo autonomo.
Il percorso dell’autodidatta, pur essendo lodevole, deve ricordarci quello che succede in tutta una serie di campi professionali. Quando si impara a giocare a tennis da soli, a suonare uno strumento senza un maestro, a studiare una lingua straniera senza una guida, i risultati possono anche essere positivi, ma dif cilmente sono veramente validi. Si sa sempre qualcosa in meno e quello che si sa è costato fatica, molto tempo e qualche volta non ha consentito di evitare costosi errori.
Il self-made man in materie manageriali non sempre è la soluzione vincente, in alcuni casi può essere andata bene, ma magari si sarebbe potuto fare di più.
Quando i mercati tirano, la crescita fa dimenticare le eventuali carenze. Ma ecco
che quando i mercati diventano più dif cili la conoscenza manageriale diventa utile. Un esempio può aiutare: in un’impresa si ritiene utile elaborare il budget delle vendite, poiché da esso dipendono tutti i numeri dell’anno oggetto del budget; elaborare tale budget quando l’evoluzione del settore in cui si opera è relativamente prevedibile è un’attività semplice. Ben diverso è farlo in un mercato reso incerto dall’evoluzione degli incentivi. In questo caso le tecniche di analisi statistica delle vendite possono essere un supporto adeguato. Bisogna aver affrontato almeno quanto indicato da Philip Kotler nel suo Marketing Management. Ci sono nelle diverse aree del management dei testi fondamentali che è opportuno conoscere.
Anche il lavorare in team con risultati positivi ha delle regole. Da un lato, nel comporre i team si devono considerare le caratteristiche individuali delle persone, ma poi è anche opportuno che queste stesse persone sappiano che il team funzionerà solo se si prenderanno in considerazione i bisogni di relazione dei singoli nei rapporti interper-
sonali. Basti ricordare che tra i bisogni di relazione delle persone quando lavorano con gli altri ci sono: l’essere ascoltati, l’essere chiamati a partecipare alle decisioni e il ricevere un feedback sui risultati ottenuti. Da qui la performance che il team riuscirà a realizzare.
Richiamate le relazioni tra attività di management e attività di direzione, è opportuno ora sottolineare che ci sono molti modi di fare management: alcuni più intuitivi e creativi, altri più razionali.
In questi 30 anni di attività come docente di management ho visto passare nelle mie aule persone molto diverse. Non è un falso stereotipo dire che il manager italiano sia più destrutturato rispetto ai suoi colleghi nordeuropei. Ed è un timore altrettanto emergente che le ore dedicate alla formazione manageriale nel nostro Paese, non siano tantissime rispetto alle esperienze straniere. Così, vuoi per fattori naturali, vuoi per scarsa conoscenza di alcuni strumenti, gli executive nel nostro Paese tendono a “improvvisare” di più. Sarà un bene? Difcile rispondere, di certo quando ci sono di mezzo i costi è pericoloso improvvisare e i risultati spesso sono modesti. Rimane comunque il fatto che i comportamenti assunti dai singoli dipendono anche dalle loro attitudini. Come ci ricordava Mintzberg, attingendo dagli studi sulle funzionalità del cervello, ognuno di noi può caratterizzarsi per uno sviluppo più accentuato dell’emisfero destro, quello creativo, piuttosto che dell’emisfero sinistro, quello razionale.
Per quanto si sia intuitivi, creativi o destrutturati bisogna essere consapevoli che in certe decisioni i costi devono essere considerati. Lo si potrà fare in modo più o meno analitico, demandando ad altri i calcoli, ma lo si deve fare. L’importante è considerare i “costi giusti”. Purtroppo, ed è questo uno degli obiettivi del libro, spesso si utilizzano
più o meno volutamente i costi sbagliati. In tal caso sarebbe meglio chiudere gli occhi e decidere senza considerare la convenienza economica (prassi spesso diffusa). Diversamente il rischio di prendere decisioni sbagliate aumenta in modo esponenziale. Tutti coloro che gestiscono, in una determinata situazione, più persone e altre risorse fanno management. Svolgono anche attività di direzione quando indirizzano e utilizzano tali risorse per raggiungere uno scopo o perseguire un obiettivo. C’è chi, quando gestisce queste risorse, chiude gli occhi e prova a fare, c’è chi avendo “studiato” prima cerca di applicare i concetti, i metodi e i modelli appresi.
Questa è la grande differenza tra approccio professionale e approccio improvvisato. Il primo, forte delle sue conoscenze e delle competenze maturate dall’applicazione delle sue conoscenze, riesce ad affrontare temi anche complessi con sicurezza. L’improvvisato fa, ottiene dei risultati, ma non saprà mai se avrebbe potuto fare meglio.
DALLE FORMULE ALLA PRATICA
In tutte le aree della gestione qualcuno ha messo a disposizione di altri le sue conoscenze. E se non si hanno le sensibilità, è dif cile che queste conoscenze vengano recuperate e applicate. Si tratta di quegli strumenti e quelle soluzioni che aiutano a capire e affrontare i problemi di gestione. Faccio un esempio: nella gestione del magazzino, area critica nella gestione di un’impresa di distribuzione, c’è la formula per la determinazione del lotto economico di riordino dei prodotti (L). La formula è la seguente:
L = X * D
dove X è il quantitativo del prodotto venduto in un mese, e D è il tempo di fornitura (tra emissione ordine e consegna a magazzino da parte del fornitore). Così se si vende mediamente in un mese 30 pezzi di un prodotto e il fornitore consegna in 2 gg (60
Così lotti di riordino dimensionati in modo da non andare in rottura di stock sono determinabili con la formula indicata. La sua applicazione non va data solo in pasto a un software che in automatico emette gli ordini di acquisto, ma questo va gestito da una persona competente che valuti se e quanto utilizzare i risultati.
Inutile sottolineare che applicando questa formula, con saggezza e non in modo automatico, si riesce a mantenere il livello delle scorte a livelli contenuti e in linea con le vendite, ma anche evitando disservizi da rottura di stock.
La formula è già stata inventata e utilizzata nel tempo con risultati positivi, perché non metterla in pratica? E così per tante altre idee, formule e soluzioni.
La formazione manageriale ha, dunque, un forte impatto sulla qualità delle attività di management svolte e sui risultati aziendali. Come più volte affermato e dimostrato è una delle determinanti della crescita e della redditività. La redditività si può migliorare a parità di altre condizioni anche migliorando la qualità del management aziendale. Ma non basta. Oltre alla manutenzione straordinaria è necessaria una manutenzione di routine. Se si dispone di una macchina, ogni tanto si fanno i tagliandi per far sì che tutto funzioni e soprattutto si minimizzi il rischio di rimanere a piedi. Bisogna pensare di fare manutenzione anche al motore dell’azienda e alle sue principali componenti: le persone. Nelle aziende per crescere ci vogliono le persone. Ma le persone, per aiutare in questa crescita, devono essere messe in grado di crescere.
Articolo già pubblicato su Blu&Rosso, qui ripreso per gentile concessione. giorni), si dovrà tenere un magazzino di 30 gg di vendite prodotto e quindi il lotto di riordino (L) è di 60 pezzi. L= 30 pezzi vendite mese * 2 mesi.

Nel panorama dei sistemi di pulizia professionale, STI Steam Industry si distingue come punto di riferimento nell’innovazione tecnologica a vapore. Fondata nel 2000 e con il marchio STI lanciato nel 2009, l’azienda vicentina rappresenta un esempio virtuoso di impresa familiare italiana evoluta a livello industriale avanzato, guidata dalla seconda generazione della famiglia Passuello.
La loso a di STI è racchiusa nel claim Join the Steam Revolution, che testimonia l’impegno verso soluzioni di pulizia ecosostenibili. Le tecnologie a vapore secco sviluppate dall’azienda garantiscono risultati superiori con un impatto ambientale drasticamente ridotto: un risparmio no al 90% di acqua rispetto ai metodi tradizionali e una signi cativa riduzione nell’utilizzo di detergenti chimici. «La nostra missione è fornire tecnologie che siano contemporaneamente ef caci, economiche ed ecologiche - spiega Laura Passuello, managing director di Sti -. Il vapore rappresenta non solo un metodo di pulizia superiore, ma una vera rivoluzione sostenibile applicabile in ogni contesto».
La gamma di prodotti STI comprende cinque linee principali - Domestica, Professionale, Industriale, Car Detailing e Pest Controlcon ben 18 modelli che coprono un’ampia varietà di applicazioni: dall’Horeca all’industria alimentare, dal settore sanitario all’automotive, no ad applicazioni specializzate come il controllo dei parassiti con BugsBuster.
Essere leader del mercato dei pulitori vapore signi ca soddisfare elevati requisiti e aspettative dei clienti. La formula vincente di STI risiede nel controllo totale della liera: ogni pulitore a vapore è progettato e prodotto internamente sin dall’inizio, seguendo gli standard più elevati. Questo approccio garantisce il pieno controllo sulla qualità e sui termini di consegna, permettendo all’azienda di rispondere velocemente e in modo essibile ai cambiamenti del mercato e alle esigenze dei clienti. Basandosi su una tecnologia di produzione all’avanguardia e su un team altamente quali cato, STI assicura il livello qualitativo elevato e costante di tutti i modelli di pulitrice a vapore che i clienti si aspettano.
Tra le tecnologie esclusive che caratterizzano i generatori di vapore STI spiccano il sistema Non-Stop per il rifornimento continuo dell’acqua, il Twin-Power System per il controllo di potenza, e il Vap Filter brevettato per la puri cazione dell’aria. Queste innovazioni sono frutto di un reparto R&D costantemente impegnato nello sviluppo di soluzioni all’avanguardia.
La distribuzione dei prodotti STI avviene attraverso una rete di partner-distributori presenti in tutto il mondo, selezionati per la loro capacità di offrire supporto tecnico quali cato e servizi pre e post-vendita. «Essere easy to deal with è uno dei nostri valori fondamentali - sottolinea Passuello -, la semplicità nelle relazioni commerciali è alla base del nostro successo».





La nuova pulitricea vapore STI
progettata per un ambiente a
prova di cimici dei letti!





Eliminate le cimici dei letti e i parassiti con il vapore secco surriscaldato e senza utilizzo di insetticidi!









Mi sento inadeguato nella vita di tutti i giorni dalla mancanza di coerenza fra la vita che osservo e le regole scritte.
Soprattutto per quanto riguarda il concetto, il senso più stretto di lavoro
Uno dei miei maestri, in ambito accademico, mi ha introdotto all’importanza fondamentale dell’Artefatto normativo in psicologia sociale, nella vita delle persone e della collettività (P. Calegari, F. Massimini, 1978).
Il suo allievo, mio secondo maestro, mi ha introdotto a un’equazione (con un approccio bio-socio-culturale) che spiega in modo semplice il comportamento del singolo individuo nel corso della sua esperienza quotidiana, per tutta la vita (F. Massimini, P. Inghilleri, 1987).
Il Maestro dei miei Maestri, che è stato anche il mio, ha insegnato a tutti noi che esiste un canale di energia psichica (detto Flow o usso di coscienza) che, se ben
alimentato nella nostra quotidianità, ci permette di avere una buona vita, in un continuo altalenarsi di s de e opportunità: qualsiasi cosa bella o brutta ci succeda. (di Mihály Csíkszentmihályi, 1990).
Non è questa la sede per fare teoria. Ma spero sempre che ci sia qualcuno interessato ad approfondire le affermazioni, selezionando le fonti, e leggendo qualcosa di più di 140 caratteri.
Ho usato il termine “artefatto normativo” e me ne scuso, ma almeno all’inizio ho voluto rendere omaggio ai ricercatori che, in questo caso hanno portato a termine una serie di indagini interculturali ed interna-
zionali, scoprendo che i codici, le regole (dette, Memoria culturale extrasomatica depositata) sono, per la specie umana la variabile più importante e, tra l’altro, quella che sopravvive nel tempo.
Vale a dire che la Bibbia, il Corano, la Costituzione, etc. sono le linee guida del nostro agire, andando al di là della dinamica bio-culturale che caratterizza ognuno di noi. E perché sopravvivano queste regole di comportamento desiderato o proibito, siamo stati disposti nei millenni per no ad uccidere o ad essere uccisi. Queste regole di solito sono scritte e depositate (nei libri, nella pietra, etc.) ma nella maggior parte dei casi sono tramandate oralmente o apprese nel corso delle nostre relazioni.

La base di questi comportamenti sono le regole, che derivano dalle idee, che scaturiscono dai valori. Pertanto i valori morali di una persona e della collettività a cui appartiene o da cui si sente rappresentato, sono la base della stessa esistenza.
Come cittadino italiano il mio punto di riferimento è sempre stato la Costituzione. Un documento che, mi rendo conto, poche persone hanno letto veramente; e pochissimi ne ricordano origini e contenuti. Ma quello è sempre stato il mio faro. Sono in crisi perché tutto attorno a me sembra diverso da quello che è stato scritto e tramandato. Preciso che quello fuori posto sono probabilmente io. Ho provato a ricordare, in modo semplice.
La Costituzione ha come rmatari Giuseppe De Nicola (1877, liberale giolittiano), Alcide De Gasperi (1881, democristiano), Umberto Terracini (1895, social-comunista). Cioè quelle che ancora oggi chiamiamo destra, centro e sinistra, nelle loro profonde diversità culturali, ideologiche e valoriali, si sono messe d’accordo su alcuni concetti di base.
Erano uomini dell’800. Maschi. Nati una ventina d’anni dopo l’unità d’Italia (1861), dopo 3 guerre di Indipendenza. Mancavano le donne che, bontà dei maschi, hanno avuto il diritto di votare solo nel 1946. Mancavano tutti i fascisti, che furono esclusi e rimasero silenti e latenti per qualche mese: nel dicembre del ‘46 fondarono il Movimento Sociale Italiano. Ancora oggi rivendicano un ruolo nella collettività, a torto o a ragione.
Mi af do ad un approccio sistemico, per scelta professionale e culturale, e i miei maestri mi hanno insegnato a non escludere nessuno, nessuna parte.
Per mettere in ordine i pensieri parto e mi fermo all’Art. 1, che recita: Art. 1 (Primo paragrafo) “L’Italia è una Repubblica democratica, fondata sul lavoro”. Repubblica (res-pubblica) cosa di tutti, al contrario di pensare al singolare presente. Mi suggerisco di ripensare all’idea di solidarietà.
Democratica (democrazia come diritto di appartenere, riconoscimento del diverso, dell’altra parte, discussione, dibattito, confronto costruttivo, sintesi e accettazione del volere della maggioranza).
Mi trattengo per un attimo sul signi cato di lavoro: credo sia da rimettere sul piatto dei valori fondamentali. In quanto è la sintesi sulla quale i “padri fondatori” hanno trovato un accordo. Ripeto IL LAVORO. Art. 1 (secondo Paragrafo) “La sovranità appartiene al popolo, che la esercita nelle forme e nei limiti della Costituzione”.
La sovranità è l’espressione della somma dei poteri di governo (legislativo, esecutivo e giudiziario) che sono, o dovrebbero essere, indipendenti fra loro. Ecco vorrei andare dal popolo italiano del 2025 per ricordargli che comanda lui, se gli interessa. Questo sistema infatti dovrebbe garantire a tutti i cittadini giustizia e libertà.
Calegari e Massimini (1978) dimostrano che secondo un approccio multidisciplinare l’uguaglianza è il parametro di riferimento delle strategie di relazione fra le persone ed
è intesa come “medesima opportunità di sviluppo per tutti”. Ed è questa la direttrice dei principi costituzionali.
Gli elementi che costituiscono il principio dell’uguaglianza sono
1. Il diritto di accedere all’informazione e di comprendere il sistema simbolico.
2 Il diritto alla partecipazione attiva per realizzare le conoscenze acquisite, nelle forme che rispecchiano le diversità dei soggetti.
3. Il diritto di partecipare al potere decisionale.
Per quanto sopra, non mi sento rappresentato, non mi sento compreso, mi sento sempre più solo. Posso spiegare questo stato d’animo: mi sento inadeguato nella vita di tutti i giorni dalla mancanza di coerenza fra la vita che osservo e le regole scritte. Soprattutto per quanto riguarda il concetto, il senso più stretto di lavoro.
Ancora una volta mi af do alla costituzione:
Art. 4 (primo paragrafo) “La Repubblica riconosce a tutti i cittadini il diritto al lavoro e promuove le condizioni che rendano effettivo questo diritto”.
Art. 4 (secondo paragrafo) “Ogni cittadino ha il dovere di svolgere, secondo le proprie possibilità e la propria scelta, un’attività o una funzione che concorra al progresso materiale o spirituale della società”.
La prima questione riguarda la promozione delle condizioni per realizzare il diritto al lavoro. Ma io non sono più tanto sicuro che le persone vogliano svolgere un lavoro come si è inteso per millenni: manodopera (agricoltura, produzione, servizi a cose), mentedopera (professionisti, servizi alla persona), salutopera (chi opera nella sanità), logisticopera (distribuzione), socialopera (mondo social e del web), intrattenimentopera (turismo, ristorazione, divertimento, cultura), diversopera (il cosiddetto terzo settore).
Mi sono inventato dei termini che cambiano per tempi e modi il concetto stesso di lavoro: e non permettono ad un contadino di comprendere chi passa il suo tempo di lavoro a registrare balletti su tik tok, o ad
un operaio a comprendere perché un manager guadagna no a 300 volte più di lui, a parità di tempo. Qualcuno mi ricorderà la diversa responsabilità: condivido. Ma il problema è spiegare questa diversità, laddove il secondo paragrafo recita “contribuire al progresso materiale e spirituale della società”.
PROSPETTIVE
Si dovrebbe parlare di futuro, di cambiamento, cioè di sostenibilità intesa come permettere al futuro di vivere le stesse condizioni di adesso.
La visione di futuro: questo nella dottrina è la caratteristica dell’imprenditore che dovrebbe “creare opportunità e ricchezza per sé e per gli altri”. Senza opportunità non c’è futuro, senza ricchezza non c’è energia per investire e accrescere il valore; se lo fa solo per sé stesso rimane solo, se lo fa solo per gli altri sarà insoddisfatto.
Questa dovrebbe essere l’etica dell’impresa all’interno del sistema economico. Negli anni 90 il prof. Leone Barbieri mi introdusse al concetto di EconomEtica. La domanda era “è possibile mettere insieme etica ed economia?”
Il losofo Jean-Jacques Rousseau precisava che «il termine economia o œcono-mia (oikonomia) deriva dal greco oikos (la casa) e nomos (la legge) e signi ca originariamente il legittimo e giudizioso governo della casa per il bene comune di tutta la famiglia.
L’economia quindi studia il modo in cui i membri di una collettività soddisfano i loro bisogni, attraverso l’utilizzo di beni e mezzi, di solito scarsi. In altre parole, l’economia è una scienza sociale che studia i comportamenti dell’uomo e l’interazione tra i vari soggetti.
EconomEtica è anche un centro di eccellenza per la ricerca, la formazione e la promozione dell’etica e della responsabilità sociale nell’economia e nell’impresa, con una forte vocazione alla collaborazione interdisciplinare e all’impatto sociale. (Bicocca e Fondazione Accenture).
Creare valore, occuparsi del benessere al-
trui e, di conseguenza, generare ricchezza. Possibilmente bellezza. Questa per me è sempre stata l’idea di economia, e quella di impresa come strumento per realizzare questo valore. Questa è una grande responsabilità, sociale.
Invece mi trovo di fronte a persone che spostano ricchezza esercitando speculazione nanziaria pura, spesso “parassitaria”, come citato più volte da economisti come Smith, Marx, Taylor, Keynes, Galbraith, (J.K. Galbraith, 2003).
Dialogo con professionisti che non hanno mai fatto impresa ma che ristrutturano le imprese altrui per conto di investitori che non conoscono minimamente la cultura di prodotto, di mercato, di territorio, di saperi: l’unico credo è l’ebitda. Legittimo, ma difficile da comprendere sul piano etico per chi ha l’idea di lavoro come creatività, come realizzazione del sé, come risultato di un percorso per la soluzione di problemi e di ricerca di innovazione.
Accolgo e ascolto eredi che aspettano che il vecchio muoia per ereditare e vendere; così come trovo anziani che presiedono la loro storia imprenditoriale bloccando qualsiasi interesse e passione dei giovani. In genere vedo intorno a me lo sguardo basso: a volte credo sia puntato sul cellulare, più spesso capisco che è sso sulla punta dei piedi. Si ragiona e si guarda sul qui ed ora. Così non si può guardare lontano, né guardarsi negli occhi.
Vorrei ancora credere:
• che sia possibile utilizzare criteri di equità per favorire scelte collettive, a motivazioni non solo auto-interessate;
• alla possibilità di educare le persone e la loro coscienza alle norme etiche;
• che la partecipazione sia percepita come un sistema per rappresentare la diversità delle parti;
• alla libertà come una conquista che riconosca a chi non l’ha avuta il sacri cio che ha permesso a me di averla.
A questo proposito, da un punto di vista psicologico, si può intendere la libertà com’è percepita dalle persone: negativa-
mente, come assenza di sottomissione, di schiavitù, di costrizione per cui l’uomo si considera indipendente, oppure positivamente, nel senso dell’autonomia e spontaneità del soggetto; con questo signi cato i comportamenti umani volontari si basano sulla libertà e vengono qualificati come (Inghilleri, P., 2003):
• libertà da qualcuno
• libertà di fare
• libertà di poter decidere (se hai gli strumenti intellettuali e relazionali per poter esercitare il libero arbitrio e la capacità critica)
«L’essenza della libertà è sempre consistita nella capacità di scegliere come si vuole scegliere e perché così si vuole, senza costrizioni o intimidazioni, senza che un sistema immenso ci prende e ci massacra; e nel diritto di resistere, di essere impopolare, di schierarti per le tue convinzioni per il solo fatto che sono tue. La vera libertà è questa, e senza di essa non c’è mai libertà, di nessun genere, e nemmeno l’illusione di averla.» (Berlin I., 1982)
Credo di condividere con molti altri, in questo momento storico, il sentimento della solitudine, convinto che le parole fondamentali di questo scritto dovrebbero essere in collegamento fra loro: lavoro, sovranità, diritti, doveri, famiglia, libertà… E non credo siano possibili cambiamenti a breve, a meno che coloro che pensano al “plurale futuro” non siano in grado di imporre, o mediare, una visione del domani a coloro che professano in tutti i modi il “singolare presente”. Nel rispetto di una vecchia-nuova Costituzione che sentiamo nostra.
BIBLIOGRAFIA
Berlin, Isaiah, 1982, Four Essays on Liberty, Oxford UP, Oxford Csíkszentmihályi, Mihály, 1990, Flow, Psicologia dell’esperienza ottimale, ed. Italiana, 2021, ed. ROI Macerata
3. Calegari, P., Massimini, F., 1978, Psicologia dell’Artefatto Normativo Sociale, Franco Angeli Editore, Milano
Galbraith, J., K., 2003, L’Economia della Truffa, ed. Rizzoli, Milano Inghilleri, P., 2003, La buona vita. Per l'uso Creativo degli Oggetti nella Società dell'Abbondanza, Ed. Angelo Guerini, Milano
F. Massimini, P. Inghilleri, 1987, L’esperienza Quotidiana, Teoria e Metodo di Analisi, Franco Angeli Editore, Milano







Falpi è presente anche quest’anno alla Fiera ISSA Pulire di Milano, con uno stand rinnovato, dove trovano spazio i prodotti di punta dell’azienda biellese che fa del Made in Italy, della qualità e della sostenibilità ambientale i suoi punti di forza sul mercato. Nata nel 1987, Falpi si è da sempre contraddistinta per la sualoso a basata sull’innovazione e sulla durabilità dei suoi prodotti, impegnandosi costantemente nella ricerca di nuove soluzioni e sistemi in grado di ridurre gli impatti ambientali. Da tempi non sospetti, infatti, Falpi ha intrapreso percorsi pionieristici, con tenacia, determinazione e convinzione, certi cando processi, prodotti, sistemi, in un continuum di attenzione all’uomo e all’ambiente, che non ha mai avuto battute d’arresto, e che continua ancora oggi, con immutato entusiasmo.
Oltre a numerosi prodotti conformi ai criteri CAM/GPP, Falpi offre un’ampia gamma di articoli con certi cazioni ambientali. Tra questi: 5 carrelli certi cati Ecolabel UE, 73 carrelli con etichetta EPD certi cati anche per l’impronta climatica secondo la norma UNI EN ISO/TS 14067, 54 contenitori ReMade in Italy e 277 articoli tessili con etichetta Ecolabel UE. Proprio in ambito Ecolabel UE, Falpi è stata pioniera nella certi cazione dei primi tessili, affermandosi come azienda “driver” del settore. Un primato riconosciuto da Ispra, che le ha assegnato per tre volte il Premio Nazionale Ecolabel UE, e oggi confermato da una gamma sempre più estesa e in continua evoluzione.
Oltre alle certi cazioni ambientali, Falpi ha ottenuto importanti riconoscimenti di sistema che confermano il suo impegno verso

qualità, etica e sostenibilità. Tra questi: ISO 9001:2015 (Qualità), ISO 14001:2015 (Ambiente), SA 8000:2014 (Responsabilità sociale), UNI/PdR 125:2022 (Parità di genere) e la prestigiosa attestazione ECOVADIS Silver Top. Un insieme di certi cazioni che testimonia l’adozione di standard internazionali in ogni fase dell’attività, integrando responsabilità ambientale, sociale e attenzione alla qualità.
La partecipazione a ISSA Pulire rappresenta per Falpi un’importante vetrina per presentare le novità sviluppate nell’ultimo anno: dalle soluzioni eco-friendly al nuovo Sistema Dosacontrol. Proprio in occasione della Fiera verranno infatti presentate le nuove proposte, sulle quali il Team Tecnico di Falpi è impegnato ormai da mesi, per lo sviluppo della progettazione dei servizi di pulizia e per la conduzione e il controllo delle prestazioni: novità queste destinate esclusivamente agli utilizzatori dei prodotti Falpi; non solo quindi prodotti quali carrelli e tessili per il professionista delle pulizie ma anche soluzioni pensate per la gestione di ogni fase del rapporto con il mercato.

Il Flat mop a lo continuo di Essecinque garantisce una pulizia impeccabile e senza aloni grazie all’intreccio tra micro bra e cotone. La micro bra rimuove sporco e polvere, mentre il cotone mantiene la giusta umidità, prolungando la durata del mop bagnato e permettendo di coprire super ci più ampie senza interruzioni.
La sani cazione è ef cace su ogni tipo di materiale e pavimentazione.

Al termine dell’uso, il mop si rimuove facilmente grazie al sistema a strappo, che assicura praticità, velocità nel cambio e massima aderenza al telaio.











Il prodotto è disponibile anche nella versione interamente in micro bra, ideale per un utilizzo più tradizionale.
Il mop con sistema a strappo offre il massimo delle prestazioni se abbinato al telaio in alluminio con snodo centrale scorrevole.
Con un semplice gesto, lo snodo si sgancia e si sposta lateralmente lungo i binari, dove si blocca: l’operatore può così far scorrere il mop sotto mobili e ostacoli senza sforzo.
Il blocco laterale consente l’uso del telaio anche nei passaggi più dif cili, facilitando la pulizia in ambienti ingombrati da scaffali, arredi o attrezzature.

































































































Industrie Celtex, fondata nel 1985 da Andrea Bernacchi, Alessandro Carrara e Claudio Giacometti, celebra quest’anno il suo 40° anniversario: quattro decenni di crescita costante nel settore cartario. Una realtà solida e strutturata, che fonda la propria filosofia su tre pilastri essenziali: qualità, innovazione e sostenibilità. Principi che stanno alla base di tutte le scelte produttive a marchio Celtex, dall’attenta selezione delle materie prime all’implementazione di processi produttivi responsabili e circolari. Un esempio concreto di questa visione sono i sistemi di dispensazione Megamini, sintesi di estetica e tecnologia. Erogazione controllata, riduzione dei consumi, elevata autonomia, continuità di servizio, queste le caratteristiche distintive dei sistemi Megamini. Realizzati in ABS, materiale riciclabile al 100%, sono pensati per integrarsi perfettamente in ogni ambiente, grazie anche alla variante bianca e nera, fornendo la soluzione ideale alle esigenze della struttura in cui sono inseriti.
I sistemi di dispensazione Megamini sono compatibili con le linee in carta Celtex, declinate in formati e materie prime differenti, dalla pura cellulosa al riciclato, coprendo così ogni necessità di pulizia e igiene. Indipendentemente dalla materia prima di origi-

ne, ciascuna bra viene lavorata con cura e precisione per creare carte professionali dalle prestazioni elevate. Le linee Celtex sono pensate per valorizzare la materia prima, a partire dalla pura cellulosa, proveniente da foreste gestite responsabilmente, no alle carte in riciclato, realizzate donando nuova vita agli sfridi di lavorazione, secondo una logica di economia circolare. Nulla va sprecato: ciò che resta dal processo produttivo viene recuperato già in fase pre-consumo e trasformato in nuove soluzioni performanti e di qualità. Prime rappresenta l’eccellenza: una linea in 100% pura cellulosa che coniuga resistenza, morbidezza e alto potere assorbente. Una scelta premium, ideale per chi ricerca performance superiori e standard qualitativi elevati. Save Plus interpreta il concetto di risparmio sostenibile. Realizzata con il 100% di bre rigenerate, recuperate dagli sfridi della pura cellulosa in fase di trasformazione, questa gamma offre un prodotto economico e responsabile, con un grado di bianco del 75%, senza l’aggiunta di agenti sbiancanti. La gamma E-Tissue, invece, è il riciclato di prima generazione che nasce dalla lavorazione combinata degli sfridi di kraft e dei ri li di cellulosa. Caratterizzata da una naturale tonalità avana, E-Tissue mantiene intatte la forza e la resistenza dei materiali da cui trae origine, nel pieno rispetto delle risorse. Attraverso proposte complete, Celtex conferma il proprio impegno verso un modello produttivo sempre più responsabile, dove qualità, eco-sostenibilità e innovazione convivono in un equilibrio perfetto tra performance e rispetto per l’ambiente.

TENDENZE
Cleaning-in-place con gli enzimi

CASE HISTORY
Procedure igieniche in una cantina vinicola
PRODOTTI CERTIFICATI
E TRACCIABILI, GIÀ CONFORMI ALLA NUOVA
REGOLAMENTAZIONE EUROPEA
PEST CONTROL
Nuove tecnologie nel controllo roditori

















DA

PROFESSIONALI DI ALTA QUALITÀ, EFFICIENZA ED AFFIDABILITÀ
Per ulteriori informazioni, visita il nostro sito web

NELLE TUE MANI









HiMiX Professional assicura alte prestazioni, rispetto per le superfici e l’ambiente e garantisce la sicurezza di clienti e lavoratori. Conforme ai piani di controllo HACCP, assicura i massimi standard di pulizia e igiene.

DA OLTRE 60 ANNI, FORMULATI PROFESSIONALI DI ALTA QUALITÀ, EFFICIENZA ED AFFIDABILITÀ
Per ulteriori informazioni, visita il nostro sito web


Il 21 febbraio 2025 la Commissione Europea ha introdotto il Regolamento (UE) 2025/351 relativo ai materiali e agli oggetti di materia plastica destinati al contatto con gli alimenti. Tra le novità più rilevanti vi è un nuovo articolo dedicato a etichettatura, dichiarazione di conformità e documentazione che rafforza l’impegno verso una trasparenza totale e una sicurezza sempre più elevata per l’utilizzatore.
In questo scenario, Igeax si conferma realtà d’eccellenza: unico produttore italiano specializzato in articoli per la pulizia certi cati MOCA, è stato tra i primi ad adottare un sistema di tracciabilità sostenibile direttamente impressa sui propri prodotti. La marcatura applicata non sbiadisce nel tempo, non richiede l’utilizzo di sostanze chimiche e non altera la composizione dei materiali che rimangono sicuri da utilizzare. Un approccio quello di Igeax che unisce igiene, trasparenza e responsabilità ambientale, ponendosi al servizio delle industrie alimentari più esigenti. Per l’azienda la certi cazione MOCA rappresenta un valore imprescindibile che rispecchia pienamente la sua missione: fornire strumenti conformi, af dabili e tracciabili, valorizzando il knowhow italiano e anticipando le esigenze del settore. Schede tecniche chiare, dichiarazioni di conformità aggiornate, materiali sicuri e
durevoli: ogni dettaglio è pensato per rispondere alle richieste degli auditor e garantire la massima sicurezza.
UNO SGUARDO AL FUTURO
La delizzazione di clienti che condividono la medesima visione di Igeax ha contribuito ad alimentare il percorso di crescita e innovazione continua che ha portato l’azienda ad ampliare nel tempo l’offerta, includendo soluzioni dedicate alle industrie di produzione e lavorazione degli alimenti. Tra le novità più recenti spiccano i raschietti e i pennelli di precisione, studiati per garantire una pulizia impeccabile e conforme alle normative più stringenti, in un settore in cui ogni dettaglio conta. Rispettosi dei più alti standard di igiene, sono il risultato di un’attenta analisi dei bisogni speci ci del comparto alimentare, dove l’ef cienza e la sicurezza non possono essere compromesse.
Non solo raschietti e pennelli, la gamma Igeax continua ad arricchirsi di nuovi strumenti: a ISSA Pulire l’azienda svelerà una nuova eccellenza, frutto di un lungo percorso di progettazione e sperimentazione.
Con Igeax, la pulizia professionale si evolve: non semplici utensili ma strumenti certi cati, sostenibili e tracciabili lungo tutta la liera, progettati per soddisfare pienamente le reali esigenze di chi lavora a contatto con gli alimenti.




































































































































Unico produttore italiano di articoli per la pulizia certificati MOCA








































Pioniere nell’adozione di un innovativo sistema di tracciabilità sostenibile



















Partner ideale per ogni esigenza di pulito in ambito alimentare e industriale
Vieni a scoprire il mondo Igeax a PAD.8 STAND G27 H28

PROSPETTIVA
SETTORI COMPLEMENTARI IN EVOLUZIONE

CONTROLLO QUALITÀ 128PRINCIPI DI IGIENE DEGLI ALIMENTI

LABORATORIO
IGEAX
è il partner ideale per ogni esigenza di pulito: le soluzioni offerte spaziano dalle linee Hygiene e Detectabile per il settore alimentare alla linea Industrial per le attività commerciali, passando per i prodotti della linea Aricasa destinati alla GDS e all’utilizzo domestico.
Gli innumerevoli articoli realizzati in Italia con materie prime di alta qualità permettono di ottenere il massimo con il minimo sforzo.

PACKAGING 140PROTEGGERE GLI ALIMENTI



144ECCELLENZA DEL VINO E DELLA CURA DELL’IGIENE SANIFICAZIONE


DISINFESTASTORIE
152RIFLESSIONI DI UNO ZUZZURELLONE
SICUREZZA
156GLI ACARI DELLE DERRATE TECNOLOGIE
RODITORI
162RILEVAMENTO CON INFRAROSSI
INSETTI ALIENI
166INVASIONE SILENZIOSA
LEPIDOTTERI
172LA TIGNOLA DELLE DERRATE CASE HISTORY
148ENZIMI PER UN CLEANING IN PLACE SOSTENIBILE
160MONITORAGGIO INTELLIGENTE







CRISTINA CARDINALI
Negli ultimi anni il cleaning professionale ha subito notevoli trasformazioni, grazie all’introduzione di nuove tecnologie, a una crescente attenzione alla sostenibilità ambientale e a normative sempre più stringenti.
Nell’industria alimentare questi cambiamenti sono cruciali e hanno un impatto decisivo per assicurare la sicurezza alimentare, mantenere alti standard di qualità e la ducia dei consumatori.
Le tecnologie avanzate, in particolare, stanno cambiando radicalmente il modo in cui le aziende alimentari gestiscono la pulizia e la sani cazione. Parliamo ad esempio di pulizia automatizzata, ormai sempre più diffusa, a partire dal periodo della pandemia. Questi robot eseguono operazioni di pulizia in modo ef ciente e costante, riducendo il rischio di errori umani e migliorando e monitorando l’ef cacia complessiva del processo.
La sostenibilità è l’altro fattore chiave che sta in uenzando il settore. Le aziende stanno infatti adottando prodotti di pulizia ecologici o tecniche che possono ridurre l’uso di acqua.
Mi riferisco ad esempio all’introduzione di nuovi prodotti, come i detergenti enzimatici, o alle opportunità offerte dalla corretta gestione dell’acqua di processo delle lavorazioni.
Questo non solo aiuta a proteggere l’ambiente, ma risponde anche alle crescenti aspettative dei consumatori per pratiche aziendali più sostenibili.
E poi le normative europee, come il Regolamento (CE) n. 852/2004, che continuano a stabilire standard rigorosi per l’igiene degli alimenti. Disposizioni puntuali, sempre più stringenti, richiedono che le aziende implementino procedure basate sui principi dell’HACCP (Hazard Analysis and Critical Control Points), garantendo un approccio sistematico alla sicurezza alimentare. In ne, non ci stancheremo mai di sottolinearlo, il ruolo fondamentale della formazione continua del personale. Due esigenze si pongono con forza sempre maggiore: la quali cazione degli addetti, in particolare sulle tematiche della sicurezza igienica che è intimamente connessa alla responsabilità. Il personale deve essere costantemente formato sulle buone pratiche di igiene: lavaggio delle mani, uso corretto dei DPI (dispositivi di protezione individuale), accurata pulizia degli ambienti e delle attrezzature. Fare in modo che i dipendenti siano aggiornati sulle ultime tecniche e normative non solo migliora la qualità della pulizia, ma contribuisce a creare una cultura aziendale orientata alla sicurezza e alla qualità.
igiene alimentarecontrollo qualità
In Europa vige il Regolamento UE 852/2004, il cui obiettivo principale è garantire un elevato livello di protezione dei consumatori in materia di sicurezza alimentare
PAOLO BERSIGHELLI Business Developer Manager Food sector, BSI
ROBERTO MOZZONE iologo auditor e tutor ualificato
Il Codex Alimentarius è un insieme di standard internazionali per gli alimenti, le bevande e gli ingredienti alimentari, sviluppato congiuntamente dall’Organizzazione Mondiale della Sanità (OMS) e dall’Organizzazione delle Nazioni Unite per l’Alimentazione e l’Agricoltura (FAO). Questo corpus normativo ha lo scopo di proteggere la salute dei consumatori e garantire pratiche commerciali eque nel settore alimentare su scala globale.
Le revisioni dei Principi Generali di igiene degli alimenti CXC 1-1969 del 2020 e del 2022 da parte del Codex Alimentarius hanno rappresentato importanti pietre miliari nella continua evoluzione degli standard alimentari globali.
La revisione del 2020 ha affrontato una serie di tematiche cruciali nel contesto attuale della sicurezza alimentare. Uno degli aspetti più signi cativi di questa revisione
è stata l’integrazione di nuove tecnologie e metodologie per l’analisi dei rischi alimentari.
Nello speci co i cambiamenti sono apprezzabili nei seguenti punti:
• ampliamento sezione de nizioni;
• riferimento all’utilizzo dell’albero decisionale;
• rafforzamento sezione formazione e competenze;
• nclusione nella sezione impegno della direzione della clausola sulla cultura della sicurezza alimentare;
• nuovo requisito per identi cazione del lotto e tracciabilità.
Questo ha consentito una maggiore precisione nelle valutazioni dei rischi e una migliore gestione delle problematiche sanitarie relative agli allergeni, introducendo un nuovo codice di condotta (CXC 80-2020 Code of practice on food allergen management for food business operators). Inoltre,
la revisione del 2020 ha posto particolare enfasi sulla trasparenza e sulla partecipazione delle parti interessate nel processo decisionale.
Ciò ha permesso una maggiore inclusione di prospettive diverse e ha rafforzato la legittimità e l’accettazione degli standard stabiliti.
La revisione del 2022 (pubblicata nel 2023) ha visto ulteriori miglioramenti negli standard alimentari, con un focus particolare sulla sostenibilità ambientale e sull’etica nel settore alimentare. Si è dedicata attenzione alla riduzione degli sprechi alimentari e alla promozione di pratiche agricole e di produzione più sostenibili.
Viene ampliato l’approfondimento sulle buone prassi igieniche o GHP - Good Hygiene Practices (comunque già presente nella versione 2020) e inserito un nuovo albero delle decisioni per la valutazione delle fasi del processo e l’identi cazione dei CCP - Punti critici di controllo.
Il termine Codex Alimentarius ha radici latine e significa letteralmente libro degli alimenti l suo sviluppo ha avuto inizio negli nni , con l obiettivo di ornire linee guida armonizzate per garantire la sicurezza e la qualità degli alimenti a livello internazionale al momento della sua creazione, il ode ha subito revisioni e aggiornamenti costanti per ri ettere gli sviluppi scientifici e tecnologici nel campo della sicurezza alimentare che a valle sono stati recepiti dall H ra gli altri comitati coinvolti nello sviluppo e nell aggiornamento dell H possiamo citare ational dvisor ommittee on icrobiological riteria or oods , nternational ommission on icrobiological Specifications or ood S e nternational i e Sciences nstitute S n uropa vige il egolamento il cui obiettivo principale garantire un elevato livello di protezione dei consumatori in materia di sicurezza alimentare articolo del egolamento richiede l attuazione dei principi H , ma non richiede un sistema H pienamente documentato l regolamento si applica a tutte le operazioni alimentari, a eccezione della produzione primaria

Questi controlli preventivi possono essere ancora necessari per la sicurezza alimentare, ma non soddisfano i criteri per un CCP. Per queste situazioni, l’albero decisionale del Codex modi cato potrebbe essere più utile, perché permette di identi care anche misure di controllo diverse dai CCP, con un criterio che si avvicina a quanto già previsto da ISO 22000 e dalla normativa USA, predisposta da FDA, nel Title 21 cfr. 117.126.
ganizzazioni internazionali nel migliorare costantemente gli standard alimentari, garantendo la protezione della salute dei consumatori e promuovendo pratiche sostenibili nell’industria alimentare.
La nuova versione dell’albero ha infatti solo quattro domande mentre la versione precedente ne aveva cinque disposte con un ordine diverso. L’inizio del nuovo albero è più in linea con quello proposto dall’Istituto Campden BRI e offre l’opportunità di identi care, nella domanda Q1, se un pericolo signi cativo può essere gestito da un PRP.
Inoltre, la revisione del 2022 ha affrontato in modo più dettagliato le questioni legate all’etichettatura alimentare, fornendo linee guida più chiare per garantire informazioni accurate e accessibili ai consumatori.
MIGLIORAMENTI CONTINUI
Il Codex Alimentarius rimane un pilastro fondamentale nel panorama della sicurezza alimentare globale.
Le revisioni del 2020 e del 2022 hanno dimostrato l’impegno continuo delle or-
L’importanza dei Programmi di Prerequisito (GMP e GHP) come procedure necessarie a creare un ambiente di lavoro sicuro è stata rimarcata nella Linea guida del Codex, come anche la necessità di individuare altre misure di controllo, diverse dai CCP, al ne di controllare pericoli signi cativi come quelli derivati dalle procedure di gestione degli allergeni, delle pulizie, dell’etichettatura e di approvazione dei fornitori.
In un mondo in rapida evoluzione, la collaborazione internazionale e l’adattamento costante sono essenziali per affrontare s de sempre nuove nel settore alimentare.
Il Codex Alimentarius continua a svolgere un ruolo chiave in questo processo, fungendo da guida af dabile per produttori, consumatori e regolatori in tutto il mondo.




È ormai assodato che un’ambiente pulito e salubre contribuisce al benessere delle persone che risiedono in esso. Considerando gli ambienti con un alto usso di persone (uf ci pubblici, scuole, mense) o gli ambienti dove risiedono persone fragili come ospedali o centri di cura, diventa davvero essenziale mantenere un ambiente salubre per ridurre di diffusione di microrganismi patogeni. Quindi le parole d’ordine sono essenzialmente: Pulire e Disinfettare.
Ma anche le procedure di pulizia devono essere adeguate e speciche per l’ambito in cui si sta operando. È assolutamente controproducente utilizzare grossi quantitativi di prodotto oppure ripetere le operazioni di pulizia troppo frequentemente se questo non è necessario. I prodotti chimici utilizzati per le operazioni di sani cazione sono generalmente costosi e i loro residui sono anch’essi dannosi per la salute umana. Quindi è necessario trovare il giusto equilibrio tra un ambiente che deve essere pulito e l’utilizzo di prodotti chimici potenzialmente dannosi per la salute umana.
Il consiglio è quello di veri care l’effettiva pulizia mediante un test oggettivo e rapido che ci premette di stabilire se le procedure di sani cazione sono state effettuate correttamente oppure se è necessario intervenire nuovamente.
Il test che meglio si adatta a questa applicazione è il test dell’ATP
che si effettua con il Bioluminometro e con i tamponi monouso ad esso dedicati. Per questo scopo, RG Strumenti propone il Bioluminometro En Sure Touch con i relativi tamponi Ultrasnap. Il test dell’ATP sfrutta la capacità della molecola Adenosin Trifosfato (ATP) di emettere luce quando è a contatto di un particolare enzima (Luciferina). Poiché l’ATP è presente in tutti gli organismi viventi, la sua presenza sulle super ci è riconosciuta da tutti come indice di “sporco organico”. La semplicità del test e l’immediatezza del risultato permettono all’operatore di determinare oggettivamente e in tempo reale se una super cie è stata pulita adeguatamente oppure se è necessaria un’eventuale azione correttiva. Si può utilizzare anche il test dell’ATP durante le operazioni di pulizia proprio per ottimizzare le procedure che si sono adottate. Infatti se dopo l’applicazione del detergente e il relativo risciacquo, ho modo di veri care che la super cie è già adeguatamente pulita, non è più necessario utilizzare il disinfettante. L’utilizzo di un prodotto sani cate su una super cie già priva di microorganismi non solo è inutile ma è anche dispendioso.
UNA SCELTA GREEN
Utilizzando il test dell’ATP si possono anche veri care quali siano le minime concentrazioni dei prodotti utilizzati per la pulizia, che
però mi garantiscano l’ef cacia del risultato. In questo modo eviterò degli sprechi di sostanze chimiche che andranno a vantaggio dell’ambiente e delle nostre tasche.
La salvaguardia dell’ambiente è molto importante anche per Hygiena International LTD il produttore del Bioluminometro EnSure Touch. Infatti i tamponi monouso Ultrasnap che si utilizzano per eseguire il test dell’ATP, sono costruiti in materiale plastico completamente riciclabile e non contengono sostanze chimiche pericolose. Dopo il loro utilizzo possono essere gettati nel contenitore della raccolta differenziata della plastica. Anche il Bioluminometro EnSure Touch è “amico” dell’ambiente. Lo strumento è dotato di un sistema di archiviazione dei dati in cloud che permette di visualizzare i risultati ottenuti accedendo da qualsiasi PC eliminando la necessità di effettuare la stampa su carta. In conclusione, utilizzando un sistema di monitoraggio dell’igiene ambientale come il test dell’ATP si ottengono numerosi vantaggi: innanzitutto si ha la garanzia della salubrità dell’ambiente che ci circonda, si possono ottimizzare le procedure di pulizia adottate ed in ne si possono testare i detergenti e i disinfettanti utilizzati. Tutte queste attività vanno a favore della salvaguardia dell’ambiente che ci circonda e sono volte ad ottenere un risparmio signi cativo per l’azienda che le applica sia in termini economici che di tempo.




igiene alimentarelaboratorio

Il latte, quando contaminato da microrganismi, provoca trasformazioni dannose per la qualità dei prodotti finiti attraverso la degradazione dei suoi costituenti
STEFANIA MILANELLO
esperta in tecnologie alimentari e divulgatrice scientifica
Comprendere la conta batterica totale nel latte crudo è fondamentale per valutarne la qualità microbiologica. La Scheda informativa dell’IDF n° 36/2024 Expression of total bacteria count in raw milk, preparata sotto la guida del Comitato permanente dell’IDF per le statistiche e l’automazione, spiega i processi di misurazione e le diverse espressioni dei risultati. È importante evidenziare che il latte contaminato può avere un impatto sulle proprietà organolettiche dei prodotti niti (Murphy et al., 2016). Il latte, quando contaminato da microrganismi, provoca trasformazioni dannose per la qualità dei prodotti niti attraverso la degradazione dei suoi costituenti (proteine, lipidi, lattosio) e/o il rilascio al loro interno di composti indesiderati. Queste degradazioni provocano difetti nel gusto, nell’odore, nell’aspetto e nella consistenza.
COME VIENE MISURATA LA CONTA BATTERICA TOTALE
In molti paesi, la determinazione di routine della conta batterica totale nel latte crudo si basa sull’applicazione di analizzatori citometrici a usso automatizzati. Con la citometria a usso, i singoli batteri vengono colorati con un colorante uorescente e rilevati come impulsi luminosi, indipendentemente dalla loro capacità di crescere. Punti di forza sono la precisione del metodo e la disponibilità diretta del con-
teggio. I risultati ottenuti con questi strumenti sono espressi come conta batterica individuale per millilitro (IBC/mL), che è quindi un’unità correlata al metodo. Tuttavia, molti modelli di sedimentazione e limiti legali sono indicati in unità del metodo di conta su piastra standard (SPC), ovvero unità formanti colonie per millilitro (CFU/mL). Il metodo SPC classico si
04 / 2025
basa sulla crescita di singole unità (batteri o gruppi di batteri) in colonie batteriche visibili agli occhi dopo un periodo di incubazione di tre giorni. Per la conta batterica totale, si presuppone che ciascuna colonia derivi da un batterio presente nel campione di latte. Le CFU conteggiate includono solo microrganismi in grado di moltiplicarsi e formare colonie visibili agli occhi
con la combinazione specifica di terreno di crescita, temperatura e tempo.
Entrambi i metodi, IBC/mL e CFU/mL, forniscono una proiezione della popolazione batterica nel campione. Tuttavia, poiché questi metodi si basano su principi diversi e si riferiscono a proprietà diverse delle cellule microbiche, i risultati non saranno equivalenti.
ESPRESSIONE DEI RISULTATI, CONVERTIRE O NON CONVERTIRE?
Quando si utilizzano metodi citometrici a usso, la classi cazione del latte può essere eseguita esclusivamente in base ai valori in IBC/mL. Nel caso in cui sia necessario veri care il rispetto dei limiti (normativi) in CFU/mL, i risultati in IBC/mL devono essere convertiti in valori equivalenti in CFU/mL. La conversione consente il confronto dei risultati quantitativi ottenuti con metodi alternativi, come gli analizzatori citometrici a usso, con valori o limiti indicati in CFU/mL. Una guida sullo sviluppo e il mantenimento di un’equazione di conversione adeguata è descritta nella norma ISO 21187/IDF 196 (International Dairy Federation & International Organization for Standardization, 2021). La norma fornisce le linee guida per stabilire un rapporto di conversione tra i risultati di un metodo alternativo e un metodo di ancoraggio, e la sua veri ca per la determinazione quantitativa della qualità microbiologica del latte. La relazione di conversione può essere utilizzata per convertire i risultati di un metodo alternativo alla base di ancoraggio oppure per convertire i risultati/limiti, espressi su base di ancoraggio, in risultati in unità di un metodo alternativo.
Le equazioni di conversione nei diversi paesi possono differire a causa dei sistemi locali di produzione del latte, che possono avere un impatto sulla popolazione batterica e di conseguenza sulla relazione tra la loro colorabilità con metodi citometrici a usso e la loro capacità di crescita con il metodo SPC. Inoltre, la variazione nell’esecuzione sia del metodo SPC che del metodo alternativo può esercitare un effetto sul risultato (Cassoli et al., 2016). Lo sviluppo e il mantenimento delle equazioni di conversione sono condotti dagli stessi laboratori o da organismi nazionali competenti e richiedono notevoli risorse analitiche e statistiche.
L’SPC registra solo i microrganismi in grado di crescere e formare colonie visibili. Il
La conta batterica totale è un indicatore chiave della qualità microbiologica del latte crudo. In generale, le misurazioni hanno un duplice scopo:
• Promuovere pratiche igieniche nella gestione delle mandrie da latte, nella mungitura e nella conservazione del latte. Ciò garantisce l’idoneità del latte crudo alla lavorazione e la qualità dei prodotti finali risultati dei test possono essere accompagnati da incentivi per mantenere elevati standard igienici o per stimolare le azioni desiderate come parte di accordi privati tra agricoltori e trasformatori.
erificare il rispetto dei limiti legali per il contenuto totale di batteri secondo le normative, ad esempio il Regolamento UE n. 853/2004, che stabilisce norme specifiche in materia di igiene per gli alimenti di origine animale, o l’Ordinanza sul latte pastorizzato negli Stati Uniti. Risultati non conformi possono portare al rifiuto del latte i conseguenza, i dati sono soggetti a controllo legale.

risultato è espresso in CFU/mL. Mentre FC rileva i segnali luminosi provenienti da cellule batteriche colorate individualmente. Il risultato è espresso in IBC/mL.
ESEMPI DI ESPRESSIONE
DELLA CONTA BATTERICA TOTALE
La conta batterica totale è espressa in IBC/ mL o in CFU/mL, tuttavia è anche possibile una combinazione in cui, sulla base di una singola misurazione, IBC/mL viene applicata per la classi cazione e il pagamento del latte e CFU/mL viene applicata a ni normativi.
Alcuni paesi con molti laboratori come il Stati Uniti, Germania, Italia e Brasile hanno sviluppato un’equazione di conversione nazionale per garantire che il latte misurato in diversi laboratori venga classi cato e valutato in modo uniforme rispetto ai limiti normativi (Bolzoni et al., 2015). Altri Paesi, invece, applicano equazioni di conversione diverse a seconda della regione, rispettando così le differenze nei sistemi di produzione. Ad esempio, paesi come Regno Unito, Norvegia, Islanda e Canada utilizzano IBC/mL per la classi cazione del latte e per scopi legali sin dall’introduzione degli analizzatori citometrici a usso. Per dettagli su vantaggi e svantaggi delle possibili opzioni, l’IDF suggerisce di fare riferimento al Bollettino dell’IDF n° 511/2021 (International Dairy Federation, 2021) Guida all’applicazione delle equazioni di conversione per la determinazione della qualità microbiologica del latte crudo, che descrive le esperienze maturate in quasi 40 anni e illustra le situazioni in cui la conversione delle unità TBC è rilevante e in cui potrebbero essere utilizzate le unità di metodi alternativi. Fornisce un confronto di tre possibili approcci alla conversione per aiutare gli utenti a scegliere l’approccio migliore. Le informazioni fornite hanno lo scopo di aiutare il settore lattiero-caseario a prendere una decisione ottimale per ciascun laboratorio/regione/paese o altro scopo speci co.
Si tratta di dispositivi adatti a campionare superfici di ogni genere e ampiezza, punti difficilmente raggiungibili, attrezzature, carcasse animali, allevamenti ecc.
Vengono inumiditi con una soluzione sterile, spesso neutralizzante rispetto ai comuni disinfettanti, e poi strisciati sulla superficie delimitata da una cornice sterile di 10x10 cm o 5x5 cm. Infine vengono processati per seminare specifici terreni di coltura e determinare il numero di UFC.










Ampia gamma di kit rapidi ed ELISA per la ricerca di allergeni alimentari su superfici e in matrici alimentari. I kit, a seconda della tipologia, sono adatti per lo screening in produzione e per il rilascio finale.


igiene alimentare
I challenge test sono strumenti estremamente vantaggiosi per valutare la sicurezza alimentare e per definire la shelf life, i parametri di processo e di prodotto
VALENTINA BERNINI
Dipartimento Scienze degli Alimenti e del Farmaco UniParma
5.763 epidemie di origine alimentari (+43,9% -17,6% Salmonella)
48.605 casi di malattia
2.783 ospedalizzazioni (50,5% Salmonella)
64 morti (43,8% Listeria monocytogenes)
Il challenge test nasce come strumento per dare un contributo alla valutazione della sicurezza degli alimenti, ma è applicato oggi anche per tutti gli aspetti legati alla qualità microbiologica. Nel 2022 si sono registrate più di 5.700 epidemie di origine alimentare e hanno registrato rispetto all’anno precedente un incremento signi cativo (+40%).
A queste epidemie sono stati associati oltre 48.000 casi di malattia, con un numero molto elevato di ospedalizzazioni, riferite soprattutto a casi di salmonellosi. Sono stati registrati 64 decessi, di questi la metà è da imputarsi alla Listeria monocytogenes
Oltre all’effetto diretto che ha sul consumatore, il pericolo microbiologico ha ricadute più ampie anche sul contesto sociale (le persone tendono a non acquistare più i prodotti coinvolti in episodi noti), e industriale (perdita del fatturato).
Fortunatamente, all’interno dell’Unione
Europea bene ciamo di ottimi strumenti che permettono di tenere sotto controllo il rischio associato alla presenza di questi microrganismi patogeni nel corso della liera produttiva.
A COSA SERVONO I CHALLENGE TEST?
I challenge test sono degli strumenti scientifici che permettono di determinare la capacità di uno o più microrganismi di crescere e svilupparsi in un alimento, ma anche di veri care l’ef cacia di uno step di processo nell’inibizione o nella riduzione, al di sotto di quella che è considerata la soglia di pericolo per i consumatori, di microorganismi che possono eventualmente entrare all’interno del processo di produzione. Interessando sia lo sviluppo in un alimento che la valutazione degli step di processo, si differenziano in due categorie.

Il challenge test di prodotto è una simulazione di contaminazione eseguita in sito, quindi in condizioni reali, che avviene sul prodotto solo al termine del processo produttivo; in questo caso non è importante la storia produttiva che ha permesso di ottenere quel prodotto, ma valutare cosa potrebbe accadere nella shelf life di quel
04 / 2025
prodotto nel caso in cui si riscontrasse una contaminazione all’interno del processo produttivo. Nel caso del challenge test di processo viene analizzato il processo di trasformazione, perché, molto spesso, in questa simulazione si procede con la contaminazione della materia prima, si va a condurre una trasformazione in quelle che
sono le effettive correzioni operative e si va a verificare se particolari step di processo abbiano un effetto significativo nel controllo dei microrganismi.
CORRETTA PROGETTAZIONE
DELLA SPERIMENTAZIONE
Prima di progettare un challenge test, è ne-
UNI EN ISO 20976-1:2019
Microbiologia della catena alimentare
• Requisiti e linee guida per condurre “Challenge tests” in alimenti e mangimi - Parte 1: “challenge tests” per lo studio del potenziale di crescita, lag time e il tasso di massima crescita.
UNI EN ISO 20976-2:2022
Microbiologia della catena alimentare
• Requisiti e linee guida per condurre “Challenge tests” in alimenti e mangimi - Parte 2: “challenge tests” per lo studio del potenziale di inattivazione e dei parametri cinetici.
cessario individuare i target che sono interessati nel particolare studio, ovvero quei microrganismi che possono essere riscontrati come contaminanti di quel prodotto o di quel processo e che sono anche collegati a casi epidemiologici. Dopo aver identicato la specie di interesse è importante selezionare correttamente i microrganismi, quindi nello speci co i ceppi che vengono utilizzati per questa contaminazione articiale. Si tratta dunque di dover identi care delle miscele di microrganismi appartenenti alla specie target, in quanto l’utilizzo di un singolo ceppo potrebbe non essere rappresentativo del comportamento della specie in quel prodotto o nel corso di quel processo, perché all’interno delle specie esistono comunque delle biodiversità. In conclusione l’utilizzo della miscela permette di ottenere delle risposte che si possono effettivamente ricondurre alla specie stessa ed elimina il rischio di ottenere degli scenari dettati da peculiari caratteristiche del singolo biotipo.
Fondamentale è anche la scelta della modalità di inoculo. Il challenge test è una simulazione di contaminazione in condizioni
reali quindi il monitoraggio del comportamento del microrganismo deve avvenire nelle condizioni in cui il consumatore, ad esempio, conserva il prodotto, quindi non bisogna nella fase di contaminazione andare a denaturare quella che è la struttura del prodotto per non andare a comprometterne da un punto di vista chimico- sico le caratteristiche.
È necessario poi stabilire le condizioni di conservazione, identi care in modo preciso quelle che sono le fasi del processo o i punti degli impianti che vogliono essere monitorati e stabilire il piano di campionamento prima di iniziare la sperimentazione, perché la contaminazione del lotto soggetto ad analisi deve avvenire nello stesso momento.
Diversi sono i fattori da considerare per la corretta progettazione e realizzazione della sperimentazione: la selezione dei microrganismi da utilizzare per la contaminazione, le modalità di inoculo, le condizioni di conservazione del prodotto, le fasi del processo/punti dell’impianto, il piano di campionamento (metodo e tempi di analisi, numero di campioni).
SPERIMENTAZIONE SU LISTERIA MONOCYTOGENES
La noti ca da parte del sistema di allerta RASFF di alcuni casi relativi al ritrovamento di Listeria monocytogenes in alcune mozzarelle, ha portato allo sviluppo di challenge test che andassero a focalizzarsi sulla capacità del microrganismo, una volta presente, ad esempio, nell’acqua di rassodamento utilizzata nel processo di produzione di aderire sulla super cie del prodotto e quindi analizzare anche il fatto che potesse eventualmente essere poi rilasciato nel contatto con altri liquidi che intervengono nelle fasi di processo.
A seguito di contaminazione dell’acqua di rassodamento, l’immersione di una mozzarella non contaminata, dopo un certo tempo di contatto sia del liquido dell’acqua di ras-
sodamento che della mozzarella e successive operazioni, ha permesso, ad esempio, di stabilire come in poche ore già avvenga l’adesione e nelle successive fasi di lavorazione parte del microrganismo rimane adeso e parte viene rilasciato nei liquidi. Questo può, quindi, creare delle cross-contaminazioni tra anche i liquidi coinvolti nel processo che magari inizialmente non risultano contaminati, perché la contaminazione deriva da passaggi successivi. Un altro esempio legato sempre al prodotto, che analizza però un’operazione: il taglio delle forme formaggio gorgonzola. In questo caso il challenge test ha predisposto la contaminazione superficiale di intere forme di formaggio e poi la simulazione di operazioni di taglio. L’esperimento ha determinato delle percentuali di contaminazione della pasta, ovvero la parte edibile del formaggio. È possibile ridurre questo trascinamento controllando la contaminazione della crosta, il challenge test ha confermato l’importanza delle operazioni di manipolazione di questi prodotti. Considerando altre tipologie di applicazioni, il challenge test può essere utilizzato per valutare il mantenimento dell’ermeticità delle bottiglie PET utilizzate per il riempimento a caldo di prodotti acidi che ha generato un cambiamento nella conformazione della bottiglia. Per essere sicuri del fatto che questa modi ca dell’imballaggio continuasse a garantire una chiusura ermetica, si è proceduto disegnando un challenge test che prevedesse un contatto del nostro target con il caldo della bottiglia, af nché si potesse valutare se in fase di raffreddamento questo potesse rappresentare un punto critico. In seguito alla simulazione di questo step, successivi punti critici sono stati quelli della movimentazione che le bottiglie possono subire a seguito del riempimento. Una volta che la bottiglia è stata riempita, vengono sovrapposte altre bottiglie e subiscono un carico che in questo caso potrebbe portare all’ingresso di microrganismi.

In un mondo in continua evoluzione, dove la sostenibilità non è solo una scelta, ma una necessità imposta dalle s de ambientali contemporanee, Paperdi presenta la nuova gamma di prodotti in carta tissue riciclata: EcoGreen Plus
Questa linea unisce la sostenibilità della carta EcoGreen con le performance della pura cellulosa, in un perfetto equilibrio tra prestazioni elevate e responsabilità ambientale.
Un progetto teso a ridurre al minimo gli sprechi ottimizzando i processi di recupero e mantenendo un elevato standard qualitativo per prodotti realizzati con carta riciclata al 100% ma, allo stesso tempo, equiparabili alla pura cellulosa per morbidezza, resistenza e grado di bianco.
La gamma EcoGreen Plus è prodotta con materie prime riciclate, provenienti per oltre il 50% da pre-consumo interno e per la restante parte da post consumo riquali cato, per un prodotto sostenibile e al contempo con un elevato grado di bianco grazie a un attento processo di selezione preliminare dei materiali.
Attraverso un modello di approvvigionamento che mira a ottimizzare le risorse locali l’innovativa gamma di casa Paperdi promuove lo sviluppo di un’economia di tipo circolare a KM0, riducendo, al contempo, i consumi associati ai processi di trasporto e movimentazione dei materiali.
Le caratteristiche distintive della linea EcoGreen Plus sono numerose. Innanzitutto, la forti cazione del networking territoriale che permette di promuovere un modello di economia circolare in cui

ogni fase della produzione è pensata per massimizzare l’ef cienza e minimizzare gli sprechi. La linea PLUS mantiene una elevata uniformità, nonostante la variabilità della materia prima, grazie a un’attenta e scrupolosa selezione delle materie di lavorazione: un ulteriore passo verso la valorizzazione del prodotto e una crescente soddisfazione della clientela.
Un approvvigionamento sostenibile, quindi, che consente di ottimizzare l’uso delle risorse disponibili sul territorio attraverso un approccio locale che si traduce in minori emissioni relativamente ai processi di logistica e in una strategia complessiva tesa alla riduzione dell’impatto ambientale.
Attraverso pratiche produttive responsabili, Paperdì opera nel rispetto e nella tutela dell’ambiente, senza compromettere la qualità del prodotto nale.
L’introduzione della linea EcoGreen Plus segna un passo signi cativo nella missione aziendale orientata a fornire la giusta carta per chi la consuma e per il pianeta. Prodotti di alta qualità con un impatto ambientale contenuto dimostrano che è possibile coniugare innovazione, qualità e responsabilità sociale per promuovere uno stile più sostenibile.
Paperdi vi invita a scoprire i vantaggi della nuova linea
EcoGreen Plus dal 27 al 29 maggio a Milano durante la 27esima edizione di Issa Pulire, Padiglione 8 | E39 F46

tecnologo e consulente alimentare igiene alimentarepackaging
L’imballaggio svolge un ruolo primario per preservare la qualità degli alimenti venduti a libero servizio e per proteggerli dalla deperibilità
GIUSEPPE PASTORI
L’evoluzione tecnologica che ha progressivamente interessato il settore del packaging ha favorito la crescita del consumo di prodotti come la carne e i suoi derivati a partire dagli anni ’50 del secolo scorso, quando ha avuto luogo un’importante rivoluzione in ambito commerciale: l’affermarsi di un modello di vendita basato sui supermercati. Le vendite a scaffale hanno preso avvio dai salumi pre-affettati confezionati in buste plastiche sottovuoto (i primi brevetti del sottovuoto a uso alimentare sono proprio degli anni ’50).
Poi l’affermarsi negli anni ’70-’80 della tecnologia con atmosfera modicata – di cui hanno bene ciato soprattutto le carni rosse in porzioni per il consumatore nale – ha contribuito a portare nelle case di tutto il mondo alimenti altrimenti deperibili che potevano essere consumati a distanza di più giorni dall’acquisto.
In questa nuova dinamica, l’imballaggio ha acquisito un’altra importante funzione oltre a quella di proteggere l’alimento: comunicare con i potenziali consumatori per invogliarli alla scelta di questo o quel prodotto anche in base alle speci che attese di ciascuno di noi.
Gli imballaggi nel corso di questi ultimi settant’anni si sono fatti via via più tecnologici. La protezione della deperibilità non si focalizza solo nel controllare e limitare la crescita microbiologica durante la vita a scaffale: nel caso delle carni rosse e dei salumi si è dovuto tenere conto di altri fattori di deterioramento dell’alimento, frutto di un’equazione complessa intrinseca al prodotto stesso. Durante la conservazione, queste specialità si deteriorano a causa dell’ossidazione dei pigmenti (provocati dalla luce o dalla presenza/assenza di ossigeno), dell’ossidazione e dell’irrancidimento, della crescita microbica (i microrganismi intervengono a loro volta nell’accelerare i processi deterioranti in presenza di essudato, modi ca delle condizioni ambientali come il pH e rilascio di enzimi) e persino della disidratazione super ciale. Una corretta progettazione del packaging può certamente contribuire al controllo microbico e, se associata a condizioni di conservazione adeguate, può preservare i prodotti deperibili per molto più tempo rispetto a quelli non confezionati, diventando un elemento chiave per ridurre gli sprechi alimentari.
Diversi tipi di materiali sono stati abbondantemente utilizzati nelle strutture di imballaggio, tra cui il polietilene (PE), il polipropilene (PP), il polietilene tereftalato (PET), l’alcool etilevinilico (EVOH), le poliammidi (PA) e il PVDC, oltre a diversi copolimeri all’interno di tali famiglie di polimeri. Questi materiali proteggono adeguatamente gli alimenti perché sono
scamonesottofiletto fesa
girello sottofesa fiocco noce
pancia petto scaramella fesone di spalla pesce
reale carrè con osso cappello del prete
spalla
Occorre distinguere l’abitudine di confezionare sottovuoto i tagli anatomici praticati dai sezionatori diversamente dai tagli porzionati in unità consumatore.
La tecnica di confezionare sottovuoto intere parti anatomiche nasce sul finire degli anni tali tagli vengono distribuiti ai punti vendita, che provvedono poi a porzionare la carne.
Lo scopo di questa operazione è di contribuire alla maturazione e alla frollatura della carne (soprattutto quella bovina) ed è conosciuta come wet-aging (maturazione in umido).
Ma è solo con l’avvento dell’atmosfera modificata che compaiono sul mercato le vaschette di carne rossa già porzionata in unità consumatore, mentre il sottovuoto si è evoluto poi in sottovuoto skin.
in grado di garantire la sigillatura e una corretta ermeticità, offrono una barriera all’ambiente interno proteggendo adeguatamente gli alimenti, resistono all’abuso dovuto all’impatto meccanico.
CONFEZIONAMENTO SOTTOVUOTO
Con la tecnica del sottovuoto, che consiste nell’eliminazione dell’aria e dell’ossigeno dall’imballaggio, si vuole prevenire il deterioramento degli alimenti, l’ossidazione e la proliferazione dei batteri aerobi. Il confezionamento sottovuoto dei salumi affettati, in buste non termoretraibili, ha diversi vantaggi. In primo luogo, estende la durata di conservazione degli alimenti; ne preserva poi il sapore, il profumo, la freschezza e le proprietà organolettiche. Inoltre, può essere utilizzato sia per i cibi cotti che crudi. In ne, incrementa il livello di igiene rispetto ai prodotti affettati a contatto con l’aria, sempre che venga mantenuto il rigoroso rispetto della catena del freddo. Tuttavia il confezionamento sottovuoto (a parte lo skin che si usa ancora per prodotti di qualità premium o il pesce) per i salumi e i formaggi affettati è stato abbandonato –soprattutto nel nostro paese – a favore del confezionamento in atmosfera modi cata (MAP).

CONFEZIONI SKIN
La tecnologia skin è solo l’ultima evoluzione del sottovuoto introdotta per i prodotti a base di carne di qualità premium come costate e hamburger.
Negli alimenti di alta qualità come carne (compresi hamburger e tagli con osso), salsicce, affettati stagionati e prodotti avicoli, pesce e frutti di mare, formaggi a pasta dura, le necessità di confezionamento sono molteplici: le confezioni skin sono perfette per impedire la fuoriuscita di liquidi o il formarsi di essudato e garantire la protezione da fattori esterni.
La pellicola superiore, saldata su una base rigida termoformata o preformata, scaldata a determinate temperature, avvolge saldamente il prodotto come una seconda pelle (“skin” in inglese), senza tensioni. I prodotti confezionati in skin si possono esporre nel punto vendita in posizione orizzontale, verticale o appesi senza che l’alimento si sposti.
CONFEZIONAMENTO IN MAP
Nel confezionamento in MAP le strutture che compongono il packaging sono state progettate no ad oggi prevalentemente in plastica, costituita da una vaschetta rigida alla base, termoformata a partire da un laminato di spessore adeguato o preformata, e un lm superiore essibile che si sigilla lungo i bordi, dopo che è stata tolta l’aria e sostituita con la miscela di gas. Perché il condizionamento con il gas sia ef cace è richiesto uno spazio di testa più elevato in funzione del volume occupato dal prodotto. I materiali plastici che costituiscono i lm inferiori e superiori sono strutture complesse, che combinano tra loro materiali di diversa natura o con la tecnica del-
la laminazione (la sovrapposizione di più strati mediante adesivi) o con quella più efcace della coestrusione (un procedimento in cui singoli materiali plastici estrusi vengono convogliati insieme nello stesso stampo per produrre una struttura laminare unica prima del raffreddamento). Quest’ultima può inglobare in un’unica matrice anche 7-8 o più elementi di materiali diversi in grado di fornire tutte le caratteristiche necessarie all’imballaggio (proprietà barriera, di permeabilità ai gas, azione anti UV e anti fog ecc.). Si tratta di elementi fondamentali per massimizzare l’estensione della vita utile dei prodotti, fornendo anche un corretto ne vita per il riciclaggio, il riutilizzo o lo smaltimento. L’impiego di tale tecnologia risponde meglio alle esigenze di conservazione e risolve taluni aspetti critici del confezionamento sottovuoto:
1. elimina lo schiacciamento della confezione dovuto alla pressione esterna esercitata per eliminare l’aria e la conseguente “incollatura” delle fette tra loro, rendendo dif cile separarle senza romperle;
2. migliora le caratteristiche batteriostatiche del prodotto all’interno della confezione grazie all’azione della CO2 e quindi aumenta la shelf life. Nei salumi da affettare le miscele di gas sono abitualmente composte da CO2 al 20/30% e N2 all’80/70% (dove l’azoto si comporta come gas inerte, ma impedisce lo schiacciamento della confezione);
3. permette ai tagli di carne rossa fresca di mantenere il colore rosso vivo, per una migliore presentazione. Miscele con l’80% di O2 e il 20% di CO2 associate a temperature di conservazione dell’ordine di 4°C possono conservare la carne fresca no a
7-10 giorni e mantenerne intatto il colore. Tuttavia occorre osservare che anche il confezionamento in atmosfera modi cata non è esente da difetti. La miscela di gas deve avvolgere completamente il prodotto per esercitare la sua azione protettiva e non ci devono essere parti in cui il lm superiore sigillante stia a contatto con il prodotto, perché in quel punto la carne assumerà un colore più scuro. Ne consegue che per evitare un aspetto poco attraente le vaschette devono avere uno spazio di testa più elevato, e quindi gli imballaggi risultano molto più ingombranti.
Nei prodotti trasformati a base di carne, la formulazione è un fattore chiave per la shelf life, a seconda degli ingredienti e dei metodi di conservazione utilizzati (ad esempio, salatura, affumicatura, cottura ecc.). Anche la temperatura di stoccaggio (e di trasporto), in uisce direttamente sul tasso di decomposizione, sulla crescita microbica e sullo sgocciolamento.
Il packaging deve fare la sua parte e sebbene l’ambiente gassoso intorno alla carne, associato alle confezioni sottovuoto e a quelle MAP, è utile per controllare la crescita microbiologica e le reazioni chimiche, i materiali devono essere studiati appositamente allo scopo, impiegando polimeri con proprietà di protezione dalla luce e anti-UV (per l’azione delle lampade che illuminano i banchi frigoriferi) e dalla formazione di condense (proprietà anti fog).
Una corretta progettazione dell’imballaggio, associata a buone pratiche di produzione e a un adeguato stoccaggio, è fondamentale per offrire ai consumatori un prodotto di alta qualità e sicuro.

I tamponcini, le spugnette, i panni e i sovrascarpe Hy Con Check sono dispositivi speci ci per eseguire il campionamento di microrganismi da super ci di lavoro, apparecchiature, carcasse e allevamenti. Le spugnette e i panni possono presentarsi asciutti oppure già umidi cati con soluzioni adatte alle diverse tipologie di super cie, come Neutralizing Buffer, BPW o MRD in conformità ai metodi descritti nelle norme ISO 17604:2015 e ISO 18593:2018.
Sono kit pronti all’uso che non richiedono ulteriori preparazioni: i dispositivi sono sterili e sigillati singolarmente in buste richiudibili o buste adatte alla successiva omogeneizzazione. La confezione singola include anche dei guanti sterili, fondamentali per evitare cross-contaminazioni durante il campionamento. La super cie da esaminare viene delimitata con quadrati sterili monouso (10×10 cm o 5×5 cm), confezionati singolarmente.
Le spugnette e i panni sono utili per super ci ampie e lisce, punti dif cilmente raggiungibili, carcasse, anche per contaminazioni elevate. La spugna viene umettata con soluzione sterile, strisciata uniformemente sulla super cie da esaminare e riposta in un sacchetto sterile con l’aggiunta di terreno di trasporto o diluente, da cui, dopo un passaggio in Stomacher, verrà prelevata un’aliquota da inoculare in piastra Petri. Nel caso di analisi di tipo qualitativo (Salmonella e Listeria) si arricchisce la spugna con un adeguato pre-arricchimento in modo da recuperare le cellule che possono aver subito danni subletali.

TAMPONCINI FLOCCATI
I tamponcini Hy Con Check sono occati e pre-umidi cati con Neutralizing Buffer. Sono confezionati in lm e abbinati a provette contenenti TSB. L’imballaggio può essere triplo per l’utilizzo in clean room. Sono adatti a super ci e lisce, punti dif cilmente raggiungibili, anche per contaminazioni elevate. I tamponi sterili sono inumiditi con soluzione neutralizzante e poi strisciati su una super cie delimitata di 10x10 cm con movimento a zig-zag incrociato. Vengono poi riposti in una provetta contenente soluzione siologica o terreno di trasporto, seminati per inclusione o spatolamento sui terreni desiderati e in ne incubati alla temperatura e per il tempo necessario. Ciò permette di stabilire il numero di UFC presenti e quindi il numero di microrganismi per centimetro quadrato della super cie esaminata
SOVRASCARPE
I sovrascarpe o boot-swabs sono speciali sovrascarpe utilizzati per il campionamento di Salmonella negli allevamenti. I sovrascarpe sono preumidi cati e accompagnati da guanti e bustine per il trasporto, si indossano prima di camminare in allevamento, eseguendo di fatto il campionamento.
igiene

Abbiamo incontrato il responsabile
Sostenibilità e Risorse umane del Gruppo Collis
Heritage, leader nella produzione vitivinicola nel Veneto, per parlare di sostenibilità e pulizia professionale
analizzando l’esperienza di una realtà al vertice di un settore strategico dell’economia italiana
Franco Moretti ci accoglie nella sede del Gruppo Collis Heritage, realtà leader nella produzione vitivinicola del Veneto. Nato dall’alleanza strategica tra alcuni prestigiosi brand del territorio – Sartori di Verona, I Saltari, Casalforte, Mont’Albano, Riondo e Murari – il Gruppo si posiziona oggi tra i principali attori del panorama enologico italiano.
L’incontro avviene nel Comune di Negrar, graziosa cittadina nel cuore della Valpolicella, a pochi chilometri da Verona, nella storica Villa Maria. Dimora settecentesca immersa in un parco di cinque ettari, la villa è da oltre 125 anni il cuore pulsante della Cantina Sartori e ospita attualmente anche Collis Heritage. Le sue antiche fondamenta custodiscono le cantine dedicate alla vini cazione e all’af namento dei grandi vini della Valpolicella. Un luogo che racconta, anche attraverso l’antico vigneto di Corte Bra, la lunga e nobile tradizione vitivinicola di questa terra, celebrata n dai tempi dei Romani e simbolicamente rappresentata dal celebre e raf nato Amarone.
Con il nostro autorevole interlocutore, iniziamo il nostro colloquio partendo da una ri essione generale sulla sostenibilità, termine che richiama molti valori cardine della cultura del pulito. Un obiettivo “s dante” per tutte le aziende del settore vitivinicolo: cosa può dirci al riguardo?
Calcolare il proprio valore di sostenibilità è divenuto essenziale per tanti motivi, a partire dal raggiungimento delle certi cazioni necessarie all’esportazione di alcuni prodotti. Le aziende devono quindi avere la visione reale e aggiornata dell’insieme delle emissioni di gas a effetto serra del ciclo di vita del prodotto. Il Carbon Footprint consente di valutare l’impatto che queste emissioni hanno sui cambiamenti climatici. In particolare, il Water Footprint permette di valutare la cosiddetta impronta idrica, cioè una misura che quanti ca il totale di acqua dolce utilizzata direttamente o indirettamente per produrre beni o servizi da parte di un’azienda. Per il settore vitivinicolo quest’ultima è ancora più importante perché tiene conto non solo dell’acqua consumata direttamente, ad esempio per l’irrigazione dei campi o per l’approvvigionamento idrico, ma considera anche l’acqua impiegata per la produzione di materie prime, la lavorazione industriale, il trasporto e altre attività connesse.
La pulizia e la sani cazione in cantina sono fondamentali per evitare la contaminazione del vino, e garantendo sempre la produzione di un prodotto di alta qualità: con quale

90mio di euro il fatturato
40mio la produzione di bottiglie
70 i Paesi dove è presente
140 i dipendenti
100 gli agenti di vendita
Tra le prime dieci aziende italiane del settore per fatturato crescita dell’export
“ loso a” e mission il Gruppo Collis Heritage ha affrontato il tema dell’igiene?
Igiene signi ca sicurezza a 360 gradi, sia come sicurezza igienica del prodotto per il consumatore nale, come garanzia di alti standard qualitativi dei nostri vini, ma anche in termini di ordine e pulizia degli ambienti di lavoro, presupposto di sicurezza per i lavoratori.
Quanto è importante la pulizia in cantina, non solo per la prevenzione di germi e batteri, ma anche per garantire la massima tutela e qualità dei vini, contro il rischio di alterazioni degli stessi?
Credo che rappresenti senz’altro un prerequisito fondamentale per assicurare al meglio le caratteristiche qualitative ed organolettiche

di un prodotto “vivo” come il vino. Garantire che le attrezzature, gli impianti e gli ambienti lavorativi siano igienicamente sicuri, permette di raggiungere il target qualitativo richiesto per i nostri prodotti, e di tutelarne l’evoluzione nel tempo.
Chi sono, in sostanza le “ gure” preposte, all’interno del vostro Gruppo e delle cantine, alla cura della pulizia e dell’igiene, nell’ambito del processo produttivo e distributivo?
Potrei rispondere, senza tema di smentita, che tutte le persone che lavorano nei processi produttivi, sono attori e garanti della sicurezza igienica dell’azienda. Ovviamente, il loro impatto è tanto più rilevante, nella misura in cui operano sul prodotto prima dell’imbottigliamento, e nella fase di confezionamento no alla tappatura: ma sarebbe errato pensare ad una sola gura come garanzia dell’igiene. Un sistema di sicurezza alimentare è fatto di istruzioni, procedure, registrazioni, controlli, ma soprattutto di persone formate e coinvolte nel delicato lavoro che svolgono.
In particolare, è possibile approfondire il ruolo e i compiti del Responsabile Controllo Qualità e Sicurezza?
La gura corrisponde con il responsabile enologico di Heritage, a testimoniare come qualità e sicurezza siano legati per noi. Inutile sottolineare come entrambe abbiano una grande importanza nell’organizzazione aziendale. Sia nelle realtà non certi cate, che, soprattutto, in quelle dove sia stato adottato un sistema di gestione aziendale, o uno standard alimentare che rispecchia i requisiti delle certi cazioni IFS, e BRC, in nostro possesso.
È FATTO DI ISTRUZIONI, PROCEDURE, REGISTRAZIONI, CONTROLLI,
MA SOPRATTUTTO
DI PERSONE FORMATE E COINVOLTE
NEL DELICATO
CHE SVOLGONO
Come viene selezionato, addestrato e formato il personale preposto ai delicati compiti di sicurezza e pulizia?
Ovviamente la formazione scolastica e l’eventuale percorso lavorativo pregresso in realtà di produzione alimentare sono titoli preferenziali nella scelta di collaboratori a cui è delegato un compito così delicato.
Compito dell’Azienda è poi quello di far crescere il proprio personale, sia con la tradizionale formazione in aula, sia con l’addestramento, ma anche con presa di coscienza da parte di ogni addetto, dell’importanza del suo lavoro, e della condivisione degli obiettivi di sicurezza totale ai quali tendiamo.
Guardando al futuro, quali problematiche e progetti sono al centro della vostra attenzione, in termini di miglioramento di ef cienza e soprattutto di rispetto dell’ambiente?
Sia Collis Veneto Wine Group che Collis Heritage sono certi cate secondo lo standard di sostenibilità Equalitas.
Se il miglioramento, e ne siamo convinti, passa dalla misurazione e dall’oggettiva presa di coscienza del reale livello di ef cienza organizzativa, l’implementazione di questo standard ha ulteriormente accentuato la naturale predisposizione aziendale all’analisi delle performance. Particolarmente s danti sono i requisiti che prevedono, nell’ambito del primo triennio di certi cazione, il calcolo delle impronte carbonica e idrica, sia di organizzazione che di prodotto, che non saranno un punto di arrivo per il Gruppo, ma un nuovo punto di partenza verso l’ef cientamento dei consumi, e una visione ancor più sostenibile della nostra liera.
Nel settore del food, il rischio di contaminazione è sempre in agguato. La pulizia dell’ambiente è la nostra migliore difesa per prevenire questo pericolo. Mantenere standard igienici elevati è indispensabile per garantire la sicurezza di clienti e lavoratori, la salvaguardia della reputazione e per soddisfare i requisiti normativi. Ecco perché af darsi a prodotti professionali è fondamentale. Grazie alla linea HiMiX Professional di Rubino Chem, ottenere una pulizia profonda e sicura diventa un processo semplice ed efcace. Questi detergenti professionali, sviluppati per rispettare ogni tipo di super cie, assicurano prestazioni eccellenti e sono conformi agli standard HACCP. L’attenzione alla qualità rende questa
linea un punto di riferimento per chi desidera offrire ambienti sempre perfettamente igienizzati.
Tra le soluzioni proposte, spicca Protection 24H, un igienizzante arricchito con sali d’ammonio quaternario, capace di rimuovere germi e batteri in modo ef cace. La sua formula innovativa crea una barriera invisibile che garantisce protezione no a 24 ore, risultando ideale per super ci ad alto contatto. Questa caratteristica lo rende un alleato indispensabile per mantenere elevati standard igienici senza la necessità di continue applicazioni.
Per le esigenze più impegnative, Degreaser Food è la soluzione perfetta. Si tratta di uno sgrassatore ultra concentrato ad alta alcalinità, progettato per dissolvere anche lo sporco più ostinato. Agisce in profondità su grassi animali e vegetali, residui carbonizzati e oli, senza corrodere le super ci e senza lasciare aloni, garantendo una pulizia impeccabile.


Quando si tratta di super ci delicate come cristalli, vetro e acciaio, Glass + Inox Food è la scelta ideale. Questo detergente ultra concentrato rimuove con facilità impronte, polvere e residui di grasso, lasciando una pellicola protettiva invisibile che ritarda il ridepositarsi dello sporco. Grazie alla rapida evaporazione, assicura una brillantezza perfetta senza lasciare aloni, valorizzando l’estetica di ogni ambiente con un effetto di pulizia immediato e duraturo.
L’ampia gamma di soluzioni offerte dalla linea HiMiX Professional, unita alla costante ricerca di innovazione e sicurezza, rende questo marchio un punto di riferimento in tutti i settori. L’impegno nella realizzazione di prodotti altamente ef caci conferma la missione di HiMiX Professional: offrire strumenti af dabili per garantire pulizia, igiene e benessere in ogni ambiente, dalle strutture pubbliche agli spazi privati.
CIP ENZIMATICO
• Meno acqua e meno energia
L’uso degli enzimi consente cicli di lavaggio più brevi e a temperature inferiori, con un risparmio concreto di acqua e consumi energetici ridotti.

• Pulizia più mirata e meno aggressiva
Gli enzimi agiscono solo sui residui organici da rimuovere, senza intaccare le superfici né richiedere sostanze chimiche corrosive.
• Maggiore efficacia contro i biofilm
A differenza di molti detergenti tradizionali, gli enzimi riescono a penetrare nella struttura dei biofilm e a acilitarne la rimozione.
• Meno rifiuti pericolosi da smaltire
Essendo di origine naturale, gli enzimi non generano residui tossici e semplificano la gestione delle acque re ue
• Un’opzione sostenibile in sviluppo
Oggi l’uso degli enzimi nel CIP si concentra soprattutto sulla pulizia delle membrane. Ma gli studi promettono nuove applicazioni su scala industriale.
igiene alimentaretendenze
Gli enzimi offrono numerosi vantaggi in termini di consumi di acqua,
temperature operative più basse, tempi di pulizia più brevi e costi inferiori per il trattamento delle acque reflue. È necessaria tuttavia una maggiore
conoscenza relativa ai costi, al controllo del processo, alla riutilizzabilità delle soluzioni enzimatiche e al potenziale di attività residua
STEFANIA MILANELLO
Il CIP (cleaning-in-place) impiega trattamenti termici e sostanze chimiche non biodegradabili (acidi e alcali), che richiedono un’adeguata neutralizzazione prima dello smaltimento, con conseguenti s de di sostenibilità. Inoltre, i bio lm rappresentano una delle principali fonti di contaminazione e deterioramento nelle industrie lattiero-casearie e si ritiene che gli attuali protocolli CIP chimici non li distruggano completamente. L’uso degli enzimi come agenti ef caci per la CIP e come alternativa più sostenibile ai trattamenti chimici e termici sta guadagnando interesse. Gli enzimi offrono numerosi vantaggi se utilizzati per il CIP, come un ridotto consumo di acqua richiesta per il risciacquo, temperature operative più basse con conseguente risparmio energetico, tempi di pulizia più brevi e costi inferiori per il trattamento delle acque re ue. Inoltre, derivano gene-
ralmente da fonti naturali, sono facili da neutralizzare e non producono ri uti pericolosi. Tuttavia, nonostante tali vantaggi, gli enzimi per il CIP nel settore della lavorazione lattiero-casearia continuano a concentrarsi principalmente sulla pulizia delle membrane. Si prevede un’adozione crescente del CIP a base enzimatica per le industrie casearie in attesa di una maggiore conoscenza relativa ai costi, al controllo del processo (cinetica di inattivazione), alla riutilizzabilità delle soluzioni enzimatiche e al potenziale di attività residua, compresi i possibili effetti sui successivi lotti di prodotto. Tali studi sono essenziali af nché l’industria casearia si muova verso soluzioni di pulizia più ef cienti dal punto di vista energetico e sostenibili.
ALTERNATIVA
Gli impatti ambientali primari sulla lavo-
razione del latte e sulla produzione lattiero-casearia sono associati all’elettricità, all’energia termica, all’acqua e ai prodotti per la pulizia, senza considerare gli impatti della produzione di latte. Pertanto, l’utilizzo di enzimi come alternativa agli agenti chimici nel CIP presenta alcuni vantaggi, come la riduzione del potenziale inquinamento causato dai rifiuti chimici e la possibilità di evitare i problemi associati alla natura corrosiva degli agenti chimici. Anche la rimozione di bio lm può trarre giovamento dall’utilizzo di preparati a base di enzimi, in combinazione con biocidi. I processi CIP utilizzati regolarmente nell’industria lattiero-casearia mostrano, infatti, risultati variabili contro i bio lm a causa della resistenza ai trattamenti chimici e sici.
Gli enzimi possono essere utilizzati per abbattere i depositi organici sulle super -
ci di lavorazione, riducendo la necessità di prodotti chimici aggressivi e migliorando la sostenibilità. Il CIP mediante una combinazione di enzimi e disinfezione chimica a base acida ha dimostrato di avere il più basso impatto ambientale e potenziale di acidi cazione in una LCA delle procedure di pulizia utilizzate nelle industrie lattiero-casearie, compreso l’utilizzo di energia e acqua. Ulteriori vantaggi derivanti dall’utilizzo degli enzimi per il CIP includono la minore manipolazione di prodotti chimici detergenti corrosivi e pericolosi da parte dei lavoratori e la riduzione dello stress chimico e termico sulle apparecchiature di lavorazione. Gli studi si stanno focalizzando sull’ottimizzazione della dose di enzimi, del controllo del processo e dei costi. Le proteasi si sono dimostrate utili nel CIP in vari settori ma, per livelli di ef cacia più elevati, diversi studi suggeriscono l’integrazione con una miscela di altri enzimi, l’aggiunta di tensioattivi o l’implementazione di una fase di pulizia aggiuntiva. Studiando approfonditamente parametri quali gli impianti di lavorazione, le metodologie di produzione, il tipo di prodotto alimentare e i rischi speci ci dell’attività enzimatica residua sui prodotti alimentari, la pulizia enzimatica ha un grande potenziale per essere utilizzata per il CIP in combinazione con i metodi di sani cazione tradizionali per migliorare l’igiene delle piante.
AGENTI PER LA RIMOZIONE
DEL BIOFILM
Gli enzimi potrebbero essere utilizzati anche come soluzione alla resistenza del bio lm ad alcuni agenti chimici, in sostituzione o in combinazione con questi. La complessità della composizione dell’EPS nei bio lm può variare tra le specie batteriche. Gli enzimi possono degradare i componenti della matrice dell’EPS nei bio lm, il che facilita l’inattivazione e la rimozione delle cellule staccate durante le procedure di pulizia e disinfezione industriale. Recenti studi su preparati a base di enzimi

NEI PROCESSI
INDUSTRIALI. L’USO
DI ENZIMI NEI CICLI
CIP RIDUCE CONSUMI
E IMPATTO AMBIENTALE,
MIGLIORANDO
L’EFFICACIA ANCHE
CONTRO I BIOFILM,
TRA LE PRINCIPALI FONTI
DI CONTAMINAZIONE
hanno dimostrato risultati promettenti per la rimozione dei bio lm microbici formati su varie super ci. Talvolta gli enzimi stessi potrebbero non essere in grado di eliminare i bio lm, ma piuttosto consentire l’ingresso del disinfettante nella matrice del biolm. Gli enzimi funzionano prendendo di mira la matrice dei bio lm, allentandola per innescare il rilascio di cellule planctoniche; questo aiuta gli agenti disinfettanti standard a raggiungere le loro cellule bersaglio planctoniche. Alcuni dei vantaggi dell’utilizzo degli enzimi per degradare
i bio lm sono la loro elevata speci cità e velocità di reazione rapida in condizioni moderate di temperatura, pH e concentrazione. È stato dimostrato che una combinazione di ossidoreduttasi con enzimi idrolizzanti i polisaccaridi agisce ef cacemente contro bio lm modello di organismi patogeni come Staphylococcus epidermidis, Pseudomonas aeruginosa, S. aureus e Pseudomonas uorescens su super ci in polipropilene e acciaio, come confermato mediante microscopia a uorescenza e un’analisi indiretta test di conduttanza o test delle emissioni di anidride carbonica. Tuttavia, gli enzimi sono stati ampiamente studiati come strategia antibio lm nei biofilm monospecie, ma i biofilm misti sono più comuni negli ambienti reali. Uno studio ha valutato l’ef cacia di nove preparazioni enzimatiche commerciali nel trattamento di sette tipi di bio lm a doppia specie contenenti L. monocytogenes e batteri associati provenienti da impianti di trasformazione alimentare. Lo studio ha rilevato che i ceppi di L. monocytogenes erano ugualmente suscettibili all’attacco enzimatico nei bio lm giovani sia mono che bispecie, ma l’effetto dell’associazione è stato bene co per alcuni dei suoi partner come E. coli e S. saprophyticus. Sebbene l’uso di enzimi non abbia ottenuto buoni risultati in termini di riduzioni del registro delle cellule vitali attaccate nei bio lm a doppia specie, le immagini al microscopio confocale a scansione laser (CLSM) hanno mostrato un danno strutturale signi cativo dopo il trattamento enzimatico con DNasi I, pronasi e pectinasi. Gli enzimi potrebbero essere uno strumento utile per indebolire la struttura dei bio lm sulle super ci degli impianti di trasformazione alimentare, in combinazione con un trattamento di disinfezione, e possono essere utilizzati per sondare la struttura esterna o accessibile del bio lm. Le classi di enzimi con il maggior potenziale che possono essere utilizzate per l’eliminazione del bio lm sono cellulasi, proteasi, amilasi, lipasi o DNasi. In par-
ticolare, considerando che le proteine sono il componente strutturale più vitale, soprattutto nella matrice dei bio lm dei latticini, le proteasi sono considerate gli enzimi più potenziali contro i bio lm. Questi enzimi legano e idrolizzano le molecole proteiche e le convertono in unità più piccole che escono attraverso la membrana cellulare e vengono metabolizzate. Studi suggeriscono che la proteasi funziona in maniera più ottimale in modo indipendente, richiedendo quindi un ritardo nel suo rilascio per consentire agli enzimi che degradano i polisaccaridi di funzionare. Sebbene questi enzimi siano parzialmente in grado di degradare i bio lm da soli, la combinazione degli enzimi di degradazione dei polisaccaridi riduce signi cativamente le cellule del bio lm. Alcuni studi hanno valutato l’attività delle cellulasi contro i bio lm. Questi enzimi danneggiano la cellulosa che è uno dei componenti principali dei bio lm. I tre gruppi di cellulasi che possono distruggere la cellulosa sono esoglucanasi, endoglucanasi e β-glucosidasi. Il bersaglio principale delle cellulasi sono i legami α-1,4 nella struttura della cellulosa. Le cellulasi si sono dimostrate particolarmente ef caci nell’inibizione dei ceppi ad alto contenuto di polisaccaridi. Anche in questo caso, gli studi raccomandano una combinazione di cellulasi con altri enzimi per aumentare l’ef cacia della boni ca del bio lm. Il gruppo di enzimi più studiato nelle procedure di pulizia enzimatica sono le amilasi. La glucoside amilasi e l’α-amilasi rappresentano il 25% del mercato globale della pulizia enzimatica. Le amilasi idrolizzano i legami α-1,4-glicosidici nelle strutture dei bio lm provocandone la rottura. Diversi studi hanno studiato l’effetto dell’α-amilasi e della cellulasi in combinazione contro i bio lm provando una signi cativa riduzione della biomassa del bio lm a causa della rottura dei legami glicosidici nella matrice EPS e della dispersione e del rilascio di batteri planctonici, aumentando così l’efcacia dei successivi trattamenti antibiotici.
Anche i lipidi sono un componente importante della struttura dell’EPS nei bio lm e contribuiscono alla struttura e alla stabilità dei bio lm batterici e formano il doppio strato lipidico delle membrane batteriche. Di conseguenza, le lipasi hanno un alto potenziale per la distruzione dei bio lm. Il DNA extracellulare (eDNA) è un altro componente importante dei bio lm poiché facilita l’adesione, il trasferimento genico e l’aggregazione dei batteri e funge da impalcatura strutturale per loro. L’uso delle DNasi potrebbe rivelarsi uno strumento efcace contro i bio lm. Tuttavia, in diversi studi si fa notare che la degradazione dei bio lm da parte della DNasi dipende dalla maturità dei bio lm; i bio lm giovani sono principalmente suscettibili al trattamento con DNasi, mentre man mano che il biolm invecchia, la suscettibilità alla DNasi diminuisce.
APPLICAZIONI
DELLA PULIZIA ENZIMATICA
Poiché sono state condotte poche ricerche sull’ef cacia e la fattibilità del CIP enzimatico nel settore lattiero-caseario, gli enzimi sono attualmente utilizzati prevalentemente nella pulizia delle membrane. Anche se studi di laboratorio e su scala pilota hanno rivelato un grande potenziale negli enzimi come agenti CIP, sono necessarie maggiori informazioni per la loro applicazione, in particolare nell’industria casearia. Le proteasi sono gli enzimi più studiati poiché sono ef caci nella rimozione dei depositi proteici formati negli impianti lattiero-caseari e aiutano anche a rimuovere lo strato EPS dei bio lm. La pulizia enzimatica è interessante come agente igienizzante efcace per l’industria casearia e lattiero-casearia in generale, con vantaggi come una maggiore sostenibilità, tra cui una migliore gestione/biodegradabilità dei ri uti, uso di energia e acqua e relativi costi economici rispetto al CIP tradizionale. Altri vantaggi includono processi CIP speci ci del substrato, la possibilità di rottura mirata dei
BIOFILM
Strato invisibile e tenace composto da batteri e residui organici. Si forma su pareti e tubazioni, resiste ai detergenti comuni e può contaminare i prodotti.
CIP (Cleaning-in-place)
Sistema che pulisce automaticamente tubazioni e impianti senza smontaggio. È usato per mantenere l’igiene nei processi industriali, come quello lattiero-caseario.
ENZIMI
Molecole naturali che attaccano lo sporco organico (proteine, grassi, zuccheri). Permettono cicli di pulizia più rapidi, a basse temperature, con meno sostanze chimiche.
EPS
la colla del biofilm una matrice gelatinosa che contiene proteine, zuccheri, grassi e DNA. Protegge i batteri rendendo la pulizia più complessa.
INATTIVAZIONE ENZIMATICA
ase finale gli enzimi usati nella pulizia vengono disattivati per evitare interferenze con le fasi successive della lavorazione.
PROTEASI – AMILASI – LIPASI –CELLULASI – DNASI
Cinque gruppi di enzimi specializzati, ciascuno contro un tipo di sporco roteasi proteine milasi amidi e zuccheri ipasi grassi ellulasi cellulosa asi dei biofilm
bio lm per l’ingresso di disinfettanti e così via. Prima di poter stabilire protocolli CIP enzimatici nell’industria casearia, è necessario considerare i costi, il potenziale di riutilizzo, l’impatto dell’attività enzimatica residua sui prodotti successivi e l’inattivazione/rimozione degli enzimi dopo l’uso.
Pest Control
igiene alimentaredisinfestastorie

LO ZUZZURELLONE
Un ragazzo già grande e grosso che si trastulla tuttavia come un bambino. Dal Novissimo dizionario della lingua italiana (quindicesima edizione -1954, casa editrice Ceschina, Milano), per la precisione è corretto anche dire “zuzzerellone”.
(Di fatto è l’ultima parola dei dizionari di italiano).
Parliamo di biodiversità, ecologia e sostenibilità nella realizzazione dei nostri protocolli di difesa antiparassitaria


Per essere metodologicamente corretto - almeno nelle intenzioni - iniziamo dalle de nizioni. Per biodiversità le cose si complicano perché il termine può riferirsi sia alla variabilità morfologica, siologica e genetica di individui della stessa specie soprattutto in relazione alle condizioni ambientali (clima, nutrienti, ecc.) sia alla coesistenza in uno stesso ambiente (ecosistema) di diverse specie di esseri viventi in un equilibrio che sappiamo essere dinamico. Ecco affacciarsi l’ecologia che analizza i rapporti fra





l’ambiente e gli esseri viventi. Per la sostenibilità mi riservo di affrontare l’argomento come conclusione di queste zuzzurellesche riflessioni. Per ora mi preme sottolineare che per quanto mi riguarda l’ecologia essa è una radiogra a dei rapporti fra gli esseri viventi di un dato territorio e le sue condizioni ambientali. Da cui deriva che la radiogra a non trae conclusioni, fotografa una realtà. Le considerazioni, le deduzioni e le eventuali terapie, se ritenute necessarie, sono da rimandare ad altre branche dello scibile umano. Ne derivano alcuni punti critici come la qualità della radiogra a e la competenza di chi leggendola si assume la responsabilità di esprimere delle opinioni, considerazioni, terapie e prognosi più o meno catastro che (§).
Riporto come dato pertinente, la consistenza della popolazione della penisola italica del XVI secolo stimandola, come riporta la letteratura, in ≈ 13 milioni di abitanti. Tre volte meno della popolazione di Tokyo (≈37 milioni che è più o meno la popolazione italiana del 1912). Teniamo conto che le città di Roma, Milano e Napoli assommano a più di un terzo dell’intera popolazione dell’Italia della ne del 1500! Attualmente l’Italia conta poco meno di 59 milioni di abitanti come dire la popolazione di Tokyo e Città del Capo insieme, e se consideriamo che la super cie del sacro suolo nazionale e di 302.073 km2 mentre quella delle due megalopoli è di 4.640 km2 (Tokyo = 2.194 km2 e Città del Capo = 2.446 km2) signi ca che su ≈ l’1,54% della super cie dell’Italia coesisterebbe lo stesso numero di abitanti. Già siamo stretti noi, guriamoci loro.
Ora parlare di biodiversità, ecologia e magari anche sostenibilità del territorio italiano e delle due megalopoli rispettivamente giapponese e messicana, con gli stessi criteri valutativi, a parer mio, rasenta una incompatibilità metodologica.
Mi chiedo, tra l’altro, quali siano i proble-
Evento negativo che si manifesta improvvisamente con conseguenze irreversibili.
Se si accetta questa definizione per buona, mi pare che gli orizzonti scientifici stiano analizzando i mutamenti con attenzione e le scoperte tecnologiche siano di buon auspicio per soluzioni sempre più attente a salvaguardare la biodiversità, con terapie ecologicamente sostenibili…
Ho usato un termine di cui non padroneggio il significato, ma cosa ci si può aspettare da uno zuzzurellone!
mi igienico-sanitari e di lotta antiparassitaria nella Città del Capo e quali gli slogan dialettici delle ditte di disinfestazione che operano nella capitale messicana e magari compararli con i PCO nipponici e italiani.
Per inoltrarci nella sostenibilità esaminiamo quanto accade in una mega realizzazione nata nel Nevada, la “Las Vegas Sphere”. Esaminiamo quindi, a volo radente, i dati sui consumi energetici che i suoi 160.000 metri quadrati di schermi LED e il sistema audio da 157.000 altoparlanti richiedono. La quantità di energia per un luogo di intrattenimento si stima aggirarsi intorno a 95.779 megawatt, pari ai consumi di una piccola città.
Va aggiunto che tale consumo di energia genera circa 46.835 tonnellate di CO2 all’anno, equivalenti alle emissioni di circa 10.000 automobili. Sbalorditivo!
Tutto questo panegirico per sottolineare che parlare di biodiversità, ecologia e sostenibilità necessita di inserire le proprie ri essioni in assi cartesiane ben de nite, anche nella realizzazione dei nostri protocolli di difesa antiparassitaria. Una cosa è parlare di bio-




diversità di una città con le problematiche di entità biologiche infestanti altra cosa è analizzarla in una monocoltura agricola o addirittura in un’area protetta di un parco. Infatti, è mia convinzione, che gli aspetti di sicurezza ecologica rivolta soprattutto agli aspetti igienico-sanitari in un presidio ospedaliero poco o nulla abbiano in comune ad esempio con il Parco del Ticino. Fermo rimanendo che ogni biotopo debba vedersela con le zoonosi veicolate dalle zanzare e dall’invasione delle specie aliene. Per concludere o quantomeno tirare le somme di questi dati che dovrebbero aiutarci a razionalizzare le nostre ri essioni direi che dobbiamo tornare alle de nizioni. La valutazione della biodiversità in fondo si basa su indagini naturalistiche certamente complesse, ma con le giuste competenze possibili. L’ecologia se viene focalizzata ai rapporti fra gli esseri viventi e l’ambiente senza entrare nelle derivate terapeutiche, sia pure su livelli di complessità superiore, può fornire dati attendibili. Ma la sostenibilità, a mio giudizio, si basa su una dialettica sfuggente e superiore alla mia capacità critica. Per cui mi limito a riportarne alcune de nizioni tratte da Internet:
• Possibilità di essere mantenuto o protratto con sollecitudine e impegno o di essere difeso e convalidato con argomenti probanti e persuasivi.
• La possibilità di essere sopportato, specialmente dal punto di vista ecologico e sociale ad es. “sostenibilità dello sviluppo economico”.
Come far convivere tutto questo con le necessità professionali, aziendali e familiari è decisamente arduo anche perché, inutile nasconderselo, sembra che la crisi, le norme, la burocrazia e il millantato credito, ognuno per proprio conto, convergano a complicarci la vita.



Da oltre 40 anni, Copyr è un punto di riferimento nel settore dell’erogazione automatizzata, offrendo soluzioni avanzate per migliorare la qualità degli ambienti e preservare la salute delle persone. Il settore Horeca, dove è forte la presenza di ambienti sensibili, è sicuramente uno di quelli dove l’erogazione automatizzata trova largo utilizzo. L’innovazione di Copyr si concentra su due aspetti fondamentali: la deodorazione degli ambienti e il controllo degli insetti volanti, garantendo soluzioni ef caci e su misura per ogni esigenza. Due sono i sistemi di erogazione automatizzata: Copyrmatic® e Dose Spray™.
Al cuore del sistema Copyrmatic® si trova un erogatore automatico che nelle diverse declinazioni di modelli consente la distribuzione di prodotto, che sia insetticida o deodorante, temporizzata e senza la necessità di alcuna operatività da parte di addetti specializzati. Il suo design elegante e discreto, oltre alla sua estrema silenziosità, permette l’inserimento di Copyrmatic® in qualsiasi ambiente.
Parte importante del sistema sono le bombole insetticide contro gli insetti volanti, come mosche e zanzare. Infatti, insetti come le mosche oltre ad arrecare fastidio, possono compromettere l’igiene e la sicurezza alimentare. L’offerta di bombole insetticide è ampia e risponde alle diverse necessità di utilizzo grazie alle diverse formulazioni. Kenyasafe Extra, Kenyasafe PY Plus, Pyrematic e Kenyatrin Safe contengono estratto di Piretro, una sostanza insetticida di
derivazione vegetale: viene infatti estratta dai capolini essiccati del Chrysanthemum cinerariaefolium, una pianta simile a una comune margherita.
Copyrmatic® può essere utilizzato anche con bombole deodoranti. La linea Fresh Air, composta da sei fragranze professionali per la deodorazione di ambienti no a 100 metri cubi: Agrumi, Lime, Muschio Bianco, Lavanda, Vaniglia e Zenzero, Talco. Ogni bombola garantisce no a 3.000 erogazioni, migliorando la percezione degli ambienti e offrendo un’esperienza sensoriale di qualità.
A completare l’offerta Copyr arriva Dose Spray™, l’ultima evoluzione nei sistemi automatizzati ad alte prestazioni. Il dispositivo si distingue per versatilità, precisione e durata, grazie all’innovativa micro-elettrovalvola solenoide che regola l’erogazione con tre livelli d’intensità (minima, media, massima), riducendo gli sprechi e migliorando l’ef cacia.
Compatibile con bombolette da 250 e 400 ml, Dose Spray™ riduce la frequenza di sostituzione e offre un controllo avanzato con tre modalità (giorno, notte, 24h) e intervalli regolabili (ogni 7, 5, 15 o 30 minuti). È dotato di sistema di blocco delle bombolette, indicatore luminoso e design moderno, perfetto per qualsiasi ambiente come hotel, ristoranti e aree di pregio.
Dose Spray ™ è ideale per l’erogazione automatica di insetticidi, deodoranti ambientali e disinfettanti, adattandosi con versatilità a piccoli, medi e grandi ambienti.



C P e o nat ale
C P e o nat ale



















































Questi artropodi rappresentano
un rischio emergente per la qualità e la sicurezza degli alimenti stoccati. Per combatterli è necessario adottare un approccio che coinvolga pulizia, disinfezione e prevenzione

Gli acari delle derrate rappresentano una delle criticità più sottovalutate nell’ambito della sicurezza e conservazione alimentare, specialmente in ambienti ad alto rischio come mulini, pasti ci, pani ci, depositi di cereali, mangimi ci e industrie di trasformazione. Sebbene invisibili a occhio nudo, questi artropodi possono compromettere in modo signi cativo la qualità igienico-sanitaria delle materie prime e dei prodotti niti, con ripercussioni sul piano economico, normativo e sanitario.
Sono diverse le principali specie di interesse igienico-sanitario che infestano le derrate alimentari, perchè il sempre maggior ricorso allo stoccaggio di derrate o alla lavorazione di ingenti quantità di alimenti ha portato nel tempo ad un incremento del numero delle specie di acari coinvolte nelle infestazioni. Gli acari infestanti delle derrate in generale misurano circa 200-300 micron e non possono quindi essere visti ad occhio nudo, ma soltanto al microscopio.
Gli acari sono tofagi, micofagi o detriti-
vori e possono compromettere l’integrità di cereali (frumento, mais, avena, orzo), farine, semole, amidi, mangimi zootecnici e alimenti composti, frutta secca, semi oleosi, derivati caseari, spezie. I danni diretti comprendono la degradazione organolettica dei prodotti a causa di odore sgradevole, gusto rancido, presenza di escrementi, perdita di massa e valore commerciale, sviluppo secondario di microrganismi (es. muffe) dovuto all’attività tro ca degli acari. I danni indiretti includono problemi di salute occupazionale (asma, dermatiti, allergie respiratorie), contaminazioni crociate (es. trasporto meccanico di muffe o spore), reazioni avverse nei consumatori (specialmente nei soggetti allergici).
STRATEGIE DI LOTTA
Un piano ef cace di controllo degli acari richiede l’approccio IPM (Integrated Pest Management), che prevede l’integrazione di strumenti chimici, sici, ambientali e procedurali. Le fasi principali includono un sopralluogo tecnico ispettivo con verica di ambienti critici (intercapedini, silos,
zone morte), la raccolta di campioni da lotti sospetti e super ci, seguita da analisi microscopica, e la mappatura delle aree infestate mediante check-list e trappole collanti (opzionale per acari).
Si procede quindi applicando delle azioni correttive ambientali che comprendono la deumidi cazione, un’azione prioritaria nei magazzini, che ha lo scopo di abbassare l’umidità relativa a un valore inferiore al 55%. Si procede poi con ventilazione forzata e rimozione della condensa.
L’igiene è fondamentale per prevenire e combattere le infestazioni da acari. Farine residue, polveri organiche e accumuli vanno asportati tramite aspiratori industriali con ltri HEPA.
Dove è possibile, le super ci vanno frequentemente pulite con detergenti appositi e disinfettate con prodotti a base di alcoli o perossidi, per evitare che restino residui tossici. Trattamenti specifici contro gli acari sono i termotrattamenti ambientali (50 - 60 °C per 24 - 48 h) con sistemi a generazione d’aria calda, criotrattamenti localizzati con azoto liquido o ghiaccio
siro
(Linnaeus, 1758) è tra le specie più comuni, predilige ambienti con umidità relativa (UR) > 65% e temperature comprese tra 17 - 30 °C. Particolarmente presente in farine, cereali, semi oleosi e mangimi.
(Schrank, 1781) è una specie fungina-polifaga, associata a prodotti proteici e lipidici (prodotti caseari, frutta secca, spezie, carne secca). Predilige condizioni con UR >85%. Può svilupparsi anche in presenza di muffe o substrati in decomposizione. È l’acaro più dannoso per le derrate conservate.
Lepidoglyphus destructor
(Schrank, 1781) è un acaro tipico degli ambienti zootecnici e depositi di mangimi. Tollerante all’umidità, è un noto allergene occupazionale, cioè un organismo che può causare reazioni allergiche nei lavoratori durante l’attività lavorativa.
Glycyphagus domesticus
(De Geer, 1778) è un Infestante secondario di magazzini umidi e strutture con problemi di risalita capillare o condensa. Attacca cereali, carta e legno ammu to

secco per ambienti ridotti, uso di atmosfere modi cate (CO2/azoto) per silos, bulk o ambienti chiusi.
L’utilizzo degli acaricidi è consentito solo in aree non a contatto diretto con alimenti. I principi attivi ammessi sono le piretrine naturali (ef caci ma fotosensibili) e i piretroidi sintetici (es. permethrin, deltamethrin, previa autorizzazione e rispetto dei Limiti Massimi di Residuo).
PREVENZIONE
Le pratiche preventive sono incluse nel Piano di Autocontrollo HACCP e nel Piano IPM aziendale. Le best practices includono i controlli in accettazione delle derrate (ispezione visiva e campionamento analitico), lo stoccaggio corretto su pallet distanziati da pareti/pavimento in contenitori chiusi, la rotazione dei lotti (FIFO) e il monitoraggio delle scadenze, la manutenzione degli impianti, la formazione periodica del personale sulla rilevazione di segni indiretti (odori, residui polverosi, anomalie nelle confezioni).
Il controllo degli acari delle derrate non
Acarus siro
Tyrophagus putrescentiae
Lepidoglyphus destructor
Glycyphagus domesticus
Temp. tra 17 - 30 °C e UR > 65% 9 –11 giorniFrumento e farina
Temp. superiore a 30°C e UR > 85% 10 - 27 giorni
Derrate ad alta percentuale di grassi e proteine (insaccati in genere, formaggi, farine di carne)
Temp. tra 20 °C - 30 °C e UR tra il 65% e l'80% 10 - 21 giorniCereali, mangime
Temp. tra 23 °C e UR 80 - 90% 3 settimane Frumento, farine, zucchero, formaggio
può essere af dato a misure generiche o reattive. È necessaria una strategia integrata, preventiva, conforme agli standard BRC, IFS e alla normativa CE 852/2004. L’intervento tempestivo di professionisti del pest
Fonte: disinfestanti.it
management, combinato con un piano di controllo interno solido e aggiornato, rappresenta la garanzia più ef cace per la tutela del prodotto e la protezione del brand aziendale.

Nel settore Horeca, l’igiene è una priorità assoluta e la presenza di insetti striscianti e volanti compromette non solo la sicurezza degli alimenti, la salubrità degli ambienti e soprattutto la reputazione di aziendale. Azamet 10 EC rappresenta una soluzione ef cace e af dabile per il controllo di infestanti come cimici dei letti, scarafaggi, formiche, mosche, zanzare e vespe. Si tratta di un insetticida concentrato emulsionabile a base di azametifos, appartenente alla famiglia degli organofosforici, con un’azione abbattente immediata e una persistenza prolungata. Unico nel suo genere la sua efcacia è testimoniata da risultati concreti: la mortalità delle zanzare avviene in pochi minuti dall’applicazione, mentre per scarafaggi, cimici dei letti, mosche e formiche il trattamento elimina gli infestanti entro 24 ore. Applicato in nebulizzazione, mantiene la sua azione residuale per sei settimane, garantendo una protezione duratura.
Di particolare attualità risulta il proliferarsi del fenomeno di infestazioni da cimice dei letti. Sul mercato non solo non esistono molto prodotti biocidi autorizzati per tale uso, ma tanto meno soluzioni ef caci in grado di controllarle. Tuttavia, Azamet è in grado di apportare un eccellente contrasto a questi sgraditi infestanti e si inserisce perfettamente in protocolli I.P.M. (Integrated Pest Management).
Per ottenere il massimo risultato, è fondamentale applicare il prodotto nelle giuste diluizioni. A seconda del tipo di infestante, il trattamento varia: per gli scarafaggi si consiglia di spruzzare direttamente nelle crepe e fessure, per le cimici dei letti è necessario trattare mobili infestati, sotto e intorno alla struttura letto evitando

la biancheria, mentre per le zanzare l’applicazione è indicata intorno alle fonti di luce, letti e tende. Le formiche vanno trattate direttamente all’entrata del nido e nell’area circostante, utilizzando circa 50 ml di prodotto per nido. Per la massima ef cacia, si consiglia di chiudere gli ambienti trattati per 4-6 ore e poi ventilare adeguatamente prima di rioccuparli.
È consigliato preparare la soluzione diluita e utilizzarla subito, evitando di lavare le super ci trattate per non ridurne l’ef cacia.
TRATTAMENTI CON NEBBIOGENI
Per trattare ambienti no a 1.000 m3 è suf ciente utilizzare 100 mL di prodotto. Questo metodo è particolarmente indicato per il controllo di zanzare, mosche e vespe. Prima della nebulizzazione, è essenziale rimuovere persone, animali (inclusi i pesci) e piante sensibili dall’area da trattare. Occorre chiudere porte e nestre che danno verso l’esterno, mentre è consigliato aprire quelle interne, incluse ante di armadi e mobili, per consentire una diffusione uniforme del prodotto. Durante l’applicazione non deve essere presente nessuno nei locali. Una volta conclusa la nebulizzazione, è necessario lasciare agire il prodotto in ambiente chiuso per almeno 2 ore. Per risultati ottimali, si consiglia un tempo di contatto di 4 ore. Al termine, prima di accedere nuovamente ai locali, è importante ventilare adeguatamente aprendo nestre e porte esterne per almeno 10-15 minuti.
Grazie alla sua ef cacia e lunga durata, Azamet 10 EC si conferma come una soluzione ideale per il controllo degli infestanti nel settore Horeca, garantendo ambienti sicuri e protetti.

















igiene alimentare
I sistemi digitali per il monitoraggio e la gestione dei roditori si stanno dimostrando particolarmente efficaci e l’integrazione con l’IoT
offre numerosi benefici in termini di efficienza e sostenibilità
FRANCESCO NICASSIO
dottore forestale esperto in gestione integrata degli infestanti
Negli ultimi anni, l’innovazione tecnologica sta sempre più trasformando le nostre case, i nostri mezzi di trasporto ed in generale le nostre vite. Alcune tecnologie, come gli smartphone con le loro app, hanno cambiato il nostro modo di vivere e relazionarci con gli altri in maniera talmente rilevante, che non sapremmo più immaginare la nostra vita senza la possibilità di essere costantemente connessi e informati. Internet ha rivoluzionato la nostra esistenza, non solo sul piano lavorativo, ma anche con riguardo alle relazioni familiari e amicali; corrisponde, a tutti gli effetti, ad uno strumento di uso comune e ci consente di essere connessi con oggetti inanimati e ricevere da loro, su tutto ciò che accade, un numero di informazioni quanto mai vasto, per la cui gestione sono necessari potenti computer e idonei software gestionali. Questa rete di dispositivi fisici, veicoli, elettrodomestici e altri oggetti dotati di sensori, software e altre tecnologie, sempre connessi tra di loro, si chiama Internet delle Cose (IoT).
L’obiettivo che si intende realizzare è la
connettività: gli oggetti sono collegati a Internet e possono comunicare tra loro, e con altri dispositivi, tramite sensori che raccolgono dati dall’ambiente circostante, come ad esempio temperatura, umidità, movimento. Scopo ultimo è l’automazione dei processi, in modo da ridurre l’intervento umano e aumentare l’ef cienza. Alcune tra le più comuni applicazioni dell’IoT sono nei campi dell’industria 4.0, dei dispositivi medici, dell’agricoltura.
Negli ultimi anni, anche il campo del pest management è stato oggetto di un’evoluzione signi cativa grazie all’introduzione di tecnologie digitali avanzate. Tra queste innovazioni, i sistemi digitali per il monitoraggio e la gestione dei roditori si sono dimostrati particolarmente ef caci. L’integrazione con l’IoT ha ulteriormente potenziato queste soluzioni, offrendo numerosi bene ci in termini di ef cienza e sostenibilità.
Tradizionalmente, il controllo dei roditori si basava su metodi manuali, come l’u-
so di trappole siche e l’ispezione visiva. Tuttavia, questi metodi spesso si rivelano inef caci e richiedono un notevole impiego di tempo e risorse. I sistemi digitali di monitoraggio, invece, utilizzano sensori avanzati e tecnologie di rilevamento per identicare la presenza di roditori in tempo reale. L’IoT ha rivoluzionato il pest management, permettendo la creazione di reti di dispositivi interconnessi che comunicano tra loro. Nel contesto della gestione dei roditori, l’IoT consente di monitorare costantemente le aree a rischio e di ricevere aggiornamenti immediati tramite applicazioni mobili o piattaforme online. Ad esempio, i sensori di movimento e i dispositivi di rilevamento possono essere posizionati strategicamente per rilevare l’attività dei roditori e inviare noti che ai responsabili del controllo. Tale possibilità di rilevare immediatamente la cattura di un roditore, o semplicemente il passaggio dello stesso, ci offre la possibilità di ridurre drasticamente i tempi di risposta e, quindi, di minimizzare i danni.
I bene ci non si limitano solo a questo, ma consentono la piena ottimizzazione delle ri-




Questi sistemi comprendono:
• trappole intelligenti dotate di sensori e tecnologie wireless che rilevano la cattura di roditori. Le trappole sono in grado di inviare noti che in tempo reale agli operatori, indicando esattamente la posizione in cui si è veri cato l’intervento, riducendo il tempo necessario per ispezioni manuali;

sorse. Grazie ai dati raccolti dai sensori IoT è possibile, per esempio, ottimizzare l’uso di trappole ed esche, che possono essere posizionate solo dove risulta necessario. L’uso di tecnologie digitali riduce inoltre la necessità di ispezioni manuali frequenti, abbassando i costi operativi a lungo termine. I dati raccolti consentono anche di personalizzare le soluzioni, ovvero le strategie di controllo in base alle speci che esigenze e caratteristiche dell’ambiente da monitorare.
I potenziali benefici interessano anche la tutela dell’ambiente e l’operatività in chiave sostenibile. La riduzione dell’uso di derattizzanti chimici, data la possibilità di limitare l’uso di veleni, mitiga l’impatto ambientale e permette di salvaguardare la salute umana.
L’integrazione con l’IoT permette un monitoraggio continuo e non invasivo, riducendo la necessità di interventi frequenti. Gli operatori possono recarsi meno volte sul posto riducendo gli spostamenti, i tempi morti e i tempi di lavorazione.
La diminuzione delle fasi del lavoro, come l’apertura delle stazioni di monitoraggio, la sostituzione delle esche e la compilazione di report di monitoraggio, permette di utilizzare meno materiali.
Inoltre queste operazioni, per loro natura ripetitive, vengono spesso effettuate dall’operatore automaticamente e con poca attenzione e la loro diminuzione consente di abbassare il margine di errore.
Le soluzioni digitali aiutano a preservare la biodiversità, poiché consentono un controllo mirato dei roditori senza danneggiare altre specie non target. In ne, l’ottimizzazione delle risorse e la diminuzione degli interventi manuali contribuiscono a minimizzare gli sprechi e a promuovere pratiche sostenibili.
STRUMENTI
Il monitoraggio digitale è uno degli strumenti più promettenti nell’ambito del pest management. I sistemi digitali di monitoraggio per i roditori utilizzano sensori avanzati per rilevare la presenza e il movimento dei roditori in tempo reale.
• sensori di movimento che rilevano il passaggio dei roditori in un’area speci ca. Questi sensori possono essere posizionati in punti strategici (pareti, sof tti o punti di ingresso) per monitorare in tempo reale l’attività dei roditori. La raccolta dei dati è poi analizzata da algoritmi per determinare i periodi e i luoghi di maggiore infestazione;
• sensori di presenza e di vibrazione in grado di rilevare il movimento o il passaggio degli animali attraverso la tecnologia PIR (Passive Infrared) o le vibrazioni, metodi che consentono di captare movimenti anche in aree di dif cile accesso;
Questi sistemi sono generalmente collegati a piattaforme software centralizzate, dove i dati raccolti vengono analizzati e resi accessibili tramite applicazioni mobili o desktop. In questo modo, gli operatori possono avere un monitoraggio costante senza dover eseguire ispezioni manuali e continuative.
Le innovazioni digitali nel pest management stanno trasformando la gestione dei roditori, portando a sistemi più efficaci, ef cienti e sostenibili. L’integrazione delle tecnologie IoT con sensori intelligenti, monitoraggio remoto e analisi dei big data ha migliorato la capacità di rilevare tempestivamente le infestazioni e ottimizzare gli interventi, riducendo i costi operativi e l’impatto ambientale.
igiene alimentare

Un intervento di disinfestazione effettuato in un molino dimostra come l’uso della tecnologia possa essere di grande aiuto per individuare punti di ingresso utilizzati dai roditori altrimenti difficilmente rilevabili
FRANCESCO NICASSIO
Siamo all’interno di un molino a grano duro dei primi del ‘900. La struttura, benché sempre perfettamente manutenuta e periodicamente ammodernata, risente dei problemi tipici degli edi ci costruiti all’inizio del secolo scorso: scale strette e anguste, un montacarichi posticcio più utile al trasporto di merce e macchinari che di persone, il pavimento in legno, un piano interrato attraversato da numerosissimi cavidotti e tubazioni ma, soprattutto, un ultimo piano, dove sono presenti i ltri dell’aria, coperto da una tettoia.
La struttura - un parallelepipedo con lati di circa 100 X 20 m e sei piani di altezza più quello interrato e, nelle immediate vicinanze, un complesso formato da una decina di silos in acciaio - con na a nord e ad ovest con il centro abitato, a sud con la ferrovia e a est con un capannone industriale abbandonato.
Agli inizi del mese di novembre 2024, al sesto piano vengono notate impronte ed escrementi di roditori; nei giorni successivi, grazie ad un sensibile aumento della vigilanza, si notano tracce anche in altre zone del molino.
Viene immediatamente allertato il disinfestatore che, tempestivamente, implementa il posizionamento di trappole a scatto e colle su tutti i piani, con particolare attenzione alle scale e ai pianerottoli, i quali, assieme alle tubazioni pneumatiche e le canaline, sono l’unico collegamento tra i piani.
Contestualmente vengono veri cati e chiusi, con materiale non oltrepassabile dai roditori, tutti i cavidotti e gli spazi tra le pareti e i pavimenti attraversati dalle tubazioni pneumatiche.
Il giorno successivo viene rinvenuto un ciuffetto di peli e
In un molino vengono notate numerose tracce di presenza di roditori.
Viene implementato il posizionamento di trappole a scatto e colle e vengono chiuse le possibili vie di ingresso.
Nonostante le misure adottate i roditori continuano a manifestare la loro presenza.
Tutti i fori sembrano essere stati chiusi, e non si capisce come riescano a spostarsi da un piano all’altro.
Si decide di installare una rete di sensori di passaggio a infrarossi. Ricostruendo il percorso dai roditori, si scopre un punto di ingresso del quale non si conosceva l’esistenza.
Dopo la chiusura del foro di ingresso non prima individuato, non sono più stati riscontrati roditori.
La rete di sensori di passaggio è stata mantenuta a scopo di monitoraggio.

un’impronta su di una trappola collante, segno evidente che il roditore, benché fosse entrato in contatto con la stessa, sia riuscito poi a liberarsi. Da quel momento in poi, né sulle trappole collanti, né su quelle a scatto, né in altro luogo del molino si rinviene più alcuna evidenza.
NUOVE TRACCE
Col passare dei giorni, si pensa che il roditore sia uscito dalla struttura ma, a distanza di circa una settimana dall’intervento straordinario di disinfestazione, si rinvengono due trappole a scatto disarmate al piano terzo. Il molino viene ispezionato accuratamente, sebbene con esito negativo, alla ricerca di eventuali punti di nidi cazione o accesso; tale ispezione consente però di rinvenire tracce: impronte di zampe e di coda, escrementi e rosicchiamenti, segno di una presenza piuttosto continuativa e costante nel tempo.
Nonostante il numero di trappole a scatto, colle e sistemi multicattura posizionati in ogni ambiente i roditori continuano a sfuggire e sembra che abbiano smesso di frequentare il pavimento dei piani e si siano spostati solo sulle parti più alte: canaline elettriche, tubi pneumatici, coclee e parti alte dei macchinari.
Come facciano a spostarsi da un piano all’altro resta un mistero; tutti i fori passanti da piano a piano sembrano essere stati chiusi e le scale non sembra vengano visitate.
A distanza di circa un mese dal primo rinvenimento, si decide di installare una rete di sensori di passaggio con tecnologia PIR (Passive InfraRed). Tale sistema consente il rilevamento grazie a sensori che si attivano al passaggio di animali a sangue caldo che emettono radiazioni infrarosse. Tali sensori sono collegati tra loro con tecnologia LO.RA (Long Range), un sistema di comunicazione wireless a lungo raggio e a bassa potenza in grado di inviare piccole quantità di dati su grandi distanze, e comunicano con una centralina che invia in tempo reale i dati ad un software gestionale in grado di elaborare le informazioni. Vengono installati venti sensori di cui: cinque al sesto piano, posizionati in modo perimetrale al piano con attenzione ai punti di ingresso e uscita delle tubazioni e dei cavi; tre al quarto piano, di cui uno vicino la porta, uno nel punto di ingresso delle tubazioni pneumatiche ed uno all’uscita; tre al secondo di cui uno vicino la porta, uno nel punto di ingresso delle tubazioni pneumatiche ed uno all’uscita; cinque al piano terra posizionati in modo perimetrale al piano, con attenzione ai punti di ingresso e uscita delle tubazioni e dei cavi; quattro al piano interrato, posizionati in modo perimetrale al piano con attenzione ai punti di ingresso e uscita delle tubazioni e dei cavi.
Detti sensori, installati in data 2 dicembre 2024, iniziano a raccogliere dati.
A distanza di una settimana esatta, incro-
ciando i dati delle segnalazioni con gli orari, si capisce con buona sicurezza il tragitto percorso dai roditori. A seguito di un sopralluogo mirato nella zona di potenziale ingresso posta al sesto piano, si scopre un foro che collegava l’esterno con l’interno, dif cilmente raggiungibile, tra due tubazioni parallele che percorrono tutti i piani del molino. Nello spazio tra un tubo e l’altro si rinvengono numerosi escrementi.
I roditori evidentemente entravano dall’esterno a scopo tro co e poi uscivano percorrendo lo stesso percorso. Vengono quindi posizionate due tavolette collanti immediatamente all’ingresso del foro; anche qui viene posizionato un sensore di passaggio che, nella notte successiva, segnala la presenza. La mattina dopo vengono rinvenuti sulle tavolette collanti quattro roditori della specie Rattus rattus e, contestualmente, viene chiuso dall’esterno il foro di ingresso.
Dopo la chiusura di quell’unico foro di ingresso, non prima individuato, non sono più stati riscontrati ingressi. La rete di sensori di passaggio è stata mantenuta a scopo di monitoraggio.
L’AVVENTO DI NUOVE SOLUZIONI
La gestione intelligente dei parassiti è ormai una realtà che offre alle aziende una soluzione altamente tecnologica per affrontare le problematiche legate ai roditori, portando a risultati migliori per l’ambiente e per l’economia.



La corretta gestione degli infestanti è un pilastro fondamentale per assicurare sicurezza, conformità normativa e continuità operativa nei diversi contesti, dall’industria alimentare no ai trasporti e all’ambito residenziale. La minaccia degli infestanti non si limita alla contaminazione degli spazi e può mettere a rischio la reputazione aziendale e generare importanti danni economici. È dunque fondamentale che i professionisti della disinfestazione possano avvalersi di strumenti innovativi e rispettosi dell’ambiente.
Tra le soluzioni all’avanguardia nel settore, i gel Advion® si distinguono come un’opzione ef cace, af dabile e sostenibile per il controllo di scarafaggi e formiche. La loro formulazione innovativa e le caratteristiche uniche lo rendono uno strumento prezioso per i professionisti della disinfestazione. Ci sono almeno cinque buoni motivi per cui i gel Advion rappresentano la scelta ottimale nella lotta contro scarafaggi e formiche.
1 APPETIBILITÀ
Advion® Gel Scarafaggi è tra le formulazioni a più elevata palatabilità disponibili in Europa (PPME23030-32, Arthroscience 2023). Si è dimostrato no a sette volte più appetibile rispetto ai prodotti testati in prove condotte da centri di ricerca indipendenti. Advion® Gel Formiche è formulato appositamente per essere attrattivo verso le principali specie di formiche infestanti e risultare appetibile a seconda delle diverse preferenze alimentari.
2
La bioattivazione, caratteristica esclusiva dei gel Advion, fa sì che il principio attivo distingua ef cacemente tra insetti bersaglio e organismi non bersaglio, come i mammiferi. Il principio attivo infatti viene attivato nella sua forma letale solo all’interno dell’insetto bersaglio da enzimi speci ci e questo consente ai professioni-
sti della disinfestazione di gestire al meglio il controllo degli insetti infestanti e i suoi effetti sull’ambiente.
3 FLESSIBILITÀ
I gel Advion possono essere utilizzati in ambienti interni ed esterni e in diverse aree di utilizzo che includono spazi residenziali, trasporti (aerei, treni, navi, autobus), aree pubbliche e siti commerciali e industriali. A dimostrazione del loro favorevole prolo ambientale e della loro caratteristica unica di bioattivazione, Advion Gel Formiche e Advion Gel Scarafaggi sono certi cati HACCP (Hazard Analysis and Critical Control Points) per l’utilizzo nell’industria alimentare in Splash or Spill Zone (SSZ: articoli adatti per l’uso nelle aree di manipolazione alimentare come cucine, aree di produzione e aree di lavorazione, ma non sono adatti a venire direttamente a contatto con alimenti o oggetti che verranno a contatto con alimenti).
4 EFFICACIA POTENZIATA
Il leggero ritardo dell’effetto letale dei gel Advion consente agli insetti, una volta consumata l’esca, di tornare nel loro rifugio e contaminare altri individui presenti nel nido. Questo si traduce in un’ef cacia potenziata per un controllo ottimale delle infestazioni.
5 CONTROLLO VERSATILE E AD AMPIO SPETTRO
I gel Advion agiscono sulle principali specie di blatte e formiche infestanti. Di recente Advion Gel Scarafaggi ha ottenuto anche la registrazione per il controllo del pesciolino d’argento e una durata di conservazione estesa a 3 anni.
Per maggiori informazioni visitare www.syngentappm.com/it/adviongels. I gel Advion sono distribuiti in esclusiva in Italia da Colkim (www.colkim.it).

















Segnalata in una nuova regione italiana, questa volta in Campania, la presenza in natura della Shelfordella lateralis, batta di origine asiatica, piuttosto rilevante dal punto di vista sanitario e igienico-alimentare




MORFOLOGIA
isura fino a cm asc io di colore c iaro e alato emmina di colore rosso e arancione scuro
DIFFUSIONE
i pro a ile origine asiatica in Italia è stata già avvistata in ardegna eneto om ardia a io
CICLO BIOLOGICO
lla temperatura di si completa in mesi e emmine adulte econdate depongono ooteca da circa uova ogni giorni li adulti vivono circa anno
RISCHI SANITARI
È in grado di diffondersi rapidamente e di sopravvivere in am ienti diversi a sua presen a in aree dove si conservano alimenti pu portare a contamina ioni e a gravi risc i per la salute
di fuori del loro habitat naturale, che minacciano la biodiversità locale. Allo stesso tempo, costituiscono un rischio anche per le attività umane, come l’agricoltura o la tutela della salute. Secondo il Regolamento (UE) n. 1143/2014, sono de nite come specie esotiche invasive quelle il cui impatto negativo richiede un intervento coordinato a livello dell’Unione Europea. Questi organismi possono includere insetti, piante, mammiferi e altri tipi di ora e fauna che, grazie alla loro adattabilità, trovano nei contesti antropici opportunità ideali per crescere e riprodursi.
Il lavoro dei disinfestatori è in costante evoluzione e, indubbiamente, ci sono circostanze che potrebbero complicarlo: mutano le leggi, diminuiscono le sostanze attive disponibili, gli adempimenti sono complessi e articolati ed il mercato, in ne, richiede maggiore attenzione, anche sotto il pro lo delle certi cazioni. Di contro, vi sono fattori che dovrebbero o potrebbero semplicarlo: nuove strategie di lotta integrata, attrezzature sempre più smart, formulati più performanti e, non ultimo, software gestionali che diventano un ausilio sempre più importante, sia per la sempli cazione dell’attività documentale che per la miglior piani cazione del lavoro.
Esistono poi fattori esterni, globali, di cui non sempre siamo in grado di considerare l’impatto: il clima e la globalizzazione. Cosa c’entrano questi ultimi con il nostro discorso? Come il cambiamento climatico e il trasporto di merci e persone possono in uire sulle specie animali e vegetali presenti in un territorio ed, in particolare, sul lavoro dei disinfestatori professionali?
CAUSE E PERICOLI
Al riguardo, sempre più spesso sentiamo parlare di specie aliene invasive o di specie alloctone invasive. Le specie aliene invasive sono organismi introdotti dall’uomo, intenzionalmente o accidentalmente, al
In un mondo sempre più connesso, dove merci e persone si spostano costantemente trasportate da un capo all’altro, è probabile che gli insetti più adattabili si diffondano e diventino cosmopoliti; l’Italia poi, nazione ospitale, risulta particolarmente vulnerabile a questo genere di colonizzazioni; pensiamo alla zanzara tigre (Aedes albopictus), alla cimice asiatica (Halyomorpha halys), al coleottero giapponese (Popillia japonica), alla cocciniglia tartaruga (Toumeyella parvicornis), al punteruolo rosso delle palme (Rhynchophorus ferrugineus), solo per citarne alcuni.
I danni derivanti, nella sola Italia, dall’introduzione della cimice asiatica all’agricoltura nel 2012, sono stati ingenti, specialmente nel 2019. In quell’anno, le perdite stimate hanno superato i 740 milioni di euro, con alcune colture che hanno registrato perdite no al 100%.
Dal punto di vista della salute pubblica, l’impatto delle zanzare AIM (Aedes Invasi-
ve Mosquitoes: negli ultimi anni sono state segnalate in Italia Ae. japonicus e Ae. koreicus, senza dimenticare il rischio di introduzione della nota Ae. aegypti), provenienti da aree lontane dall’Unione Europea, sta costituendo a livello globale una minaccia importante per la salute delle persone e degli animali, per la diffusione di arbovirosi. Il riscaldamento globale, inoltre, favorisce la diffusione di insetti invasivi dannosi per la salute umana e le attività economiche. L’aumento delle temperature estende l’habitat di vettori come zanzare e zecche, incrementando il rischio di malattie trasmesse all’uomo e agli animali. Inoltre, il cambiamento climatico amplia le aree di distribuzione di insetti nocivi per l’agricoltura, minacciando la sicurezza alimentare. La tematica non è nuova in assoluto: già Charles Darwin comprese che alcune specie possono essere un pericolo, per esempio, per la biodiversità. Nel 1834, rilevò che il ratto grigio aveva di fatto avuto un impatto negativo sulle popolazioni di ratti preesistenti in Nuova Zelanda (a loro volta introdotte dai Maori qualche secolo prima).
Quando questi organismi si adattano a vivere in stretta vicinanza e rapporto con gli uomini, vengono de niti sinantropici.
Le specie sinantropiche spesso sfruttano le modi che ambientali apportate dall’uomo, come l’aumento delle temperature nelle città, la disponibilità di ri uti come fonte di cibo, e la mancanza di predatori naturali.
LE BLATTE IN ITALIA
Un esempio classico di specie sinantropica è la Blattella germanica, che infesta abitazioni, ristoranti, pani ci, industrie alimentari, bar e locali pubblici sostanzialmente ovunque nel mondo; a ben guardare, non è un caso se tra le specie di insetti sinantropici cosmopoliti vi siano numerose blatte. Le blatte - comunemente conosciute come scarafaggi - sono tra gli insetti più adatta-

PER ANIMALI ESOTICI,
SI STA ADATTANDO
AGLI SPAZI URBANI
ITALIANI. RICONOSCERE
PRECOCEMENTE
NUOVE PRESENZE È
FONDAMENTALE PER UNA
GESTIONE EFFICACE
DELLE INFESTAZIONI
bili e resilienti del pianeta; riescono a colonizzare numerose nicchie ecologiche e spesso, pur vivendo a stretto contatto con l’uomo, risultano “invisibili”. La loro presenza diventa manifesta quando, grazie alla loro veloce capacità riproduttiva, entrano in competizione alimentare e, costretti dalla fame e dalla mancanza di spazio, devono trovare nuovi punti di approvvigionamento tro co e di colonizzazione. Ma gli scarafaggi sono tutti sinantropici e commensali dell’uomo?
L’ordine delle Blatte comprende 6 famiglie con 460 generi e oltre 4.000 specie; sono insetti cosmopoliti che vivono pressoché ovunque eccetto che nelle regioni polari e ad altitudini superiori ai 2.000 m. Delle oltre 4.000 specie presenti al mondo, solo una quarantina sono considerate sinantropiche o commensali dell’uomo e, di queste, solo quattro sono infestanti di interesse sanitario e merceologico in Italia: Blattella germanica (fuochista o mangiapane), Blatta orientalis (scarafaggio nero), Periplaneta americana (blatta americana), Supella longipalpa (blatta dei mobili).
Di fatto, quindi, in Italia vi è circa un decimo delle specie di blatte sinantropiche presenti al mondo. Potrebbero arrivarne altre, e quindi dover attuare strategie di lotta a blatte ad oggi ancora sconosciute? Chi individua l’arrivo di nuovi insetti in un territorio? Molto spesso le Università, le quali ricevono campioni da cittadini curiosi ed attenti e procedono con l’identi cazione; negli ultimi anni, le app di riconoscimento stanno contribuendo in questo genere di campionamenti. Alle volte, sono gli operatori del settore a rendersi arte ci del riconoscimento, come è successo nel caso riportato in questo articolo. Una nuova blatta in città Nella primavera del 2024, il signor Luigi Cotumaccio, tecnico specializzato dell’impresa Iside S.r.l, fornitore professionale di servizi di pest management, svolgendo le sue normali attività di disinfestazione e monitoraggio, nota su alcuni supporti collanti impiegati per le attività di monitoraggio un’importante presenza di una blatta diversa da quelle solitamente rinvenute. Nel corso dei mesi, rileva che la stessa blatta è presente anche presso altri siti da lui seguiti: interporto di Nola (Na), interporto di Maddaloni (Ce) e zona industriale di Carinaro (Ce).
Incuriosito, il Sig. Luigi reperta alcuni campioni perché vengano identi cati e gli stessi pervengono al Dr. Francesco Nicassio, esperto del settore disinfestazioni e consulente di entomologia urbana e merceologica.
Il riconoscimento delle blatte è stato effettuato dallo stesso Dr. Nicassio presso i laboratori dell’Università degli Studi di Bari, per mezzo delle chiavi di riconoscimento dei generi di Blattidae noti in Italia e nel resto d’Europa. Si è così stabilito trattarsi di una blatta che, sebbene capillarmente presente nei negozi di cibo per animali e nelle case di appassionati erpetologi, solo
da pochi anni vive in natura in limitate zone d’Italia.
Infatti, tra i campioni vi erano sia adulti (maschi e femmine), che neanidi ed ooteche, consentendo di identi carli come appartenenti alla specie Shelfordella lateralis (Walker), conosciuta anche come Blatta lateralis o “Turkestan Cockroach”. Questa blatta è una delle specie più diffuse ed allevate nel settore hobbistico, tra gli allevatori di animali insoliti, come rettili e an bi o uccelli insettivori; viene solitamente utilizzata come cibo vivo per sauri. La loro proli cità e facilità di gestione casalinga la rende estremamente comune ma anche - nel caso assai probabile in cui alcuni esemplari dovessero sfuggire dall’allevamento casalingo - estremamente pericolosa e diffusiva. Questa, molto probabilmente, è stata la via di ingresso in molti Paesi, Italia compresa.
Originaria probabilmente delle zone desertiche e semi-desertiche dell’Asia medio orientale, è diffusa anche in Africa Nord-orientale, India e Asia centrale (AL-Houty, 2011). A partire dagli anni ‘70, è presente anche negli Stati Uniti, Giappone e Messico, mentre solo negli ultimi anni appare anche a Cipro, in Turchia (Davranoglou et al. 2020) e nella penisola Iberica (Pradera & Carcereny, 2018).
Qual è però la situazione in Italia? A seguito delle prime segnalazioni in Sardegna nel 2009 (Fois et al., 2009), ve ne sono state diverse più recenti in Veneto, sia nella città di Vicenza, che a Santa Maria di Sala (Ve), negli anni dal 2018 al 2022; in Lombardia, a Galbiate (Lc) nel 2022; in Lazio, a Roma e Pomezia nel 2022.
BIOLOGIA ED ETOLOGIA
Shelfordella lateralis è una blatta di medie dimensioni; raggiunge i 3 cm con dimorsmo sessuale piuttosto evidente. Il maschio ha una colorazione marrone chiaro ed è
alato, mentre la femmina, decisamente più scura, è di colore rosso e arancione scuro. Questa blatta è piuttosto veloce nei movimenti ma non è una grande arrampicatrice, non riesce a superare pareti lisce. È onnivora. Tendenzialmente vive all’esterno nelle vicinanze delle abitazioni ma, in alcuni casi, può infestare le case esattamente come la Blattella germanica
Il ciclo biologico alla temperatura di 25 °C - 30 °C si completa in 3-5 mesi e le femmine adulte fecondate depongono 1 ooteca da circa 20 uova ogni 15 giorni.
Gli adulti vivono circa 1 anno.
Sherfoldella lateralis può trasmettere diverse malattie, anche gravi, a causa della sua presenza in ambienti umani e animali.
Sherfoldella lateralis è potenziale vettore di malattie che includono infezioni batteriche come quelle causate da Staphylococcus, che possono portare a infezioni cutanee, polmonari e altre complicazioni. Inoltre, questi scarafaggi possono trasportare parassiti intestinali come i nematodi, che possono infettare sia gli esseri umani, che gli animali domestici.
I rischi legati alla presenza di questa blatta risiedono nella sua capacità di diffondersi rapidamente e di sopravvivere in ambienti diversi, compresi quelli urbani e rurali. La sua presenza in cucine, bar, ristoranti, forni e pasticcerie e altre aree dove si conservano alimenti può portare a contaminazioni e a gravi rischi per la salute pubblica.
I disinfestatori (dai responsabili tecnici ai tecnici operanti in campo, sino a tutto il personale di supporto) e tutte le parti interessate dovranno continuare ad aggiornarsi e formarsi; solo una adeguata preparazione consentirà infatti di superare le innumerevoli sfide che l’introduzione di nuove specie invasive nel nostro territorio ci pone davanti.

Introdotta nel mercato del Pest Control per arricchire e ampliare l’offerta di soluzioni ecologiche a basso impatto ambientale, la linea di trappole luminose Klight è oggi un punto di riferimento nel panorama nazionale. Realizzata e distribuita da Ekommerce, essa ri ette l’eccellenza del Made in Italy, fondendo innovazione, impegno per la sostenibilità ambientale e design di alta qualità.
La linea Klight, composta da tre diverse collezioni, è pensata per soddisfare le esigenze di speci ci segmenti di mercato. Le trappole luminose rispondono alle normative vigenti in materia di sicurezza e igiene, garantendo soluzioni ideali per ambienti del settore Horeca, industrie alimentari, aree di trasformazione, luoghi di lavoro e ambienti a rischio di esplosione.
La collezione Industrial è pensata per il monitoraggio e la cattura di insetti volanti nelle aree produttive delle industrie della liera agro-alimentare, quella Commercial per i depositi, i magazzini e le aree di trasformazione, mentre le trappole della collezione Horeca come indicato dal nome stesso, vengono impiegate nel canale Horeca e in generale nelle aree aperte al pubblico.
Tra i modelli Klight, le trappole UV Pro 40 e Pro 80 sono progettate appositamente per applicazioni professionali nell’industria agro-alimentare dove ef cacia, qualità, robustezza e praticità sono elementi di fondamentale importanza per un servizio di monitoraggio all’altezza delle esigenze del settore.
Oggi la linea di trappole luminose Klight si arricchisce con l’intro-
duzione di due nuovi modelli a LED: Food e Wall Led. Le trappole a LED, rispetto alle tradizionali lampade UV, offrono numerosi vantaggi, tra cui una maggiore ef cienza energetica, una durata superiore e una ridotta emissione di calore.
L’introduzione di questi nuovi modelli si allinea con le normative europee e internazionali in materia di sicurezza e sostenibilità ambientale.
L’ef cacia delle trappole UV Klight è potenziata dall’innovativa linea FLUX, una linea avanzata di pannelli collanti per trappole luminose, capace di attrarre e catturare no al 180% in più di mosche e altri insetti alati rispetto a una tradizionale piastra gialla della stessa dimensione. Prodotta da Ekommerce, insieme alle piastre collanti Tak, Flux nasce a seguito di studi scienti ci, condotti dall’Università del Molise e volti a potenziare l’ef cacia dei pannelli collanti.
L’adozione di protocolli propri dell’Integrated Pest Management (IPM) nell’industria alimentare sarà sempre più diffusa data la necessità di ridurre in modo sensibile gli interventi chimici per il controllo delle infestazioni da insetti volanti. Tra i sistemi di monitoraggio maggiormente utilizzati nelle aree di produzione e stoccaggio di alimenti vi sono le trappole luminose a piastra collante. Numerosi sono stati i contributi offerti dalla ricerca scienti ca per la comprensione del funzionamento, lo sviluppo dei dispositivi luminosi e le interessanti applicazioni realizzate in alcune liere agro-alimentari.


igiene alimentarelepidotteri
La lotta contro gli infestanti non può prescindere da misure di prevenzione volte a evitare che essi riescano a introdursi e proliferare in un determinato ambiente. In particolare nel contesto dell’industria alimentare, ondamentale ai fini della prevenzione adottare una rigorosa gestione igienica degli ambienti, evitando l’accumulo di residui alimentari, garantendo una corretta rotazione delle scorte e ispezionando regolarmente le materie prime in
ingresso.
Oltre a ciò, ogni azienda dovrebbe formare il proprio personale sull’importanza delle buone pratiche igieniche, sull identificazione precoce dei segni di infestazione e sul corretto utilizzo dei sistemi di contenimento. Saper riconoscere i segni di infestazione, infatti, permette di intervenire quando essa è ancora in fase iniziale, limitando i danni e rendendo l’eradicazione dell’infestante più semplice, veloce e meno costosa.
Le tignole sono potenzialmente responsabili di gravi infestazioni nei prodotti stoccati. Il modo migliore per affrontarle consiste in un approccio integrato che comprenda prevenzione, monitoraggio e tecniche di pest control che limitino l’uso di prodotti chimici
I lepidotteri infestanti delle derrate alimentari, comunemente denominati tignole, appartengono all’ordine dei Lepidotteri, che include sia farfalle sia falene. La denominazione di questo ordine fa riferimento alla presenza, sulle ali, di minute squame disposte in modo embricato (le squame sono cioè disposte in maniera contigua e parzialmente sovrapposta), le quali conferiscono una caratteristica apparenza polverosa visibile a occhio nudo. I Lepidotteri sono insetti olometaboli, ossia presentano un ciclo vitale completo con metamorfosi distinta, comprendente gli stadi di larva e pupa prima del raggiungimento della forma adulta. Le larve, note comunemente come bruchi, sono tofaghe e mostrano un’elevata voracità alimentare; sono inoltre provviste di un apparato boccale di tipo masticatore. Al termine dello sviluppo larvale, avviene l’impupamento e la formazione della crisalide, dalla quale emergerà l’individuo adulto. Le specie più comuni e dannose sono la tignola fasciata del grano

SPECIE
NOME VOLGARE
Tignola fasciata del grano

INQUADRAMENTO SISTEMATICO
Classe Insecta
Ordine Lepidoptera
Sottordine glossata
Famiglia Pyralidae

CICLO BIOLOGICO
Se le condizioni sono particolarmente favorevoli può essere completato in 27 giorni circa, oppure durare anche 10 mesi. Ogni femmina è in grado di deporre da 60 a 400 uova. Si accoppia e depone dopo circa 3 giorni dallo sfarfallamento. Le uova schiudono in 7-8 giorni a 20 °C, mentre ne impiegano solo 3-4 se la temperatura è di 30 °C, con umidità relativa di 40-60%. Dopo la schiusa, le larve si disperdono nel substrato alimentare, raggiungono la maturità in 6-8 settimane a temperature di 18-35 °C. Il numero degli stadi larvali dipende dall’alimento e dalla temperatura e può variare da 5 a 7. Si possono trovare libere oppure ricoperte da bave sericee, stese sulla superficie del su strato alimentare
Lo stadio di crisalide dura 15-20 giorni a 20 °C, mentre a 30 °C dura circa una settimana. Il ciclo è continuo in luoghi riscaldati. La larva matura si allontana dal

substrato su cui si è nutrita per cercare un luogo adatto all’incrisalidamento.
MORFOLOGIA
L’uovo è di colore bianco-grigiastro, lungo 0,3-0,5 mm, e viene deposto direttamente sul substrato di alimentazione della futura larva, singolarmente oppure a gruppi.
La larva è di colore generalmente biancastro, ma si possono rinvenire anche larve rosate o brunastre, a seconda del cibo di cui si è nutrita. Presentano il capo e la parte dorsale del primo segmento del torace di colore marrone. Di forma cilindrica, a maturità sono lunghe circa 12-14 mm. Hanno un aspetto molto simile ad altre specie di piralidi per cui l identifica ione non acile da parte di personale non esperto.
L’adulto presenta un’apertura alare di 1520 mm e una lunghezza di 8-10 mm circa. Le ali anteriori sono di colore marroncino
- giallo con puntini neri nella parte articolata al torace, mentre nella parte distale presentano bande scure a bordi frastagliati su fondo bruno-rossastro. Questa colorazione forma una fascia quando l’insetto è in posizione di riposo. Il capo e il torace appaiono grigio-marrone. Le antenne sono molto lunghe.
CARATTERISTICHE
Gli adulti sono un segno tangibile dell’infestazione così come le bave sericee. Di solito sono attivi di notte. Hanno un volo zigzagante. Sono attratti dalla luce. Non si nutrono. Preferiscono luoghi poco luminosi e poco frequentati. Plodia interpunctella è polifaga, ma infesta principalmente i cereali e derivati (pasta, farina), frutta secca, legumi secchi, funghi secchi, prodotti da forno, cioccolato, latte in polvere, succhi di frutta, materiali zuccherini, alimenti per cani e gatti, spezie.
TRATTAMENTI TERMICI
elevano la temperatura dell’ambiente infestato a valori superiori a 50 - 55 °C per un tempo controllato
TRATTAMENTI CRIOGENICI
abbassano rapidamente la temperatura di piccole quantità di prodotto o di aree localizzate a valori inferiori a -20 °C
(Plodia interpunctella) e la tignola grigia delle derrate (Ephestia kuehniella). La tignola fasciata del grano e la tignola grigia delle farine infestano le derrate alimentari costituite da cereali come il frumento e il mais, prodotti derivati come la pasta, frutta secca e alimenti di origine animale, ad esempio carni essiccate. Le infestazioni causate da questi insetti possono provocare rilevanti danni economici. Le larve sono responsabili del danno, poiché si nutrono dei prodotti conservati. Oltre a consumare direttamente le derrate, le larve le danneggiano avvolgendole con li sericei, nei quali si accumulano escrementi e spoglie delle mute.
DEL MONITORAGGIO
Il monitoraggio consente di rilevare precocemente la presenza degli infestanti e di valutare l’entità dell’infestazione. Si effettua utilizzando trappole a feromoni speci che per Plodia ed Ephestia, che attirano i maschi adulti grazie a segnali chimici sessuali. Le trappole, posizionate strategicamente in ambienti di stoccaggio e produzione, permettono di localizzare i focolai e programmare le azioni correttive.
TECNICHE DI DISINFESTAZIONE
I trattamenti termici rappresentano una delle soluzioni più sicure e rispettose dell’ambiente. Esse consistono nell’elevare la temperatura degli ambienti infestati a valori letali per le tignole (superiori a 50 - 55 °C)
FUMIGAZIONI
utilizzano dei gas che, penetrando anche nei punti meno accessibili, eliminano ogni forma vitale dell’insetto
ATMOSFERA CONTROLLATA/ MODIFICATA
modificano la composizione dell’aria riducendo l’ossigeno e aumentando l’anidride carbonica o l’azoto, uccidendo gli insetti per asfissia
per un tempo controllato. Le alte temperature agiscono su tutte le fasi del ciclo vitale degli insetti: uova, larve, pupe e adulti. Questa tecnica è particolarmente ef cace nei silos, nei magazzini e nei macchinari di lavorazione. I vantaggi includono l’assenza di residui chimici e la possibilità di tornare rapidamente ad utilizzare le aree trattate. Tuttavia, richiede attrezzature specializzate e personale quali cato. In alternativa al calore, si possono utilizzare le basse temperature. I trattamenti criogenici, realizzati tramite l’impiego di anidride carbonica liquida o azoto, abbassano rapidamente la temperatura a livelli incompatibili con la sopravvivenza delle tignole (inferiore a -20 °C). Sono indicati per il trattamento di piccole quantità di prodotto o di aree localizzate.Un’altra alternativa è rappresentata dalla fumigazione, una tecnica ad alta ef cacia impiegata in casi di infestazione estesa. Consiste nell’applicazione di gas disinfestanti, come la fos na, in ambienti chiusi, silos o container, in grado di penetrare anche nei punti meno accessibili. L’intervento elimina completamente tutte le forme vitali degli insetti. Essendo un trattamento potenzialmente pericoloso, la fumigazione deve essere effettuata esclusivamente da operatori certicati, nel rispetto delle normative sulla sicurezza e dei tempi di ventilazione. Inoltre, la sua applicazione è soggetta a regolamentazioni stringenti, specie nell’ambito alimentare, per evitare contaminazioni. Una tecnica che ha preso piede negli ultimi
INSETTICIDI A BASSO IMPATTO AMBIENTALE applicati sotto forma di nebulizzazione, termonebulizzazione o polveri residuali
anni è quella dell’atmosfera controllata o modi cata, che prevede la modi ca della composizione dell’aria all’interno di un ambiente chiuso, riducendo l’ossigeno e aumentando l’anidride carbonica o l’azoto. In queste condizioni, gli insetti muoiono per as ssia. Questo metodo è privo di residui chimici e sicuro per i prodotti alimentari, ma richiede tempi più lunghi rispetto alla fumigazione.
Quando è necessario l’uso di prodotti chimici, si preferiscono insetticidi a basso impatto ambientale, autorizzati per l’impiego nell’industria alimentare. Questi possono essere applicati sotto forma di nebulizzazione (cold fogging), termonebulizzazione (ULV) o mediante l’uso di polveri residuali, a seconda della con gurazione dell’ambiente.
I biocidi devono essere selezionati in base alla normativa vigente (Regolamento Biocidi UE 528/2012), al principio attivo e alla compatibilità con la produzione alimentare.
Il controllo delle tignole nei contesti industriali alimentari richiede quindi un approccio sistemico, integrato e professionale. La combinazione di monitoraggio costante, tecniche non invasive e, se necessario, interventi mirati con prodotti autorizzati, rappresenta la strategia più ef cace e sicura. Solo un approccio strutturato e rispettoso delle normative può garantire la protezione delle derrate alimentari, la sicurezza del consumatore e la sostenibilità del processo produttivo.









PRESENTARE BENE
SUL SITO WEB I SERVIZI
OFFERTI, I LORO PREZZI
E LE INFORMAZIONI
DI CONTATTO
CREARE CONTENUTI
DI VALORE PER I SOCIAL,
SENZA TRASCURARE
LA QUALITÀ DI IMMAGINI E VIDEO


COSTRUIRE UN DATABASE EMAIL
DI POTENZIALI CLIENTI
A CUI INVIARE
NEWSLETTER E OFFERTE
SPECIALI
UTILIZZARE PROGRAMMI
PUBBLICITARI ONLINE PER RAGGIUNGERE UN PUBBLICO PIÙ AMPIO



imprenditività formazione

Il marketing online
offre strumenti utili per raggiungere un pubblico mirato, costruire la propria reputazione in rete e far crescere il proprio business
NICCOLÒ LUONGO

Nel dinamico mondo di oggi, anche per un’impresa di pulizia farsi notare dai clienti giusti richiede più del semplice passaparola. In questo, un valido aiuto è in grado di offrirlo il marketing digitale. Non si tratta di diventare esperti di codici e algoritmi complessi, ma di comprendere alcune strategie chiave e metterle in pratica in modo ef cace. Vediamo insieme come sfruttare il web per aumentare la visibilità della propria impresa.
UNA VETRINA ONLINE
Bisogna immaginare il proprio sito web come se fosse la vetrina del proprio negozio, aperta 24 ore su 24, 7 giorni su 7, accessibile a chiunque stia cercando i servizi offerti. Avere una presenza online professionale non è più un lusso, ma una necessità per trasmettere af dabilità e serietà. Ma cosa dovrebbe contenere questa vetrina digitale per attirare i clienti giusti? Innanzitutto, i servizi offerti vanno presentati in modo chiaro e



dettagliato, non limitandosi a elencare “pulizie domestiche” o “pulizie uf ci”. Bisogna approfondire, spiegando cosa includono i servizi. Ad esempio, per le pulizie domestiche si potrebbe speci care la pulizia di pavimenti, bagni, cucine, vetri, la possibilità di pulizie approfondite o occasionali. Per le pulizie uf ci, si potrebbe menzionare la pulizia di postazioni di lavoro, aree comuni, servizi igienici, svuotamento cestini, ecc. Importante includere anche eventuali servizi speciali come la pulizia di tappeti, moquette, o trattamenti speci ci per pavimenti. Un altro aspetto importante è rappresentato dalla trasparenza sui prezzi. Indicarli chiaramente, o dare un’idea di essi, è un fattore determinante per molti clienti. È possibile indicare tariffe orarie, prezzi a forfait per determinati servizi o fasce di prezzo in base alle dimensioni degli ambienti. Se si preferisce fornire preventivi personalizzati, spiegare chiaramente il processo e invitare i visitatori a contattare per un sopralluogo gratuito.
RENDERE FACILE IL CONTATTO
Le informazioni di contatto devono essere ben visibili in ogni pagina del sito e devono includere il numero di telefono, l’indirizzo email e, se esiste una sede sica aperta al pubblico, anche l’indirizzo. Un modulo di contatto diretto è un modo comodo attraverso il quale i potenziali clienti possono inviare una richiesta.
Le opinioni di altri clienti sono una potente forma di riprova sociale. Se un’azienda ha clienti soddisfatti, vale la pena chiedere il permesso di pubblicare una loro breve testimonianza sul proprio sito web. Si può anche integrare con recensioni da piattaforme esterne, come ad esempio Google My Business. L’ideale sarebbe creare sul sito una sezione “cosa dicono di noi”, con citazioni di clienti che elogiano professionalità, qualità del servizio o puntualità. Molto utile anche prevedere una sezione “chi siamo”, che racconti la storia della propria impresa, i propri valori, la propria esperienza e le qualità di-
stintive dalla concorrenza. Un tocco umano può fare la differenza nel costruire ducia. Non dimentichiamo che un sito web ben progettato, facile da navigare e visivamente accattivante trasmette professionalità e cura per il dettaglio. Fondamentale assicurarsi che sia ottimizzato per la visualizzazione su dispositivi mobili (smartphone e tablet).
Per un’impresa di pulizia, questi strumenti possono diventare un canale prezioso per entrare in contatto con potenziali clienti a livello locale, costruire una community e mostrare il proprio lato umano. Non serve essere ovunque: è importante concentrarsi sulle piattaforme dove è più probabile trovare il proprio pubblico target. Ad esempio, Facebook e Instagram sono spesso ef caci per raggiungere un pubblico ampio e locale. LinkedIn può essere utile se ci si rivolge principalmente ad aziende e uf ci. A prescindere dal social scelto, l’importante è creare contenuti di valore, non limitandosi quindi a pubblicizzare i propri servizi ma condividendo contenuti utili e interessanti per il tuo pubblico, come ad esempio consigli pratici per la pulizia domestica, oppure brevi video o post con trucchi per pulire diverse super ci, organizzare gli spazi o rimuovere macchie dif cili. I contenuti visivi devono essere di qualità: foto e video ben fatti sono molto più coinvolgenti del semplice testo.
Un’ottima iniziativa social può anche consistere nel mostrare i dietro le quinte della propria attività: mostrare il team al lavoro (nel rispetto della privacy dei clienti), i prodotti utilizzati, i risultati ottenuti. Questo contribuisce a umanizzare il proprio brand. Altri contenuti che riscuotono successo sui social sono le case history (anonimizzate) che raccontano come è stato risolto un problema per un cliente, i sondaggi e le domande (utili a coinvolgere il pubblico e sapere quali servizi cerca), le promozioni speciali esclusive per i follower (incentivano le persone a seguire la pagina offrendo sconti o vantaggi). Non bisogna mai trascurare l’in-
terazione con la community, rispondendo ai commenti e ai messaggi in modo tempestivo e cordiale. Inoltre, partecipare a conversazioni locali, seguire le pagine di altre attività della propria zona e interagire con i loro post aiuterà a farsi conoscere e a costruire relazioni. La costanza fa la differenza: pubblicare regolarmente contenuti mantiene vivo l’interesse del pubblico. Non bisogna postare ogni giorno, ma creare un calendario editoriale e cercare di rispettarlo. In ne, non sottovalutare l’utilizzo delle storie, un mezzo informale e veloce per condividere aggiornamenti, promozioni lampo o momenti della propria giornata lavorativa.
Una volta ottenuta una solida presenza online con il sito web e i social media, si può iniziare a considerare l’utilizzo di strumenti di marketing più mirati per raggiungere un pubblico più ampio e coltivare i propri contatti.
Piattaforme come Google Ads e Facebook Ads permettono di creare annunci pubblicitari che vengono mostrati a persone speciche in base ai loro interessi, alla loro posizione geogra ca e ad altri criteri demogra ci. Rendono quindi possibile raggiungere un pubblico altamente mirato, consentendo contemporaneamente un controllo preciso sul proprio budget e di misurare i risultati delle proprie campagne.
Con Google Ads è possibile ad esempio creare annunci che compaiono quando qualcuno cerca su Google un tipo di impresa o un servizio in una determinata zona. Si paga solo quando qualcuno fa clic sull’annuncio sponsorizzato e visita il sito web dell’inserzionista. Con Facebook Ads, invece, è possibile mostrare i propri annunci a persone che vivono nella stessa area dell’inserzionista, che hanno mostrato interesse per la pulizia della casa o che hanno determinate caratteristiche demogra che.
Un’altra risorsa fondamentale, spesso gratuita per le attività locali, è Google My Business (ora Google Business Pro le). Essa
permette di creare e ottimizzare la propria scheda per apparire nei risultati di ricerca locali e su Google Maps quando le persone cercano servizi di pulizia in zona. Ovviamente è importante assicurarsi che le proprie informazioni siano accurate e aggiornate (nome, indirizzo, numero di telefono, orari di apertura, sito web) e incoraggiare i clienti soddisfatti a lasciare recensioni positive. Le recensioni, infatti, in uenzano notevolmente la decisione di altri potenziali clienti.
In ne, analizziamo lo strumento dell’email marketing: costruire una lista di indirizzi email di potenziali clienti permette di comunicare direttamente con loro, inviando offerte speciali, promemoria stagionali o aggiornamenti sulla propria attività.
Per raccogliere indirizzi email, una buona strategia può essere quella di offrire un incentivo (ad esempio, una guida gratuita sulla pulizia o un piccolo sconto sul primo servizio) in cambio dell’iscrizione alla newsletter sul sito web o sui social media.
Per incrementare il proprio database di indirizzi è anche importante creare email coinvolgenti, personalizzando i messaggi, segmentando la propria lista in base agli interessi dei clienti e offrendo contenuti di valore oltre alle semplici promozioni. Una buona idea, ad esempio, può essere l’invio di un’email in primavera con un’offerta speciale per le pulizie di primavera, oppure un promemoria prima delle festività natalizie per prenotare una pulizia post-feste. Il marketing digitale non è quindi un’attività da delegare completamente a esperti esterni (anche se può essere utile in alcuni casi), ma un insieme di strumenti che bisogna imparare a utilizzare per far crescere la propria impresa. Un sito web professionale è un ottimo punto di partenza, dal quale poi proseguire coltivando la propria presenza sui social media e considerando il potenziale della pubblicità online e dell’email marketing nel raggiungere i clienti giusti. La costanza e la cura dei dettagli, le stesse che è importante mettere in campo durante le operazioni di pulizia, sono importanti anche nelle strategie di marketing digitale.


In un mondo sempre più attento all’ambiente e alla sostenibilità, anche il settore della lavanderia professionale è chiamato a fare la sua parte. Una delle scelte più ef caci e immediate per ridurre l’impatto ambientale è il lavaggio a bassa temperatura, una pratica che, grazie ai giusti prodotti, garantisce risultati impeccabili riducendo consumi e sprechi.
La linea Green’r di Christeyns, con formulazioni all’avanguardia e certi cazioni Ecolabel, è la risposta perfetta per chi cerca efcienza, risparmio e rispetto per l’ambiente.
PERCHÉ SCEGLIERE IL LAVAGGIO BASSA TEMPERATURA
Il lavaggio a bassa temperatura consente un notevole risparmio energetico, no al 60% rispetto ai tradizionali cicli di lavaggio. Questo si traduce in minori costi operativi e una signi cativa riduzione delle emissioni di CO2. Inoltre, lavare a freddo aiuta a preservare la qualità dei tessuti, rallentandone l’usura e mantenendo più a lungo colori e bre.
Ma i vantaggi non niscono qui. Il lavaggio a freddo è anche più delicato su bre sensibili, rendendolo ideale per capi tecnici, tessuti misti o articoli che richiedono cure particolari. È un gesto semplice, ma concreto, verso una lavanderia più green e responsabile. I prodotti della linea Green’r sono particolarmente ef caci per of-
frire performance elevate anche in condizioni di lavaggio a freddo. Composta da detergenti, candeggianti, ammorbidenti e additivi certi cati Ecolabel. La loro azione mirata permette di lavare tutti i tipi di tessuti a basse temperature, mantenendo alti standard di pulizia. Inoltre, grazie al supporto tecnico Christeyns, è possibile ottimizzare ogni ciclo di lavaggio, personalizzando i dosaggi in base a carichi, tipologia dei capi e grado di sporco. Il risultato? Massima ef cienza con il minimo impatto ambientale.
La certi cazione Ecolabel, riconosciuta a livello europeo, garantisce che i prodotti Green’r rispondano a criteri rigorosi in termini di ecocompatibilità, sicurezza e prestazioni. Scegliere Green’r signi ca dunque fare una scelta trasparente e veri cata, a favore dell’ambiente e della salute di operatori e utenti nali. Con prodotti adeguati e un uso consapevole, è possibile contenere l’impatto ambientale senza compromettere l’ef cacia. Christeyns supporta chi punta su soluzioni sostenibili e sceglie ogni giorno un’idea di pulizia più responsabile.

Atteggiamento mentale, emozioni e capacità di gestire le relazioni sono fattori chiave che determinano il successo o il fallimento di un percorso professionale
Nel mondo del lavoro, come nella vita, ci si trova costantemente di fronte a ostacoli e s de. A volte sembrano insormontabili e possono metterci alla prova sia professionalmente che emotivamente. Ma ciò che realmente fa la differenza non è la dif coltà in sé, bensì il modo in cui si sceglie di affrontarla.
Alcune persone, di fronte a un problema, si arrendono subito, convinte di non avere il talento o le capacità per superarlo. Altre, invece, vedono ogni ostacolo come un’opportunità per migliorare e acquisire nuove competenze. Questo modo di pensare può
determinare non solo i risultati di una carriera, ma anche il livello di soddisfazione personale e la qualità delle relazioni professionali. La chiave sta nell’approccio mentale adottato quando si affrontano le dif coltà.
Carol Dweck, psicologa di fama mondiale, ha studiato a lungo questo fenomeno e ha individuato due diversi approcci mentali che guidano il nostro comportamento: la mentalità ssa e la mentalità di crescita. La sua teoria del mindset ha rivoluzionato
il modo in cui comprendiamo il talento e il successo, dimostrando che il nostro atteggiamento mentale può in uenzare profondamente le capacità di apprendimento e miglioramento.
Non è solo una questione di abilità innate, ma piuttosto di come affrontiamo le sde e di quanto siamo disposti a imparare. Questa distinzione è cruciale per chiunque voglia crescere nel proprio settore. Che un professionista sia un venditore, un manager o un imprenditore, il suo mindset può determinare la sua capacità di adattarsi ai cambiamenti, migliorare le sue competenze e affrontare le s de con resilienza. E il bello è che non si tratta di un talento innato, ma di un’abilità che si può sviluppare con il tempo e la giusta mentalità. Scopriamo allora come applicare la mentalità di crescita al mondo del lavoro e come integrarla con l’intelligenza relazionale® e l’intelligenza emotiva, due competenze fondamentali per chi desidera eccellere nelle relazioni professionali e ottenere risultati migliori.
IL PRINCIPIO DEL “NOT YET”
Chi ha una mentalità fissa crede che le proprie capacità siano innate e immutabili: o sei bravo in qualcosa, o non lo sarai mai. Questo atteggiamento porta a evitare
NON SONO CAPACE
NON SONO BRAVO A GESTIRE CLIENTI COSÌ, NON FA PER ME
IL FEEDBACK NEGATIVO CHE HO RICEVUTO NON MI È PIACIUTO E MI HA OFFESO
le s de per paura del fallimento, generando insicurezza e ansia. Al contrario, chi possiede una mentalità di crescita vede le competenze come qualcosa che può essere sviluppato con impegno e strategia. Qui entra in gioco anche l’intelligenza emotiva: riconoscere le proprie emozioni di frustrazione o scoraggiamento e saperle gestire è fondamentale per mantenere la motivazione. Il fallimento non è la ne, ma una tappa dell’apprendimento.
Una volta si diceva, in inglese, “Sometimes you win, sometimes you lose” ovvero “Qualche volta vinci, qualche volta perdi”. Alla luce di questi primi concetti potremmo riscrivere questa frase in questo modo:
NON LO SO ANCORA FARE
COME POSSO MIGLIORARE IL MIO APPROCCIO PER IL PROSSIMO CLIENTE?
COME POSSO TRASFORMARE QUESTO OSTACOLO IN UN’OPPORTUNITÀ?
“Sometimes you win, sometimes you learn” ovvero “Qualche volta vinci, qualche volta impari”.
Un concetto chiave che Dweck introduce è quello del “not yet”; invece di pensare di non essere capaci di fare qualcosa, si può pensare di non essere ancora in grado, per il momento, di farlo. Questo cambio di prospettiva aiuta a ridurre la frustrazione e a mantenere alta la determinazione, rendendo il percorso di crescita personale e professionale più ef cace e grati cante. Quando ci concediamo il tempo di imparare, accettiamo il fatto che la competenza non è un punto di arrivo immediato, ma un processo.
SBAGLIARE PER APPRENDERE
Immaginiamo il professionista di un’impresa di pulizie che si trova di fronte a un committente particolarmente esigente, magari con idee precise e un budget limitato. Se ha una mentalità ssa, potrebbe pensare di non essere bravo a gestire clienti così, che non faccia per lui, e magari evitare situazioni simili in futuro. Questo atteggiamento lo porterà a limitare le proprie opportunità di crescita e a ripetere gli stessi schemi inef caci. Se invece adotta una mentalità di crescita, si chiederà cosa è possibile imparare dall’esperienza appena vissuta e come migliorare l’approccio per il prossimo cliente.
Qui entra in gioco il principio del “not yet”: invece di vedere l’interazione dif cile come una scon tta, va considerata come una tappa di apprendimento. Il professionista che abbiamo preso come esempio non è ancora in grado di gestire perfettamente quel tipo di cliente, ma può sviluppare competenze che lo aiuteranno nel tempo. Può, per esempio, seguire corsi di aggiornamento su nuove procedure e tecnologie del settore, oppure partecipare a workshop di comunicazione per migliorare la sua capacità di ascolto e di persuasione. O ancora, chiedere supporto ai colleghi più esperti, consultare tutorial online o partecipare a
corsi di formazione speci ci. Ogni errore diventa una fonte di conoscenza, ogni successo parziale un trampolino verso il miglioramento continuo.
La mentalità di crescita ha molto in comune con l’intelligenza relazionale®, che è la capacità di gestire ef cacemente le relazioni umane, leggendo e rispondendo ai bisogni emotivi e comunicativi degli altri. In un settore dove la relazione con il cliente è fondamentale per la vendita e la delizzazione, l’intelligenza relazionale® è un elemento chiave per il successo. Se vediamo la comunicazione come una competenza che può essere allenata, diventa più facile gestire clienti dif cili, risolvere con itti con i colleghi o negoziare con successo. Un venditore con una buona intelligenza relazionale® sarà in grado di comprendere le esigenze del cliente, di creare un clima di ducia e di proporre soluzioni personalizzate.
Inoltre, l’intelligenza emotiva è fondamentale per sviluppare la mentalità di crescita. Chi riesce a gestire le proprie emozioni negative, come la paura del fallimento o la frustrazione, ha maggiori possibilità di migliorare. Quando un professionista è consapevole delle proprie emozioni e le utilizza in modo costruttivo, affronta meglio le sfide e diventa più efficace nella gestione delle relazioni. Un professionista che sa gestire le proprie emozioni sarà in grado di mantenere la calma di fronte a un problema imprevisto, di trovare soluzioni creative e di comunicare in modo ef cace con il cliente.
Un professionista che riceve un feedback negativo da un collaboratore potrebbe reagire in due modi: con una mentalità ssa, sentirà il commento come un attacco personale e si chiuderà. Con una mentalità di crescita, invece, lo vedrà come un’opportunità per migliorare il proprio stile di leadership e costruire un team più coeso. Se unisce questa mentalità a una buona gestione
emotiva e relazionale, potrà trasformare il feedback in uno strumento per rafforzare il rapporto con il team e migliorare la qualità del lavoro.
Quando ci si trova di fronte a una dif coltà, che si tratti di un cliente esigente, di un intervento di pulizia complesso da effettuare o di un nuovo software gestionale da imparare, bisogna pensare a come poter trasformare l’ostacolo incontrato in un’opportunità di crescita. Nel dinamico settore della pulizia professionale, dove innovazione tecnologica e sostenibilità ambientale sono in continua evoluzione, la capacità di adattarsi, imparare e crescere è più importante che mai. Adottare una mentalità di crescita signi ca accettare la s da, imparare dai propri errori e sviluppare nuove abilità, sia tecniche che relazionali. Signi ca guardare a ciò che ancora non si è in grado di fare come a un trampolino di lancio verso il miglioramento, anziché come a un limite invalicabile. Il vero successo non è essere perfetti subito, ma essere disposti a migliorare ogni giorno.
Coltivare una mentalità di crescita consente di affrontare con ducia le s de del mercato, accogliendo le novità tecnologiche e normative come opportunità di crescita e di sviluppo professionale. Permette inoltre di migliorare le proprie competenze tecniche e relazionali, sviluppando una maggiore capacità di problem solving, di comunicazione e di gestione delle relazioni con clienti e colleghi.
In ne, permette di contribuire al successo della propria azienda: un team di persone con una mentalità di crescita è un team più motivato, innovativo e performante, in grado di raggiungere risultati eccellenti. Con il giusto atteggiamento mentale, è possibile trasformare ogni s da in un’occasione per crescere e raggiungere il proprio pieno potenziale. Abbandonando la propria zona di comfort, sperimentando e imparando cose nuove: il percorso di crescita non nisce mai, e ogni passo porta più vicino al successo.





Lyreco Italia, debutta a ISSA PULIRE 2025 con una proposta integrata per l’igiene e la pulizia professionale, portando a livello locale tutta la forza del Gruppo Lyreco, attore globale nella fornitura responsabile di prodotti e servizi per ogni ambiente di lavoro, attivo sul mercato dal 1926. Un’offerta completa, che include assistenza e supporto continuo al cliente con: specialisti dedicati, account generalisti, ordini smart su lyreco.it, consegne essibili e customer care interno.
PRODOTTI E SERVIZI MULTIBRAND
Lyreco aiuta imprese e professionisti a creare spazi di lavoro funzionali, sicuri e salubri, ottimizzando il processo d’acquisto con una gestione ef ciente di ordini, stock e consegne. Grazie alla partnership con i migliori brand sul mercato, l’azienda assicura che tutte le esigenze di igiene e sostenibilità, in ogni settore e ambiente, siano soddisfatte in modo continuativo e nel rispetto dei più alti standard di qualità. Che si tratti della gestione di una grande struttura o di un piccolo uf cio, Lyreco fornisce soluzioni complete e gamme responsabili per una pulizia impeccabile: dai prodotti per il bagno alle attrezzature professionali, dall’installazione dei dispenser allo smaltimento di guanti contaminati.
LOGISTICA EFFICIENTE
Il servizio di consegna rapido e puntuale è sostenuto da una logistica all’avanguardia e da un network distributivo capillare, sia a livello nazionale che internazionale. In Italia, dove Lyreco opera da 30 anni, sono presenti un centro di distribuzione automatizzato di
32.000 mq, 18 hub regionali e una otta di oltre 120 mezzi, tra cui Truck Bio LNG e Van Full Electric.
SPECIALISTI IN IGIENE E PULIZIA PROFESSIONALE
La divisione Igiene e Pulizia Professionale di Lyreco Italia è composta da una squadra di specialisti dedicati, che unisce alla profondità di gamma le migliori competenze tecniche. L’obiettivo è portare ai clienti una consulenza personalizzata, partendo dall’analisi dei bisogni no alla de nizione delle forniture più adatte, garantendone la consegna puntuale secondo le modalità concordate. E non solo, il team supporta attivamente le aziende anche nell’uso corretto dei prodotti, offrendo, su richiesta, af ancamento in collaborazione con i produttori. Tutto questo è possibile grazie a una formazione continua e a forti sinergie con i partner. Completano il servizio strumenti digitali come reportistica e schede tecniche a portata di click.
SOLUZIONI PER OGNI SETTORE
Con Lyreco, affrontare le s de di ogni settore con soluzioni concrete e mirate è una realtà. Industria, Produzione e Trasporti: prodotti per aumentare l’ef cienza; Retail: ordini smart e consegne capillari; Uf ci e Aziende: soluzioni e servizi per la cura degli ambienti; Imprese di Pulizia: forniture professionali su misura e consegne essibili; Horeca: soluzioni mirate per l’igiene, la sicurezza e il comfort; Sanità e Pubblica Amministrazione: forniture professionali, presenza su MEPA e team gare.


Da zero a eccellenza. Il mio viaggio. Le loro teorie. Il tuo sogno racconta e condivide il percorso imprenditoriale di Luca Fierro, partendo dalle sue radici più profonde. Attraverso questo viaggio, ci vengono svelati non solo i momenti professionali che hanno segnato la sua carriera, ma anche le vicissitudini personali, spesso inedite e segrete, che hanno forgiato la sua persona, il suo carattere e la sua visione aziendale.
Il libro, elaborato con la la tecnica di scrittura a più atti, ha una struttura narrativa tipica dello storytelling, che prevede la suddivisione dell’opera in segmenti distinti, nei quali vengono esplorati alcuni pilastri essenziali per sviluppare un’azienda felice e prospera, con l’obiettivo di ispirare e stimolare qualche giovane avventuriero del mondo del business.Il volume verrà promosso durante la fiera ISSA PULIRE. Per informazioni, è possibile recarsi presso lo stand Hygenia (Pad. 12, stand K29). Il libro è acquistabile sullo store di Amazon.

Ad aprile 2025, l’Istituto Superiore di Sanità (ISS) ha aggiornato il report 2023 della Sorveglianza nazionale del Consumo della Soluzione Idroalcolica (CSIA) per l’igiene delle mani in ambito ospedaliero. Secondo gli ultimi numeri disponibili, che aggiornano quelli pubblicati lo scorso novembre con ulteriori dati per due Regioni, i consumi della soluzione per l’igiene delle mani sono in progressivo calo. Nel 2023 il dato nazionale mediano è stato di 10,5 L/1000 GDO (litri ogni mille giornate di degenza ospedaliera) per la degenza ordinaria. I consumi variano per area: più alti in terapia intensiva (39,9 L/1000 GDO), più bassi in ortopedia (8,9 L/1000 GDO). Le due Province Autonome (Trento e Bolzano) presentano valori superiori alla media, mentre diverse Regioni del Sud mostrano valori inferiori. Negli anni, si è osservato un progressivo calo dei consumi in tutte le aree, con un consumo per la degenza ordinaria che è dimezzato negli ultimi tre anni, scendendo sotto il valore soglia di 20 litri. Cresce invece il numero di strutture partecipanti alla sorveglianza.

Anche quest’anno, si assegna durante ISSA PULIRE 2025 il Premio “Product of the Year”, che certifica, attraverso il giudizio di una giuria di esperti, i valori di qualità, affidabilità, eco-compatibilità, ergonomia ed economicità dei prodotti presenti sul mercato. Le aziende in gara sono le seguenti: Annovi Reverberi, Arcora International, Copyr, Dryft/ MotorScrubber, Essity Tork, Vileda, Ghibli&Wirbel, Hygenia, i-Team Global, Idrobase, Lucart, Makita, Newpharm, Robovox Distributions, Sofidel, Taxon, Trojan Battery Company, Unger Germany.

Da ottant’anni al servizio della pulizia professionale, con un occhio sempre rivolto all’innovazione e alla sostenibilità: Allegrini rappresenta oggi una delle principali realtà italiane nel settore della detergenza per il cleaning professionale. Fondata nel 1945, l’azienda ha saputo evolversi nel tempo, mantenendo salde le proprie radici e i valori di qualità, af dabilità e attenzione all’ambiente. Allegrini offre un vasto assortimento di prodotti per la pulizia professionale, sviluppati per rispondere alle esigenze di diversi settori: dall’Horeca all’industria alimentare, al carwash, dagli ambienti sanitari no alle imprese di servizi e facility management. Grazie a un costante lavoro di ricerca e sviluppo, i laboratori Allegrini formulano detergenti ad alte prestazioni che garantiscono igiene e sicurezza, rispettando le normative vigenti e le richieste del mercato. L’attenzione all’ambiente è da sempre uno dei pilastri della loso a aziendale. Negli anni, Allegrini ha investito in tecnologie sostenibili, sviluppando prodotti in grado di ridurre l’impatto ambientale senza comprometterne l’ef cacia. Un impegno che si concretizza in una gamma di detergenti certi cati Ecolabel, il marchio europeo che garantisce elevati standard di performance e minore impatto sull’ecosistema. Tra i prodotti di punta troviamo l’Ecolabel sgrassatore concentrato, un detergente liquido ad alto potere pulente, capace di rimuovere qualsiasi macchia e garantire risultati impeccabili. C’è poi l’Ecolabel detergente anticalcare, formulato con acidi organici, che restituisce brillantezza alle super ci. In ne, l’Ecolabel vetri, a base di tensioattivi di origine naturale, assicura una pulizia ef cace di vetri, specchi e cristalli senza lasciare aloni.
Il 2025 segna un traguardo importante per Allegrini, che festeggia il suo 80° anniversario. Otto decenni di esperienza e innovazione, durante i quali l’azienda ha saputo crescere e adattarsi alle nuove s de del mercato, mantenendo sempre al centro la qualità e la sostenibilità. Questo anniversario rappresenta un’occasione per celebrare i successi raggiunti e per guardare al futuro con nuovi progetti e ambizioni. Allegrini sarà protagonista della prossima edizione di ISSA Pulire Milano. L’evento rappresenterà un’occasione unica per presentare le ultime novità dell’azienda, con un focus particolare sulla gamma di prodotti Ecolabel e sulle soluzioni più innovative per il cleaning professionale. In era saranno protagoniste anche le soluzioni cosmetiche rmate Allegrini, frutto di una lunga esperienza nella cura dell’ospite e pensate per offrire benessere ed esclusività. Dalle formulazioni certi cate Cosmos Organic ed Ecolabel, alle proposte plastic-free e water-free della linea DPlanet, no ai progetti di personalizzazione che valorizzano l’identità dell’hotel: Allegrini porta in scena una bellezza responsabile, su misura per ogni struttura ricettiva.
Sarà un’opportunità per incontrare clienti e partner, condividere know-how e rafforzare il legame con un mercato in continua evoluzione.
Allegrini sarà presente a ISSA Pulire PAD. 8
Stand D27 E28

MACCHINARI, ATTREZZATURE, DETERGENTI E SERVIZI:
UNA SELEZIONE DI PROPOSTE
PER IL CLEANING PROFESSIONALE.
INNOVAZIONE, FUNZIONALITÀ
E SOLUZIONI PENSATE
PER RISPONDERE ALLE ESIGENZE DEL SETTORE.
TUTTO QUELLO CHE LE AZIENDE VOGLIONO FARVI CONOSCERE

Detergente concentrato di Fulcron PRO, marchio di propietà Arexons, per la manutenzione quotidiana di pavimenti in laminato, PVC, SPC e parquet verniciato, anche trattato. La formula a bassa schiuma non richiede risciacquo, riduce i tempi di intervento e rilascia un profumo avvolgente nell’ambiente circostante. L’azione antistatica rallenta il ridepositarsi della polvere per giorni.
Disincrostante acido ad alte performance, formulato per una pulizia quotidiana e intensiva delle superfici del bagno. Ideale per eliminare efficacemente incrostazioni di calcare e residui di sapone da lavabi, sanitari, piatti doccia, rubinetterie in acciaio, pareti doccia in vetro e piastrelle. La sua tecnologia avanzata protegge le superfici trattate, prevenendo la formazione di nuovo calcare. Inoltre, rilascia nell’ambiente una gradevole profumazione floreale, per un’esperienza di pulizia completa e duratura.



C120 è la lavasciuga pavimenti industriale uomo a bordo Comac progettata per unire grandi prestazioni di pulizia e un comfort unico per l’operatore. Ciò che rende unica C120 è il suo nuovo sistema spazzante-lavante composto da un gruppo prespazzante con due spazzole laterali e due spazzole cilindriche seguito da un gruppo lavante con tre spazzole a disco, per garantire ottimi risultati sempre e ovunque.








Combimac è la nuova macchina combinata, che unisce le migliori caratteristiche delle lavasciuga pavimenti e delle spazzatrici. Pensata per soddisfare le richieste di diversi settori, Combimac è dotata di un sistema a doppia azione separata composto da un sistema spazzante capace di convogliare nella parte centrale sporco e detriti solidi, e un basamento lavante composto da quattro spazzole a disco.


La spazzatrice uomo a bordo FSR8 di Fimap può lavorare a una velocità di 10 km/h, per 5 ore consecutive, coprendo una pista di lavoro che varia dagli 85 cm con la sola spazzola centrale, utile quando i passaggi sono più stretti, fino ad arrivare a 150 cm con entrambe le spazzole laterali. Mentre nella versione base lo svuotamento del cassone è manuale, nelle versioni Pro e Plus è automatico in quota. Lo scarico automatico può sollevare fino a 210 kg a 163 cm di altezza.
JMx è una lavasciuga pavimenti in cui la qualità e le prestazioni di pulizia della gamma Performance di Fimap sono condensate in un modello efficace e conveniente. Nella sua semplicità di allestimento, mantiene le promesse di robustezza, qualità dei materiali, ergonomia, facilità di manutenzione e risultati, per garantire gli standard del pulito professionale in una forma essenziale. È indicata per le imprese di pulizia, per la partecipazione a grandi appalti e una varietà di settori, tra cui la GDO.

Icefor presenta la linea I Green, detergenti super concentrati in sacca certificati CAM ed Ecolabel, con formulazioni vegetali, rapidamente biodegradabili, prive di VOC (Composti Organici Volatili) e testati per l’assenza di metalli pesanti. Prodotti efficaci e sicuri come: All Clean, Ice-103 Eco Nf e Super Dekalk.


Disinfettanti concentrati ad alta efficacia. Aminosept 10, a base di triammina, è ideale per l’industria alimentare e la ristorazione (HACCP), con azione battericida, levuricida e virucida. ICE 113 SEPT, ad ampio spettro, è perfetto per ambienti alimentari, sanitari e d’igiene pubblica. Entrambi i Presidi Medico Chirurgici, sono disponibili in diversi formati tra cui le sacche da 1,5 litri.

La lavatrice supercentrifugante LM di Imesa, con capacità 11 Kg è uno strumento versatile, personalizzabile e ideale per soddisfare tutte le esigenze di lavaggio di un’attività di piccole e medie dimensioni. Il computer Touch screen IM11 da 7” consente all’operatore di modificare i programmi esistenti o crearne di nuovi. Il set di 15 programmi Opticycle memorizzati di default include un ciclo dedicato al lavaggio di MOP, frange e panni di pulizia.




La linea essiccatoi ES Imesa è disponibile in tre versioni: Easy, Smart e Premium. Easy per un’asciugatura semplice e efficace, Smart e Premium, invece, dotate di computer touch screen IM10 offrono funzionalità avanzate, la possibilità di personalizzare i programmi e il controllo del grado di umidità residuo. Il modello ES 11Kg è il completamento ideale per la lavatrice da 11Kg: insieme garantiscono un ciclo di lavaggio e asciugatura perfettamente bilanciato, ottimizzando tempi, consumi e risultati.


Detergente sgrassante alcalino per l’industria alimentare. Ideale per rimuovere sporco di natura inorganica e organica, come: grasso, unto, scarti di lavorazione della carne, del pesce, dell’industria conserviera, lattiero-casearia e dolciaria. Adatto a superfici in acciaio, ferro, alluminio e plastica grazie agli inibitori di corrosione. Non profumato, facilmente risciacquabile.
Mr Shield PRO TECH, brand di Indupharma, presenta LP2, detergente concentrato con effetto deodorante, ideale per la pulizia quotidiana di superfici dure e lavabili, compresi marmo, ceramica, cotto, linoleum, plastica e metallo; consigliato per gli ambienti ad alto traffico di persone come uffici, palestre, centri commerciali e ambulatori. Applicabile sia a mano che con lavapavimenti. Utilizzabile nelle procedure di pulizia conformi al Sistema HACCP.

La linea Sweeper di OMM offre spazzatrici durevoli e robuste in grado di coprire tutte le esigenze di mercato. Fa parte della linea di spazzatrici uomo a bordo T-REX con una capacità di lavoro fino ai 8000 mq/h e una larghezza di pulizia di 700mm.


TORO 1000 la lavasciuga uomo a bordo potente contro ogni tipo di sporco, su ogni tipo di pavimento. Per un risultato sorprendente ad ogni uso.
Toro è la più grande lavapavimenti uomo a bordo in casa OMM, adatta per chi ha bisogno di pulire superfici di grandi dimensioni (fino ai 5500 mq/h) restando comodamente seduto.


Orma presenta Spray Jet, linea di deodoranti per ambienti ad elevata persistenza e caratterizzati dalla loro triplice azione: neutralizzano i cattivi odori, profumano gradevolmente l’area e, contestualmente, la purificano, creando un’atmosfera piacevole ed una immediata sensazione di pulito. Spray Jet è disponibile in 3 differenti profumazioni, e grazie alla sua potente valvola, riesce a profumare grandi ambienti in pochi secondi.
Insetticida pronto uso a rapida azione abbattente, è la soluzione più efficace per debellare nidi di vespe e calabroni, anche quelli più grandi e posizionati nei punti più insidiosi. Disponibile in versione spray o schiuma, dispone di una valvola a lunga gittata che ne potenzia l’erogazione permettendo di agire da una distanza di 5 metri.


Per rispondere ai requisiti delle gare d’appalto e del Green Public Procurement (GPP), Paredes propone una linea di detergenti a produzione europea, caratterizzata da basso consumo energetico, packaging unimateriale e un eccellente rapporto qualità-prezzo. Grazie alla partnership esclusiva con Innuscience, l’azienda offre anche una gamma biotecnologica: formulazioni 100% naturali, sicure per gli utenti e rispettose dell’ambiente. Tra i prodotti di punta, Nu-Kleen All, multiuso certificato Ecolabel, combina efficacia e sostenibilità in un’unica soluzione.


Paredes propone tramite la sua partnership esclusiva con Innuscience una gamma biotecnologica, sostitutiva della chimica tradizionale, che risulta essere perfetta per chi vuole accelerare la sua transizione ecologica e sostenibilità ambientale. I prodotti sono efficaci, 100% di origini naturali, sicuri per gli utenti e l’ambiente. n particolare, Nu-LactiKleen, prodotto polivalente ad azione biocida.


La linea Bacticyd® Vebi PRO offre soluzioni innovative per detergenza e disinfezione ad alte prestazioni. Bacticyd® Spray agisce in pochi istanti, eliminando il 99% dei batteri e neutralizzando odori. Bacticyd® Foam, schiuma attiva e leggera, copre uniformemente superfici ampie per una pulizia profonda, ideale per impianti HVACR. La formulazione One-Shot consente di sanificare ambienti ad elevata frequentazione con una sola dose. Bacticyd® è sinonimo di efficacia, facilità d’uso e affidabilità.
Insetticidi in bombola aerosol automatizzata Vebi PRO per una protezione continua contro insetti volanti. Pyretech Automatic Extra, a base di Piretro vegetale, è perfetto per trattamenti in ambienti domestici, civili e industriali. Abbinato al dispositivo automatico con erogazione temporizzata, elimina mosche, zanzare, zanzare tigre e insetti delle derrate. Completano la gamma Automaticsafe AE e MultiPy Automatic, a base di Piretro naturale.
XpirA Extreme Spray, da 400 ml, offre un doppio utilizzo: sia manuale con ugello sia automatico, grazie al dispositivo Automatic Revolution.


Gel a base di acido citrico per la pulizia di WC e sanitari, la sua formula garantisce una triplice azionenell’uso quotidiano: igienizza, deodora e rimuove il calcare. Il prodotto è parte della linea We CleanGreen, i detergenti We Italia certifi cati Ecolabel. Il pack riciclato al 50% è certifi cato Plastica SecondaVita, l’acido citrico, di origine vegetale, proviene dalla lavorazione del mais.
Nuovo sapone Ecolabel a marchio We Italia per mani e corpo dalla formula delicata, dermatologicamente testata su pelli sensibili. A base di tensioattivi naturali vegetali da fonti rinnovabili. Indicato per le imprese e per tutte le categorie di clienti in particolare per le gare d’appalto, in linea con gli obiettivi ESG di riduzione dell’inquinamento e risparmio delle risorse naturali del pianeta.








In un’epoca in cui la sostenibilità è fondamentale, Lucart Professional emerge come pioniere nell’economia circolare, grazie al progetto EcoNatural, che da 15 anni rappresenta un esempio di innovazione sostenibile. Questo progetto, frutto di tecnologie avanzate, trasforma i materiali di scarto in risorse preziose, riciclando tutti i componenti dei cartoni per bevande attraverso un processo produttivo unico nel settore. I cartoni per bevande, composti da bre di cellulosa, polietilene e alluminio, possono essere riciclati ef cacemente quando scomposti correttamente. Grazie alla tecnologia esclusiva di Lucart, le bre di cellulosa vengono trasformate in Fiberpack®, la materia prima utilizzata per realizzare l’intera gamma di carte EcoNatural. Il polietilene e l’alluminio residui vengono invece convertiti in Al.Pe®, un materiale impiegato per produrre dispenser, rendendo EcoNatural l’unico sistema in grado di fornire una soluzione completa di carta e dispenser, interamente derivata da cartoni per bevande riciclati.
TANGIBILE, MISURABILE, CERTIFICATO
EcoNatural offre una soluzione ecologica concreta e misurabile: negli ultimi dieci anni, Lucart ha recuperato oltre 10,7 miliardi di cartoni per bevande da un litro, producendo tonnellate di carta Fiberpack®. I prodotti EcoNatural sono circolari, sostenibili e rispettosi dell’ambiente, avendo ottenuto numerose certi cazioni: ogni articolo della gamma è certi cato Ecolabel, FSC® Recycled e, per i prodotti realizzati nello stabilimento di Laval-sur-Vologne, Cradle

to Cradle® Silver. Inoltre, tutte le carte igieniche e gli asciugamani EcoNatural sono Climate Neutral secondo lo standard PAS 2060, assicurando che tutte le emissioni di gas serra generate durante il ciclo di vita del prodotto siano state ridotte e compensate, raggiungendo un valore netto pari a zero. L’impegno per la sostenibilità si estende anche agli imballaggi, che, dove possibile, sono stati sostituiti con soluzioni in carta riciclata e compostabile o in plastica riciclata.
La nuova linea EcoNatural FLOW, realizzata in polietilene e alluminio provenienti da cartoni per bevande riciclati, presenta un design esclusivo e brevettato, caratterizzato da linee eleganti e sinuose. Lucart Professional continua il suo percorso innovativo con tre nuove proposte: il dispenser per asciugamani a rotolo a taglio automatico EcoNatural Flow Autocut Towel ID; il dispenser per carta igienica a dispensazione foglio a foglio L-ONE FLOW; e il dispenser per saponi liquidi e in schiuma Soap 400 FLOW ID. La collezione comprende dispenser per ogni necessità, disponibili in nero e bianco, tutti certi cati OK Recycled e completamente riciclabili, garantendo così un impegno costante verso la sostenibilità.








FLOW TOILET PAPER L1
Riduzione degli sprechi con l’erogazione singola
108 cartoni per bevande
riciclati per produrre un dispenser*




Una gamma completa in bianco e in nero







NEW FLOW SOAP 400
Super compatto, basta solo una dose

FLOW AUTOCUT TOWEL
Riduzione dei consumi con il taglio automatico









Innovativo design brevettato









